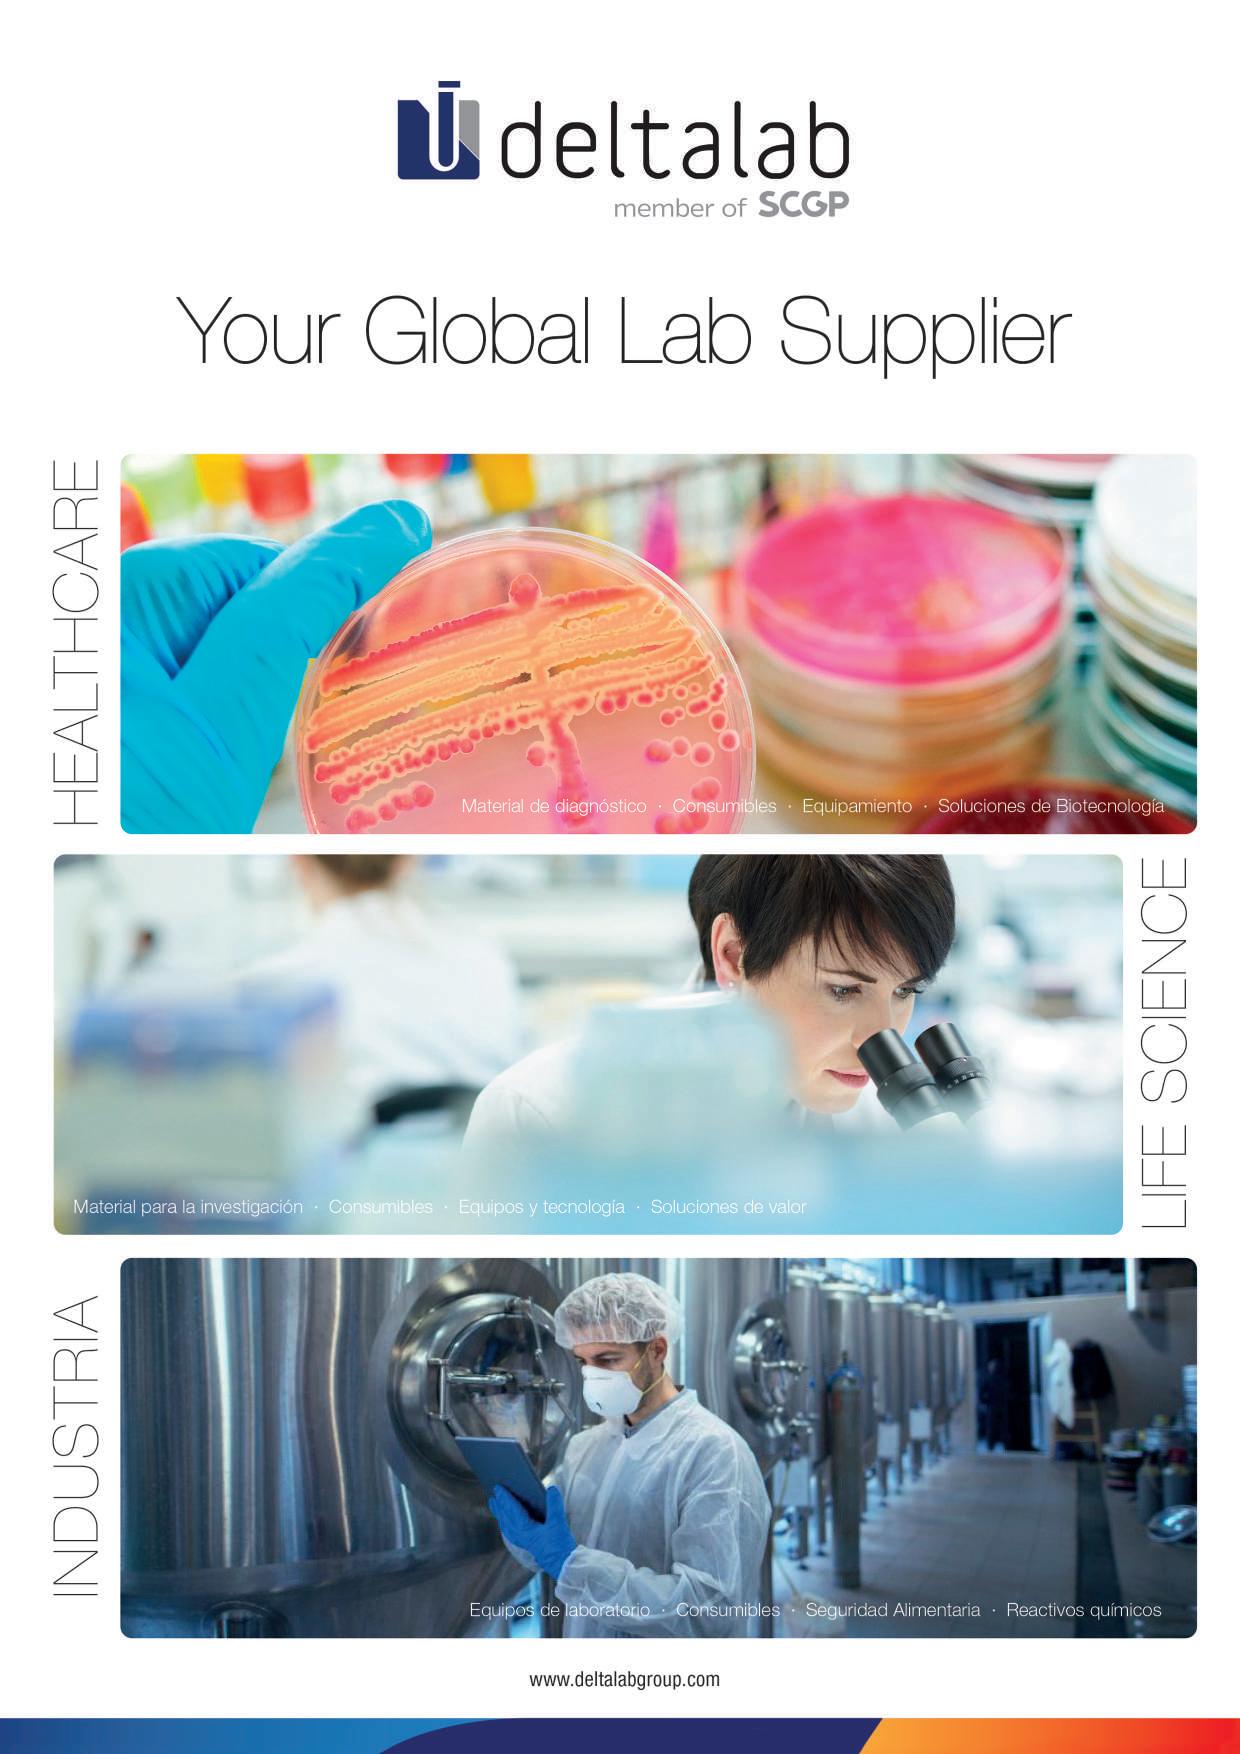

![]()



Ofrecemos una vez más a todos los lectores de la revista (on line o en papel) la Guía de Empresas de Técnicas de Laboratorio, edición 2025/2026, cuyo núcleo es la información sobre las más destacadas empresas del sector que nos ocupa. La sección que abre esta edición y que precede a la ‘Guía de Empresas y Productos’ propiamente dicha reúne reportajes y artículos de interés general.
La clasificación alfabética de empresas por productos y servicios se elabora gracias a las actualizaciones permanentes de las propias firmas realizadas a través de nuestro portal web. Dichas compañías pueden acceder a esta información de forma privada y exclusiva para modificarla cuando lo consideren necesario, para que la versión on line de la Guía esté siempre al día, sin que ello reste vigencia a un documento -nos referimos a la versión en soporte papel- cuya utilidad se mantiene prácticamente intacta hasta que se publica una nueva edición. Cabe destacar que la información sobre las empresas que ofrece la versión on line del documento, donde no hay limitaciones de espacio -como sí sucede con el papel-, es más amplia.
La estructura del resto de la publicación se mantiene respecto a la de entregas anteriores. La ‘Agenda’ es un elemento más de consulta en este documento. Reúne datos de instituciones, asociaciones, ferias y congresos (tanto nacionales como extranjeros) siempre en relación más o menos estrecha con el mundo de los fabricantes y usuarios de cualquier tipo de laboratorio.
Cierra el volumen la Guía del Comprador, sección fija de la revista, de gran utilidad y prestigio entre los proveedores españoles y extranjeros.
Les recordamos que los usuarios registrados pueden consultar la Guía también on line mediante www.tecnicasdelaboratorio.com utilizando las claves (e-mail y contraseña) que recibieron al formalizar la suscripción al portal.
Queremos seguir mejorando esta propuesta para que sea una herramienta cada vez más útil, versátil, completa e interactiva. Recibiremos agradecidos cualquier sugerencia, adición, ampliación, modificación o corrección de los datos ofrecidos en estas páginas, ya se refieran a asociaciones, empresas, instituciones, ferias o congresos.
Publica, S.L.


351 PRESENTACIÓN
Guía de Empresas 2025/2026
354 EMPRESAS
Lauda obtiene la medalla de plata de EcoVadis
356 CRIOCONSERVACIÓN
Caracterización de excursiones térmicas en viales almacenados criogénicamente: implicaciones de superar la temperatura de transición vítrea del agua
Erica Waller
360 ENTREVISTA
Andrea Romero, directora de Biotechforum 2025:
“El congreso es una oportunidad única para compartir experiencias reales del ecosistema biotech”




362 DIVULGACIÓN
Alemania, la cuna de la farmacología y su aplicación en laboratorios
Xavier Bautista
366 PERSONAS
Otorgados los Premios SusChem-España 2025
368/374 AGENDA
Asociaciones e instituciones / Ferias y congresos especializados
380 GUÍA DE EMPRESAS
Guía de empresas y productos (véase detalle en la pág. 353)
428 GUÍA DE EMPRESAS
Relación de firmas
443 GUÍA DE EMPRESAS
Índice de productos
444 TÉCNICAS INSTRUMENTALES
Relación de productos
465 GUÍA DEL COMPRADOR

380 ALBUS Suministros para laboratorios
382 Auxilab, S.L.
384 Calibre Scientific Spain
386 Carlo Erba Reagents, S.A.
388 Carlos Árboles, S.A.
390 Controltecnica, Equipos y Proyectos, S.L.
392 CRUMA Laboratory equipment made in Barcelona
394 Deltalab Member of SCGP
396 Dicsa
398 Fisher Scientific
400 Fritsch GmbH
402 Infrico Medcare
404 Julabo The Temperature Control Company
406 Labbox Labware, S.L.
408 Lauda Dr. R. Wobser GmbH & CO. KG
410 LGC Standards
412 Memmert GmbH + Co. KG
414 Mettler Toledo SAE
416 Nippon Gases España, S.L.U.
418 Peter Huber Kältemaschinenbau SE
420 Scharlab, S.L.
422 Socorex Isba SA
424 Verder Scientific Iberia, S.L.
426 Vidra Foc, S.A.
LAUDA DR. R. WOBSER GMBH & CO. KG, fabricante líder mundial de unidades y sistemas de control de temperatura, ha sido galardonada con la medalla de plata de EcoVadis. Con una calificación de 70 sobre 100 puntos posibles, la empresa alemana, a la vanguardia de la sostenibilidad, se sitúa entre el 15% de las mejores empresas de todo el mundo y subraya así su compromiso con las prácticas empresariales sostenibles.
EcoVadis está considerada líder mundial en calificaciones de sostenibilidad. La organización evalúa a las empresas en función de 21 criterios de sostenibilidad detallados que abarcan cuatro áreas clave: medio ambiente, trabajo y derechos humanos, ética y abastecimiento sostenible. Hasta la fecha, más de 85.000 empresas de todo el mundo se han sometido al riguroso proceso de evaluación de EcoVadis, que se basa en normas internacionales, incluidos los diez principios del Pacto Mundial de las Naciones Unidas, los convenios de la Organización Internacional del Trabajo y la norma ISO 26000.
LAUDA recibe este premio en reconocimiento a sus esfuerzos integrales en materia de gestión de la sostenibilidad y sus iniciativas estratégicas en este ámbito. “Este reconocimiento confirma nuestra convicción de larga data de que las prácticas empresariales sostenibles y el éxito empresarial van de la mano”, destaca el Dr. Gunther Wobser, presidente y CEO de LAUDA . “Recibir la medalla de plata de EcoVadis es un hito importante en nuestro camino hacia una empresa más sostenible.”

LAUDA recibió la medalla de plata de EcoVadis en marzo de 2025, lo que la sitúa entre el 15% de las mejores empresas de todo el mundo evaluadas en el ámbito de la sostenibilidad (© LAUDA)

El primer informe de sostenibilidad, publicado en 2023, fue un factor clave para LAUDA en la exitosa evaluación de EcoVadis y documenta las iniciativas sistemáticas de la empresa en cuanto a sostenibilidad (© LAUDA)
Un componente clave de este éxito fue la publicación del informe de sostenibilidad 2023, que se editó a finales de 2024. Esta transparencia en la presentación de informes permitió a LAUDA documentar y demostrar a EcoVadis la calidad y el alcance de sus actividades de sostenibilidad. “La documentación sistemática de las actividades ESG en nuestro primer informe de sostenibilidad fue un factor decisivo en esta evaluación”, explica el Dr. Marc Stricker, director General de LAUDA y responsable de la gestión de la calidad y el medio ambiente. “Hemos demostrado a EcoVadis que implantamos medidas concretas que medimos y comunicamos de forma transparente.”
La mejora en la calificación de EcoVadis ha sido posible gracias a varias medidas que LAUDA ha implementado de forma sistemática. La empresa ha desarrollado políticas de sostenibilidad más detalladas y ha ampliado considerablemente la recopilación y publicación de cifras clave relevantes para EcoVadis. Por primera vez, la empresa ha publicado informes exhaustivos
“Recibir la medalla de plata de EcoVadis es un hito importante en nuestro camino hacia una empresa más sostenible.”
sobre aspectos ambientales y sociales. Además, se elaboró un informe CSRD de acuerdo con las nuevas normas europeas de información. Este enfoque sistemático permitió a LAUDA optimizar sus procesos internos y aumentar significativamente su transparencia externa.
“Estamos especialmente orgullosos de que las especificaciones más detalladas de LAUDA y el registro ampliado de los indicadores clave hayan dado lugar a mejoras cuantificables”, añade el Dr. Stricker. “Esto demuestra la eficacia de nuestro enfoque integral de la gestión de la sostenibilidad y valida nuestra orientación estratégica.”
De cara al futuro, LAUDA tiene previsto utilizar de forma específica los conocimientos adquiridos en el proceso de evaluación de EcoVadis en las conversaciones con los clientes. La empresa familiar seguirá perfeccionando su estrategia de sostenibilidad y continuará con su información sobre ESG.
www.lauda.de/es
(Véase anuncio en la sección Guía del Comprador.)
LAUDA es líder en el sector de la regulación exacta de la temperatura. Sus equipos e instalaciones de termorregulación son parte fundamental de aplicaciones importantes y contribuyen a mejorar el futuro. Es un proveedor integral y garantiza la temperatura óptima en la investigación, la producción y el control de calidad. Es el socio en el que confiar para la electromovilidad, el hidrógeno, las industrias química, farmacéutica/biotecnológica y de semiconductores, así como de la tecnología médica. Gracias a su asesoramiento competente y a unas soluciones innovadoras, lleva casi 70 años entusiasmando cada día de nuevo a los clientes de todo el mundo. En cuanto al estilo empresarial, también va siempre un paso por delante. Impulsa a sus empleados y constantemente se plantea desafíos por un futuro mejor que forjan juntos.
Caracterización
Las muestras biológicas almacenadas por debajo de −150 °C en congeladores de nitrógeno líquido (LN2) en fase de vapor se basan en la suposición de que los procesos bioquímicos y degradativos cesan por debajo de la temperatura de transición vítrea del agua (Tg,H2O ≈ −134 °C). Sin embargo, las excursiones térmicas transitorias durante la manipulación pueden exponer las muestras a tasas de calentamiento suficientes para superar Tg,H2O en segundos. Este estudio caracteriza el comportamiento de calentamiento de crioviales individuales llenos de H2O durante condiciones típicas de manipulación y cuantifica el riesgo de sobrepasar la Tg,H2O. Los resultados de mediciones experimentales y simulaciones por elementos finitos se utilizan para informar sobre las mejores prácticas para una manipulación segura de muestras criogénicas.
Erica Waller, Azenta Life Sciences, Burlington, Massachusetts, EE.UU.
Introducción
El almacenamiento criogénico es fundamental para la conservación a largo plazo de muestras biológicas. El umbral crítico para la estabilidad de las muestras es la temperatura de transición vítrea del agua (Tg,H2O), por debajo de la cual la movilidad molecular y la actividad química se detienen eficazmente. Sin embargo, durante la manipulación, particularmente durante las transferencias desde almacenamiento en LN2 hacia ambientes a temperatura ambiente (RT) o con hielo seco (−80 °C), las muestras son susceptibles a excursiones térmicas rápidas. Comprender la dinámica de las tasas de calentamiento de los viales es crucial para mitigar el riesgo de degradación durante estos eventos.
Materiales y métodos
Configuración experimental
• Almacenamiento: viales equilibrados en congelador de fase vapor de LN2 a −173 °C.
• Medición: viales instrumentados con tres termopares Tipo T de calibre 32 ubicados en:
- 2 mm por debajo de la superficie del agua
- Centro del vial
- Base del vial.
• Condiciones de calentamiento: viales calentados por suspensión en aire ambiente o inmersión en pélets de hielo seco, sin contacto con el usuario. El calentamiento ocurrió por convección natural salvo que se indique lo contrario.
Configuración de simulación
Se desarrollaron modelos por elementos finitos (FE) en ANSYS 15.0 calibrados con datos empíricos. Las propiedades del hielo dependían de la temperatura; las propiedades de los viales de polipropileno se asumieron a temperatura ambiente.
• Muestras: viales FluidX™ de 1,0 mL y 2,0 mL, y viales Wheaton™ de 2,0 mL, llenos con 100% o 25% del volumen de trabajo máximo (MWV) con agua desionizada.
Resultados
Tasas de calentamiento:
• Viales individuales (−175 °C a −120 °C): tasas de calentamiento de 55 a 255 °C/minuto.
• Dentro de cryoboxes: tasas reducidas a entre 5,4 y 66,7 °C/ minuto.
Tiempo para superar Tg,H2O:
• Ambiente RT: 24 - 40 s
• Hielo seco: 9–45 s (más rápido por conducción y convección de CO2).
Efecto del volumen: volúmenes menores de H2O se calentaron entre un 15–35% más rápido, aunque el impacto fue menor que el del entorno.
Uniformidad térmica: La variación espacial de temperatura en el interior de los viales fue ≤4 °C en todo momento, confirmando una distribución térmica casi uniforme.
Tabla 1. Tasas de calentamiento de tubos individuales desde -175 °C hasta banco de laboratorio (21 °C) o temperatura del hielo seco [°C/minuto].
Tubos llenos con H2O

1. Tasa de calentamiento linealizada en el intervalo de -175 °C a -120 °C.
Tabla 2. Tasas de calentamiento de tubos almacenados en cryobox desde -175 °C hasta banco de laboratorio (21 °C) [°C/minuto].
Tubos llenos con H2O

1. Tasa de calentamiento linealizada en el intrervalo de -175 °C a -130 °C.
2. Tubo de almacenamiento en formato 96 con tapa roscada y 0,73 ml de H2O; base del rack perforada.
3. Tubo de almacenamiento 9x9 con tapa roscada y 1,8 ml de H2O, sin base perforada.
4. Cryobox TruCool con bisagra 9x9 con orificios de drenaje para LN2; tubos llenos con 1,8 ml de H2O.
5. Caja de congelador KeepIT-100, tubos llenos con 1,8 ml de H2O, base del rack perforada.

Figura 1. Sensibilidad de la tasa de calentamiento al volumen y al entorno de exposición. Volúmenes más bajos de H2O proporcionan menor masa térmica a una energía absorbida equivalente, lo que da lugar a tasas de calentamiento ligeramente mayores (15 - 30%). Sin embargo, este efecto es poco significativo comparado con el rápido calentamiento de un vial por debajo de −90 °C. Los viales individuales en hielo seco superan Tg,H2O (−134 °C) mucho más rápidamente que en ambiente RT.
Durante la manipulación, particularmente durante las transferencias desde almacenamiento en LN2 hacia ambientes a temperatura ambiente o con hielo seco (−80 °C), las muestras son susceptibles a excursiones térmicas rápidas.

Figura 2. Sensibilidad de la tasa de calentamiento al volumen de H2O en RT, sensor interior. Los viales se calentaron por encima de Tg,H2O en un tiempo de entre 24 y 40 s. Se detectó una meseta de temperatura inicial entre −173 °C y −169 °C debida a un breve intervalo donde los viales permanecen en el cryorack y cryobox al ser extraídos del congelador. Todos los sensores interiores muestran sensibilidad comparable al volumen de H2O.

Figura 3. Sensibilidad de la tasa de calentamiento al volumen de H2O en hielo seco, sensor interior. Los viales superaron Tg,H2O en un tiempo de entre 9 y 45 s. Todos los sensores interiores muestran sensibilidad comparable al volumen de H2O.

Figura 4. Distribución de temperatura en un vial FluidX lleno de H2O al ser extraído del almacenamiento criogénico y expuesto a RT. En cualquier momento dado, la variación máxima de temperatura del hielo es de hasta 4 °C debido a la mayor difusividad térmica (α) del hielo en comparación con el polipropileno (PP) (por ejemplo, αHielo (T -150 °C) = 1,07e-5 mm²/s vs. αPP (T 22 °C) ≈ 1.29e-7 mm2/s). Los datos indican que el aumento de temperatura dentro del vial es altamente uniforme.

Figura 5. Distribución de temperatura simulada en un tubo FluidX 1.0 ml al 100% MWV extraído del almacenamiento criogénico y expuesto a condiciones RT. A lo largo del tiempo, la temperatura es muy uniforme en todo el volumen de la muestra.

Figura 6. Calor absorbido simulado por el tubo FluidX 1.0 ml al calentarse de −173 °C a −1 °C. La transferencia de calor por convección representa la mayor contribución de energía del ambiente al tubo, mientras que la conducción a través de los cables TC fue insignificante y no se simuló.
Ecuación 1
Q = h · A · (T_env − T_vial) · t
Manipular viales en entornos < −150 °C reduce el calor absorbido en más del 90%.
Esta ecuación demuestra cómo la transferencia de calor por convección hacia un vial puede reducirse significativamente disminuyendo la temperatura del entorno.
Discusión
El rápido acercamiento a Tg,H2O incluso durante exposiciones breves a ambientes más cálidos resalta la necesidad de protocolos estrictos de manipulación criogénica. Particularmente, los entornos con hielo seco pueden representar mayores riesgos térmicos que el aire ambiente por debajo de −90 °C, debido al contacto directo y la convección de CO2. Las cryoboxes con tapa reducen significativamente la exposición y deben usarse siempre que sea posible. El tiempo de manipulación debe minimizarse e, idealmente, realizarse en ambientes mantenidos por debajo de −150 °C.
Los crioviales extraídos del almacenamiento en LN2 están en alto riesgo de superar la Tg,H2O en segundos durante la manipulación. La tasa de calentamiento está más influenciada por la temperatura ambiental y el método de exposición del vial, con influencia mínima del volumen o geometría del vial. Las mejores prácticas criogénicas deben incluir:
• Mantener las muestras en cryoboxes con tapa durante la manipulación.
• Limitar el tiempo de exposición fuera de ambientes con LN2
• Realizar manipulaciones en ambientes ≤ −150 °C. Estos pasos ayudan a preservar la integridad de las muestras biológicas evitando cruces transitorios por encima de Tg,H2O.
www.azenta.com

Andrea
Romero, directora de Biotechforum 2025:
“El
”
Andrea Romero, cofundadora de Konexio Biotech y directora de Biotechforum 2025, nos ofrece una visión completa sobre los retos, tendencias y oportunidades que marcarán esta nueva edición del congreso. Con un enfoque integrador y realista, nos habla de la necesidad de tender puentes entre la investigación, la industria y la tecnología para impulsar la biotecnología hacia una medicina más personalizada y sostenible.
Qué criterios se han seguido para definir el programa y los temas que se tratarán este año?
Este año el criterio fundamental que se ha seguido para organizar el congreso ha sido seleccionar compañías biotecnológicas medianas y grandes, nacionales e internacionales, y compañías pequeñas o startups junto a grupos de investigación biomédica, para poder realizar un análisis del ecosistema biotecnológico desde distintos puntos de vista y perspectivas, con el único objetivo de generar un espacio de diálogo crítico y enriquecedor tanto para ponentes como para asistentes al evento.
¿Qué tipo de público profesional esperáis atraer en esta edición?
Tal y como comentaba, el único objetivo de Biotechforum es generar un espacio de diálogo entre los diferentes agentes del sector, un espacio donde los asistentes puedan encontrar soluciones a problemas o casuísticas que se encuentran en el día a día. La jornada está orientada a proyectos biotecnológicos en fase de desarrollo, por lo que el público esperado lo formarán tanto grupos de investigación básica como grupos de investigación traslacional, así como fondos de inversión y compañías farmacéuticas y biotecnológicas.
¿Cómo está impactando la inteligencia artificial en la I+D de soluciones biotecnológicas?
En mi opinión, la IA es una herramienta de gran utilidad en el sector, no solo porque permitirá agilizar algunos puntos clave en el desarrollo de esta tipología de fármacos, sino porque se va a convertir en un producto farmacéutico per se. Cómo se va a adaptar la IA al sector es uno de los mayores retos que vamos a ver en los próximos años, pero sin duda, su incorporación cada vez más común en distintos proyectos marcará un valor diferencial.
¿Qué papel crees que desempeña la biotecnología en la transición hacia una medicina más personalizada y sostenible?
La biotecnología es una pieza clave en esta transición, ya que permite desarrollar herramientas y terapias dirigidas, adaptadas a las características específicas de cada paciente. Además, promueve modelos más sostenibles de producción y desarrollo farmacéutico, optimizando recursos y reduciendo impactos negativos, tanto económicos como ambientales. Sin duda, con los años se conseguirán procesos y tecnologías que hagan que los procesos sean cada vez mejores y más precisos.

Como cofundadora y directora Científica de Konexio Biotech, ¿qué retos encuentras en el día a día de una empresa biotecnológica en crecimiento?
Uno de los principales retos es equilibrar la innovación científica con la regulación en la que se ve envuelto el sector. Las nuevas tecnologías obligan a establecer procesos normativos distintos que tienen que englobar a los productos que están en el mercado. Esta regulación no debería afectar a la calidad de la investigación o del proceso de desarrollo, pero vemos cada vez más complejidad en encontrar marcos normativos que acojan nuevos proyectos con los estándares establecidos hasta ahora.
El
objetivo de Biotechforum es generar un espacio de diálogo entre los agentes del sector
¿Cómo conectas tu experiencia empresarial con tu labor como directora del Biotechforum?
La experiencia en el ámbito empresarial me permite identificar con claridad las necesidades reales del sector biotecnológico. Esto me ayuda a diseñar un programa que no solo sea inspirador, sino también útil y aplicable para quienes están liderando proyectos, permitiendo que el Biotechforum sea un espacio realmente útil de conexión, reflexión y colaboración entre distintas empresas del sector para poder seguir impulsando la innovación y el desarrollo en este país.
¿Qué mensaje lanzarías a quienes aún no conocen Biotechforum y están considerando asistir por primera vez en 2025?
Les diría que es una oportunidad única para conectar con profesionales de referencia, descubrir nuevas ideas y compartir experiencias reales del ecosistema biotech. Es un foro cercano, dinámico y multidisciplinar, donde el diálogo es el motor principal del aprendizaje. Nuestra intención siempre es dar un enfoque 360° del sector sobre lo que está pasando en la actualidad, pero, sobre todo… sobre lo que pasará.
marco: Farmaforum
Farmaforum es el Foro de la Industria Farmacéutica, Biofarmacéutica y Tecnología de laboratorio. Tendrá lugar los días 17 y 18 septiembre de 2025, en el Pabellón 9 IFEMA (Madrid), y se desplegará en 13 ramas, a saber: Cosméticaforum, centrado en la creación y producción de cosméticos, reúne a la industria cosmética y sus proveedores.
Biotechforum: Foro de la industria biotecnológica, sanitaria y cosmética.
Clinical Research Forum, dedicado a la investigación clínica y el desarrollo de nuevos medicamentos.
Innovaforum: encuentro para presentar soluciones analíticas innovadoras a problemas de biotecnología, industria farmacéutica, cosmética y nutrición.
Cannabisforum, dedicado al cannabis medicinal y todas sus implicaciones.
APIsforum se centra en el mundo de los APIs, elementos fundamentales a la hora de completar el proceso de desarrollo de medicamentos.
Nutraforum, foro al que las empresas fabricantes asisten para informarse, formarse en las últimas novedades, tendencias y regulaciones del sector nutracéutico.
MedicalDeviceForum explora las últimas innovaciones, tendencias regulatorias y oportunidades de negocio en el ámbito de los productos sanitarios.
Vetforum, foro de la industria de salud animal.
Farmacovigilanciaforum, encuentro sobre la vigilancia de la seguridad tanto de medicamentos de uso humano y veterinario, como de dispositivos médicos y cosméticos.
Logisticforum, sobre la logística y distribución del producto healthcare, comprende todas las actividades relacionadas con el almacenaje y la distribución del producto healthcare Young Pharma Forum: dirigido a los futuros profesionales de la industria farmacéutica.
Labforum: esta cita de proveedores de materiales, instrumentación, equipos y métodos para el análisis y diagnóstico en el laboratorio se centra en satisfacer las necesidades que surgen en los laboratorios que analizan e investigan. El laboratorio clínico, analítico o de investigación moderno ha dejado de ser un espacio cerrado para convertirse en un espacio flexible y de colaboración en el cual se comparten los avances a escala internacional. Tanto el entorno “laboratorio” como sus herramientas de trabajo están cambiando drásticamente en los últimos años y para competir es imprescindible conocer las novedades que facilitan la investigación. Especialmente en el área de salud los laboratorios tienen un papel clave. Últimos equipos y aparatos de análisis, innovadoras técnicas de laboratorio, materiales para la preparación de muestras, microscopios… Labforum procura reunir a los fabricantes destacados y pretende ser el punto de encuentro de los investigadores y técnicos de laboratorio.
Alemania es una de las cunas de la industria farmacéutica moderna. Desde sus raíces en los colorantes sintéticos del siglo XIX hasta convertirse en líder mundial en innovación médica y biofarmacéutica, los laboratorios germanos han marcado hitos cruciales para la salud global. Productos como la aspirina, el prontosil, la penicilina, la talidomida, el pervitin o los avances en biosimilares muestran cómo Alemania ha influido decisivamente en la medicina.

Acontinuación, se exponen los orígenes del sector químico-farmacéutico germano, la consolidación antes y durante las dos guerras mundiales, la era del milagro alemán, la industrialización posbélica y la era contemporánea de la biotecnología y la globalización, con los momentos más trascendentales, así como los productos que marcaron un antes y un después.
De los colorantes sintéticos a la farmacología moderna
A mediados del siglo XIX, Alemania lideraba el desarrollo de colorantes sintéticos gracias a empresas como BASF, Bayer y Hoechst (esta última hoy bajo el paraguas de la francesa Sanofi). El dominio en estos químicos facilitó la transición hacia los medicamentos, aprovechando instalaciones y conocimientos
de síntesis orgánica. Hoy día, esas tres firmas todavía son líderes mundiales en los sectores químico y farmacéutico.
Al mismo tiempo, en 1860, Rudolf Buchheim fundó el primer Instituto de Farmacología en Dorpat (hoy Tartu, Estonia), considerado el inicio formal de la farmacología moderna. Imprescindible también fue Oswald Schmiedeberg, discípulo de Buchheim, quien impulsó la

investigación sistemática de fármacos, sentando las bases científicas de la disciplina.
La invención de la aspirina y la evolución de la industria
En 1863, Friedrich Bayer y Johann Friedrich Weskott crearon Bayer en Barmen, inicialmente dedicada a los colorantes. En 1897, el químico Felix Hoffmann sintetizó el ácido acetilsalicílico y en 1899 Bayer registró la marca “Aspirina”. Este medicamento, uno de los antiinflamatorios más utilizados en el mundo, consolidó la imagen de Alemania como potencia farmacéutica.
Otros medicamentos surgidos en los albores de los laboratorios farmacéuticos modernos fueron:
- Heroína: Bayer comercializó diacetilmorfina como supresor de la tos a principios del siglo XX antes de descubrirse su potencial adictivo.
- Barbital (Veronal), considerado el primer barbitúrico, y la procaína o novocaína (Novocain) se introdujeron entre 1905 y 1909, posicionando a Alemania a la vanguardia en sedantes y anestesia.
- Salvarsan, desarrollado por Paul Ehrlich entre 1910 y 1914, fue el primer tratamiento quimioterapéutico contra la sífilis, y es considerado el origen de la quimioterapia moderna.
En los años 30, los laboratorios Bayer (entonces parte del conglomerado I.G. Farben) desarrollaron prontosil, el primer antibiótico sulfonamida, que reveló su eficacia contra infecciones. Gerhard Domagk obtuvo el Premio Nobel de Medicina en 1939. Este antibiótico fue un antes y un después en la lucha contra las enfermedades bacterianas.
La fusión de varias empresas químicas, incluida Bayer, bajo el conglomerado I.G. Farben, creó una de las mayores corporaciones industriales del mundo. Esta consolidación integró investigación, producción y capacidades globales, aunque luego se vinculó al régimen nazi (se encargó, por ejemplo, de la producción del gas letal Zyklon B, utilizado en los campos de exterminio).
Durante el nazismo, la farmacología se entrelazó con la ideología militar y médica. Se potenció la investigación, a menudo con métodos no éticos, dentro de una estrecha colaboración entre el régimen, la industria y la universidad.
En 1863, Friedrich Bayer y Johann Friedrich Weskott crearon Bayer en Barmen, inicialmente dedicada a los colorantes

La aspirina, cuya marca comercial fue registrada a finales del siglo XIX por los laboratorios Bayer, es uno de los fármacos más identificados con su fabricante
En 1938, la empresa Temmler desarrolló pervitin, un tipo de metanfetamina, ampliamente usada por el ejército alemán para aumentar la resistencia y reducir el sueño entre las tropas. Fue un producto simbólico de esta época, aunque su uso se prolongó hasta 1988.
Tras la II Guerra Mundial, I.G. Farben se disolvió. En 1951, Bayer AG vivió su refundación y, en 1946, Grünenthal (originalmente Chemie Grünenthal) fue el primer laboratorio en comercializar penicilina en Alemania, tras levantarse su prohibición. Fue clave para combatir infecciones durante la posguerra.
En los años 50, Grünenthal lanzó la talidomida (Contergan) como calmante para las náuseas en embarazadas. Sin embargo, provocó severas malformaciones y miles de muertes en todo el mundo. En 1961 la asociación entre la talidomida y sus efectos teratogénicos se confirmó, provocando reformas globales en la regulación farmacéutica.
En 1960 se lanzó “Anovlar”, la píldora anticonceptiva europea de los laboratorios Schering, hoy integrados en la división de Healthcare de Bayer, revo-
La posguerra vio el auge de empresas como Boehringer Ingelheim, fundada en 1885, que en 1955 amplió sus líneas hacia la salud animal, y más tarde instaló grandes plantas de productos biotecnológicos
lucionando la salud reproductiva y marcando un hito en la llamada liberación de la mujer.
Diversificación, productos genéricos y suministros hospitalarios
La posguerra vio el auge de empresas como Boehringer Ingelheim, fundada en 1885, que en 1955 amplió sus líneas hacia la salud animal, y más tarde instaló

Bien entrado el siglo XXI, la biotecnología se hizo un hueco en los laboratorios farmacéuticos, pero fue en Alemania donde surgieron dos vacunas a la pandemia de coronavirus basados en ARN mensajero. Comirnaty, la denominación de una de ellas, fue desarrollada por los laboratorios BioNTech, con sede en Maguncia, en el oeste del país
grandes plantas de productos biotecnológicos, como la de Biberach en 1986.
En 1970, Stada entró en el mercado de genéricos, con expansión real en la década de 1990. Hoy es uno de los principales fabricantes de medicamentos genéricos en Europa.
Fresenius, con orígenes en 1912, se expandió en nutrición parenteral, soluciones intravenosas y hemodiálisis. En las décadas de 1980 y 1990 amplió su catálogo con bolsas de nutrición, jeringas, y sistemas de infusión para hospitales.
Avances en biofarmacéutica y biosimilares
En los últimos 30 años, Alemania ha liderado la investigación y la innovación en biotecnología, con la construcción de plantas de producción de biofármacos en Boehringer Ingelheim (Biberach); Stada, Fresenius Kabi y otros fabrican biosimilares en Europa. Fresenius lanzó su primer biosimilar en 2019.
Temmler se convirtió en uno de los principales fabricantes por contrato en Europa, habilitando instalaciones conforme a normas GMP y FDA desde 2005.
En junio 2025, la alemana XL-protein se asoció con la española Grífols para desarrollar biofármacos con tecnología PASylation, que prolonga la vida media de proteínas terapéuticas.
Regulación y lecciones aprendidas de cara al futuro
La catástrofe de la talidomida llevó en la década de 1960 a endurecer los controles de farmacovigilancia, introduciendo ensayos clínicos más rigurosos. Alemania también impulsó normas europeas de buenas prácticas de fabricación (GMP) y regulaciones más estrictas en la producción y comercialización de fármacos.
Hoy, con más de 90.000 empleados en Bayer, 54.000 en Boehringer Ingelheim

y miles en empresas como Stada, Fresenius y Grünenthal, Alemania sigue siendo una potencia farmacéutica mundial. El enfoque se centra ahora en:
- Biotecnología: anticuerpos, terapias génicas, PASylation
- Biosimilares para abaratar medicinas biológicas
- Contratos globales de fabricación (CMO)
- Medicina personalizada con base molecular.
La colaboración público-privada y la inversión en I+D en Alemania siguen siendo clave para mantener la competitividad y liderar nuevos tratamientos.
La lección de la pandemia de coronavirus
La irrupción en 2020 de la enfermedad cardiorrespitratoria covid-19, que hizo que la Organización Mundial de la Salud declarara la situación de pandemia a escala mundial con lo que se conoció con el nombre genérico de coronavirus, hizo que la industria farmacéutica alemana se pusiera manos a la obra. Dos laboratorios lideraron la investigación, con diferentes resultados.
La posguerra vio el auge de empresas como Boehringer Ingelheim, fundada en 1885, que en 1955 amplió sus líneas hacia la salud animal, y más tarde instaló grandes plantas de productos biotecnológicos
La empresa BioNTech, fundada en 2008, desarrolló junto con Pfizer la vacuna de ARN mensajero (ARNm) BNT162b2 (Comirnaty), la primera autorizada (en Estados Unidos y Reino Unido) en diciembre de 2020, que alcanzó un 95 % de eficacia en ensayos clínicos, consolidando a BioNTech como pionera global.
La producción masiva en Alemania se planteó el objetivo de fabricar hasta 1.000 millones de dosis anuales. Tuvo respaldo estatal y un plan de contingencia a través del cual el Gobierno alemán entregó hasta 375 millones de EUR para acelerar el desarrollo y la producción, y entró en un acuerdo para
garantizar capacidad ante futuras pandemias junto a otras firmas. Más allá de la covid-19, BioNTech planeó desarrollar vacunas ARNm para malaria, cáncer e infecciones.
Por su parte, CureVac desarrolló la vacuna CVnCoV tras iniciar ensayos clínicos en junio de 2020 con 36.500 participantes en sus tres primeras fases. Inicialmente prometedora, la vacuna mostró solo alrededor del 47 % de eficacia en la tercera fase, lo que llevó a cancelar el desarrollo primario, pese a que el Gobierno alemán invirtió 300 millones de EUR para apoyarlo. Posteriormente, CureVac se reorientó hacia vacunas de segunda generación (CV2CoV) y otras terapias, incluidas las destinadas a luchar contra el cáncer.
Desde los colorantes sintéticos del siglo XIX hasta la biotecnología avanzada del siglo XXI, la historia de los laboratorios farmacéuticos en Alemania es un reflejo del progreso científico y de las lecciones aprendidas. Productos emblemáticos como la aspirina, prontosil, penicilina, talidomida y biosimilares han transformado —y, en algunos casos, reformado— el mundo. Hoy, la innovación continúa con vistas a fármacos más efectivos, seguros y accesibles.
En su XVII edición, la Plataforma Tecnológica y de Innovación de Química Sostenible SusChem España ha reconocido el trabajo de tres jóvenes investigadores en distintos ámbitos de la química y afines con los Premios SusChem. Estos galardones tienen como objetivo distinguir el talento emergente, los logros y proyección de los jóvenes investigadores que desarrollan su labor científica en los diferentes ámbitos de la química en España.

Los galardones cuentan con una dotación de 10.000 EUR y se convocan en tres categorías: Futura, al mejor expediente académico de grado en química o ámbitos afines; Investiga, a la mejor publicación científica en cualquier área de la química, e Innova-Miguel Burdeos, al mejor trabajo desarrollado a partir de una colaboración público-privada en el ámbito de la química sostenible.
La Plataforma Tecnológica y de Innovación de Química Sostenible SusChem-España, gestionada por Feique, ha anunciado los ganadores de la decimoséptima edición de los Premios SusChem 2025. Estas distinciones buscan reconocer y fomentar la actividad científica y divulgativa de los investigadores de menos de 40 años que desarrollan su labor en las áreas de la química y disciplinas afines y que contribuyen a la generación de soluciones tecnológicas innovadoras y sostenibles para alcanzar los objetivos de circularidad y neutralidad climática.
Este año hubo más de 70 candidaturas de un altísimo nivel en las tres categorías de los premios, muestra del gran talento con el que cuentan las nuevas generaciones de la investigación en España.
Los galardones los convoca SusChem – España y están promovidos por la Federación Empresarial de la Industria Química Española (Feique), la Asociación Nacional de Químicos e Ingenieros Químicos de España (ANQUE), la Conferencia Española de Decanos de Químicas (CEDQ), el Salón Internacional de la Química Expoquimia, el Foro Química y Sociedad y Tecnalia Ventures.
El jurado de expertos de este año lo formaron Carmen Cartagena (ANQUE), Belén Yélamos (CEDQ), Antonio Chica (CSIC), Beatriz Fernández (Expoquimia), Cristina González (Feique), Gabriel González (OEPM), Sonia Guri (SusChem España) y Jesús Torrecilla (Tecnalia Ventures). Durante su deliberación, el jurado quiso resaltar el alto nivel de las candidaturas presentadas, augurando un futuro brillante para la química en España.
Los jóvenes investigadores premiados en la XVI edición son:
- Categoría Futura, premio al mejor expediente académico de grado de química o cualquier otro relacionado con la ciencia y las tecnologías químicas y cuyo título se hubiera obtenido en 2024. Dotación: 2.000 EUR y un año de afiliación a SusChem-España y a ANQUE.
El jurado, presidido por Carmen Cartagena (ANQUE), decidió otorgar este galardón por unanimidad y debido a su brillante trayectoria académica a Miguel López León, graduado en Química por la Universidad de Córdoba.
El jurado declaró finalistas -por unanimidad- a Maykell Suárez Padrón, graduado en Química por la Universidad de La Laguna, y a Marina Crespo Delgado, graduada en Ingeniería Química por la Universidad Complutense de Madrid.
- Categoría Investiga. premio al autor de la mejor publicación científica, con número de página de 2024, en cualquier área de la química, y que estuviera en posesión del título de doctor a 31 de diciembre de 2024. Dotación: 3.000 EUR y un año de afiliación a SusChem- España y a ANQUE.
El jurado, presidido por Cristina González (Feique), decidió otorgar este galardón a Javier Mateos López, doctor en Química Orgánica por la Universidad de Padua, por su trabajo Nitrate reduction enables safer aryldiazonium chemistry, desarrollado en el Max-Planck-Institut für Kohlenforschung.
El jurado declaró finalistas -por unanimidad- a Jordi Ballesteros Soberanas, doctor en Química Sostenible, por su publicación A MOF-supported Pd1-Au-1 dimer catalyses the semihydrogenation reaction of acetylene in ethylene with a nearly barrierless activation energy, desarrollada en el Instituto de Tecnología Química (ITQ) de la Universidad Politécnica de Valencia, y a Juan Pellico Sáez, doctor en Química, por su trabajo In vivo
Creada en 2005, SusChem España es la Plataforma Tecnológica y de Innovación de Química Sostenible, entidad promovida por la Federación Empresarial de la Industria Química Española (FEIQUE), la Federación Española de Centros Tecnológicos (FEDIT), la Asociación Española de Bioempresas (ASEBIO) y Tecnalia, que tiene como objetivos fomentar el desarrollo de la investigación y la innovación en el campo de la química, contribuir a la implementación de los objetivos generales de la estrategia estatal de innovación, canalizar la transferencia de la I+D+i al mercado para la generación de empleo y de empresas innovadoras, así como apostar por la incorporación del talento investigador al tejido productivo.
La Asociación Nacional de Químicos e Ingenieros Químicos de España (ANQUE), fundada en 1945 por un grupo de compañeros que sintieron la necesidad de unirse para fortalecer la profesión y la imagen de la Ciencia y de la Tecnología Química en nuestro país. Ha devenido una asociación de prestigio con más de 6.000 asociados, siendo la asociación de químicos más numerosa de nuestro país y la mejor implantada en todas las comunidades autónomas. En el plano internacional ocupa la tercera posición en liderazgo a escala europea después de las sociedades británica y alemana. Sus líneas de actuación prioritarias buscan elevar el nivel científico y profesional de los profesionales de la química en España, así como conseguir que la profesión disfrute de un mayor calor social y sensibilidad política. La ANQUE aspira naturalmente a impulsar la actuación de los químicos en España en todos los ámbitos -científico, técnico, social, económico y cultural-, así como en el plano internacional.
real-time positrón emisión particle tracking (PEPT) and single particle PET, desarrollado en el King’s College de Londres.
- Categoría Innova-Miguel Burdeos, premio al mejor trabajo desarrollado a partir de una colaboración público-privada. El trabajo presentado debe haber generado resultados en los tres últimos años en cualquier área relacionada con la Química Sostenible, incluidos trabajos sobre la transición hacia la economía circular y la descarbonización. Dotación: 5.000 EUR, un año de afiliación a SusChem-España y a ANQUE, y la posibilidad de disfrutar de una estancia en los laboratorios de investigación de química aplicada de Tecnalia o una mentorización por parte de los equipos de Tecnalia Ventures, enfocada a mejorar sus capacidades en el ámbito de emprendimiento tecnológico.
El jurado, presidido por Sonia Guri (SusChem-España), decidió otorgar -por unanimidad- este galardón a Tomás Ramírez Reina, doctor en Química, por sus prometedores resultados en el proyecto Nicer Biofuels, desarrollado en la Universidad de Zaragoza, en colaboración con Urbaser.
El jurado declaró finalistas -por unanimidad- a María de los Ángeles Moreno Fernández, doctora en Física, por su trabajo Fabricación de un stack de pila de combustible de tipo PEMFC de hasta 10 kW, desarrollado en la Universidad de Huelva en colaboración con Protio Power, S.L., y a Claudia Giménez Campillo, doctora en Química Básica y Aplicada, por su trabajo Nuevos ingredientes para reducir el riesgo asociado a carne roja y procesada, desarrollado en la Universidad de Murcia en colaboración con Empresa Productos del Sur, S.A.
www.feique.org
www.anque.es
AACC
(véase The American Association for Clinical Chemistry)
Acofesal
Príncipe de Vergara, 91, 2º A 28006 Madrid
Tel.: +34 91 128 90 07
Fax: +34 91 655 98 46
E-mail: acofesal.formacion@acofesal.org www.acofesal.org
ADECÚA
Asociación Española de Empresas de Ensayos, Inspección y Certificación
Calle Gran Vía 78, 5 Izda. 28013 Madrid
E-mail: info@asociacionadecua.com www.asociacionadecua.com
AEAS
Asociación Española de Abastecimientos de Agua y Saneamiento Sor Ángela de la Cruz, 2, Pl. 13ª D 28020 Madrid
Tel.: +34 914 490 910
E-mail: fmorcillo@aeas.es www.aeas.es
AEC
Asociación Española de Científicos Apartado de Correos 36500 28080 Madrid www.aecientificos.es
AEC
Asociación Española para la Calidad
Claudio Coello, 92 28006 Madrid
Tel.: +34 915 752 750
Fax: +34 915 765 258
E-mail: aec@aec.es www.aec.es
AECIC
Asociación Española de Compañías de Investigación Clínica www.aecic.org
AEGIC
Asociación Española de Grupos Empresariales de Inspección y Certificación
Castelló, 59 28001 Madrid
Tel.: +34 91 432 32 61 www.aegic.es
AEIH
Asociación Española de Ingeniería Hospitalaria
Serrano, 76, 7º dcha. 28006 Madrid
Tel.: +34 913 86 35 69
E-mail: secretaria@aeih.org www.aeih.org
AELI
Asociación Española de Laboratorios Independientes Alenza, 1 28003 Madrid
Tel.: +34 91 399 01 74
E-mail: aeli@felab.org www.aeli.org
AENOR
Asociación Española de Normalización y Certificación
Génova, 6 28004 Madrid
Tel.: +34 914 32 60 00
Fax: +34 913 10 36 95
E-mail: comercial@aenor.es www.aenor.es
AEQT
Associació Empresarial Química de Tarragona
Av. Marquès de Montoliu, 2, ent. 43002 Tarragona
Tel. +34 977 252 308
E-mail: aeqt@aeqtonline.com www.aeqtonline.com
AETEL
Asociación Española de Técnicos de Laboratorio
Mayor, 6 - 1º, local 3 28013 Madrid
Tel.: +34 915 225 197*
Fax: +34 915 214 641
E-mail: madrid@aetel.es www.aetel.es
AFAQUIM
Asociación Española de Fabricantes de Química para la Salud Marquès de Sentmenat, 54-58 (Les Corts)
08029 Barcelona
Tel.: +34 934 85 20 86 www.afaquim.org
AFOP
Syndicat Professionnel OptiquePhotonique
185 rue de Bercy
75012 París (Francia)
Tel.: +33 01 43 46 27 49
Fax: +33 01 43 46 27 58
E-mail: contact@afoptique.org www.afoptique.org
ALA: véase (The) Association for Laboratory Automation
Agencia Española del Medicamento y Productos Sanitarios AEMPS
Campezo, 1, Edificio 8 28022 Madrid www.aemps.gob.es
ALDA
Analytical, Life Science & Diagnostics Association
1800 Diagonal Road, Suite 600 Alexandria, VA 22314 (Virginia, EE.UU.A.)
Tel.: +1 703.647.6214
Fax: +1 703.647.6368 www.thealda.org
ANQUE
Asociación Nacional de Químicos de España
Lagasca, 27, 1º E 28001 Madrid
Tel.: +34 91 431 07 03
Fax: +34 91 576 52 79
E-mail: anquejg@anque.es www.anque.es
Anses
Agence Nationale de Sécurité Sanitaire
- 14 rue Pierre et Marie Curie 94701 Maisons-Alfort Cedex (Francia)
Tel.: 01 49 77 13 50
- 6 boulevard Bassin Napoléon 62200 Boulogne-sur-Merm (Francia)
Tel.: 03 21 99 25 00
E-mail: contact.LSAL@anses.fr www.anses.fr
ASEBIO
(Asociación Española de Bioempresas)
Príncipe de Vergara, 55, 5º B
28006 Madrid
Tels.: +34 91 210 93 10 / 74
Fax: +34 91 250 00 63
E-mail: secretariageneral@asebio.com www.asebio.com
Asociación Española de Ensayos No Destructivos
Bocángel, 28, 2º izda. 28028 Madrid
Tel.: +34 91 361 25 85
Fax: +34 91 361 47 61
E-mail: informacion@aend.org www.aend.org
Asociación Española de Normalización, UNE E-mail: comunicacion@une.org www.une.org
Association for Laboratory Automation
800572 Health Sciences Center University of Virginia Charlottesville, Virginia 22908 (EE. UU.A.)
Tel.: +1 804 924 94 30
Fax: +1 804 924 5718 www.labautomation.org
Asociación NOTIO
Centro Tecnológico de Actividades de la Construcción (CTAC)
Río Cabriel, s/n 45007 Toledo
Tels.: +34 925 24 11 62 / 630 96 87 86
E-mail: info@notio.es www.notio.es
Atlantic Biotherapies
Château de la Chantrerie
B.P. 90702
44307 Nantes CEDEX 3 (Francia)
Tel.: +33 240 252 256
Fax: +33 240 251 088
E-mail:
cluster@atlantic-biotherapies.com www.atlantic-biotherapies.com
BioEuroLatina
Promoción de la biotecnología en Latinoamérica en cooperación con Europa www.bioeurolatina.com
BIOIB
Clúster Biotecnològic i Biomèdic de les Illes Balears
Edificio Europa, bajos, Parc BIT 07121 Palma (Islas Baleares)
Tels.: +34 664 441 083 / 871 230 022
E-mail: cluster@bioib.org
E-mail: gerencia@bioib.org www.bioib.org
BIPM
Bureau International des Poids et Mesures
Pavillon de Breteuil
F-92312 Sèvres CEDEX (Francia)
Tel.: +33 1 45 07 70 70
Fax: +33 1 45 34 20 21 www.bipm.org
BLWA
Association of the Laboratory Supply Industry
St George’s House
195-203 Waterloo Road
London SE1 8WB (Reino Unido)
Tel.: +44 20 7207 9666
Fax: +44 20 7207 9659
E-mail: blwa@blwa.co.uk www.martex.co.uk/blwa
British Mass Spectrometry Society
Orchard House, 172 High Street, Yelling,
St Neots, PE19 6SD (Reino Unido)
Tel.: +44 01480 880 669
E-mail: BMSSadmin@btinternet.com www.bmss.org.uk
CADIAC
Cámara del Instrumental y Aparatos de Control
Paraná 597 - Piso 4º Of. 27 C1417AAK C.A.B.A. Buenos Aires (Argentina)
Tel. / Fax: +54 11 4372-9704
E-mail: info@cadiac.com.ar www.cadiac.com.ar
CED: véase Comité Español de la Detergencia, Tensioactivos y Afines
CEFIC
The European Chemical Industry Council, AISBL
Belliard, 40 1040 Bruselas (Bélgica)
Tel.: +32 2 436 93 00 www.cefic.org
Centro Nacional de Biotecnología
Campus de la Universidad Autónoma de Madrid
Ctra. de Colmenar Viejo, km 15,500 28049 Cantoblanco (Madrid)
Tel.: +34 91 585 45 00
Fax: +34 91 585 45 06 www.cnb.uam.es
Centro Nacional de Tecnología y Seguridad Alimentaria (CNTA)
Ctra. Nal. 134, km 53 31570 San Adrián (Navarra)
Tel.: +34 948 670 159
Fax: +34 948 696 127
E-mail: cnta@cnta.es www.cnta.es
CIFL
Comité Interprofessionel des Fournisseurs du Laboratoire
28, rue St Dominique
F - 75007 París (Francia)
Tel.: +33 (0) 1 44 18 98 62
Fax: +33 (0)1 44 18 98 63 www.cifl.com
CIMA (China Instrument Manufacturers Association)
China. No26 Yue Tan, Nan Jie
Beijing 100825 China
Tel.: +86 10 88395128
Fax: +86 10 88395130
E-mail: cima@cima.org.cn www.cima.org.cn
Clinical and Laboratory Standards Institute (antes NCCLS) 940 West Valley Road, Suite 1400 Wayne, PA 19087-1898 USA
Tel.: +1 610 688 0100
Fax: +1 610 688 0700
E-mail: CustomerService@clsi.org www.clsi.org
Club Español del Medio Ambiente
Ríos Rosas, 19 28003 Madrid
Tel.: +34 91 441 46 11
Fax: +34 91 442 61 09
E-mail: cema@iies.es www.clubcema.org

CNTA: véase Centro Nacional de Tecnología y Seguridad Alimentaria
COLABIOCLI
Confederación Latinoamericana de Bioquímica Clínica
Antezana, 847
Edificio Torre Atlanta, piso 4, Of. 11 Cochabamba (Bolivia)
E-mail: colabiocli2019.2021Bol@gmail.com www.colabiocli.com
COLIPA
(Asociación Europea de Perfumería, Higiene y Cosmética)
Avenue Herrmann Debroux 15A
B-1160 Auderghem - Bruselas (Bélgica)
Tel.: +32 2 227 66 10
Fax: +32 2 227 66 27
E-mail: colipa@colipa.be www.colipa.com
Comité Español de la Detergencia, Tensioactivos y Afines (CED)
Tels.: +34 93 204 02 12, 34 93
400 61 00 - Ext. 290
Fax: +34 93 280 53 00; 34 93 204 49 04
E-mail: ced@jornadasced.com www.jornadasced.com
Consejo Europeo de la Industria Química (CEFIC, The European Chemical Industry Council) Belliard, 40 1040 Bruselas (Bélgica) www.cefic.org
Consejo General de Colegios
Oficiales de Químicos de España
C/ Lagasca, 27 28001 Madrid
Tel. +34 912 141 863
E-Mail: secretariapc@cgquimicos.es www.cgquimicos.com
CSIC
Consejo Superior de Investigaciones Científicas
Instituto de Química Orgánica
General
C/ Juan de la Cierva, 3 28006 Madrid
Tel.: +34 91 562 29 00
Fax: +34 91 564 48 53 www.csic.es
CTQ
Centro Tecnológico de la Química
Carrer de Marcel·lí Domingo, 2 43007 Tarragona
Tel.: +34 977 29 70 17
Fax: +34 977 29 79 54
www.ctqc.org
Dechema
Gesellschaft für Chemische Technik und Biotechnologie e.V.
Theodor-Heuss-Allee 25
D-60486 Frankfurt am Main (Alemania) (Apartado 15 01 04
D-60061 Frankfurt am Main)
Tel.: +49 69 75 64-0
Fax: +49 69 75 64-201
E-mail: info@dechema.de www.dechema.de
EFCG
European Fine Chemicals Group
E-mail: info@efcg.cefic.org www.efcg.cefic.org
EGNATON
(Europäische Gesellschaft für Nachhaltige Labortechnologien e.V., Asociación Europea para la Tecnología Sostenible de Laboratorio)
Mühltalstrasse 61
64625 Bensheim (Alemania)
Tel.: +49 6251-704720
Fax: +49 6251-7047220
E-mail: info@egnaton.com www.egnaton.com
ENAC
Entidad Nacional de Certificación Serrano, 240, 4 planta 28016 Madrid
Tel. +34 91 457 32 89
E-mails: enac@enac.es (Asociados); administracion@enac.es (Administración); auditores@enac.es (Auditores); campus@enac.es (Campus ENAC); calidad@enac.es (Calidad); soporte_sgd@enac.es (Centro de Soporte sEgNAC); secent@enac. es. (entidades acreditadas o en proceso de serlo) www.enac.es
ESBES
European Society of Biochemical Engineering Sciences www.esbes.org
Eurachem www.eurachem.org
EuroLabAutomation 4 Rivercourt Trinity Street Oxford, OX1 1TQ (Reino Unido)
Tel.: +44 1865 723 885
Fax: +44 1865 203 885
E-mail: eurolab2001@aol.com www.eurolabautomation.org
EUROLAB aisbl
Rue du Luxembourg, 3 B-1000 Bruselas (Bélgica)
Tel.: +32 2 502 86 98
Fax: +32 2 502 86 93 www.eurolab.org
EUROLAB España
Ríos Rosas, 21 28003 Madrid
Tel.: +34 609 540 904
Fax: +34 91 441 99 33
E-mail: ssantalla@teleline.es
EUROM
c/o SPECTARIS e.V. Werderscher Markt 15 D-10117 Berlín (Alemania) www.eurom.org
European Nanotechnology Trade Alliance (ENTA) Garscube Technology Complex Garscube Estate, Bearsden Road Glasgow G61 1QH (Reino Unido)
Tel.: +44 141 330 2143
Fax: +44 141 330 2144
E-mail: info@euronanotrade.com www.euronanotrade.com
Exportlab Supplies, S.L. J. V. Foix, 33 08034 Barcelona
Tel.: +34 93 633 17 53
Fax: +34 93 486 31 16
E-mail: sales@exportlab.com www.exportlab.com
Fabrilabo
Chambre Syndicale des Fabricants et Négociants D’Appareils de Laboratoire - Federación de Cooperativas de los fabricantes y distribuidores de equipos de laboratorio de Francia 45 rue Louis Blanc Cedex 72
92038 París La Défense (Francia)
Tel.: +33 1 47 17 64 05
Fax: +33 1 47 17 64 81
E-mail: contact@fabrilabo.com www.fabrilabo.com
FACCS
Federation of Analytical Chemistry and Spectroscopy Societies www.facss.org
Federación Empresarial de la Industria Química
Española (FEIQUE)
Hermosilla, 31 28001 Madrid
Tel.: +34 91 431 79 64
Fax: +34 91 576 33 81
E-mail: feique@interbook.net www.feique.org
Federación Española de Entidades de Innovación y Tecnología (FEDIT)
Juan Ramón Jiménez, 43, 1º izda. 28036 Madrid
Tel.: +34 91 350 28 75.
Fax: +34 91 350 53 71
E-mail: informacion@fedit.es www.fedit.es
Federation of Analytical Chemistry and Spectroscopy Societies
1201 Don Diego Avenue, Santa Fe NM 87505 (EE.UU.A.)
Tel.: +1 (856) 224-4266
E-mail: jsjoberg@trail.com www.facss.org
FEDIT: véase Federación Española de Entidades de Innovación y Tecnología
FEIQUE: véase Federación Empresarial de la Industria Química Española
FELAB
Asociación de Entidades de Ensayo, Calibración y Análisis Alenza, 1 28003 Madrid
Tel.: +34 91 399 01 74 / +34 647 666 817
Fax: +34 91 399 01 74
E-mail: gerente@felab.org www.felab.org
FHI
Federation of Technology Branches Postbus 366
3830 AK Leusden (Países Bajos)
Tel.: +31 033 465 75 07
Fax: +31 033 461 66 38
E-mail: info@fhi.nl www.fhi.nl
FIDA
Fundación para la Investigación y Desarrollo Ambiental Sagasta, 13, 3º dcha.
28004 Madrid
Tel.: +34 91 593 41 62
Fax: +34 91 593 45 89
E-mail: fida@fida.es www.fida.es
Finnish Chemical Society www.suomalaistenkemistienseura.fi
FLUIDEX
Edificio Albia I
San Vicente 8, 3º, Dpto. 5C
48001 Bilbao
Tel.: +34 94 607 46 63
E-mail: fluidex@fluidexspain.com www.fluidexspain.com
GAIKER Centro Tecnológico
Parque Tecnológico, Edificio 202 48170 Zamudio (Bizkaia)
Tel.: +34 94 600 23 23
Fax: +34 94 600 23 24
E-mail: mark@gaiker.es www.gaiker.es
GAMBICA Association Ltd.
Asociación inglesa de técnica de medición y regulación, técnica de automatización y técnica de laboratorios
Broadwall House, 21 Broadwall London SE1 9PL (Reino Unido)
Tel.: +44 (0) 20 7642 8080
Fax: +44 (0) 20 7642 8096
E-mail: assoc@gambica.org.uk www.gambica.org.uk
IAF
International Accreditation Forum Box 1811
Chelsea Quebec J9B 1A1 (Canadá)
Tel.: +1 (613) 454-8159 https://iaf.nu
IAIA
Indian Analytical Instruments Association
No.205, Solaris I, Saki Vihar Road
Powai, Mumbai – 400 072 (India)
Tel.: +91-9967061333
Fax: +91-22-25563356
E-mail: iaia@rediffmail.com www.iaia.org.in
ICIQ
Institut Català d’Investigació Química
Av. Països Catalans, 16 43007 Tarragona
Tel.: +34 977 92 02 00
Fax: +34 977 92 02 24 www.iciq.es
IDAE
Instituto para la Diversificación y Ahorro de la Energía
Pº de la Castellana, 95, Pta. 21
28046 Madrid
Tel.: +34 91 456 49 00
Fax: +34 91 555 13 89
E-mail: comunicacion@idae.es www.idae.es
IFCC
International Federation of Clinical Chemistry and Laboratory Medicine
E-mail: ifcc@ifcc.org www.ifcc.org
iGEM
International Genetically Engineered Machine iGEM Foundation
45 Prospect Street, 02139 Cambridge MA, USA
iGEM Europe
10 rue du Mail, 75002 Paris, France www.igem.org
IIR
Institute for International Research
IIR Bressenden Place
London, SW1E 5DR (Reino Unido)
Tel.: +44 20 7915 5070
Fax: +44 20 1915 5001
E-mail: vansell@iir-conferences.com www.iir-pharma.com
ILAC
International Laboratory Accreditation
Cooperation
The ILAC Secretariat c/o NATA PO Box 7507
Silverwater NSW 2128 (Australia)
Tel.: +61 2 9736 8374
Fax: +61 2 9736 8373
E-mail: ilac@nata.asn.au www.ilac.org
INASMET
Mikeletegi Pasealekua, 2
Parque Tecnológico / Teknologi
Parkea
20009 Donostia - San Sebastián
Tel.: +34 943 00 37 00
Fax: +34 943 00 38 00 www.inasmet.es

International Genetically Engineered Machine
iGEM Foundation
45 Prospect Street, 02139 Cambridge MA, USA
iGEM Europe
10 rue du Mail, 75002 Paris, France www.igem.org
INVEMA
Parque Tecnológico de San Sebastián
Paseo Mikeletegi, 59
20009 Donostia - San Sebastián
Tel.: +34 943 30 90 07
Fax: +34 943 30 90 08
E-mail: invema@invema.es
ISBER
International Society for Biological and Environmental Repositories 1618 Station Street
Vancouver, BC, V6A1B6 (Canada)
Tel.: 1-604-484-5693
Fax: 1-604-874-4378
e-mail: info@isber.org www.isber.org
Istituto del Colore Via Garegnano, 32
20156 Milán (Italia)
Tel.: +39 02 38008385
Fax: +39 02 38003781
E-mail: info@istitutocolore.it www.istitutocolore.it
JAIMA
Japan Analytical Instruments Manufacturers’ Association 1-12-3, Kanda Nishiki-cho, Chiyoda-ku
Tokyo, 101-0054 (Japón)
Tel.: +81-3-3292-0642
Fax: +81-3-3292-7157
E-mail: webmaster@jaima.or.jp www.jaima.or.jp/en/
LabAutomation
Palm Springs, CA Association for Laboratory Automation www.labautomation.org
Labmas Laboratory Manufacturers Association of Spain
Camí de Can Calders, 14 08173 Sant Cugat del Vallès (Barcelona)
Tel.: +34 933 801 739
E-mail: labmas@labmas.es www.labmas.es
Labson
Oil Hydraulic and Pneumatic Systems Lab
E.T.S. d’Enginyeries Industrial i Aeronàutica de Terrassa (UPC)
Campus Terrassa
Departament de Mecànica de Fluids
Edifici TR4, planta 0 Colom, 11
08222 Terrassa (Barcelona)
Tel.: +34 739 86 64
Fax: +34 93 739 89 88
E-mail: contijoc@mf.upc.edu www.upclabson.com
LGAI
Laboratori General d’Assaigs i Investigacions
Tel.: +34 900 10 30 67 www.applus.com/appluslgai
LPA
Laboratory Products Association
Dirección postal: Laboratory Products Association P.O. Box 428 Fairfax, VA 22038 (EE.UU.A.)
También: 5618 Ox Rd., Suite C Fairfax, VA 22039 (EE.UU.A.)
Tel.: +1 (703) 836-1360
Fax: +1 (703) 836-6644 www.lpanet.org
MATGAS
Campus UAB 08193 Bellaterra (Barcelona)
Tel.: +34 93 592 99 50
Fax: +34 93 592 99 51
E-mail: matgas@carburos.com www.matgas.com
NCCLS: véase Clinical and Laboratory Standards Institute
QUIMICOVA
Asociación de Empresas Químicas y Medioambientales de la Comunidad Valenciana
Tels. +34 96 351 86 19; +34 606
888 721; +34 655 477 110
Fax: +34 960 618 174
E-mail: info@quimacova.org www.quimacova.org
Real Sociedad Española de Química (RSEQ) Facultad de Ciencias Químicas Universidad Complutense de Madrid
Ciudad Universitaria, s/n 28040 Madrid
Teléfono: +34 91 394 43 61
Fax: +34 91 543 38 79
E-mail: RSEQUIM@RECT.UCM.ES www.rseq.org
RIC Group
President Kennedypark 26 8500 Kortrijk (Bélgica)
Tel.: +32 (0) 56 20 40 31
Fax: +32 (0) 56 20 48 59
E-mail: info@RIC-group.com www.ric-group.com
Royal Microscopical Society
37/38 St Clemens
Oxford OX4 1AJ (Reino Unido)
Tel.: +44 1865 248 768
Fax: +44 1865 791 237 www.rms.org.uk
RSEQ: véase Real Sociedad Española de Química
SAS Society for Applied Spectroscopy https://www.s-a-s.org
SECPhO
Southern European Cluster in Photonics and Optics Espai Catalonia Clusters C/ Milà i Fontanals 14-26, 1º - 6ª 08012 Barcelona
Tel.: +34 937 83 36 64
E-mail: info@secpho.org www.secpho.org
SECyTA
(Sociedad Española de Cromatografía y Técnicas Afines)
E-mail: mario@iqog.csic.es www.secyta.org
SEEM
(Sociedad Española de Espectrometría de Masas) Departamento de Química Analítica Universidad de Barcelona Diagonal, 647, 3ª pl. 08028 Barcelona
Tel.: +34 93 402 1286 Fax: +34 93 402 1233
E-mail: secretaria@e-seem.org www.e-seem.org
SEMAT
(Sociedad Española de Materiales)
Av. Gregorio del Amo, 8 28040 Madrid
Fax: +34 91 534 74 25
E-mail: avazquez@fresno.csic.es
SEQA
(Sociedad Española de Química Analítica) www.seqa.es
SEQC
(Sociedad Española de Químicos Cosméticos)
Pau Claris, 107, Pral. 08009 Barcelona
Tel.: +34 934 881 808
E-mail: info@e-seqc.org www.e-seqc.org
SLAS
Society for Laboratory Automation and Screening 1301 West 22nd Street, Suite 708 Oak Brook, IL 60523 USA E-mail: slas@slas.org www.slas.org
Sociedad Española de Bioquímica Clínica y Patología Molecular Padilla, 323, despacho 68 08025 Barcelona
Tel.: +34 93 446 26 70
Fax: +34 93 446 27 72 www.seqc.es
Sociedad Española de Bioquímica y Biología Molecular Vitruvio, 8 28006 Madrid
Tel.: +34 91 561 33 81
Fax: +34 91 561 32 99
E-mail: bmsgr04@fresno.csic.es http://sebbm.es/
Sociedad Española de Química Analítica www.seqa.es
Sociedad Española de Químicos Cosméticos
Pau Claris, 107, Pral. 08009 Barcelona
Tel.: +34 934 881 808
E-mail: info@e-seqc.org www.e-seqc.org
AGENDA
Spectaris
(Asociación de la industria alemana de óptica, fotónica, analítica y tecnología médica)
Saarbrücker Straße 38
D-10405 Berlín (Alemania)
Tel.: +49 (0)30 41 40 21-0
Fax: +49 (0)30 41 40 21-33
E-mail: info@spectaris.de www.spectaris.de
SusChem-España
Plataforma Tecnológica Española de Química Sostenible Hermosilla, 31 28001 Madrid
Tel.: +3491 431 79 64
E-mail: info@suschem-es.org www.suschem-es.org
The American Association for Clinical Chemistry (AACC)
900 Seventh Street, NW Suite 400 Washington, DC 20001 (EE.UU.A.)
Tel.: +1 202 857 0717 / 800.892.1400
Fax: +1 202 887 5093 www.aacc.org
The Institute of Nanotechnology Head Office
Suite 5/9 Scion House Innovation Park University of Stirling Stirling, FK9 4NF (Reino Unido)
Tel.: +44 1786 458020
Fax: +44 1786 447530
E-mail: ottilia.saxl@nano.org.uk www.nano.org.uk
The Swedish Chemical Society Wallingatan 24 3 tr
SE-11124 Estocolmo (Suecia)
Tel.: +46 8 411 52 60
Fax: +46 8 10 66 78
E-mail: info@kemisamfundet.se www.chemsoc.se
UDIAS
Unión de Proveedores para el Sector de Laboratorio Udias vzw-asbl
Z.1 Researchpark 310
B-1731 Zellik (Bélgica)
Tel.: +32 (0) 2 481 00 50
Fax: +32 (0) 2 463 17 06
E-mail: info@udias.be www.udias.be
UILI
Union Internationale des Laboratories Indépendants Kon. Emmalaan 3
Postbus 4602
4835 KH, Breda (Países Bajos)
E-mail: info@uili.org www.uili.org
UNE
Asociación Española de Normalización
E-mail: comunicacion@une.org www.une.org
WAITRO
World Association of Industrial and Technological Research Organizations - Fraunhofer-Institutszentrum
Schloss Birlinghoven IZB
Schloss Birlinghoven 1 53757 Sankt Augustin (Alemania)
- Waitro Secretariat
Danish Technological Institute Gregersensvej, PO Box 141, DK-2630 Taastrup (Dinamarca)
Tel.: +45 (43) 50 43 50
Fax: +45 (43) 50 70 50
E-mail: waitro@dti.dk www.waitro.org
XaRTAP
Red de Referencia de I+D+i en Técnicas Avanzadas de Producción
Fundació Privada Centre CIM
Llorenç i Artigas, 12 08028 Barcelona
Tel.: +34 93 401 71 71
Fax: +34 93 401 71 70
E-mail: rroig@cim.upc.edu www.xartap.cat

AACC Annual Scientific Meeting & Clinical Lab Expo (Chicago, Anaheim...)
The American Association for Clinical Chemistry 900 Seventh Street, NW Suite 400 Washington, DC 20001 (EE.UU.A.)
Tel.: +1 202 857 0717 / 800.892.1400
Fax: +1 202 887 5093 www.aacc.org
Achema (Frankfurt) (trienal) Dechema
Deutsche Gesellschaft für Chemisches Apparatewessen, Chemische Technik und Biotechnologie e.V.
Theodor-Heuss-Allee 25 D-60486 Frankfurt am Main (Alemania) (Apartado 15 01 04
D-60061 Frankfurt am Main)
Tel.: +49 69 75 64-0
Fax: +49 69 75 64-201
E-mail: internetinfo@dechema.de www.achema.de
Achema Middle East (Riyadh) www.achema-middle-east. ae.messefrankfurt.com
AchemAsia (Shanghai) (trienal) Dechema
Deutsche Gesellschaft für Chemisches Apparatewessen, Chemische Technik und Biotechnologie e.V.
Theodor-Heuss-Allee 25 D-60486 Frankfurt am Main (Alemania) (Apartado 15 01 04
D-60061 Frankfurt am Main)
Tel.: +49 69 75 64-0
Fax: +49 69 75 64-201
E-mail: internetinfo@dechema.de www.achema.de
Acofesal (itinerante, bienal – años pares) www.acofesal.org
AGBT Advances in Genome Biology and Technology
The Genome Partnership 20 S. Sarah St. Louis, MO 63108 (EE.UU.)
E-mail: leisaz@agbt.org
Tel.: +1 314.615.6360 www.agbt.org
Alimentaria FoodTech (Barcelona) (trienal) Alimentaria Exhibitions Diputació, 119 08015 Barcelona
Tel.: +34 93 452 18 00
Fax: +34 93 452 18 01
E-mail: bta@alimentaria.com www.alimentaria.com www.bta-bcn.com
AnaLabAsia (Singapur) Singapore Exhibition Service Pte Ltd 47 Scotts Road, 11th Floor Goldbell Towers Singapore 22 82 33
Tel.: +65 738 6776
Fax: +65 732 6776
E-mail (expositores): bt@sesallworld.com
E-mail (visitantes): wen@sesallworld.com www.cia-asia.com/analab.htm
Analitica Latin America (São Paulo) NürnbergMesse Brasil Rua Verbo Divino, 1.547 – 7º andar São Paulo-SP, CEP: 04719-002 (Brasil)
Tel.: +55 11 3205-5000
Fax: +55 11 3205-5070
E-mail: analitica@nm-brasil.com.br www.analiticanet.com.br
Analitika Expo (Moscú)
Tel.: +7-(495)-799-55-85
Email: analitikaexpo@ite.group https://analitikaexpo.com/en/
Analytica (Munich) (bienal)
Messe München GmbH Messegelände
D-81823 München (Alemania)
Tel.: +49 89 949-01
Fax: +49 89 949-09
E-mail: info@analytica.de www.analytica.de
En España: Firamunich, S.L.
Av. de Les Corts Catalanes, 2, 1ª pl. local 3
08173 Sant Cugat (Barcelona)
Tel.: +34 934 881 720
Fax: +34 934 881 583
E-mail: info@firamunich.com www.firamunich.com
Analytica Anacon (Hyderabad) (bienal)
Messe München GmbH
Messegelände
D-81823 München (Alemania)
Tel.: +49 89 949-01
Fax: +49 89 949-09
E-mail: info@analytica.de www.analyticaindia.com
En España: Firamunich, S.L.
Av. de Les Corts Catalanes, 2, 1ª pl. local 3
08173 Sant Cugat (Barcelona)
Tel.: +34 934 881 720
Fax: +34 934 881 583
E-mail: info@firamunich.com www.firamunich.com
Analytica China (Shanghai) (bienal)
Messe München GmbH
Messegelände
D-81823 München (Alemania)
Tel.: +49 89 949-01
Fax: +49 89 949-09
E-mail: info@messe-muenchen.de www.analyticachina.com
En España: Firamunich, S.L.
Av. de Les Corts Catalanes, 2, 1ª pl. local 3
08173 Sant Cugat (Barcelona)
Tel.: +34 934 881 720
Fax: +34 934 881 583
E-mail: info@firamunich.com www.firamunich.com
Analytica Lab Africa (Johannesburgo) (bienal)
Messe München GmbH
Messegelände
D-81823 München (Alemania)
Tel.: +49 89 949-01
Fax: +49 89 949-09
E-mail: info@analytica.de www.analytica-africa.com
En España: Firamunich, S.L. Av. de Les Corts Catalanes, 2, 1ª pl. local 3
08173 Sant Cugat (Barcelona)
Tel.: +34 934 881 720
Fax: +34 934 881 583
E-mail: info@firamunich.com www.firamunich.com
Analytica Vietnam
(Ho Chi Minh City) (bienal)
Messe München GmbH
Messegelände
D-81823 München (Alemania)
Tel.: +49 89 949-01
Fax: +49 89 949-09
E-mail: info@analytica.de www.analyticavietnam.com
En España: Firamunich, S.L.
Av. de Les Corts Catalanes, 2, 1ª pl. local 3
08173 Sant Cugat (Barcelona)
Tel.: +34 934 881 720
Fax: +34 934 881 583
E-mail: info@firamunich.com www.firamunich.com
Aqua-Expo (Bruselas)
Feria Internacional de Bruselas
Place de Belgique
B-1020 Bruselas (Bélgica)
Tel.: +32 2 474 84 24
Fax: +32 2 474 83 91
E-mail: fib@ips.be
Arab-Lab (Dubai)
The Domus Group
P.O. Box 74463, Dubai (UAE)
Tel.: +9714-329 0666
Fax: +9714 332 9664
E-mail: info@domusevents.com www.arablab.com
Arab Health (Dubai) www.arabhealthonline.com
Asia Bio Partnering Forum (Singapur) www.informaconnect.com/asia-biopartnering-forum
Biennale des Technologies et des Processus Industriels (París) (bienal)
Comité des Expositions de Paris
55, Quai Alphonse Le Gallo BP 317
92107 Boulogne CEDEX (Francia)
Tel.: +33 1 49 09 60 88
Fax: +33 1 49 09 61 07
E-mail:
industrie@comite-expo-paris.asso.fr www.forumprocess.com
BioAnalytica (Munich) (bienal)
Messe München GmbH Messegelände
D-81823 München (Alemania)
Tel.: +49 89 949-20 650
Fax: +49 89 949-20 659
E-mail: info@bioanalytica.de www.bioanalytica.de
En España:
Firamunich, S.L.
Av. de Les Corts Catalanes, 2, 1ª pl. local 3
08173 Sant Cugat (Barcelona)
Tel.: +34 934 881 720
Fax: +34 934 881 583
E-mail: info@firamunich.com www.firamunich.com
Bio-Europe (Itinerante)
EBD Group
Tel. +49 892 3121 7290
E-mail:
EBDcustomerservice@ebdgroup.com www.informaconnect.com/bioeurope
Bio-Europe Spring (itinerante)
EBD Group Tel. +49 892 3121 7290
E-mail:
EBDcustomerservice@ebdgroup.com www.informaconnect.com/bioeurope-spring
Biolatam (Bogotá)
ASEBIO
Contactos: Esther Campos; David Fernández
Tel.: +34 912 109 37 www.biolatam.org
BioPharm America™ www.ebdgroup.com/bpa
BioSpain www.asebio.com
Biotech (Milán)
Artenergy Publishing Srl info@biotechexpo.eu
Via Antonio Gramsci, 57 20032 Cormano (MI)
Tel.: +39 0266306866
Fax: +39 0266305510
E-mail:
logistica.lifemed@zeroemission.eu www.life-med.com
BioTech Forum + ScanLab (itinerante)
Stockholmsmässan
Stockholm International Fairs
S-125 80 Estocolmo
Tel.: +46 8 749 41 00
Fax: +46 8 749 61 77
E-mail: biotechforum@stofair.se www.stofair.se www.scanlab.nu www.biotechforum.org
Biotechnica/Labvolution (Hannover) (bienal)
Deutsche Messe AG Messegelände
D-30521 Hannover (Alemania)
Tel.: +49 511 89 380 11/12
Fax: +49 511 89 380 03 www.biotechnica.de www.labvolution.de
BioTrinity (Londres)
E-mail: events@obn.org.uk www.biotrinity.com
C&I UK (Control and Instrumentation) (Birmingham) Blenheim Exhibitions & Conferences 630 Chiswick High Rd London W4 5BG (Gran Bretaña)
Tel.: +44 181 742 28 28
Fax: +44 181 742 38 56
Cell & Gene Meeting on the Mediterranean (Roma) www.meetingonthemed.com
ChemBio (Helsinki)
The Finnish Fair Corporation P.O. Box 21
FIN-00521 Helsinki (Finlandia)
Tel.: +358 9 150 91
Fax: +358 9 142 358
E-mail: info@finnexpo.fi www.chembiofinland.fi
ChemE Show – Powered by Achema (Houston) www.cheme-show.com
Chemexpo (Budapest) (bienal) Hungexpo Rt. 1441 Budapest, Pf. 44. (Hungría) Tel.: 263-6451
Fax: 263-6335
E-mail: chemexpo@hungexpo.hu www.chemexpo.hu
ChemPlastExpo (Madrid) Nebext
O’Donnell, 12 planta 2 28009 Madrid
Tel.: 34 917 942 830 www.chemplastexpo.com
Chemspec Europe (Itinerante) Quartz Business Media, Ltd. Westgate House, 120/130 Station Rd Redhill, Surrey RH1 1ET (Reino Unido)
E-mail: Michelle Baalham@quartzltd.co.uk www.chemspecevents.com/europe
Chemspec India (Bombay) India:
Tel.: +91 (0) 22 2404 4472 (Vijay Raghavan)
E-mail: Vijay@chemicalweekly.com
Internacional:
Tel.: +44 (0) 1737 855 076
E-mail: johnlane@quartzltd.co.uk (John Lane) www.chemspecindia.com
CISILE (Beijing)
China International Scientific Instrument and Laboratory Equipment Exhibition
CIMA (China Instrument Manufacturers Association)
China. No26 Yue Tan, Nan Jie
Beijing 100825 China
Tel.: +86 10 88395128
Fax: +86 10 88395130
E-mail: cima@cima.org.cn www.cisile.com.cn
Compamed (Düsseldorf)
Messe Düsseldorf GmbH
P.O. Box 10 10 06, 40001 Düsseldorf (Alemania)
Messeplatz, Stockumer Kirchstrasse 61
D-40474 Düsseldorf (Alemania)
Tel.: +49 (0)211 4560-01
Fax: +49 (0)211 4560-668
E-mail: info@COMPAMED.de www.compamed-tradefair.com
Congreso Internacional de Seguridad AlimentariaAcofesal (itinerante) www.acofesal.org
XXVI Congreso Latinoamericano de Bioquímica Clínica (Cartagena, Colombia) COLABIOCLI www.colabiocli.com
Congreso Nacional de Científicos Emprendedores (itinerante) www.cientificosemprendedores.es
Congreso Nacional del Laboratorio Clínico (itinerante)
Grupo Pacífico
Marià Cubí, 4 08006 Barcelona
Tel.: +34 932 388 777
E-mail: labclin@pacifico-meetings.com www.labclin.org
Control (Sinsheim, Stuttgart, Lyon, Parma, Coimbatore, Shanghai)
P.E. Schall GmbH
Gustav-Werner-Straße 6 72636 Frickenhausen-Linsenhofen (Alemania)
Tel.: +49 7025 9206-0
Fax: +49 7025 9206-620
E-mail: info@schall-messen.de www.control-messe.de
CPHI (Milán) https://europe.cphi.com/
CPhI Worldwide (varias sedes) www.cphi.com
Drinktec (Munich) (cuatrienal)
Messe München GmbH
Messegelände
81823 Munich (Alemania)
Tel.: +49 89 949 201 11/14
Fax: +49 89 949 102 19
E-mail: info@drinktec.de www.drinktec.de
Ecomondo (Rimini)
Riminifiera
Via della Fiera, 52 47900 Rimini (Italia)
Tel.: +39 0541 711 711
Fax: +39 0541 786 686
E-mail: mrkgestero@riminifiera.it www.ecomondo.com
Efiaqua (Valencia)
E-mail: efiaqua@feriavalencia.com http://efiaqua.feriavalencia.com/
Entsorga (Colonia)
Salón internacional del reciclado y la gestión de desechos
Messe- und Ausstellungs GmbH Köln
Postfach 21 07 60
D-50532 Köln (Alemania)
Tel.: +49 221 821-0
Fax: +49 221 821 25 74
E-mail: 220@koelnmesse.de www.koelnmesse.de/entsorga
En España:
Koelnmesse Spain, S.L. Arenal, 20 - 3º izda. 28013 Madrid
Tel.: +34 91 359 84 55 - +34 91 359 81 41
Fax: +34 91 350 04 76
E-mail: info@koelnmesse.es
EuroLabAutomation
4 Rivercourt
Trinity Street
Oxford, OX1 1TQ (Reino Unido)
Tel.: +44 1865 723 885
Fax: +44 1865 203 885
EuroMedlab (itinerante)
European Congress of Clinical Chemistry and Laboratory Medicine www.euromedlab2021munich.org/
European Biotechnology Symposium (itinerante)
Europa:
BioConferences International
Tel.: +44 131 660 6605
Fax: +44 131 660 6989
E-mail: ebs@impressmedia.com www.bioconferences.com/ebs
Norteamérica:
BioConferences International Inc.
Tel.: +1 914 834 3100
Fax: +1 914 834 3689
E-mail: hmatysko@liebertpub.com www.bioconferences.com/ebs
European Congress of Chemical Engineering (Berlín) https://ecce-ecab2023.eu/
Expo Pack México (Ciudad de México)
Homero No 418, Piso 7 Col. Chapultepec Morales Ciudad de México
Tel.: (+52 55) 5545-4254
Fax: (+52 55) 5545-4302
E-mail: info@expopack.com.mx www.expopack.com.mx
Expopharm (itinerante)
Postfach 6144
65735 Eschborn (Alemania)
Tel.: +49 61 96 928 410
Fax: +49 61 96 928 404
E-mail: e.zeidan@wuv.aponet.de www.wuv.gmbh.de
En España:
Brifer Services, S.L. Arturo Soria, 320 28033 Madrid
Tel.: +34 91 767 27 67
Fax: +34 91 766 99 32
E-mail: brifer@attglobal.net
Expoquimia (Barcelona) (trienal)
Fira de Barcelona
Av. Reina Mª Cristina 08004 Barcelona
Tel.: +34 93 233 20 00
Fax: +34 93 233 22 99; 34 93 233 26 02
E-mail: expoquimia@firabcn.es www.expoquimia.com
FarmaForum (Madrid)
Tel.: +34 916 308 591
E-mail: info@farmaforum.es www.farmaforum.es
Feria de Hannover (Hannover)
Deutsche Messe AG
Messegelände
D-30521 Hannover (Alemania)
Tel.: +49 (511) 890
Fax: +49 (511) 893 26 26
E-mail: hannovermesse@messe.de www.hannovermesse.de
Filtech (Colonia)
Filtech Exhibitions
Germany GmbH & Co. KG
PO Box 12 25 40637 Meerbusch (Alemania)
Tel.: +49 (0)2132 93 57 60
Fax: +49 (0)2132 93 57 62
E-mail: jens@filtech.de www.filtech.de
Filtrex India - EDANA (Nueva Delhi)
EDANA
Av. Herrmann-Debroux 46 B-1160 Bruselas
Tel.: +32 2 740 18 22
Fax: + 32 2 733 35 18
E-mail: delphine.rens@edana.org www.edana.org
FiltXPO (Chicago) International Filtration/Separation Exhibition & Technical Conference https://www.filtxpo.com/
Food & drink technology
Africa (Johannesburg) (bienal)
MMI South Africa (Pty) Ltd. PO Box 4367 Cresta 2118 (South Africa)
Dain Richardson
Tel.: +27 11 476 8093
Fax: +27 11 478 4323
E-mail: dain.richardson@mmisouthafrica.co.za www.fdt-africa.com
Forum Labo Biotech (París) MCI - Groupe Comexpo 55, Quai Alphonse Le Gallo 92100 Boulogne CEDEX (Francia)
Tel.: +33 (0) 1 49 09 68 68
Fax: +33 (0) 1 49 09 68 69
E-mail: info@forumlabo.com www.forumlabo.com
Forum Labo Maghreb (Casablanca) Forum 7 www.agenceforum7.com Reed Exhibitions http://reedexpo.fr www.forumlabomaghreb.com
Future Analytical Summit 2024 – FAS (Kortijk) https://ric-group.com/fas2024/ GEO2 (Bilbao) (bienal) Feria del desarrollo sostenible Bilbao Exhibition Centre Apartado de Correos 468 48080 Bilbao
Tels.: +34 94 428 54 00 Fax: +34 94 442 42 22 www.bilbaoexhibitioncentre.com
Het Instrument (Utrecht) (bienal)
FHI
Postbus 2099
3800 CB Amersfoort (Países Bajos)
Tel.: +31 (0)33 465 75 07
Fax: +31 (0)33 461 66 38
E-mail: info@hetinstrument.nl www.hetinstrument.nl
HospitalForum (L’Hospitalet de Llobregat)
Exposiciones y Eventos, S.L Pollensa, 2. Ed. Artemisa, oficina 12 28290 Las Rozas (Madrid)
Tels.: +34 91 630 85 91 / +34 672 050 625
E-mail: comercial@hospitalforum.es www.hospitalforum.es
HydroGaïa (Montpellier)
Tel.: +33 (0)4 67 17 67 25
E-mail: hydrogaia@enjoy-montpellier.com www.hydrogaia-expo.com
IBLA (Londres)
International Biotech and Lab Automation
Alto Marketing Limited
Building 22C Universal Marina Crableck Lane, Sarisbury Green
Southampton Hants SO31 7AL (Reino Unido)
E-mail: sarahp@alto-marketing.com www.ibla.co.uk
IFAT (Munich) (trienal) Messe München GmbH Messegelände
D-81823 München (Alemania)
Tel.: +49 89 949-01
Fax: +49 89 949-09
E-mail: info@messe-muenchen.de www.messe-muenchen.de
IFAT Eurasia (Ankara) Messe München GmbH Messegelände
D - 81823 München (Alemania)
Tel.: (+49 89) 9 49 - 21 502
Fax: (+49 89) 9 49 - 97- 21 502
E-mail: info@messe-muenchen.de www.ifat-eurasia.com
En España: Firamunich, S.L.
Av. de Les Corts Catalanes, 2, 1ª pl. local 3
08173 Sant Cugat (Barcelona)
Tel.: +34 934 881 720
Fax: +34 934 881 583
E-mail: info@firamunich.com www.firamunich.com
iGEM (itinerante)
International Genetically Engineered Machine
iGEM Foundation
45 Prospect Street, 02139 Cambridge MA, USA
iGEM Europe
10 rue du Mail, 75002 Paris, France www.igem.org
ILMAC (Basilea) (trienal)
MCH Basel Exhibition Ltd.
CH-4005 Basilea (Suiza)
Tel.: +41 58 200 20 20
Fax: +41 58 206 21 89
E-mail: info@ilmac.ch www.ilmac.ch
ImagineNano (Bilbao) Phantoms Foundation
Tel.: +34 91 1402145 info@imaginenano.com www.imaginenano.com
IMSC 2022 (Maastricht)
International Mass Spectrometry Conference
Tel.: +31(0)43-36 27 008
E-mail: info@imsc2022.com www.imsc2022.com
Indowater (Surabaya, Yakarta)
International Water, Wastewater & Recycling Technology Expo & Forum
MEREBO Messe Marketing Jakobikirchhof 9
20095 Hamburgo (Alemania)
Tel.: +49-40-3999905-0
Fax: +49-40-3999905-25
E-Mail contact@merebo.com www.indowater.merebo.com
Innorobo (Lyon) Innoecho
30 rue Maryse Bastie 69008 Lyon (Francia)
Tel./Fax: +33 (0) 483 076 281
E-mail: contact@innoecho.com www.innorobo.com
InstrumentAsia (Singapur)
Singapore Exhibition Service Pte Ltd 47 Scotts Road, 11th Floor Goldbell Towers
Singapore 22 82 33 - Singapur
Tel.: +65 6738 6776
Fax: +65 6732 6776
E-mail (expositores): bt@sesallworld.com
E-mail (visitantes): wen@sesallworld.com www.cia-asia.com/controlsasia.htm
Interchimie Prochem (París) Idexpo
58, Bvd. Paul Vaillant Couturier 94246 L’Haÿ-les-Roses CEDEX (Francia)
Tel.: +33 1 46 65 18 34
Fax: +33 1 46 63 26 00
E-mail: info@idexpo.com www.idexpo.com
En España: Promosalons España
Gran de Gràcia, 15, Pral. 1ª 08012 Barcelona
Tel.: +34 93 21 78 596
E-mail: promosalons@promosalons.es www.promosalons.es
Interkama (Hannover)
Messe Düsseldorf GmbH
Postfach 101006
D-40001 Düsseldorf (Alemania)
Tel.: +49 211 45 60 83 70
Fax: +49 211 45 60 85 15
www.messe-duesseldorf.de
E-mail: info@tradefair.de
International Congress on Particle Technology (Nuremberg) PARTEC
NürnbergConvention Center Messezentrum 1 90471 Nürnberg (Alemania)
T +49 (0) 9 11.86 06- 89 40
F +49 (0) 9 11.86 06- 82 81 www.partec.info
IPA (París)
World Food Process Exhibition Exposium 1, rue du Parc
92593 Levallois-Perret CEDEX (Francia)
Tel.: +33 01 49 68 52 38
Fax: +33 01 49 68 54 45 www.ipa-web.com
En España: Promosalons España
Gran de Gràcia, 15, Pral. 1ª
08012 Barcelona
Tel.: +34 93 21 78 596
E-mail: promosalons@promosalons.es www.promosalons.es
ISC 2024 (Liverpool) (bienal)
34th International Symposium on Chromatography
The Old George Brewery, Rollestone Street, Salisbury SP1 1 DX (Reino Unido)
Tel: +44 (0) 1722 339811
E-mail: info@disc2024.org https://isc2024.org/
iWater Barcelona (Barcelona) (bienal)
Fira Barcelona
Tel.: 902 233 200
E-mail: iwater@firabarcelona.com www.iwaterbarcelona.com
IWEX - International Water & Effluent Treatment (Birmingham)
NEC Birmingham Turret RAI plc
Tel.: +44 1895 454 545
Fax: +44 1895 454 647 www.iwex.co.uk
Jaima Show (Chiba) Sakura Bldg, 3rd floor, Kanda Nishikicho
Chiyoda-ku, Tokio 101-0054 (Japón)
E-mail: webmaster@jaima.or.jp www.jaima.or.jp/show/english
Khimia 2023 (Moscú) Expocentre 123100 Moscow Krasnopresnenskaya nab., 14
Tel.: +7 (499) 795-37-99
E-mail: centr@expocentr.ru www.chemistry-expo.ru/en/
L.A.B. (Birmingham) (bienal) Leipziger Messe GmbH Apartado de Correos 10 07 20 04007 Leipzig (Alemania) Messe-Allee 1 04356 Leipzig (Alemania)
Tel.: +49 341 678-1211
Fax: +49 341 678-1212
E-mail: info@lab.co.uk www.lab-uk.co.uk www.leipziger-messe.de
En España: Delegación en España de la Feria de Leipzig Ana Mamarbachi-International Business
Manuel de Falla, 24, 5º 4ª 08034 Barcelona
Tel.: +34 93 412 24 60 / 302 08 70
Fax: +34 93 317 24 66
E-mail: ana.mamarbachi@mamarbachibusiness.com
LabAfrica (Johannesburgo)
Tel.: +011 460 0247
Fax: +011 460 0250
E-mail: debbiem@orbes.co.za www.labafricaonline.co.za
LabInnovations (Birmingham)
The NEC - Hall 12 Birmingham B40 INT
Tel.: + 44 (0) 121 780 414 www.lab-innovations.com
Laborama Expo (Bruselas) (anual)
UDIAS (Unión de Proveedores para el Sector de Laboratorio) Udias vzw-asbl Z.1 Researchpark 310
B-1731 Zellik (Bélgica)
Tel.: +32 (0) 2 481 00 50
Fax: +32 (0) 2 463 17 06
E-mail: laborama@udias.be www.laborama.be
Labsummit (Coimbra) www.labsummit.com
Labvolution/Biotechnica (Hannover) (bienal) Deutsche Messe AG
Messegelände D-30521 Hannover (Alemania)
Tel.: +49 511 89 380 11/12 Fax: +49 511 89 380 03 www.biotechnica.de www.labvolution.de
Life Sciences Summit (Nueva York)
Life Sciences Summit™ Tel.: 631-632-1080
Additional Contacts:
Kate Hutchinson Center for Biotechnology Tel.: 631-632-8521 www.lifesciencessummit.org
Medica (Düsseldorf) Düsseldorfer Messe GmbH Nowea Postfach 101006 (Alemania) Tel.: +49 211 45 60 0 Fax: +49 211 4560-907 E-mail: info@medica.de www.medica.de
MedicalForum (L’Hospitalet de Llobregat) Exposiciones y Eventos, S.L Pollensa, 2. Ed. Artemisa. oficina 12 28290 Las Rozas (Madrid) Tels.: +34 91 630 85 91 / +34 672 050 625
E-mail: comercial@medicalforum.es www.medicalforum.es
Miptec (Basilea)
MCH Basel Exhibition Ltd. CH-4005 Basilea (Suiza) Tel.: +41 58 200 20 20 Fax: +41 58 206 21 89
E-mail: info@miptec.com www.miptec.com
(Workshop) MRAMA http://jornades.uab.cat/workshopmrama
Nanotrends (Munich)
IIR Deutschland GmbH
Otto Volger Strasse 21
D-65843 Sulzbach/Taunus (Alemania)
Tel.: +49 (0) 619 585 0
Fax: +49 (0) 619 585 490
E-mail: info@iir.de www.nanotrends.de
PARTEC (Nuremberg)
International Congress on Particle Technology
NürnbergConvention Center Messezentrum 1 90471 Nürnberg (Alemania)
T +49 (0) 9 11.86 06- 89 40
F +49 (0) 9 11.86 06- 82 81 www.partec.info
Parts2clean (Stuttgart)
Deutsche Messe AG
Messegelände
30521 Hannover (Alemania)
Tel. +49 511 89-0
Fax +49 511 89-36694
E-mail: info@messe.de www.parts2clean.de
PharmaPack (París)
WhatsApp: +31 20 245 5355
Hotline: +31 20 245 5355
E-mail: Pharmapackcustomerservice@informa.com www.pharmapackeurope.com
Photokina (Colonia)
KölnMesse GmbH
Postfach 21 07 60
D-50532 Köln (Alemania)
Tel.: +49 221 821-0
Fax: +49 221 821 25 74
E-mail: photokina@koelnmesse.de www.photokina.de
En España: Koelnmesse Spain, S.L. Arenal, 20 - 3º izda. 28013 Madrid
Tel.: +34 91 359 84 55 / +34 91 359 81 41
Fax: +34 91 350 04 76
E-mail: info@koelnmesse.es
Pittcon (itinerante)
The Pittsburgh Conference 300 Penn Center Blvd., Suite 332 Pittsburgh, PA 15235-5503 (EE. UU.A.)
Tel.: +1 412 825-3220
Fax: +1 412 825-3224
E-mail: pittconinfo@pittcon.org www.pittcon.org
Pollutec (Lyon/París)
Reed Expositions France
70 rue Rivay
F-92532 Levallois Perret CEDEX (Francia)
Tel.: +33 1 47 56 21 24
Fax: +33 1 47 56 21 10 / 20 www.pollutec.com
En España: Promosalons España
Gran de Gràcia, 15, Pral. 1ª 08012 Barcelona
Tel.: +34 93 21 78 596
E-mail: promosalons@promosalons.es www.promosalons.es
Power-Gen (itinerante) PennWell
Corporate Headquarters 1421 S. Sheridan Road
Tulsa, Oklahoma 74112 (EE.UU.A.)
Tel.: +1 (918) 835-3161
Toll-Free: (800) 331-4463
E-mail: Headquarters@PennWell.com www.powergeneurope.com
POWTECH (Nuremberg) NürnbergMesse GmbH
Messezentrum
D-90471 Nürnberg (Alemania)
Tel.: +49 9 11 86 06-89 40 (atención al expositor)
Tel.: +49 9 11 86 06-96 96 (atención al visitante)
E-mail: powtech@nuernbergmesse.de www.powtech.de/en
En España: Nuremberg Firal, S.L. Delegación de NürnbergMesse GmbH para España y Andorra
Av. Mistral, 39, 5º 3ª
08015 Barcelona
Tel.: +34 93 238 74 75
E-mail: info@nuremberg-firal.com www.nuremberg-firal.com
Powtex (Tokio)
CNT Inc.
Omori Bldg. 4F., 2-2-2, Kanda Tsukasa-machi, Chiyoda-ku, Tokyo 101-0048 (Japón)
Tel.: 81-3-5297-8855
Fax: 81-3-5294-0909
E-mail: powtex.10@cnt-inc.co.jp www.cnt-inc.co.jp/powtex/tokyo
Propak Asia (Bangkok)
Bangkok Exhibition Services Ltd. SPE Tower, 9th Floor, 252 Phaholyothin Rd.
Samsennai, Phyathai, Bangkok 10400 (Tailandia)
Tel.: +66.0.2615.1255
Fax: +66.0.2615.2991-3 www.propakasia.com
SciX Annual Conference (Itinerante)
Federation of Analytical Chemistry and Spectroscopy Societies - FACSS Tel.: +1 (856) 224-4266 www.scixconference.org
Semicon Korea (Seúl)
Tel.: 82.2.531.7800 Fax: 82.2.551.3406 E-mail: semiconkorea@semi.org www.semiconkorea.org
Sensors & Instrumentation (Birmingham) www.sensorsandinstrumentation. co.uk
Sinergy (Rimini)
Rimini Fiera S.p.A.l Via Emilia, 155 47900 Rimini (Italia)
Tel.: +39 541 744 442 Fax: +39 541 744 490 www.internationalsinergy.com
Singapore International Water Week (SIWW) (Singapur) Singapore International Water Week Pte Ltd www.siww.com.sg
SLAS (itinerante, anual) Society for Laboratory Automation and Screening 1301 West 22nd Street, Suite 708 Oak Brook, IL 60523 USA E-mail: slas@slas.org www.slas.org
Smagua (Zaragoza) (bienal) Feria de Zaragoza Ctra. Nal. II, km 311 50012 Zaragoza
Tel.: +34 976 53 44 20 Fax: +34 976 33 06 49 Apartado de Correos 108 50080 Zaragoza
E-mail: info@smagua.com www.smagua.com
Smart Food Solutions (Bilbao) www.expofoodtech.com
Smart Systems Integration (itinerante)
Mesago Messe Frankfurt GmbH Rotebühlstraße 83-85 70178 Stuttgart (Alemania)
Tel.: +49 711 61946-16 Fax: +49 711 61946-90 E-mail: smart@mesago.com www.smartsystemsintegration.com
SPQ - Spectroscopy in Process and Quality Control Véase S3 Solutions for Scientists Symposium
Tau Expo (Milán)
PromExpo s.r.l. Via Soderini 25 20146 Milán (Italia)
Tel.: +39 02 42 34 258
Fax: +39 02 42 36 919
E-mail: promexpo@iol.it www.fieremostre.it/tauexpo
Tecma (Madrid)
Feria Internacional del Urbanismo y del Medio Ambiente IFEMA-Feria de Madrid
Parque Ferial Juan Carlos I 28042 Madrid
Tel.: +34 902 22 15 15
Fax: +34 91 722 30 00
e-mail: tecma@ifema.es www.tecma.ifema.es
Turkchem Chem Show Eurasia (Estambul)
Artkim Group
Tel.: +90 212 324 0000
Fax: +90 212 324 37 57
E-mail: sales@artkim.com.tr www.artkim.com.tr
WCPT09
9th World Congress on Particle Technology (Madrid) ANQUE Lagasca, 27 28001 Madrid
Tel. +34 914 310 703
E-mail: anquejg@anque.es www.anque.es (pestaña Congresos)
Workshop MRAMA http://jornades.uab.cat/workshopmrama
XI World Congress of Chemical Engineering (Buenos Aires) Tel. / Fax: 54-11-4326-0089
E-mail: actividades@aaiq.org.ar www.aaiq.arg.ar www.wcce11.org
XIV World Filtration Congress 2025 (Burdeos)
Société Française des Séparations Fluides Particules- SF2P www.wfc14.com
9th World Congress on Particle Technology (Madrid) WCPT09
ANQUE
Lagasca, 27 28001 Madrid
Tel. +34 914 310 703
E-mail: anquejg@anque.es www.anque.es (pestaña Congresos)


Pol. Ind. Las Quemadas
Juan Bautista Escudero, parc. 238 Apdo. 2.096 14014 CÓRDOBA
T. 957 322 140
F. 957 322 136 e-mail: admon@albuslaboratorios.com www.albuslaboratorios.com
Delegaciones y oficinas
SEVILLA
T. 954 975 562 / F. 954 956 986 e-mail: sevilla.pereyra@albuslaboratorios.com
JAÉN
T. 953 280 404 / F. 953 280 574 e-mail: jaen@albuslaboratorios.com
GRANADA
M. 627 543 494
e-mail: cordoba.rabasco@albuslaboratorios.com
JEREZ
T. 956 339 406 / F. 956 141 052 e-mail: jerez@albuslaboratorios.com
MÁLAGA
T. 952 322 450 / F. 952 322 454 e-mail: malaga@albuslaboratorios.com
ALMERÍA
T. 950 320 316 / F. 950 320 316 e-mail: almeria@albuslaboratorios.com
EXTREMADURA
T. 924 204 012 / F. 924 204 013 e-mail: extremadura@albuslaboratorios.com

Hermanos Blanco Barrera, S.A., es una empresa familiar que se dedica, ya en su tercera generación, a la venta de material e instrumentos para laboratorio, a través de su marca comercial ALBUS®
Productos
Fungibles
Instrumentación
Mobiliario - Seguridad
Kits y tiras analíticas
Reactivos - Bacteriología
Marcas distribuidas destacadas:
Fungibles
POBEL, DURAN, PROTON, BRAND, KARTELL, WHATMAN, FILTER LAB, HELLMA, DELTALAB, NIRCO, AUXILAB, HALDENWANGER, WATERS, MILLIPORE, TPP, NUNC, SARSTEDT.
Mobiliariario y seguridad
FORMIMETAL, ASECOS, CARLOS ÁRBOLES, 3M, CRUMA.
Instrumentación
HANNA, LABPROCESS, METTLER TOLEDO, COBOS, SARTORIUS, MOTIC, AUXILAB, MILLIPORE, SELECTA, TELSTAR, BUCHI, ANTON PAAR, DAFA, SETA, LABOLAN, MIELE, ORTOALRESA, OVAN, HOBERSAL, FILTRA, IUL, NEW BRUNSWICK, LEICA, CLIMAS, OLYMPUS, VACUUBRAND, ISOTHERM, EPPENDORF, IKA, HEIDOLPH, THERMO.
Reactivos - Bacteriología
PANREAC, MERCK, SCHARLAU, CARLO ERBA, CULTIMED, BIOTOOLS, BIOMÉRIEUX, BIOSER, INTRON, FAVORGEN, SIGMA ALDRICH, OXOID.
Kits tiras analíticas
MN, MERCK, HACH LANGE, HANNA, CHEMETRICS.


Pol. Ind. Morea Norte, Calle D N6
31191 BERIAIN (Navarra)
T. 948 310 513
E-mail correo@auxilab.es comercial@auxilab.es www.auxilab.com
Conoce también: ROGO-SAMPAIC nuestra empresa en Francia.
Pioneros en España en el sector de la distribución de material y equipos de laboratorio. Desde 1976 ofreciendo, con un servicio constante y creciente, una de las gamas más amplias de artículos para el laboratorio a través de una nutrida red de distribuidores especializados.
- Nuevas y ampliadas instalaciones con más de 6.000 m2 – 1.850 palés de almacenamiento, con extenso stock disponible para entrega inmediata.
- Más de 15.000 referencias en stock
- Productos de calidad para todos los sectores donde hay un laboratorio: educación, investigación, sanidad, industria farmacéutica, agroalimentaria, etc.
- Marcas propias con una excelente relación calidad-precio.
- Distribución de marcas de prestigio internacional con stock local.
- Soporte técnico preventa mediante personal cualificado.
- SAT propio para reparación y mantenimiento de equipos.
- Sistema de gestión de la calidad bajo ISO9001:2015, auditado por AENOR desde 1999.
- Presencia internacional con ventas en más de 70 países, en los 5 continentes.
- Canal de venta directa on line a través de www.labotienda.com
- Amplio soporte informativo a través web, catálogo en papel, boletines y promociones periódicas.
En resumen: calidad, servicio y proximidad.
- Nahita: Equipos y material básico de laboratorio.
- Nahita-Blue: Equipos de laboratorio de altas prestaciones.
- Ura Technic: Equipos ópticos.
- Zuzi: Equipos ópticos: microscopios, polarímetros, refractómetros, espectrofotómetros.
- Endometalware: material de acero inoxidable para laboratorio.
- Endoplasticware: Material de plástico para laboratorio.
- Endoglassware: Material de vidrio para laboratorio.
- Endoproteclab: Equipos de protección individual (EPIS).
- Digipette: Manipulación de líquidos asequible.
- Filters RS: Papeles de filtro: resmas, círculos y plegado.
- Ghäasel: Portas y cubreobjetos para microscopia.
- RSLab: Equipos de agitación y evaporadores rotativos.
SAINT-GOBAIN, KARTELL, GLASSCO, SIMAX, JIPO, UNIVET, PLUM, APERA, SOCOREX, GIBERTINI, HYDROLAB, CHEMETRICS.


Badalona
C/ de la Mora, 47
08918 BADALONA (Barcelona)
T. +34 933 207 600
Constantí
Pol. Ind. de Constantí Dinamarca, s/n 43120 CONSTANTÍ Tarragona T. +34 977 524 477
Madrid Isabel Colbrand,10, N-64 28050 MADRID T. +34 913 780 055
e-mail: info@calibrescientific.es es.calibrescientific.com
Marcas propias del grupo Calibre Scientific: REAGECON, SMART CAPS, CALIBRE SCIENTIFIC CMI, GCLAB
Marcas distribuidas
ANALYTICHEM, ASEM, BD, BINDER, BIMOS, BOCHEM, BOLA, BRAND, BRADY, BÜRKLE, DELTALAB, DWK, EBRO, EFFIMED, ELMA, EPREDIA, EXACTA OPTECH, HAIER BIOMEDICAL, HELLMA ANALYTICS, HETTICH, IKA, JT BAKER, KAKUHUNTER, KARTELL, KATANAX, KERN, KGW ISOTHERM, LAUDA, LABMIX24, LENZ, LLG, LYPHAN, MEMMERT, MERCK, MIELE, NEDERMAN, NORDIC LAB, PANREAC, QCA, RAYPA, SAUTER, SAMPLING SYSTEMS, SCHOTT AG, SI ANALYTICS, SMEG, SPEX, TERUMO, USP, VACUUBRAND, VITLAB, WASSERLAB, WTW y muchas más.

Calibre Scientific es un proveedor global de reactivos, instrumentos y soluciones para investigación, diagnóstico y biofarmacia, con presencia en más de 175 países.
El 2024 nace Calibre Scientific Spain, tras la integración de Glass Chemicals, LíneaLAB, Mervilab, Serviquimia y Acefesa, consolidando nuestro compromiso con la innovación y el servicio de calidad. Esta unión refuerza nuestra posición como proveedor integral para el laboratorio, manteniendo la excelencia que distingue a cada una de las marcas ahora unificadas bajo un mismo nombre.
Productos
• Reactivos: Amplia gama de disolventes, reactivos, soluciones valoradas y patrones para diversas aplicaciones.
• Fungibles: Extenso y variado portfolio de material de uso general para laboratorio.
• Equipos: Selección de equipos altamente especializados y de última tecnología.
• Mobiliario: Soluciones personalizadas en mobiliario de laboratorio y sistemas de seguridad.
Servicios
• Proyectos integrales de laboratorio Ofrecemos soluciones llave en mano para la creación o renovación de laboratorios. Nuestro servicio incluye el diseño personalizado del espacio, instalación completa y suministro de todos los elementos necesarios: equipos, instrumentos, mobiliario técnico y reactivos, adaptados a las necesidades específicas de cada cliente y sector (educación, industria, investigación o salud). Nos encargamos de cada fase del proyecto para garantizar funcionalidad, eficiencia y cumplimiento normativo.
• Reempaquetado y acondicionado
Disponemos de dos Salas Blancas de Grado D (ISO 8) certificadas, donde realizamos procesos de acondicionamiento, reempaquetado y manipulación de productos bajo condiciones controladas. Este servicio garantiza la calidad, seguridad y trazabilidad de los productos sensibles o destinados a entornos regulados, asegurando el cumplimiento con las normativas más exigentes.
• Servicio de Atención Técnica
Nuestro equipo técnico propio ofrece mantenimiento preventivo y correctivo, calibraciones, instalaciones y puesta en marcha de equipos. Atendemos tanto en las instalaciones del cliente como en nuestro propio taller, brindando un soporte técnico ágil y especializado para maximizar el rendimiento y la vida útil de los equipos de laboratorio.


C/ Filadors, 35 6º 5ª
08206 SABADELL (España)
T. +34 93 693 37 35 e-mail: info_es@cer.dgroup.it www.carloerbareagents.com

CARLO ERBA Reagents fundada en 1853, es parte de DASIT GROUP SpA, un holding italiano fundado en 1982 y propietario de varias empresas conocidas en los campos de fabricación de Cabinas de seguridad y mobiliario de laboratorio, diagnóstico in vitro, ciencias de la vida y producción industrial.
CARLO ERBA Reagents posee dos plantas industriales en Francia y, gracias a las cuatro delegaciones comerciales en Europa y a un sistema consolidado de exportación desde nuestro almacén central en Francia, podemos llegar a mercados de todo el mundo. Empleamos a más de 280 personas.
En CARLO ERBA Reagents nos caracterizamos porque nuestro proceso productivo está bajo un paraguas normativo Pharma auditado por la ANSM (Agencia Nacional Francesa de Seguridad Médica y de Productos de Salud).





Compositor Narváez, 10 Pol. Ind. Can Jardí
08191 RUBÍ (Barcelona) T. 935 860 780 F. 936 973 226 E-mail info@carlosarboles.com www.carlosarboles.com
Gerente: Carlos Árboles Salas
Director Comercial: Jeremy Loosdrecht
Marcas propias: ARBOLES
Propia
• Grifería para laboratorio.
• Duchas y lavaojos de emergencia.
Comercialización
• Laboratorios e industria.

Un modelo para cada
Disponemos de una amplia gama de grifería de laboratorio para: agua, gases y aguas especiales, con un diseño moderno y elegante, permitiendo su instalación en mesa, pared y suspendido, así como en vitrinas para gases.
Fabricados en materiales anticorrosivos como polipropileno, acero inoxidable o con recubrimiento de poliamida, impiden que los ácidos utilizados en el laboratorio dañen la superficie de los grifos.
Desde el año 1944 venimos suministrando grifería de laboratorio cumpliendo las normas DIN 188, de grifería de laboratorio.

Las duchas y lavaojos de emergencia son la respuesta inmediata para la descontaminación por proyección de agua para la protección por disolución y lavado extractivo de las agresiones debidas a los productos químicos, cáusticos, ácidos, así como la radiactividad..., que podrían provocar lesiones graves e irreparables.
Desde hace más de 30 años, venimos fabricando equipos de emergencia cumpliendo las normas DIN EN 15154/2006 y ANSI Z358.1:2014
Mod. 2210
Lavaojos de emergencia con soporte mural.
4220
Los lavaojos ofrecen un gran caudal de agua aireada a baja presión que no daña los delicados tejidos oculares. Incorporan filtro de acero inoxidable, recogedor de agua de plástico ABS amarillo o acero inoxidable, y van equipados de cubiertas anticontaminación de funcionamiento automático en la puesta en marcha.
c/ Artesanos, 7
28660 BOADILLA DEL MONTE
Madrid (España)
T. +34 91 661 30 04
F. +34 91 661 93 85
e-mail: comercial@controltecnica.com www.controltecnica.com/test www.controltecnica.com www.camarasclimaticas.com

Con cientos de proyectos y equipos suministrados en los últimos 40 años en el laboratorio e industria, CONTROLTECNICA se ha establecido como una de las más importantes firmas comerciales de ingeniería especializada en el diseño, fabricación y comercialización de equipos para ensayos de control de calidad e instrumentación científica. Además de su propia fabricación CONTROLTECNICA comercializa equipos de firmas alemanas y norteamericanas que representa en exclusiva y colabora estrechamente en el desarrollo comercial de equipos de control de calidad, envejecimiento y solidez a la luz para el laboratorio y la industria. CONTROLTECNICA es líder en el mercado del equipamiento de simulación ambiental y envejecimiento a la luz, gracias a su compromiso de calidad, su servicio técnico y a dedicar el máximo esfuerzo a la satisfacción de sus clientes.
CALTECNICA es servicio técnico acreditado por ENAC con garantía oficial de la marca y técnicos continuamente formados en nuestra casa matriz en Alemania. Además es Laboratorio de Calibración Acreditado por ENAC según UNE-EN ISO/IEC 17025 para la realización de calibraciones en temperatura, humedad, velocidad angular, concentración de CO2, analizadores de CO2, autoclaves, presión, punto de rocío. Ofrecemos toda clase de cursos y entrenamientos técnicos correspondientes a los equipos comercializados por nuestra compañía. Se ofrecen contratos de mantenimiento integrales con tiempos de respuesta en 24, 48 y 72 horas.


Laboratory equipment made in Barcelona

Pol. In. Fonollar Andorra, 19ª
08830 SANT BOI DE LLOBREGAT (Barcelona)
T. 933 706 162
F. 933 797 351 e-mail: comercial@cruma.es cruma.es
Director Gerente : Àlex Canals acanals@cruma.es
Directora Comercial: Laura Cerelli lcerelli@cruma.es
Director SAT: Manolo Moreno mmoreno@cruma.es
Marcas propias: CRUMA AIREO
Marcas representadas: BIOAIR
Desde 1974 proporcionamos seguridad personal y protección medioambiental:
Purificamos el aire con innovación tecnológica para preservar tu salud y cuidar nuestro planeta
Cruma es una empresa especializada en la protección de los trabajadores de laboratorio, sus trabajos y su entorno laboral: desarrollamos y fabricamos productos que protegen contra riesgos químicos y biológicos a través de la innovación técnica y de diseño, con elementos que mejoran el ambiente de trabajo. Fabricamos desde hace más de 50 años cabinas para filtración química y cabinas de flujo laminar que proporcionan la máxima seguridad para el trabajador gracias a procesos de calidad rigurosos. Hoy en día nuestra gama de productos también incluye cabinas para el pesaje ultrapreciso de polvo, cabinas para PCR, armarios de almacenamiento ventilados con filtración química y cabinas de seguridad biológica, exportando nuestros productos a más de 80 países.
Cruma es ahora una marca reconocida a nivel mundial por su garantía de protección personal y del medioambiente, que se distingue por ofrecer innovación, calidad y diseño, junto con la vocación de servicio que mantenemos como valor propio de la empresa familiar que somos.
• Cabinas de filtración de gases
• Cabinas de flujo laminar vertical y horizontal
• Cabinas para PCR
• Cabinas para pesaje de polvos
• Cabinas para pesadas de ultraprecisión
• Armarios de almacenamiento ventilados
• Incubadores de CO2
• Cabinas de seguridad biológica de Clase II A2 certificadas EN12469
• Cabinas para manipulación de medicamentos citostáticos
• Cabinas de seguridad biológica de Clase III


Oficinas centrales
Plaza de la Verneda, 1
Pol. Ind. La Llana 08191 RUBÍ (Barcelona) E-mail: communication@deltalabgroup.com www.deltalabgroup.com
Barcelona:
T. 936 995 000
Madrid: T. 916 164 268
Murcia:
T. 968 626 509
Valencia: T. 963 950 809
Directora General: Pongsuda Pongtanya
Directora General Adjunta: Mònica Torras
Dirección Strategic Bussiness Product Development: Mario Muñoz
Director de Industria: Angel Abellán
Responsable ventas HC&LS: Pere Cerro
Responsable ventas Industria: Enrique Ferrandez
International sales manager: Anna González
Empresas del grupo:
DELTALAB, S.L. NIRCO, S.L.
EQUILABO SCIENTIFIC, S.L.U. ENVASES FARMACÉUTICOS, S.A.
BICAPPALAB, S.R.L.
Fábricas: Rubí (Barcelona), España Paracuellos de Jarama (Madrid), España Roletto (Torino), Italia


Deltalab fue fundada en 1976 en Rubí, Cataluña, y desde entonces nos hemos consolidado como líderes en el diseño y fabricación de productos para laboratorios. Con más de 48 años de experiencia, hemos expandido nuestra presencia a más de 125 países y colaboramos con una red de más de 900 distribuidores.
A lo largo de nuestra historia, hemos incorporado relevantes empresas nacionales e internacionales al grupo Deltalab, convirtiéndonos en un potente conglomerado capaz de diseñar, fabricar y distribuir una solución global para laboratorios de Diagnóstico, Investigación e Industria Alimentaria.
Nuestro principal activo es disponer de un completo portfolio de alto valor añadido que incluye el material fungible fabricado en nuestra planta de Rubí, así como los reactivos y equipos de una lista seleccionada de partners fabricantes, especialistas en cada uno de los segmentos en los que operamos.
Nuestro compromiso con la calidad, la innovación y la sostenibilidad se refleja en ésta amplia gama de productos y en nuestra red de clientes y colaboradores, con los que mantenemos relaciones consolidadas y a largo plazo.
Además, invertimos continuamente en investigación y desarrollo para mantenernos a la vanguardia de la tecnología y las necesidades del mercado.
Destacamos por nuestro firme compromiso con la excelencia en el servicio al cliente, adaptándonos a las necesidades específicas de cada uno y ofreciendo soporte continuo.
Clínicas, hospitales, industrias, universidades y laboratorios de referencia en los cinco continentes confían en nosotros como sinónimo de calidad y servicio.
En 2021 el grupo Deltalab fue adquirido por la corporación tailandesa SCGP, que amplió así su alcance dentro del mercado del diagnóstico, la investigación y la seguridad alimentaria para laboratorios.
SCGP y Deltalab compartimos un objetivo común: crear valor y ofrecer soluciones innovadoras. Esta integración fortalece nuestra estrategia de desarrollo de productos a través de la cooperación, el intercambio de tecnología y la investigación conjunta, permitiéndonos crear productos más diversos y mejorar nuestra capacidad productiva.
En España, Deltalab se estructura en tres divisiones principales para atender de manera especializada las necesidades de sus clientes. Esta organización nos permite ofrecer un servicio más personalizado y eficiente, garantizando que cada cliente reciba productos y soporte adaptados a sus requerimientos específicos.
C/ Albert Einstein, 21 Parque Científico Tecnológico de Almería 04131 ALMERÍA
T. 34 950 553 333 e-mail: info@dicsa.es www.dicsa.es


DICSA inició su actividad hace más de 35 años dedicándose a la comercialización de instrumentación científica, el diseño, montaje y puesta en marcha de laboratorios. Su distribución alcanza los más importantes fabricantes internacionales de equipos científicos, ya que considera la calidad y el servicio los puntos más importantes de su actividad.
DICSA es una empresa dinámica que ha sabido crecer adaptándose a las exigencias del mercado, y que desde el principio ha apostado por la máxima profesionalidad para sus equipos humanos. Cuenta con un personal altamente cualificado, que garantiza un óptimo servicio al cliente, además de ofrecer asesoramiento técnico y una gran experiencia en el sector de la instrumentación y el equipamiento científico.
Sus controles de calidad son muy exigentes y están avalados por el sistema de certificación AENOR
Nuestras instalaciones con más de 3.500 m2 dotadas de los últimos avances informáticos nos permiten dar un servicio rápido y eficaz.
En nuestro almacén disponemos más de 20.000 referencias activas, 5.500 de ellas con stock a día de hoy. El stock se confecciona en función del consumo de nuestros clientes con el fin de disponer de sus productos habituales en stock y poderlos servir de inmediato, evitando las posibles roturas de stocks de los fabricantes o demoras.



C/ Anabel Segura, 16. Edif. 2, Planta 3
Centro Empresarial Vega Norte 28108 ALCOBENDAS (Madrid) T. 913 806 710 e-mail: es.fisher@thermofisher.com www.fishersci.es
Site Leader: Sr. Ángel Barroso

5 Prime: biorreactivos.
Acros: reactivos químicos de alta pureza.
Afora: diseño y fabricación de vidrio científico, piezas especiales a medida en vidrio y cuarzo y calibración volumétrica ENAC.
Applied Biosystems: instrumentos y biorreactivos para análisis genético.
Asecos: armarios de seguridad.
Ansell: guantes.
Azlon: plástico para uso general en el laboratorio.
BD Biosciences: reactivos e intrumentos para genómica, proteómica y desarrollo de fármacos.
Bel-Art: consumible y pequeña instrumentación de laboratorio.
Binder: estufas, incubadores, cámaras climáticas.
Brady: señalización e impresoras de etiquetas.
Brand: manipulación de líquidos, aparatos volumétricos, productos para ciencias de la vida y medición de densidad.
Branson: baños de ultrasonidos y sonicadores.
Büchi: evaporadores rotativos.
Corning-Axygen: plástico para biología molecular.
Corning: criogenia, frascos y placas para cultivo, plástico estéril para microbiología.
Cytiva: biorreactivos y productos de filtración.
Dilvac: vasos Dewar.
Düperthal: armarios de seguridad.
DuPont: material de seguridad.
Duran: piezas de vidrio científico.
Electrothermal: mantas calefactoras y controladores de temperatura.
Elma: baños de ultrasonidos.
Eppendorf: centrífugas, micropipetas automáticas, puntas de pipeta, microtubos, agitadores termostáticos y termocicladores.
Erlab: campanas extractoras y armarios con filtro de carbón activo.
Euromex: microscopios.
Falcon: material de plástico de laboratorio
Fisher Bioreagents®: biorreactivos fabricados por proveedores líderes con una óptima relación calidad-precio.
Fisher Chemical: reactivos químicos para laboratorio.
Fisherbrand: selección de consumibles de alta calidad.
Genevac: evaporadores centrífugos.
Gilson: micropipetas.
Gosselin: plástico para uso general en el laboratorio.
Hamilton: microjeringas, diluidores.
Heidolph: agitadores, evaporadores rotativos.
Hirschmann: material de laboratorio e instrumentos.
Hoefer: electroforesis.
Honeywell: material de seguridad y productos químicos.
IKA: instrumentación para laboratorio, calefacción, agitación.
Ilmvac: bombas de vacío.
Implen: lectores de nanovolumen.
Invitrogen: productos para biología celular y molecular.
Jenway: clorurómetros, conductímetros, fluorímetros, espectrofotómetros, fotómetros de llama y medidores de pH.
Justrite: contenedores de seguridad.
Kartell: material plástico para laboratorios.
Kd Scientific: bombas de perfusión.
Kimberly Clark: guantes de protección.
Kimble-Chase: vidrio de laboratorio.
Kühner: agitadores para cultivos.
Labconco: liofilizadores.
Liebherr: refrigeradores y congeladores
Masterflex: bombas peristálticas.
Sectores de aplicación
Memmert: baños, estufas, estufas microbiológicas, incubadores, refrigerados y de CO2, estufas de vacío, cámaras climáticas y de pruebas frío/calor.
Merck Millipore: reactivos para ciencias de la vida, microbiología, purificación de agua y piltración.
Mettler Toledo: balanzas e instrumentos analíticos de precisión.
MicroFlex: guantes.
Motic: microscopios.
MP Biomedicals: reactivos y equipos para ciencias de la vida.
Nabertherm: hornos de mufla y tubulares de alta temperatura, hornos especiales y estufas de alta temperatura.
Ohaus: balanzas.
Plas-Labs: cabinas de guantes.
PolyScience: baños de recirculación, chillers, termostatos de inmersión.
Protein Simple: sistemas de fotodocumentación, análisis de fluorescencia y quimioluminiscencia.
PYREX - Quickfit: material de vidrio y esmerilados para laboratorios.
Sartorius: balanzas, pipetas electrónicas y mecánicas, puntas de pipetas calidad IVD.
SciLabware: material de vidrio y plástico de laboratorio.
Selecta: equipamiento básico de laboratorio (autoclaves, estufas, baños).
Sonics: sonicadores.
Stuart: agitadores, baños, destiladores de agua y aparatos para laboratorios en general.
Techne: instrumentos de biotecnología, termostatización, calibración industrial y termocicladores.
Telstar: cabinas de flujo laminar.
Thermo Lab Vision: anticuerpos para inmunohistoquímica.
Thermo Scientific Biolite: cultivo celular.
Thermo Scientific Chromacol, LaPhaPack, National: productos relacionados con cromatografía (viales, septum y columnas).
Thermo Scientific Finnpipette: pipetas electrónicas y mecánicas, puntas de pipetas.
Thermo Scientific Forma: ultracongeladores, incubadores de CO2, agitadores.
Thermo Scientific GE-Hyclone: sueros y medios para cultivo celular.
Thermo Scientific Genomics: biorreactivos para biología molecular.
Thermo Scientific Abgene: reactivos y consumibles para PCR.
Thermo Scientific LED: evaporadores, lectores y lavadores de microplacas, hornos, espectrofotómetros UV-Vis, fluoroespectrómetros, agitadores magnéticos y orbitales, baños secos/María/termostáticos, electroforesis, termómetros, conductímetros, oxímetros, portas y cubreobjetos.
Thermo Scientific Matrix: criotubos 2D y manipulación de líquidos.
Thermo Scientific Nalgene: material plástico para laboratorios, filtración, criogenia.
Thermo Scientific NanoDropTM: espectrofotómetros y fluoroespectrómetros para micromuestras.
Thermo Scientific Nunc: material plástico para cultivo celular y ensayos celulares.
Thermo Scientific Pierce: biorreactivos para inmunología y proteómica.
Thermo Scientific Savant SpeedVac: concentradores de vacío.
Thermo Scientific Sorvall: centrífugas.
Thermo Scientific Sterilin: plástico estéril para microbiología.
Thermo Scientific Temperature Control: baños termostáticos y chillers
UVP: transiluminadores y sistemas de fotodocumentación.
Wheaton: frascos y tubos de vidrio, agitadores de orbitales. Zeiss: microscopios.
Estamos presentes en todos los sectores químicos y farmacéuticos, industria alimentaria, cerámica, metalúrgica, biotecnología, aeronáutica, petroquímica, medioambiente, hospitales, laboratorios clínicos y de veterinaria, universidades, centros docentes, laboratorios de ciencias de los materiales e investigación en general.


Industriestrasse 8
D-55743 IDAR-OBERSTEIN (Alemania)
T. +49 6784 70-0
E-mail info@fritsch.de www.fritsch.de/en
Gerente: Sebastian Fritsch
Dtor. de Exportación:
Maik Paluga
Marcas propias: PULVERISETTE, ANALYSETTE, LABORETTE
Distribuidor en España:
Para la molienda, tamizado, división:
IZASA SCIENTIFIC, S.L.U. David Aparicio
Polígono Industrial Alcobendas C/ Aragoneses, 13 28108 ALCOBENDAS (Madrid)
T. 900 810 061
E-mail daparicio@izasascientific.com www.izasascientific.com
INSTRUMENTOS DE LABORATORIO PRINCIPALES
FABRICADOS EN ALEMANIA
Laboratorio, control de calidad, investigación y desarrollo: los colegas a escala mundial son fans de FRITSCH. Porque nuestra fuerza es impresionante. Y el contacto con nosotros es estupendo. Los instrumentos de laboratorio de FRITSCH cubren todas las aplicaciones comunes, satisfacen todas las normas internacionales, son resistentes al clima tropical y están listos para su uso en el desierto. Las mejores condiciones para los mejores resultados.
FRITSCH es una empresa familiar, alemana, bien establecida, con una historia de más de 100 años. Es un socio fiable para usted, para una cooperación de larga duración. Somos expertos en tecnología de aplicación, y podemos ayudarle -en una amplia gama de industrias- a lograr la mejor trituración, análisis y tratamiento de sus pruebas. Díganos lo que quiere. Encontraremos juntos el mejor camino.
• Preparación óptima de las muestras Cualquier análisis es tan bueno como la preparación de la muestra. Por eso no debe dejar nada al azar y confiar en unos resultados excelentes y reproducibles. Con instrumentos que le ahorren tantos pasos como sea posible, FRITSCH le ofrece una amplia gama de diferentes molinos para cada material y cada aplicación de laboratorio. Todo fabricado con la calidad de FRITSCH.
• Medición moderna de partículas
Gane nuevas experiencias: Si desea llevar su medición de partículas en el control de calidad o en el laboratorio a un nivel superior, le ofrecemos analizadores de partículas de última generación a un precio justo. Incluyen asesoramiento y servicio para un uso óptimo. Utilícelos para revolucionar sus conocimientos sobre partículas analizando rápida y fácilmente su tamaño y forma.
Easy working – great results: esta es nuestra promesa. Si está interesado en el mundo FRITSCH, desea conocer nuestros instrumentos o necesita asesoramiento técnico sobre aplicaciones, estaremos encantados de atenderle. Bienvenido a la familia FRITSCH.


CR CO · 762 Los Piedros
Las Navas, s/n
14900 LUCENA (Córdoba) España
T. 34 957 59 51 14
F. 34 957 59 11 83
e-mail: info@infricomedcare.com www.infricomedcare.com

Infrico Medcare nace con una misión por bandera: ayudar a quienes más lo necesitan y lo hace como mejor sabe, diseñando y fabricando maquinaria de refrigeración de primer nivel destinada al sector biomédico y sanitario. El mejor equipamiento, excelentes equipos, para contribuir a que médicos, sanitarios, farmacéuticos y químicos, entre otros, puedan poner en práctica sus avances y descubrimientos contribuyendo, de esta forma, al progreso, al avance y la mejora de la calidad de vida de todos.
La salud es la verdadera razón de ser de la compañía y para cumplir este objetivo, posee la experiencia que proporciona su know-how en la industria del frío industrial, con más de tres décadas liderando el mercado europeo a través de la enseña Infrico, y cuenta, además, con todas las certificaciones necesarias que avalan su saber hacer.
Vanguardia tecnológica, calidad certificada y la excelencia de nuestros productos son las garantías que avalan nuestro compromiso de fabricación de ser los mejores del mercado. Para ello, Infrico Medcare cuenta con tres líneas de producto destinadas a laboratorios y temas médicos, bancos de sangre y, por supuesto, la industria farmacéutica y la cosmética.
Infrico Medcare posee el certificado de Origen Español (OEC) que acredita que sus productos son fabricados en España. El Centro de Producción Infrico está ubicado en Lucena, en la provincia de Córdoba, y es una de las instalaciones industriales más modernas de España. Tres plantas que cuentan con una superficie total de 160.000 m2 destinados a producción, actividades logísticas y oficinas.



Gerhard-Juchheim-Strasse, 1 77960 Seelbach (Alemania)
T. +49 7823 510
F. +49 7823 2491
E-mail info.de@julabo.com www.julabo.com
Ventas
T. +49 7823 51-190
F. +49 7823 2491
e-mail info.de@julabo.com
Servicio técnico
T. +49 7823 51-66
F. +49 7823 51-99
E-mail service.de@julabo.com
JULABO es sinónimo de sistemas de control de temperatura y termostatos de laboratorios del máximo nivel en todo el mundo. Las necesidades, expectativas y deseos de nuestros clientes tienen una influencia decisiva en el desarrollo de nuestros productos y servicios y en los elevados estándares de calidad que cada uno de los dispositivos debe cumplir.
Ofrecemos a los usuarios soluciones premium en el campo del control de temperatura de líquidos para todas las industrias y aplicaciones.
Nuestra amplia oferta de servicios nos permite desarrollar junto a usted la solución perfecta para sus necesidades concretas y garantizar su buen funcionamiento a largo plazo. Desde el principio podrá confiar en nuestra incomparable experiencia y nuestro personal de competencia profesional probada; en definitiva, juntos lograremos obtener lo mejor para su proyecto.
Soluciones especiales para la tecnología de control de temperatura
Para usted no solo somos asesores, sino también colaboradores que aportan ideas y solucionan sus problemas. Nuestra Business Unit Solutions (BUS), un equipo de desarrollo propio integrado por ingenieros y diseñadores, se ha especializado muy específicamente en optimizar o modificar los modelos de equipos existentes atendiendo las necesidades particulares del cliente.
Propia
• Criotermostatos sostenibles en todas las clases de potencia
• Dispositivos con refrigerantes naturales, lo que aporta una contribución importante a la protección del clima
• Termostatos de circulación
• Sistemas dinámicos de control de temperatura
• Recirculadores de refrigeración
• Baños de agua
• Baños de agua con agitación
• Productos para aplicaciones especiales
• Accesorios
• Las soluciones de red de JULABO e EasyTEMP
• Asistencia perfecta y personalizada
• Soluciones especiales para el cliente



Migjorn, 1
08338 PREMIÀ DE DALT (Barcelona)
T. +34 937 077 970
F. +34 937 909 532
e-mail: info@labbox.com
Atención al cliente: clientes@labbox.com
T. +34 937 552 084
e-Commerce: www.labbox.es www.labbox.com
Certificaciones:

Labbox Labware, S.L., es una empresa española con 19 años de experiencia en el suministro de consumibles, productos químicos y pequeños equipos para laboratorios, escuelas, universidades, instituciones gubernamentales e industrias de todo el mundo. Desde su creación a finales de 2005, Labbox se ha comprometido a ofrecer productos a precios bajos, entregas rápidas y garantía de satisfacción o reembolso.
Labbox cuenta con un extenso catálogo de más de 6.200 referencias para el día a día del laboratorio. Estas referencias están integradas en 14 marcas propias especializadas por campos.
Su sede central está ubicada en Barcelona, y cuenta con filiales propias en Francia desde 2009; en Italia desde 2020, y en Alemania y los Países Bajos desde 2023. Además, está representada por una red internacional de distribuidores en más de 50 países.
• Laboratorio general
Material de uso general, material volumétrico, manejo de líquidos, vidrio esmerilado y accesorios, filtración, separación y concentración, elementos de montaje e instrumental, recogida de muestras, frascos y recipientes, cromatografía, centrifugación, balanzas, agitadores y accesorios, termostatización, combustión y calcinación, análisis de aguas y alimentos, instrumentos de medida y técnicas instrumentales, mobiliario.
• Ciencias de la vida
Cultivo celular, biología molecular, microbiología y patología, microscopios, refrigeración y criogenización.
• Seguridad e higiene
Equipos de protección e higiene y limpieza.
• Productos químicos
















Dr. R. Wobser GmbH & CO. KG
Laudaplatz 1
97922 LAUDA-KÖNIGSHOFEN (Alemania)
T. +49 (0)93 43 / 503-0 E-mail info@lauda.es www.lauda.es
Gerente: Dr. Gunther Wobser
Filial en España: LAUDA Ibérica Soluciones Técnicas, S.L.U.
Ctra. de Rubí 316
08228 TERRASSA (Barcelona) SPAIN
T. +34 937 879 025 | F +34 937 853 988 E-mail info@lauda-iberica.es www.lauda-iberica.es
Representante en España: Calibre Scientific Spain C/ De la Mora, 47
08918 BADALONA (Barcelona) T. +34 933 297 600 E-mail ventas@calibrescientific.es https://calibrescientific.es/es
Marcas: LAUDA


Somos LAUDA, líderes mundiales en el mercado de la regulación exacta de la temperatura. Nuestros equipos de termorregulación y sistemas de calefacción y refrigeración son las piezas clave de muchas aplicaciones. Somos un proveedor integral y garantizamos la temperatura óptima en la investigación, la producción y el control de calidad. Somos el socio en el que confiar, especialmente en el sector del automóvil, en la industria química/farmacéutica y en el ámbito de los semiconductores y de la tecnología de laboratorio/sanitaria. Gracias a nuestro asesoramiento competente y a unos planteamientos innovadores y respetuosos con el medioambiente, llevamos más de 65 años entusiasmando cada día de nuevo a nuestros clientes de todo el mundo.
Producción
Propia
• Termostatos de calefacción
• Termostatos de refrigeración
• Termostatos de circulación y proceso
• Termostatos calibrados
• Enfriador de circulación
• Baños de agua
• Congeladores
• Equipos de destilación
• Agitadores
• Soluciones individuales
• Sistemas industriales de calefacción y refrigeración

Salvador Espriu, 59 2º 08005 BARCELONA
T. 933 084 181 F. 933 073 612 e-mail es@lgcgroup.com www.lgcstandards.com
Marcas propias:
Labor LGC Standards GmbH, (MM) Breitlander, LGC Poland CHE, Cayman, CDN Isotopes, Lipomed, LGC Germany CRO, LGC Germany DE, DR. EHRENSTORFER, Industrial Analytical, IARM Products, LGC Poland IBP, LGC Poland IC, LGC MM Standards, LGC (UK) (including Uk produced ER), LGC AMP LoGiCal Products, LGC Ethanol Standards, LGC FOR Products, LGCMIC Products, LGC QUANT Products, LGC Axio PTs, mbH, Paragon, TRC, VHG Products.
Marcas representadas:
ALCAN, ALCOA, ATCC, BAM, BCR, Bio Pure, BP, Brammer Standards Inc, Chromadex, Cerilliant, Chemplex Industries, Inc., Laboratorio CiFGA S.A, CIL, Conostan (SCP Science), CPA Products, Cyano Biotech, FLUKA, FPC French Pharmac, GUM, ICRM, IPO, IRMM, Larodan, Medichem, MUVA, NCS (Beiing NCS Analytical), Neochema, NIES, NIM products, NIST, NMIA, National Research Canada, Environment Canada (NW), PRG, PSL, Reagecon, RTC, SERO, Spex Certiprep, SPL Products, Stanhope Seta, Starna Scientific, SUS Ulrich Nell, DE-TOX products, Wepal, WHO, Whitehouse Scientific.


PATRONES Y MATERIALES DE REFERENCIA PARA ANÁLISIS Y CONTROL DE CALIDAD
• Principios activos farmacéuticos y sus impurezas (EP, USP, BP)
• Matrices medioambientales (aguas, suelos, sedimentos, fangos)
• Biota (plantas, hojas, vegetales)
• Alimentos (carne, pescado, cereales, comida procesada, lácteos)
• Piensos
• Aceites vegetales
• Pesticidas, herbicidas, fungicidas, plaguicidas
• Dioxinas, furanos, PCBs, PAHs, BDEs, VOCs
• Isótopos estables
• Biodiesel, gasolina, aceites lubricantes y productos relacionados
• Drogas y sustancias controladas
• Análisis clínico y forense
• Veterinaria
• ICP, AA, IC
• Acero, hierro, cobre y otros metales y aleaciones para fundiciones
• Propiedades físicas
• Productos naturales (colorantes, conservantes, antioxidantes, plantas…)
• Soluciones a medida con analitos inorgánicos y orgánicos
Circuitos de interlaboratorios para ensayos químicos y microbiológicos en:
• Alimentación
Agua de consumo
Alimentos: carne, pescado, precocinados, aceite, frutos secos, lácteos, chocolate, etc.
Bebidas: zumos, refrescos, vinos, destilados, sidras, etc.
Microbiología en superficies
• Medioambiente
Agua residual, continental y marina
Contaminación en suelos
Suelos agrícolas
Aire
• Farma
Cosméticos
Producto farmacéutico
• Clínica
Fármacos
Drogas de abuso
• Otros
Petroquímica
Seguridad de juguetes
Isótopos estables


Äuessere Rittersbacher Strasse 38 91126 SCHWABACH (Alemania)
T. +49 (0) 9122/925-0
F. +49 (0) 9122/14585
E-mail sales@memmert.com

MEMMERT es uno de los principales fabricantes mundiales de cámaras climáticas y unidades de control de temperatura. Nuestra gama de productos incluye cámaras de clima constante, estufas de calentamiento y secado, incubadores, aparatos médicos y baños de agua.
Los aparatos se utilizan para aplicaciones
• en la industria farmacéutica y la medicina
• en la investigación biológica, química y alimentaria,
• para ensayos industriales de materiales y componentes y
• para diversas pruebas de calidad en procesos de fabricación exigentes.
En nuestro papel de líderes en innovación, nuestra filosofía es orientar el desarrollo de nuevos productos a las necesidades de los clientes y, al mismo tiempo, esforzarnos por alcanzar el máximo nivel de calidad, fiabilidad y sostenibilidad. Los procesos de fabricación estandarizados en nuestras ultramodernas instalaciones de producción, llevados a cabo por una plantilla de 550 empleados cualificados y experimentados, garantizan unos niveles de alta calidad constante.
Con más de 90 años de experiencia y una red internacional que se extiende por todo el mundo, Memmert es sinónimo de máxima calidad Made in Germany
En el punto de mira: cámara de clima constante HPPeco
Una nueva dimensión en eficiencia energética y precisión
Esta potente cámara climática con tecnología avanzada Peltier se ha ganado con creces su clasificación “eco”. En funcionamiento continuo, es alrededor de un 90% más eficiente energéticamente que los aparatos refrigerados por compresor, no necesita refrigerante y, por tanto, es fácil de mantener. El rango de temperatura de +0 °C a +70 °C asi como la humidificación y deshumidificación activas del 10% al 90% rh que ofrece la HPPeco, se adaptan de forma óptima a los requisitos de las pruebas de estabilidad de la industria farmacéutica (Q1A).
Gracias a su funcionamiento silencioso, esta compacta cámara de clima constante es incluso adecuada para la cría de insectos y peces cebra.
El aparato no solo es adecuado para las pruebas de estabilidad conformes con la norma Q1A de la ICH, sino también para las pruebas de estabilidad en los sectores farmacéutico, alimentario y cosmético, así como para las pruebas de calidad y el almacenamiento con humedad controlada.
Ventajas más importantes:
• Máxima eficiencia energética en comparación con las cámaras climáticas con compresor
• Distribución absolutamente homogénea de la temperatura y la humedad
• Fiable y a prueba de fallos, incluso tras años de funcionamiento continuo
• Siempre un buen clima: sin refrigerante, silenciosa, compacta y de bajo mantenimiento


C/ Segrià 7-9
08940 CORNELLÀ DE LLOBREGAT (Barcelona)
T. +34 900 922 550 e-mail mtemkt@mt.com www.mt.com

Instrumentación analítica
Mediciones analíticas, valoración, análisis térmico, densidad y refractometría.
Manipulación de líquidos
Pipetas y preparación de muestras.
AutoChem
Reactores automatizados y análisis in situ.
Balanzas
Pesaje de laboratorio, dosificación automatizada de líquidos y sólidos y analizadores de humedad.
Aplicaciones
• Pesaje de laboratorio, pesaje de filtros.
• Determinación del contenido de sal.
• Determinación de acidez.
• Determinación de humedad.
• Análisis de grados brix (azúcar).
• Medición de pH.
• Análisis térmico.
• Comprobaciones de pureza.

• Formulación.
• Desarrollo de síntesis.


C/ Orense, 11
28020 MADRID
T. 914 533 000
e-mail: info.spain@nippongases.com http://nippongases.com/es

Nippon Gases es una compañía líder en el negocio de los gases industriales y medicinales en Europa, formando parte de Nippon Sanso Holdings Corporation. Juntos somos «The Gas Professionals».
Estamos presentes en más de 13 países europeos, contando con una sólida combinación de líneas de negocio in situ/tuberías, redes comerciales y distribuidores a través de las principales zonas industriales. Disponemos de cuatro barcos de CO2, 14 enclaves suministrados por tubería y más de 600 camiones para abastecer a tiempo a nuestra amplia cartera de clientes en toda Europa.
Somos un socio estratégico para los gases industriales y medicinales en Europa.
Nippon Gases produce y distribuye gases de calidad farmacopea, gases de alta pureza para instrumentación analítica e investigación, líquidos criogénicos, instalaciones y servicios especialmente dedicados a clientes de la industria farmacéutica, biotecnológica y cosmética.
Ayudamos a nuestros clientes a cumplir las normas de seguridad, calidad y sostenibilidad ambiental, a mejorar la productividad, a disminuir el consumo de energía y a lograr productos de mayor calidad.
Nippon Gases, partner tecnológico de la industria biofarma.


Peter Huber
Kältemaschinenbau SE

Werner-von-Siemens-Strasse 1
77656 OFFENBURG (Alemania)
T. +49 781 9603-0
F. +49 781 57211
E-mail info@huber-online.com www.huber-online.com
Gerencia:
Daniel Huber
Benedikt Huber
Joachim Huber
Beatrice Geiler
Bärbel Huber
Distribuidores en España:
Steriltech, S.L.
C/ Laguna del Marquesado, 14-Nave 1
E-28021 MADRID
T. +34 917 109 547
E-mail mdiaz@steriltech.net www.steriltech.net
Scharlab, S.L.
Gato Pérez, 33. Pol. Ind. Mas d’en Cisa
08181 SENTMENAT (Barcelona)
T. +34 937 151 940
E-mail consultas@scharlab.com www.scharlab.com
Calibre Scientific Spain
Pol. Ind. de Constantí
C/ Dinamarca, s/n 43120 CONSTANTÍ (Tarragona)
T. +34 977 524 477
E-mail ventas@calibrescientific.es https://calibrescientific.es/es

Propia
Refrigeradores de inmersión, Criostatos, Termostatos de calibración, Termostatos de calefacción, Ministat® - Termostato de frío (el más pequeño del mundo), Unichiller®
- Refrigeradores de circulación, Unistat® - Sistemas de control dinámico de temperatura, Soluciones para instalaciones protegidas contra explosión (ATEX), Termostatos de refrigeración, Termostatos de líquido, Termostatos fueraborda, Refrigeradores de caudal, Refrigeradores de recirculación, Termostatos de baño y de circulación - KISS®, SemiChillers, Unistat® híbrido (aprovechamiento de recursos energéticos ya existentes).
Aplicación
• Análisis.
• Biotecnología.
• Industria química.
• Industria de polímeros.
• Industria del automóvil.
• Medicina.
• Proceso industrial.
• Recubrimientos (coatings).
• Investigación farmacéutica.
• Pinturas y lacas.
• Bioanalítica.
• Producción farmacéutica.
TERMODINÁMICA Y MICROELECTRÓNICA… IT TAKES TWO TO TANGO
Los sistemas de control de temperatura Huber han revolucionado el mundo de la termorregulación. Desde 1976 el Ministat® es el termostato de refrigeración más compacto del mundo. Los termostatos Unistat® son líderes tecnológicos para temperaturas de alta precisión desde –125 hasta 425 °C. Los usuarios internacionales están muy satisfechos y apoyan los desarrollos de la fábrica «tango» de Huber que suponen soluciones tanto ecológicas como económicas a muchos problemas de termostatización. ¡Alta tecnología de Alemania para el mundo entero!


C/. Gato Pérez, 33. Pol. Ind. Mas d’en Cisa
08181 SENTMENAT (Barcelona)
T. 93 745 64 00 F. 93 715 27 65
e-mail: consultas@scharlab.com www.scharlab.com
Chairman: Werner Scharlau Director Gerente: Pedro Gallego
Marcas propias:
AQUAGENT®, CHEMISPILL®, DETERLABO®, ESSENTQ®, EXPERTQ®, EXTRABOND®, KROMAPHASE®, MISTRACON®, MULTISOLVENT®, PHARMPUR®, SCHARLAU®, SCHARLAU BY AFORA®, SPECTROSOL®, TITRASURE®, ULTRATRACE®
Marcas distribuidas:
3M, AFORA, AMAR, AMARELL, AMCOR, ANSELL, ARMAR, ASECOS, ASTORI, ATAGO, BANDELIN, BBRAUN, BIOCHROM, BIOCOM, BIOTOOL, BISCHOFF CHROMATOGRAPHY, BOCHEM, BOLA, BOLLÉ, BRAND, BRANSON, BÜRKLE, CARLOS ARBOLES, CHEMYX, CHROMAGAR, CHROMALYTIC, CISA, CLINET, COLE-PARMER, COMPACTDRY, CONSORT, CORNING, CPACHEM, CRUMA, DARA-LYO, DEUTSCH&NEUMANN, DELTALAB, DERMIK, DIAN, DOSTMANN, DR. EHRENSTORFER, DURAN GROUP, DÜRR TECHNIK, EBRO, EDWARDS, ELMA, FILTER-LAB, GERHARDT, GILSON, GOSSELIN, GRANT, GVS, HALDENWANGER, HANNA, HARRY GESTIGKEIT, HEIDOLPH, HELLMA ANALYTICS, HETTICH, HIRSCHMANN LABORGERATE, HMC, HOLBACH, HONEYWELL, HUBER, HYGIENA, ICO, IDEX, IKA, INFRICO, INORGANIC VENTURES, INTERSCIENCE, ISOTHERM, ITV, IUL, JUBA, KANGO, KARTELL, KD SCIENTIFIC, KERN, KIKKOMAN, KIMBERLY-CLARK, KIMBLE CHASE, KLEINFELD LABORTECHNIK, KNF, LAUDA, LIEBHERR, LOVIBOND, LUTZ, MACHEREY-NAGEL, MEMMERT, MENZEL-GLASER, MIELE, MISTRACON, MOTIC, NABERTHERM, NATIONAL SCIENTIFIC, NEDERMAN, NEO-DISHER, NERBE-PLUS, ORTOALRESA, OVAN, PANTER, PCE, PCRMAX, PLAS-LABS, POLYSCIENCE, POPE, PROQUARZ, RADLEYS, REAGECON, REPHILE, RETSCH, ROBUSTA, RÖTZMEIER, SAF, SAINT-GOBAIN, SARSTEDT, SARTORIUS, SCAT, SCHARLAU, SCHMIDT-HAENSCH, SCHUETTBIOTEC, SCOTSMAN, SELECTA, SIMAX, SPECTRONICS CORPORATION, SPETEC, SPEX, STOKOLAN, TAYLOR-WHARTON, TB GROUP, TELSTAR, TESTO, TRACEABLE, TRAJAN, UCT, VACUUBRAND, VAPLOCK, VELP, VITLAB, WELCH, WHATMAN, WILMUT, WLD-TEC, XS, ZVG

Somos una empresa española independiente con más de 75 años de historia. Nos dedicamos a la fabricación y distribución de productos y material de laboratorio. Trabajamos para que el servicio que reciban nuestros clientes se convierta en el principal valor diferencial de Scharlab. Con un equipo de más de 50 comerciales garantizamos una buena atención personal. Para ayudar a los clientes en sus decisiones de compra o posibles consultas postventa, ponemos a su disposición más de 10 gestores de producto para reactivos, microbiología, cromatografía, vidrio, seguridad e instrumentación. Un buen clima de trabajo y formación continuada forman parte del plan para mejorar la atención a los clientes. Nuestro almacén de más de 7.000 m2 de super-
PRODUCTOS
Productos químicos: Productos químicos para análisis de laboratorio y producción. Accesorios para cromatografía: Columnas para HPLC y GC, Cartuchos de extracción en fase sólida, kits QuEChERS y accesorios.
· Patrones orgánicos y de pesticidas: Patrones en solución, puros y mezclas de patrones. Productos a medida.
SERVICIOS
e-Commerce: vea toda la información sobre sus pedidos y la documentación necesaria en el área privada de nuestra web.
Hecho a medida: fabricamos y diseñamos soluciones personalizadas para su laboratorio.
· Productos OEM: ofrecemos nuestro conocimiento y nuestras fábricas para desarrollar y fabricar sus productos con su marca.
· S-LIM: Lab Inventory Manager: simplifique la gestión del stock de su laboratorio con S-LIM.
Servicio Técnico de Reparaciones: proponemos a nuestros clientes una oferta global de gestión del parque de equipos.
Servicio técnico de reparaciones: proponemos a nuestros clientes una oferta global de gestión del parque de equipos.
· Servicio de envases retornables: utilice

ficie y 180.000 unidades de producto químico y material de laboratorio, nos permite garantizar un plazo medio de entrega de 48 horas
Plataformas informáticas con nuestras propias plantas de producción y proveedores estratégicos son otro factor clave para lograr y asegurar una logística eficaz
Nuestro deseo es convertirnos en el partner de mayor confianza para los laboratorios de España. Por ello, pretendemos seguir innovando y mejorando para satisfacer las necesidades actuales y futuras de nuestros clientes. Somos la alternativa nacional, con un modelo de negocio propio y libre. Si aún no somos proveedor suyo, nos gustaría que nos brindara la oportunidad para convertirnos en su partner de confianza.
Vidrio para laboratorio: Vidrio de molde, volumétrico y esmerilado. Reactores para laboratorio y piezas especiales a medida.
· Microbiología: Medios de cultivo y complementos para microbiología.
· Consumibles, equipos y seguridad: Gama completa de consumibles y equipos para el trabajo diario en el laboratorio.
nuestro pionero servicio a laboratorios de disolventes en envases retornables.
Servicio de consulta en Cromatografía: ofrecemos cursos de cromatografía adaptado a las necesidades de cada cliente.
· Servicio de consulta en Microbiología: brindamos asesoramiento técnico sobre medios de cultivo, productos relacionados, métodos y normativa vigente a través de un equipo especializado.
Servicio de entregas: servicio urgente y servicio de entrega de equipos de grandes dimensiones. Devolución de producto: gestione cómodamente sus devoluciones desde nuestra web.
· Reclamaciones de calidad: comunicación directa con nuestro departamento de aseguramiento de calidad desde nuestra web.


Chemin de Champ-Colomb, 7a 1024 ÉCUBLENS/LAUSANNE (Suiza)
T. +41 21 651 6000
E-mail socorex@socorex.com www.socorex.com
Distribuidor:
AUXILAB, S.L.
Pol. Morea Norte, calle D - Nº 6 31191 BERIÁIN (Navarra)
T. +34 948 310 513
F. +34 948 312 071
E-mail comercial@auxilab.es www.auxilab.es
Productos y servicios
El programa de ventas Socorex, activo en el mercado desde hace más de 60 años, incluye una amplia gama de instrumentos de alta precisión utilizados para medir, dosificar, transferir, dispensar e inyectar líquidos de manera fiable en una gran variedad de aplicaciones.
Las micropipetas manuales y electrónicas, pipetas multicanal, pipetas de repetición, dispensadores, controladores de pipeta y jeringas reutilizables, junto con sus accesorios y linea puntas de Qualitix®, constituyen el centro del programa.
Nuestros clientes
Estamos orgullosos de contar entre nuestros clientes con prácticamente todos los laboratorios privados, industriales, académicos y gubernamentales.
Estos están implicados en actividades de rutina, investigación y educativas, en campos tan diversos como las ciencias de la vida (biotecnología y biología molecular), medicina, química, farmacología, ecología, agricultura, etc.
Productos de calidad
La dedicación de Socorex a la precisión y la calidad ha sido siempre una tradición. Nuestro compromiso de producir los instrumentos más fiables y de ofrecer los mejores servicios fue formalizado con el cumplimiento de las certificaciones del Sistema de Gestión de la Calidad ISO 9001 e ISO 13485.
Ventas y servicio en España




Polígono Industrial Azitain 3A
20600 EIBAR (Gipuzkoa)
T. 843 93 02 93
E-mail Info.vsib@verder.com
Director general: Haritz Elexpuru
Director comercial: Aratz Akarregi
Marcas Propias: RETSCH
MICROTRAC QATM
CARBOLITE ELTRA

Verder es un líder mundial en el desarrollo y distribución de equipos de laboratorio y procesos de alta calidad, con marcas de renombre como Microtrac y Retsch que operan bajo su paraguas.
Verder Scientific Iberia, nuestra filial recién establecida en España, actúa como socio directo de todas las marcas de Verder, lo que garantiza la experiencia localizada y el apoyo a nuestros clientes.
Retsch ofrece una amplia gama de productos que incluyen molinos de laboratorio para la preparación de muestras, tamizadoras analiticas para determinar el tamaño de partícula, así como equipos para asistencia a procesos como divisores de muestras y trituradoras
Microtrac ofrece una gama completa de instrumentos analíticos para la caracterización de partículas: Sistemas de difracción láser (LD) y análisis dinámico de imágenes (DIA) para medir el tamaño y la forma de las partículas; Analizadores BET para determinar el área superficial y la distribución y tamaño de poros; Equipos de dispersión dinámica de la luz (DLS) y potencial zeta (ZP) para análisis de coloides y nanopartículas, así como soluciones especializadas para el seguimiento y análisis de la estabilidad de fórmulas y emulsiones por SMLS con TURBISCAN



C/ dels Almogàvers, 182-186 08018 BARCELONA
T. 933 093 566 / 933 093 750 F. 933 009 766
E-mail info@vidrafoc.com www.vidrafoc.com
Administradora:
Mª Teresa Ferrer Ortuño
Marcas distribuidas:
Alfa Aesar, A&D Instruments, Anton Paar, Ansell Health Care, Asecos, Axigen, Berman, Binder, Biomerieux, Bioser, Bohlender, Brand, Brookfield, Büchi, Bürkle, Carlos Arboles, Chromacol, Cisa, Cobos, Condalab, Corning, Crison, Cruma, Deltalab, Delta Ohm, Dräger, Dr. Ehrenstorfer, Duran Group, Elma, Eppendorf, Edqm, Equitec, Euromex, Filterlab, Filtra Vibración, Fluka, General Electric, Gilson, Gosselin, Haake, Hach-Lange, Hahnemühle, Haldenwanger, Hamilton, Hanna Instruments, Heidolph, Hellma, Hettich, Hobersal, Honeywell, Huberlab, Ika, Ismatec, Jose Collado, Julabo, Kartell, Kern, Kinesis, Knittel Glass, Labprocess, Lauda, Lenz, LGC, Liebherr, Life Technologies, Liofilchem, Ludwig Schneider, Macherey-Nagel, MBY, Memmert, Menzel-Glaser, Merck, Mettler, Metrohm, Miele, Millipore, Milli-Q, MLE, Mobicat, Motic, Molecular BioProducts, Nabertherm, Nahita, Nalgene, New Brunswick, Nichiryo, Nunc, Ohaus, Orto-Alresa, Ovan, Pall, Panreac Applichem, Perkin Elmer, Plastibrand, Pyrex, Rainin, Raypa, Reagecon, Roth, Sartorius, SCAT, Schott, Selecta, Sigma Aldrich, Simax, Socorex, Supelco, Telstar, Testo, Thermo Scientific, USP, Vacuubrand, Vidra Foc, VitLab, Waters, Whatmann, WTW, XS, Zuzi

Fundada en 1968, Vidra Foc es una compañía que fabrica y diseña piezas estándar y especiales de vidrio científico así como material volumétrico. En su sector, Vidra Foc está considerada la fábrica mejor dotada de España. A su vez, está especializada en el suministro global de materiales para los laboratorios. Desde equipos básicos, consumibles generales, específicos para cromatografía y reactivos químicos, hasta el montaje llaves en mano de mobiliario. Recientemente Vidra Foc ha incorporado una nueva línea de productos para Life Science. Con los principales proveedores del sector, Vidra Foc dispone ahora de un amplio catálogo de productos para las áreas de Bioquímica, Biología Molecular, Cultivo Celular y Análisis de Proteínas.
Somos una organización que basa su actividad en la satisfacción creciente de los clientes y dirigida a todo tipo de sectores: Farmacéutico, Cosmético, Alimentario, Análisis de Aguas, Petroquímico y organizaciones industriales en general, así como Centros de Investigación y Universidades.
Vidra Foc, con una plantilla superior a las 60 personas, tiene su sede central en uno de los distritos de mayor efervescencia tecnológica, el distrito 22@ de Barcelona Con más de 7.000 m2 de superficie, distribuidos en un edificio de cinco plantas, Vidra Foc está totalmente preparada para atender las demandas de todos los laboratorios.
Propia
• Instrumentos científicos para técnicas de laboratorio.
• Material de vidrio con esmerilados intercambiables.
• Vidrio volumétrico según normas UNE e ISO.
• Material de vidrio según normas ASTM, IP, DIN…
• Piezas especiales bajo diseño.
• Tubos de nivel.
• Mirillas planas.
• Reparación de material de vidrio.
• Diseño y fabricación de piezas en acero inoxidable, PTFE…
• Fabricación y reparación de equipos “planta piloto”.
• Instrumentos coleccionables.
Comercialización
• Reactivos.
• Material de vidrio y cuarzo.
• Material de plástico.
• Aparatos diversos.
• Mobiliario.
Aplicación
• Laboratorios de análisis.
• Medio ambiente.
• Alimentación.
• Farmacéutico.
• Académica.
• Bioquímica.
• Biología molecular
• Cultivo celular
• Análisis de proteinas.
• Tecnología de salas blancas.
• Petroquímica.
• Investigación.
• Life Science.
• Industria.
• Cosmética.

2mag AG
Schragenhofstr. 35 DE-80992 MÜNCHEN
Tel. +49 (89) 14 33 42 52 - Fax +49 (89) 14 33 43 69
E-mail: michael.fischer@2mag.de www.2mag.de
3M Pumps, S.R.L. Via dell’Artigianato,120
IT-45015 CORBOLA - ROVIGO
Tel. +39 0426346304 - Fax +39 0426349126
E-mail: info@3mpumps.com www.3mpumps.com
20 Microns Limited
307-308, Arundeep Complex
IN-390007 VADODARA
Tel. +912 653 057025 - Fax +912 652 333755
E-mail: north@north-sa.com www.20microns.com
A. COLOMA Assesorament Tècnic de Microscòpia Lluís Sagnier, 26-28 Baixos 08032 BARCELONA
Tel. 934 355 555 - Fax 934 565 050
E-mail: info@acolomamicroscopis.com www.acolomamicroscopis.com
A. Krüss Optronic GmbH Alsterdorfer Strasse 276-278 DE-22297 HAMBURG
Tel. +49 405 143 170 - Fax +49 405 143 1760
E-mail: info@kruess.com www.kruess.com
A&B Laboratorios de Biotecnología, S.A. Paduleta esquina C/ Jundiz 01015 VITORIA Álava
Tel. 945 291 616 - Fax 945 292 939
E-mail: atcliente@ab-laboratorios.com www.ab-laboratorios. com
Marcas propias: 100% Marcas representadas: Propias
Abastecimientos Industriales de Valvulería, S.L. Pol. Ind. Almeda I. Albert Einstein, 58 Nau 18 08940 CORNELLA DE LLOBREGAT Barcelona
Tel. 933 770 616 - Fax 933 770 500 E-mail: abv@abv.es www.abv.es
Abel Equipos
Anochecer, 2 Edificio El Torreón 28223 POZUELO DE ALARCÓN Madrid Tel. 917 154 848 - Fax 917 990 017 E-mail: mail@abelequipos.es www.abelequipos.es
Abelló Linde, S.A. Bailén, 105 08009 BARCELONA Tel. 934 767 400 - Fax 934 767 454 E-mail: ccenternordeste@es.linde-gas.com www.abellolinde.es
Gerencia: Christoph Stein
Dir. Nacional: Jose Luis Cañedo (director general adjunto)
Dir. Comercial: Baltasar Palanca
Dir. Técnico: Ricard López
Dir. Financiera: Sonia Madrid
Dir. de Producción: François Hoche
Dir. RR.HH.: Teresa Duarte
Marcas propias: LINDE, HIQ®, BIOGON®, FRUTARGAS® CRYOCLEAN®, SOLVOX®
Accesair, S.L.
Seva, 2. Pol. Ind. L’Ametlla Park
08480 L’AMETLLA DEL VALLÈS Barcelona
Tel. 938 615 025 - Fax 938 404 155
E-mail: marketing@accesair.com www.accesair.com
Acefe, S.A.
Dalia, 11
08860 CASTELLDEFELS Barcelona
Tel. 936 362 002 - Fax 936 640 865
E-mail: acefesa@acefesa.es www.acefesa.es
Gerencia: Paul McDonough
Dir. Nacional: Ricardo Clares
Dir. Comercial: Ricardo Burgaleta
Dir. Técnico: Ricardo Burgaleta Marcas representadas: 20
Aceros Moldeados de Lacunza, S.A. Abarrategui, s/n 31830 LAKUNTZA Navarra Tel. 948 576 031 - Fax 948 576 154 E-mail: c.blazquez@amlsa.com www.amlsa.com
ACM Tools, S.L. Ronda Ponent, 50 08224 TERRASSA Barcelona Tel. 937 894 046 - Fax 937 894 061 E-mail: bombas@acm-tools.com www.acm-tools.com
Acrison Intl. (UK) Ltd. Canaside North - John Gilbert Way - Trafford Park GB-W171AH MANCHESTER Tel. +44 161 8779955 - Fax +44 161 8779198
E-mail: sales@acrisonint.net www.acrisonint.net
Actini
Parc de Montigny FR-74500 MAXILLY - EVIAN
Tel. +33 450 831212 - Fax +33 450 831210 www.actini.com
Activeng, Lda Alameda Fonte Velha, EA 14, Bloco C3 2º PT-2710-694 S. PEDRO DE PENAFERRIM SINTRA Tel. +351 918 790 439 - Fax +351 962 059 416 E-mail: andrade.rocha@activeng.pt www.activeng.pt
Actreg, S.A. Cantabria, 2. Pol. Ind. Les Salines
08830 SANT BOI DE LLOBREGAT Barcelona Tel. 936 614 410 - Fax 936 543 393
E-mail: sales@actreg.com www.actreg.com
Adispa, S.L.
Balmes, 184 5ª Planta- 4ª Puerta
08006 BARCELONA
Tel. 932 855 030 - Fax 932 855 145
E-mail: info@adispa.es www.adispa.es
Advancell
Baldiri i Reixac, 10-12
08028 BARCELONA
Tel. 934 034 545 - Fax 934 034 544
E-mail: advancell@advancell.net www.advancell.net
Aerzen Ibérica Urogallo, 13. Pol. Ind. Los Gallegos 28946 FUENLABRADA Madrid
Tel. 916 424 450 - Fax 916 422 903
E-mail: info@aerzen.es www.aerzen.es
Aerzener Maschinenfabrick GmbH
Reherweg, 28
DE-32855 AERZEN
Tel. +49 515 4810 - Fax +49 515 481191
E-mail: info@aerzener.de www.aerzener.com
AES Chemunex España, S.A.
Albert Einstein, 44. Pol. Ind. Santa Margarida II 08223 TERRASSA Barcelona
Tel. 937 853 627 - Fax 937 847 263
E-mail: aes@aes-lab.es www.aeschemunex.com
AES Laboratorio, S.A.
Santa Fe, 3 Local 08191 RUBÍ Barcelona
Tel. 935 884 012 - Fax 935 888 594
E-mail: aes@aes-lab.es www.aes-lab.es
Marcas propias: AES LABORATOIRE, CHEMUNEX, ADIAVET
Marcas representadas: BIOLIFE, BIOLOG, DON WHITLEY SCIENTIFIC, SYNOPTICS, BINDER, MMM, MICROBIOLOGICS, MICROGEN, WARNEX
Aesseal Ibérica, S.L. Pol. Ind. Riu Clar. C/ Plata, 7 43006 TARRAGONA Tel. 977 554 330 - Fax 977 206 306
E-mail: info@aesseal.es www.aesseal.es
Aflex Hose Ltd
Spring Bank Industrial Estate, Watson Mill Lane GB-HX6 3BW HALIFAX Tel. +44 (0)1422 317200 - Fax +44 (0)1422 836000
E-mail: postmaster@aflex-hose.co.uk www.aflex-hose.com
Agem, Auxiliar General de Electromedicina, S.A. Avda. Montes de Oca, 7 Nave 8 28700 SAN SEBASTIÁN DE LOS REYES Madrid Tel. 916 547 199 - Fax 916 547 887
E-mail: agemventas@agemsa.com www.agemsa.com
Marcas representadas: DOMETIC, HETTICH, JULABO, IKA, GERHARDT, SARTORIUS, WPA, etc.
Agilent Technologies Spain, S.L. Ctra. N-VI, km 18,200 28230 LAS ROZAS Madrid Tel. 901 116 890 - Fax 901 900 559
E-mail: customercare_spain@agilent.com www.chem.agilent.com
Marcas propias: AGILENT TECHNOLOGIES
Agitadores Agitaser, S.L. Castillejos, 195-197 bajos 1ª 08013 BARCELONA Tel. 932 322 509 - Fax 932 315 056
E-mail: agitaser@agitaser.com www.agitaser.com
Aguilar y Salas, S.A.
Pol. Ind. Pla de Llerona. Irlanda, s/n 08520 LES FRANQUESES DEL VALLÈS Barcelona Tel. 938 617 070 - Fax 938 400 490
E-mail: assa@aguilarysalas.com www.aguilarysalas.com
AHF Analysentechnik AG Postfach 15 43
DE-72005 TÜBINGEN
Tel. +49 70 71 970901 0 - Fax +49 70 71 970901 10
E-mail: info@ahf.de, IF@ahf.de www.ahf.de
Aicos Technologies, S.A.
Efringerstrasse 32
CH-4057 BASEL
Tel. +41 61 6869877 - Fax +41 61 6869888
E-mail: info@aicos.com www.aicos.com
Marcas propias: STAVEX, EASYSTAT, SIMBAX
Marcas representadas: CART, QUICKGANTT, SCHEDULE++
Aicrov
Pol. Ind. Alba. Villafortuny, Parcela A 19 43481 VILA-SECA Tarragona Tel. 977 395 636 - Fax 977 396 841
E-mail: info@aicrov.com www.aicrov.com
Aimplas
Gustave Eiffel, 4 Parc Tecnologic 46980 PATERNA Valencia Tel. 961 366 040 - Fax 961 366 041
E-mail: info@aimplas.es www.aimplas.es
Gerencia: José Antonio Costa Dir. Comercial: Sergio Giménez Dir. de Marketing: María Llorens
Airec
Pol. Ind. Can Humet de Dalt. Santiago Rosinyol, 9 08213 POLINYÀ Barcelona
Tel. 902 102 734 - Fax 935 747 003
E-mail: airec@airec.org www.airec.org
Airmatic, S.A.
Pol. Ind. Can Roqueta. Ca N’Alzina 112 08202 SABADELL Barcelona
Tel. 937 155 990 - Fax 937 270 859
E-mail: xbarba@airmatic.es www.airmatic-nitrogeno.es
Aislamiento y Estanqueidad Erica, S.L. C/ Marruecos 160 08019 BARCELONA
Tel. 932 663 649 - Fax 932 663 529 E-mail: dirtecnic@erica.es www.erica.es
Gerencia: J. Enrich Domènech Dir. Comercial: Juan Teixidor Marcas propias: ERICA Marcas representadas: EMPATEC, TRELLEBORG, TBA, DONIT
Akatherm Industrielterrein, 11 NL-7149 PANNINGEN
Tel. +31 7730 88650 - Fax +31 7730 75232
E-mail: info@akatherm.nl www.akatherm.nl
Akzo Nobel Chemicals, S.A. La Llacuna, 161 2ª Planta 08018 BARCELONA
Tel. 934 899 903 - Fax 934 743 027 www.euroresins.com
AL Air Liquide España, S.A. Pº de la Castellana, 35 28046 MADRID
Tel. 915 029 300 - Fax 915 029 684
E-mail: rosario.sanchezlopez@airliquide.com www.airliquide.es
Gerencia: Ole Höfelmann
Dir. Comercial: José A. Ramírez
Dir. Financiero: Alfonso de la Peña
Dir. de Producción: Juan Carlos Villaverde
Dir. RR.HH.: Teresa Rasero Dir. de Marketing: José Marqués
Álava Ingenieros, S.A. Albasanz ,16. Edif. Antalia 28037 MADRID
Tel. 915 679 700 - Fax 915 702 661
E-mail: marketing@alava-ing.es www.alava-ing.es
Gerencia: Jaime Álava
Dir. Comercial: José María Almazán
Dir. de Administración: Alfonso Román
Dir. Técnico: Gonzalo García Dir. Financiero: Carlos Rojo
Dir. RR.HH.: Victoria Mercado
Dir. de Marketing: Laura Madera
Marcas representadas: ACO ACOUSTIC ONE ACOEM - 1DB AERO INSTRUMENT AEROPROBE
AGILENT TECHNOLOGIES AMERICAN TECHNOLOGIES AML OCEANOGRAPHIC AMO GMBH ANASYS INST. ANGELANTONI APOGEE LABS APPLANIX APPLIED
MEASUREMENT APPLIED PHYSICS SYSTEM AQUALABO ARECONT AUTOMATION TECHNOLOGY AUTOMATION TECHNOLOGY 3D AVIONICS SPECIALIST AVMBERTRAM SCHAPAL BASLER BERLEBACH STATIVTECHNIK WOLFGANG FCHER BLUEVIEW BRIEFCAM BRS LABS
CAMERO CARL ZEISS CELLCRYPT COLUMBIA RESEARCH LABORATORIES,INC. COMTEST ENGINEERING BV CONSOLIDATED DEVICES INC. CONTROP CORDEX CORRELATED SOLUTIONS, INC CROSSBOW CVD EQUIPMENT CYBERTECH CZS CARL ZEISS DANISH
SENSOR ENGINEERING DANTEC DATAKUSTIK DAYTRONIC DELONG AMERICA DELTA OHM DICKSON DMA
MARCHIORI DRELLO GMBH DRIVE TEST DST CONTROL
ECA HYTEC EMTEST EMV GMBH ETM ETS-LINDGREN
EUROTEMPEST EUROTRON FASTEC IMAGING FLIR
SYSTEMS FUJITSU GANTNER GE DRUCK GE SENSING
GEMS SENSORS GENETEC GENTEC GL OPTIC GRAS
GUIDE INFRARED HAGNER HARDY INSTRUMENTS
HC TECH HEAD ACOUSTICS HEADWALL PHOTONICS HONEYWELL HUMANETICS IAC IDEAL AEROSMITH
IMAGE SYSTEMS IMC IMI Division of PCB Piezotronics IMV CORPORATION INTERFACE IO INDUSTRIES ISOTECH JDSU JENCAM JENOPTIK KAYE INSTRUMENTS GMBH LASERVISION LEPACOM Lighthouse Worldwide Solutions
Limess MAD CITY LABS MARINESTAR MARSHALL DAY ACOUSTICS MATROX IMAGING MBRAUN
MEASURAND MEASUREMENT SPECIALTIES – PSI MEMSIC MENLO SYSTEMS METROLASER MOR MORPHO DETECTION NH RESEARCH NICE OCEAN CLEANER OCEAN OPTICS OMNISENS SA ORBIT/FR OROS P&G ELECTRONIC COMPONENTS P&G POSITION SENSORS PCB PIEZOTRONICS PENNY & GILES ALEMANIA PENTAX PHOTRON LTD PPM PPM - EOD PROPHOTONIX QPS
QUEST INNOVATIONS RACELOGIC RAPTOR PHOTONICS REDBOX REDISLOGAR RENE STORMS INTERFACE RESON RETROTEC RIEGL LASER SYSTEMS GMBH RION-MGN ROHDE & SCHWARZ ESPAÑA ROWE TECHNOLOGIES
SAMSUNG SBG-SYSTEMS SCK SCHWARZBECK SENSOFAR SENSOR DEVELOPMENTS SIGNALQUEST SILENT SENTINEL SONY ISS SOUTHWEST MICROWAVE SPECTRONICS INC SPI LASERS SVANTEK SWESYSTEM SYSCOM TAOMA TELEDYNE MARINE TELEDYNE RESON TELEDYNE TSS THE MODAL SHOP TITAN ENTERPRISES LTD. TMC AMETEK TRIMBLE MARINE CONSTRUCTION TSI VAISALA VERINT VIALUX VÖGTLIN VUMII XENICS
Albet-Hahnemuehle, S.L.U Fructuós Gelabert, 2-4, Edif. Conata, 3º 3ª 08970 SANT JOAN DESPÍ Barcelona
Tel. 934 950 303 - Fax 933 631 854
E-mail: albet@albet-hahnemuehle.com www.albet-hahnemuele.com
Marcas propias: ALBET-LabScience
ALBUS Suministros para laboratorio Pol. Ind. Las Quemadas
Juan Bautista Escudero, parc. 238 Apdo. 2.096 14014 CÓRDOBA
Tel. 957 32 21 40 - Fax 957 32 21 36
e-mail: admon@albuslaboratorios.com www.albuslaboratorios.com
Allied Gases, C.A.
Urb. Araguama Country Villa Ebano # 20 Los Samanes
VE-2104 MARACAY Aragua
Tel. +58 243 2352077 - Fax +58 243 2352077
E-mail: alliedgases@intercable.net.ve
Marcas representadas: CHEMETRON, VICTOR MEDICAL, WESTERN MEDICAL, AMICO CORP., entre otras.
Amel SRL
Via San Giovanni Battista de la Salle, 4
IT-20132 MILANO
Tel. +39 022 72030601 - Fax +39 022 564832
E-mail: amel@amelchem.com www.amelchem.com
Ampo, S. Coop. Barrio Katea, s/n. Apdo. Correos 96 20213 IDIAZÁBAL Guipúzcoa Tel. 943 188 000 - Fax 943 188 130
E-mail: jmaiza@ampo.es www.ampo.es
Analab, S.A. Orient, 78 08172 SANT CUGAT DEL VALLÈS Barcelona
Tel. 935 900 007 / 932 372 441 / 932 374 641 Fax 932 177 009
E-mail: analab@analab.es www.vanwalt.com/es
Dir. Nacional: Montserrat Ampuy
Marcas propias: VAN WALT
Marcas representadas: EIJKELKAMP AGRISEARCH, PREVOR, IMKO, SDEC, JULES RICHARD INSTRUMENTS, GANN, BELLINGHAM & STANLEY, BRANSON, DELTA T, SOILMOISTURE
Análisis Vínicos, S.L. Los Pastores, 38 13700 TOMELLOSO Ciudad Real Tel. 926 513 748 - Fax 926 513 748
E-mail: correo@analisisvinicos.com www.analisisvinicos.com
Marcas representadas: SUPELCO, WATERS, PHENOMENEX
Análisis y Filtración, S.L. Aldebaran, 57 28130 ALALPARDO Madrid
Tel. 916 202 571 - Fax 916 202 642
E-mail: info@anafil.es www.anafil.es
Marcas representadas: ANALOX INSTRUMENTS, MEISSNER FILTRATION PRODUCTS, OXFORD INSTRUMENTS, SCHMIDT + HAENSCH
Analytik Jena AG Konrad-Zuse-Strasse 1
DE-07745 JENA
Tel. +49 3641 77 92 81 - Fax +49 3641 77 99 88
E-mail: c.steidl@analytik-jena.de www.analytik-jena.com
Anamet Europe BV Transformatorweg, 30 NL-1014AK AMSTERDAM Tel. +31 20 5863586 - Fax +31 20 6881126
E-mail: sales@anamet.nl www.anamet.nl
Anatrac A & I, S.A. Ctra. de la Selva, 17 Local 1 43141 VILALLONGA DEL CAMP Tarragona Tel. 977 840 257 - Fax 977 841 426
E-mail: anatrac@anatrac.com www.anatrac.com
Andreas Hofer GmbH Ruhrorter Strabe, 45 DE-45478 MÜLHEIM AN DER RUHR
Tel. +49 (0) 208-4 69960 - Fax +49 (0) 208-4 69961
E-mail: info@andreas-hofer.de www.andreas-hofer.de
Anhui Tianrun Chemicals Co., Ltd No. 71, Jianghuai Road, Bengbu 233010 Anhui, China CN-233010 ANHUI Tel. +0086 552 3951217 - Fax +0086 552 4928705
E-mail: wmb@tianrun.com.cn www.thiarun.com.cn
Aningas, S.A.
Gran Via Corts Catalanes, 327 08014 BARCELONA Tel. 934 266 928 - Fax 934 266 779
E-mail: aningas@aningas.com www.aningas.com
Marcas propias: ANINGAS ERGOS
Anisol Equipos, S.L. Rascafría, 3 - Pol. Ind. Ventorro del Cano 28925 ALCORCÓN Madrid Tel. 913 528 307 - Fax 913 527 003
E-mail: anisol@anisol.es www.anisol.es
Dir. Comercial: Pedro Navarro
Dir. de Administración: Ana Pérez
Dir. Técnico: Roberto Pardo
Dir. de Producción: Jose Miguel Álvarez
Dir. de Marketing: Raquel Riaño
Marcas propias: ANISOL - ANALIZADORES PORTÁTLES Y EN CONTINUO DE GASES, LÍQUIDOS Y SÓLIDOS PARA LA INDUSTRIA DE PROCESO
Marcas representadas: ABER, AMETEK BASELINE MOCON, ANALYTICAL INDUSTRIES, ATAC, H2SCAN, HYCONTROL, HYDRAMOTION, MICHELL, NTRON, OPTEK, PROCESS SENSORS KPM, SENSORTECH KPM, SENSOTECH, SERVOMEX, SULFILOGGER, TURNER, VAISALA BIOGAS, VAISALA KPATENTS
ANORSA (Aparatos Normalizados, S.A.) Ctra. Del Mig, 99-101 1º B 08907 L’HOSPITALET DEL LLOBREGAT Barcelona Tel. 933 006 050 - Fax 933 006 012
E-mail: anorsa@anorsa.com www.anorsa.com
Marcas representadas: AGILENT, PARKER, YMC Europe, SHODEX
Ansys France 1, Place Charles de Gaulle - Immeuble Central Gare FR-78180 MONTIGNY LE BRETONNEUX Tel. +33 1306 09897 - Fax +33 1306 49843
E-mail: iberianevents@ansys.com www.ansys.com
Anton Paar
E-mail: fiorella.rios@anton-paar.com www.anton-paar.com/es
Antonio Matachana, S.A. Almogàvers, 174 08018 BARCELONA Tel. 934 868 700 - Fax 933 005 924
E-mail: marketing@matachana.com www.matachana.com
Dir. Comercial: José Antonio Serón
Dir. de Exportación: Luis Adot
Dir. de Marketing: Marino Alonso
Marcas propias: MATACHANA
Antonio Matachana, S.A. Div. Laboratorios
Hierro, 20-22 08038 BARCELONA
Tel. 932 239 730 - Fax 932 233 331
E-mail: labo@matachana-ind.com www.matachana.com
Marcas propias: MATACHANA
Marcas representadas: LANCER, HAWO
AOG - Solucions d’Embalatge i Manipulació Manuel Fernández Márquez, 34
Parc Empresarial Grandland Badalona Sud 08918 BADALONA Barcelona
Tel. 902 196 200 - Fax 933 205 553
E-mail: info@aog.es www.aog.es
Apici Ávila, 18 28020 MADRID
Tel. 915 722 195 - Fax 915 715 024 E-mail: apici@apici.es
Aplein Ingenieros, S.A.
Avda. Valladolid, 47-C 28008 MADRID
Tel. 915 415 669 - Fax 915 470 464
E-mail: info@apleiningenieros.com www.apleiningenieros.com
Marcas representadas: SAAB ROSEMOUNT TANK RADAR, TS TANKSYSTEM, FAURE HERMAN, PROMECOM, CARL ZEISS JENA GMBH, AMETEK, VAIHINGER NIVEAU TECHNIK,TECHNOLOG LIMITED, EXPO TECHNOLOGIES, ABB TOTAL FLOW, PROCON, HITECH, GL APPLIED RESEARCH, CONTREC, OPTICAL SOLUTION, PANALARM, EIM CONTROLS, PANALARM, GULTON STATHAM, GUIDED WAVE, LABKO, KES INTERNATIONAL LTD, MACE ELECTRICAL TECHNOLOGIES, STEEL, SERGI, SICK.
Aplicaciones Analíticas Doménech, S.L. Chile, 10 28044 LAS ROZAS DE MADRID Madrid
Tel. 917 923 383
E-mail: m.domenech@aadlab.com www.aadlab.com
Gerencia: Mateo Domenech González Dir. Técnico: Ignacio García
Marcas representadas: QUALITY INVEST, MYTHIC, MINDRAY
Aplitex
Progrés, 226 08918 BADALONA Barcelona
Tel. 933 993 711 - Fax 933 992 458
E-mail: aplitex@aplitexsl.com www.aplitexsl.com
Appe Belgium
Ringlaan, 7 BE-2960 BRECHT Tel. +32 3 3300932
Applied Biosystems
Av. de la Vega, 1 Edificio 1 4 4ª Planta 28108 ALCOBENDAS Madrid
Tel. 914 846 900 - Fax 914 846 901
E-mail: irene.hernando@eur.appliedbiosystems.com www.europe.appliedbiosystems.com
Applitek
Venecoweg, 19 BE-9810 NAZARETH
Tel. +32 9 3863402 - Fax +32 9 3867297
E-mail: team@applitek.com www.applitek.com
Apria Systems, S.L.
Avda. de los Castros, s/n 39005 CANTABRIA
Tel. 942 078 145 - Fax 942 078 131
E-mail: consultec@apriasystems.es www.apriasystems.es
Aqua-Consult Ingenieros, S.L.
C/ Marqués de Ahumada, 11 - 1ºC 28028 MADRID
Tel. 916 362 804 - Fax 916 395 293
E-mail: a-cing@a-cing.com www.a-cing.com
Marcas representadas: ERA
Aquaconcept
Wikinger Strasse, 9A DE-76189 KARLSRUHE
Tel. +49 721 597210 - Fax +49 721 5972121 www.aquaconcept.de
Aqualia
Ulises, 18 28043 MADRID
E-mail: marketing@aqualia.es
Aquateknica, S.A.
Jordi de Sant Jordi, 8 46022 VALENCIA
Tel. 963 302 013 - Fax 963 300 396
E-mail: info.aqua@retemail.es www.aquateknica.com
Ar Quimica, S.L.
Castilla La Mancha, 1- 1ºB
28750 SAN AGUSTÍN DE GUADALIX Madrid Tel. 918 487 022 - Fax 918 435 513
E-mail: info@arquimica.com www.arquimica.com
Aralab - Equipamientos de Laboratorio, Lda.
Avda. de Santa Isabel, 7 PT-2635-047 ALBARRAQUE - RIO DE MOURO
Tel. +35 121 9154960 - Fax +35 121 9154969
E-mail: aralab@aralab.pt www.aralab.pt
Marcas propias: ARALAB
Marcas representadas: REVCO, MEMMERT
Arcamo Controls, S.A. Pol. Ind. Francolí. Parcela 20 Local 1 43006 TARRAGONA
Tel. 977 554 739 - Fax 977 554 754
E-mail: arcamo@arcamo.com www.arcamo.com
Gerencia: Gerard Aragones Bonillo
Dir. Comercial: Gabriel Salvat Dir. de Administración: Rosa Mª Alberich Dir. Financiera y RR.HH.: Rosa Mª Alberich Dir. de Marketing: Emilio Carmona
Marcas representadas: HY-LOK, TESCOM, BAUMER, DEKORON, NORGREN, BASOR, BARTEC
Arcox
Blasco de Garay, 57 28015 MADRID
Tel. 915 449 262 - Fax 915 449 262
E-mail: arcox@arcox-tmc.com www.arcox.es
Marcas propias: EQUITEC, FOCUS INSTRUMENTS, TECNOMED
Marcas representadas: EQUITEC, FOCUS INSTRUMENTS, TECNOMED
Aries Ingeniería y Sistemas, S.A.
Pº Castellana, 163 28046 MADRID
Tel. 915 702 737 - Fax 915 702 766
E-mail: quimica@aries-ingenieria.com www.aries-ingenieria.com
Marcas representadas: K-PATENTS, AVACO, CAMBRIDGE, SENTRONICS, ARELCO
Arístegui Maquinaria Collita, 44 08191 RUBÍ Barcelona
Tel. 935 862 940 - Fax 935 862 941
E-mail: am@aristegui.info www.aristegui.info
ART-moderne Labortechnik
Zienkener Strasse 8a DE-79379 MÜLLHEIM
Tel. +49 7631 70099 0 - Fax +49 7631 70099 99
E-mail: info@art-labortechnik.com www.art-labortechnik.com
Marcas representadas: ACEFE, BIOGEN CIENTIFICA, BONSAI TECH., IESMAT, LABOLAN
Ascell Sensor, S.L
Pol. Ind. Congost. Avda. Congost, 56 Nave 3 08760 MARTORELL Barcelona
Tel. 937 766 089 - Fax 937 751 472
E-mail: info@ascellsensor.com www.ascellsensor.com
Asebio
Príncipe de Vergara, 55 5ºB 28006 MADRID
Tel. 912 109 374 - Fax 912 500 063
E-mail: secretariageneral@asebio.com
ASECOS
Seguridad y Protección del Medio Ambiente, S.L. C/ Calderi, s/n - Ed. Cim Vallés, Planta 7, Oficinas 75-77 08130 SANTA PERPÈTUA DE MOGODA Barcelona Tel. 935 745 911 - Móvil 627 048 247
E-mail: marketing@asecos.es www.asecos.es
ASF Labmarketing Am Mühlebach 1 DE-79219 STAUFEN
Tel. +49 7633 923 42 10 - Fax +49 178 386 00 26
E-mail: asf@labmarketing.de www.labmarketing.de
Marcas representadas: La Gazette du Laboratoire (Francia y Magreb)
Asociación de Investigación y Centro Tecnológico de Miranda de Ebro Montaña, Parcelas R-60/61. Pol. Ind. de Bayas 9200 MIRANDA DE EBRO Burgos Tel. 947 331 515 - Fax 947 332 793
E-mail: acalvo@ctme.org www.ctme.org
Marcas propias: N/A
Marcas representadas: N/A
Assainissement Technique International, S.L. Roig Ventura, 117 1º 1ª 08226 TERRASSA Barcelona
Tel. 937 349 307 - Fax 937 351 856
E-mail: ati@ati-in.com www.ati-in.com
Marcas representadas: BIOSCIENCE, CRISON, CST INDUSTRIES, HACH-LANGE, LABBOX, LABPROCESS, MERCK, MICROCAT, PANREAC, PERMASTORE, THERMOSCIENTIFIC, VIDRAFOC, VWR
ASSI Sistemas e Instrumentacion, S.L. C/ Industria, 6 08320 EL MASNOU Barcelona Tel. 935400348 - Fax 935401639
E-mail: aina.cucurella@assi.es www.assi.es
Gerencia: Laura Sirerol Omedes
Dir. Nacional: Josep Maria Cucurella Dir. Técnico: Oscar Tomàs
Assocompositi
Piazza da Vinci, 32 IT-20133 MILANO
Tel. +39 02 23992467 - Fax +39 02 70638173
E-mail: ufficiostampa@assocompositi.it www.assocompositi.it
Astore
Via Tangoni, 26
IT-16030 CASARZA LIGURE Génova
Tel. +39 0185 470811 - Fax +39 0185 466894
E-mail: astore@astore.it www.astore.it
Astradur
Avda. San Julián 206 nave 7 Planta Baja. Pol. Ind. Congost 08403 GRANOLLERS Barcelona Tel. 938 495 700 - Fax 938 495 416
E-mail: astradur@astradur.es www.astradur.es
Asturfluid, S.L.
Área Industrial de Tabaza. Parcela 2 C2A
33469 CARREÑO Toledo
Tel. 985 514 066 - Fax 985 514 149
E-mail: asturfluid@asturfluid.com www.asturfluid.com
AT4 wireless, S.A.
Severo Ochoa, 2 29590 MÁLAGA
Tel. 952 619 100 - Fax 952 619 113
E-mail: bgarcia@at4wireless.com www.at4wireless.com
Auquime, S.A.
Galileo, 23-63
08028 BARCELONA
Tel. 934 901 440 - Fax 934 906 733
E-mail: auquime@auquime.com
Marcas representadas: KNF NEUBERGER, KNF FLODOS, ENGELSMANN
Auxilab, S.L.
Pol. Morea Norte, Calle D nº 6 31191 BERIAIN Navarra
Tel. 948 310 513
E-mail: correo@auxilab.es / comercial@auxilab.es www.auxilab.com
AxFlow, S.A.
Avd. de la Industria, 53 28108 ALCOBENDAS Madrid
Tel. 917 291 818 - Fax 917 292 491 E-mail: jffernandez@axflow.es www.axflow.es
Gerencia: Julio Alonso
Dir. Nacional: Julio Alonso
Dir. Comercial: Juan Francisco Fernández
Dir. Técnico: Sergio Garcia
Dir. Financiera: Mercedes Cámara
Marcas representadas: SEAL ANALYTICAL, ZEUTEC, LABORATORIOS DUJARDIN SALLERON
BAC Valves, S.A.
Tapís, 126 17600 FIGUERES Girona
Tel. 972 677 052 - Fax 972 511 199 E-mail: esteve.bernal@bacvalves.com www.bacvalves.com
Bacsa
Pol. Ind. Santiga. Flassaders, 13-15 - Tallers 2, Nave 1 08130 SANTA PERPÈTUA DE LA MOGODA Barcelona Tel. 902 101 183 - Fax 902 158 046
E-mail: bacsa@bacsa.es www.bacsa.es
Gerencia: José Mª Catalán
Dir. Técnico: Joan Martínez Gómez
Marcas propias: BACSA
Marcas representadas: PRECIA-MOLEN, DIBAL, BRUSS, TAMTRON
Bautermic, S.A.
Sant Francesc Xavier, 38 08950 ESPLUGUES DE LLOBREGAT Barcelona Tel. 933 711 558 - Fax 933 711 408
E-mail: c.gayete@bautermic.com www.bautermic.com
Gerencia: Félix de la Torre
Marcas propias: BAUTERMIC
Marcas representadas: BAUTERMIC
BC Aplicaciones Analíticas, S.L. Josep Anselm Clavé, 32-34 Local 2
08950 ESPLUGUES DE LLOBREGAT Barcelona Tel. 934 700 505 - Fax 933 718 616
E-mail: info@bcaplicaciones.com www.bcaplicaciones.com
Marcas propias: BC
Marcas representadas: HYGIENA, SENSILUX
Beko Tecnológica, S.L.
Primero de Mayo, 6
08980 SANT FELIU DE LLOBREGAT Barcelona
Tel. 936 327 668 - Fax 936 327 729
E-mail: info.es@beko.de www.beko-technologies.es
Marcas propias: CLEARPOINT®, DRYPOINT®, BEKOMAT®, BEKOKAT®, ÖWAMAT®, METPOINT®, BEKOSPLIT®
Bentley Instruments
840 RUE CURIE
FR-62161 MAROEUIL Pas-De-Calais
Tel. 0033 2 40 03 88 84 - Fax 0033 3 21 58 53 19
E-mail: flaine@bentleyinstruments.com www.bentleyinstruments.com
Gerencia: Pierre Broutin
Dir. Nacional: Pierre Broutin
Dir. de Administración: Philippe Roblin
Dir. Técnico: Adrien Cahot
Dir. de Marketing: Frédérique Lainé
Marcas propias: IBC-M
Marcas representadas: PATHOPROOF
Bercu Instruments, S.L.
Fermín Borrás, 27-29 08930 SANT ADRIÀ DE BESÒS Barcelona
Tel. 934 620 620 - Fax 934 620 795
E-mail: bercu1@coacb.com www.bercu-instruments.com
Gerencia: Andres Torralba
Berghof Products + Instruments GmbH
Harretstrasse 1
DE-72800 ENINGEN
Tel. +49 7121 894 0 - Fax +49 7121 894 300
E-mail: laboratorytechnology@berghof.com www.berghof.com
Binder GmbH
Im Mittleren Ösch 5
DE-78532 TUTTLINGEN
Tel. +49 7462 2005 0 - Fax +49 7462 2005 100
E-mail: info@binder-world.com
Sylke.Amelang@binder-world.com www.binder-world.com
Biometa, S.A.
Parque Tecnológico de Asturias. Parcela 38 33428 LLANERA Asturias
Tel. 902 244 343 - Fax 985 269 169
E-mail: info@biometa.es www.biometa.es
Marcas representadas: BUEHLER, RETSCH, PARR, LENTON, GALDABINI, HYSITRON, PARK SYSTEMS, FLUXANA
Biophyderm
244 Rue Claude François FR-34080 MONTPELLIER Tel. +33 467164763 - Fax +33 467032149
E-mail: contact@biophyderm.net www.biophyderm.net
Bioser, S.A.
Viriato, 47, pl. 14 - Edificio Numancia 1 08014 BARCELONA Tel. 932 264 477 - Fax 932 267 979
E-mail: bioser@bioser.com www.bioser.com
Marcas propias: BIOSER
Marcas representadas: 3M, TEPNEL, ROMER, BIOKAR, SDI, LDN, MICROBIAL, MICROGEN, ORION, PROGES PLUS, SENATE QA, VISTALAB
BioTek Instruments GmbH
Kocherwaldstr 34
DE-74177 BAD FRIEDRICHSHALL
Tel. +49 (0) 7136-9680 - Fax +49 (0) 7136-968 111
E-mail: drecker@biotek.de www.biotek.de
Blowair, S.L.
Valeta, 20 Bajos 1ª
08906 L’HOSPITALET DE LLOBREGAT Barcelona
Tel. 933 374 158 - Fax 933 372 851
E-mail: blowair@blowair.com www.blowair.com
Marcas propias: BLOWAIR
Marcas representadas: ROBUSCHI
Bombas Boyser, S.L.
Empordà, 3. Pol. Ind. La Borda
08140 CALDES DE MONTBUI Barcelona
Tel. 938 655 455 - Fax 938 655 456
E-mail: bombas@boyser.com www.boyser.com
Bombas Grundfos España, S.A. Camino de la Fuentecilla, s/n 28110 ALGETE Madrid
Tel. 918 488 800 - Fax 916 280 465
E-mail: marketinginfo-bge@grundfos.com www.grundfos.es
Marcas propias: GRUNDFOS
Bonsai Advanced Technologies, S.L. Avda. Valdelaparra, 27 28108 ALCOBENDAS Madrid
Tel. 914 902 334 - Fax 914 841 313
E-mail: marketing@bonsaiadvanced.com www.bonsaiadvanced.com
Marcas representadas: JOBIN YVON, HORIBA, MICROMERITICS INSTRUMENTS CORPORATION, SETARAM INSTRUMENTATION, ANALYTICAL SPECTRAL DEVICES
Borda Laboratorios
Avenida Yeseros 15, nave 12 28343 VALDEMORO Madrid
Tel. 915 733 042
E-mail: info@bordalaboratorios.net www.bordalaboratorios.net
Borel Swiss SA
Musiniere 19 CH-2072 ST BLAISE NE
Tel. +41 32 756 64 00 - Fax + 41 32 756 64 48
E-mail: mail@borel.eu www.borel.eu
Gerencia: F. Liebens
Dir. Nacional: Nicole Saponaro
Marcas propias: BOREL
Marcas representadas: AXRON
Bruker AXS GmbH
Oestliche Rheinbrueckenstr 49 DE-76187 KARLSRUHE
Tel. +49 (721) 595-2888 - Fax +49 (721) 595-4587
E-mail: Anja.Griessmeier@bruker-axs.de www.bruker-axs.de
Büchi Laboratory Equipment Meierseggstrasse 40 CH-9230 Flawil 1 Tel. +41 71 394 63 63 - Fax +41 71 394 64 64
E-mail: fitz.h@buchi.com www.buchi.com
Bulcase, S.A. Buen Suceso, 32 28008 MADRID Tel. 629464803
E-mail: bulcase@bulcase.com www.bulcase.com
Marcas representadas: FLIR, AHLBORN, BEHLMAN, SEAWARD, RIGEL, BLOWERDOOR GMBH
Burdinola, S. Coop. Ctra. de Lekeitio, km 53,5 48289 AMOROTO Vizcaya Tel. 946 840 766 - Fax 946 842 005
E-mail: burdinola@burdinola.com www.burdinola.com
Marcas propias: Burdinola
Bürkert Contromatic, S.A. Avda. Barcelona, 40 08970 SANT JOAN DESPÍ Barcelona Tel. 934 777 980 - Fax 934 777 981
E-mail: spain@burkert.com www.burkert.es
Marcas propias: BÜRKERT
Calibre Scientific Spain
C/ de la Mora, 47 08918 Badalona (Barcelona) Tel.+34 933 207 600
E-mail info@calibrescientific.es es.calibrescientific.com
Calvo Sealing, S.L.
Pol. Ind. Can Estella. Calle A, nº 13
08653 SANT ESTEVE DE SESROVIRES Barcelona Tel. 937 715 910 - Fax 937 715 319
E-mail: icpcalvo@icpcalvo.com www.icpcalvo.com
Camag (Switzerland)
Sonnenmattstr. 11
CH-413 MUTTENZ
Tel. +41 61 467 34 3 - Fax +41 61 461 07 0
E-mail: sales@camag.com www.camag.com
Marcas propias: CAMAG
Carburos Metálicos, S.A. - Grupo Air Products Av. de la Fama, 1 08940 CORNELLÀ DE LLOBREGAT Barcelona Tel. 902 13 02 02 - Fax 932 902 603
E-mail: oferta@carburos.com www.carburos.com
Gerencia: Ahmed Hababou Dir. Comercial: Javier Godoy Dir. RR.HH.: Francesc López Dir. de Marketing: Marta Rodríguez Marcas propias: CARBUROS METÁLICOS, CARBUROS MÉDICA Marcas representadas: AIR PRODUCTS
Carl Zeiss AG
Carl-Zeiss-Str. 22
DE-73447 OBERKOCHEN
Tel. +49 07364 20 0 - Fax +49 07364 20 6808
E-mail: d.hemmann@zeiss.es, s.schannewitzky@zeiss.de
Carl Zeiss Iberia, S.L. Ronda de Poniente 5 28760 Tres Cantos - MADRID Tel. 91 203 37 00 - Fax 91 203 37 01
E-mail: info.es@zeiss.com www.zeiss.es/micro Marcas propias: ZEISS
Carlo Erba Reagents, S.A. C/ Filadors, 35 6º 5ª 08206 SABADELL España T. +34 93 693 37 35 e-mail: info_es@cer.dgroup.it www.carloerbareagents.com
Carlos Árboles, S.A. Pol. Ind. Can Jardí. Comp. Narváez, 10 08191 RUBÍ Barcelona Tel. 935 860 780 - Fax 936 973 226 E-mail: info@carlosarboles.com www.carlosarboles.com
Gerente: Carlos Árboles Salas Dir. Comercial: Jeremy Loosdrecht
Marcas propias: ÁRBOLES
Casella España, S.A. Polígono Európolis. C/ Belgrado, 4B 28232 LAS ROZAS Madrid
Tel. 916 407 519 - Fax 916 360 196
E-mail: online@casella-es.com www.casella-es.com
Marcas propias: CASELLA CEL
Marcas representadas: CASELLA MEASUREMENT, INDUSTRIAL SCIENTIFIC, OLDHAM, SCOTT SAFETY, SINTROL, SIGNAL, WATCHGAS
CCI Control de Calidad Batista i Roca, 25. Pol. Ind. Pla d´en Boet 08302 MATARÓ Barcelona
Tel. 937 996 803 - Fax 937 992 139
E-mail: info@cci-calidad.com www.cci-calidad.com
Marcas propias y representadas: CCI
Cecil Instruments Limited
Milton Technical Centre, Cambridge CB24 6AZ
GB-CB24 6 CAMBRIDGE
Tel. +44 (0) 1223 42 - Fax +44 (0) 1223 42
E-mail: info@cecilinstruments.com www.cecilinstruments.com
Marcas propias: ADEPT, Q-ADEPT, IONQUEST, WAVEQUEST, AURIUS, AQUARIUS, REFLECTSCAN
Ceerem SA 1 Allée de la Filée
FR-44240 LA CHAPELLE SUR ERDRE
Tel. +33 240 842 539 - Fax +33 240 894 562
E-mail: franck.chatigny@ceeram.com www.ceeramtools.com
Gerencia: Benoît Lebeau
Dir. Comercial y de Exportación: Franck Chatigny
Dir. Técnica: Fabienne Loisy
Marcas propias: CEERAMTOOLS
Centork Valve Control, S.L.
Pº 110 Ipintza. Txatxamendi, 24-26 20100 LEZO Guipúzcoa
Tel. 943 316 137 - Fax 943 223 657
E-mail: actuator@centork.com www.centork.com
Centricast, S.A. Zudibiarte, 21 1409 OKONDO Álava
Tel. 945 898 042 - Fax 945 898 056
E-mail: centricast@centricast.com www.centricast.com
Cepexser, AIE
Avda. Ramon Ciurans, 40 08530 LA GARRIGA Barcelona
Tel. 938 704 208 - Fax 938 709 811
E-mail: cepex@cepex.com www.cepex.com
Chemlabor, S.L.
Polígono Asipo. C/ A Parcela 4, nave 7 33428 LLANERA Asturias
Tel. 985 732 293 - Fax 985 268 527
E-mail: info@chemlabor.es www.chemlabor.es
CHMLAB Group Finisterre 11A
08223 TERRASSA Barcelona
Tel. 935 128 750 - Fax 937 220 316
E-mail: info@chmlab.com www.chmlab.com
Gerencia: Martí Cebollero / Helena Buira
Marcas propias: CHM by CHMLAB
CISA - Cedacería Industrial, S.L. Àlaba, 56 Bis 08005 BARCELONA
Tel. 934 863 115 - Fax 934 863 116
E-mail: cisa@cisa.net www.cisa.net
Marcas propias: CISA
CMBE-Cial. Maquinaria y Bienes de Equipo, S.L. Vic, 5 Planta Baja
08173 SANT CUGAT DEL VALLÈS Barcelona
Tel. 935 892 060 - Fax 935 891 597
E-mail: cmbe@cmbe.es www.cmbe.es
Gerencia: Alex Aguilar
Marcas propias: CMBE
Marcas representadas: FORMECO, H2O, P.I.ECO, CEB IMPIANTI, CUSHION PACK, LAUPER, BANO, KRELUS
Cobos Precisión, S.L. Corominas, 5-7 2ª planta
08902 L´HOSPITALET DE LLOBREGAT Barcelona
Tel. 934 154 500 - Fax 934 156 607
E-mail: cobosprecision@telefonica.net www.balanzascobos.com
Gerencia: Rosario Barral
Dir. Comercial: Juan Carlos Cobos Dir. Técnico: Fco. Miguel Montalbán
Marcas propias: COBOS
Coesfeld GmbH & Co. KG
Tronjestr. 8
DE-44319 DORTMUND
Tel. +49 231 9129800 - Fax +49 231 179885
E-mail: mail@coesfeld.com www.coesfeld.com
Comecta, S.A. - Grupo Selecta
Autovía A-II, km 585,1
08630 ABRERA Barcelona Tel. 937 700 877 - Fax 937 702 362
E-mail: selecta@jpselecta.es www.jpselecta.es
Marcas propias: IVYMEN-COMECTA
Marcas representadas: HEIDOLPH, SIGMA, NABER, JENCONS, SMEG, PSI, BRA, TENAK, KNF, SEWARD
Comercial Labor, S.A.
Grases, 9-11
08004 BARCELONA
Tel. 934 246 225 - Fax 933 250 945
E-mail: octavi@comerciallabor.com www.comerciallabor.com
Marcas propias: NORMA
Marcas representadas: PAUL MARIENFLED-PRAT-DUMAS
Comercial Rafer, S.L.
Uncastillo, 19 50008 ZARAGOZA
Tel. 976 237 400 - Fax 976 217 152
E-mail: rafer@rafer.es www.rafer.es
Marcas representadas: JACOMEX, PLAS LAB, MITSUBISHI CHEMICAL, BELLINGHAN & STANLEY
Comercial Tecno, S.L.
Italia, 15-17
08100 MOLLET DEL VALLÈS Barcelona
Tel. 934 559 801 - Fax 934 352 430
E-mail: ctecno@eurocontrolsa.com
Comexglobal S.R.L.
Suipacha 472 - 1* P - OF 110
C1008AAJ BUENOS AIRES Argentina
Tel. 5,41143E+11 - Fax 5,41143E+11
E-mail: info@cmglobal.com.ar
Gerencia: Vicente Victor Frittella
Controltecnica, Equipos y Proyectos, S.L. C/ Artesanos, 7 28660 BOADILLA DEL MONTE Madrid
Tel. +34 916 613 004 - Fax +34 916 619 385
e-mail: comercial@controltecnica.com www.controltecnica.com/test www.controltecnica.com www.camarasclimaticas.com
Cosemar Ozono, S.L.
Jaime Meric, 3 28320 PINTO Madrid
Tel. 916 916 663 - Fax 916 920 664
E-mail: info@cosemarozono.es www.cosemar-ozono.com
Marcas propias: COSEMAROZONO, HOTELES SALUDABLES
Crison Instruments, S.A. Riera Principal, 34-36 08328 ALELLA Barcelona Tel. 935 409 320 - Fax 935 559 300
E-mail: crison@crison.es www.crison.es
Marcas propias: CRISON
CRUMA Laboratory equipment made in Barcelona Pol. In. Fonollar, Andorra, 19ª 08830 SANT BOI DE LLOBREGAT Barcelona Tel 933 706 162 - Fax 933 797 351 e-mail: comercial@cruma.es cruma.es
Marcas propias: CRUMA, AIREO Marcas representadas: BIOAIR
Crysforma (Institut Català d’Investigació Química) Avda. Països Catalans, 16 43007 TARRAGONA Tel. 977 920 238 - Fax 977 920 224 E-mail: ipunti@iciq.es www.iciq.es
Gerencia: Miquel A. Pericàs Dir. Técnicos: Lluís Solà, Jordi Benet-Buchholz Dir. de Marketing: Irene Puntí
Dara Pharmaceutical Packaging Pol. Ind. Can Illa. Pompeu Fabra, 23-25 08530 LA GARRIGA Barcelona Tel. 938 718 784 - Fax 938 718 375
E-mail: info@dara-pharma.com www.dara-pharma.com
David Spuch Calvar
Cernadas 6 3º H Parque Ofimático 15009 A CORUÑA Tel. 981 133 207
E-mail: dabiz@spuch.com www.spuch.com
Marcas propias: SPUCH, VEOLAB, QSINC
Deltalab, S.L.U.
Pol. Ind. La Llana. Plaza de la Verneda, 1 08191 RUBÍ Barcelona Tel. 936 995 000
E-mail: eurotubo@deltalab.es www.deltalab.es
Directora General: Pongsuda Pongtanya Empresas del grupo: DELTALAB, S.L., NIRCO, S.L. EQUILABO SCIENTIFIC, S.L.U.,ENVASES FARMACÉUTICOS, S.A. BICAPPALAB, S.R.L.
Dicsa
C/ Albert Einstein, 21 Parque Científico Tecnológico de Almería 04131 ALMERÍA
Tel. +34 950 553 333 e-mail: info@dicsa.es www.dicsa.es
Digimed Europe, S.L. Bonsoms, 1 (Local) 08028 BARCELONA
Tel. 934 787 225 E-mail: digimed@digimed-eu.com digimed-eu.com
Dimanlab, S.L. Avda. Bon Pastor, 159-163 08930 SANT ADRIÀ BESÒS Barcelona
Tel. 934 188 336 - Fax 934 188 387 E-mail: dimanlab@dimanlab.com www.dimanlab.com
Marcas propias: DIMANLAB
Dinter-Dinko
Encarnación, 123 08024 BARCELONA
Tel. 932 846 962 - Fax 932 104 307 E-mail: dinter@dinko.es www.dinko.es
Marcas propias: DINKO, SURCIS
Distribuciones Científicas Sanitarias Avda. Andalucía 27 1ºB 29006 MÁLAGA
Tel. 952 172 280
E-mail: info@dicisa.org www.dicisa.org
Marcas representadas: ROCHE DIAGNOSTICS, BLK, MEDICA, SCHARLAU, ICN, ASSAY DESIGNS, ADVANCE INSTRUMENTS, DIATRON, TECHNO MEDICA, JTBAKER, MICROKIT, HANNA, WHATMAN, FINE PCR, OVAN,GLW, FERMENTAS, SANTA CRUZ, etc.
Distrilab, S.L
Pol. Ind. Cabezo Beaza. Avda. Berlín, Parc H-3 Apdo. 2005 30353 CARTAGENA Murcia
Tel. 968 506 648 - Fax 968 529 901
E-mail: info@distrilab.net www.distrilab.net
Marcas representadas: SCHARLAB, BINDER, VARIAN, LEICA, KÖTTERMANN
Domnick Hunter Ibérica C/ de la Casa Nova, 5 08170 MONTORNÉS DEL VALLÈS Barcelona Tel. 935 720 050 - Fax 935 721 585
E-mail: dh.iberica@domnickhunter.com www.domnickhunter.com
Marcas propias: DOMNICK HUNTER, ZANDER Dycometal, Equipos de C.C., S.L. Parc d´Activitats de Viladecans. C/ De la Ciència, 35-37 08840 VILADECANS Barcelona
Tel. 936 526 610 - Fax 936 407 607
E-mail: dycometal@dycometal.com www.dycometal.com
Marcas propias: (Cámaras de ensayos climáticos, térmicos, corrosión y estanquidad)
E. Bachiller B., S.A. Pol. Ind. Levante. Can Guasch, 3 08150 PARETS DEL VALLÈS Barcelona
Tel. 935 730 770 - Fax 935 623 010
E-mail: ventas@bachiller.com www.bachiller.com
Gerencia: Eliseo Bachiller
Dir. Nacional y Comercial: David Bachiller Dir. de Exportación: Octavio Subero Dir. de Administración y Financiero: Celso Arcas
Dir. Técnico: Jordi Todó Dir. de Producción y RR.HH.: Carlos Megías
Ecogen, S.L.
Passatge Dos de Maig, 9 08041 BARCELONA
Tel. 934 502 601 - Fax 934 560 607
E-mail: ecogen@ecogen.com www.ecogen.com
Marcas propias: EG-ECOGEN
Ecutec Barcelona, S.L.
Gran Via Corts Catalanes, 701 3er 1ª A 08013 BARCELONA
Tel. 932 477 700 - Fax 932 477 701
E-mail: office@ecutec.eu www.ecutec.eu
Elecsoft, S.L.
Ballestera, 14-16 Local 4
08820 EL PRAT DE LLOBREGAT Barcelona
Tel. 933 704 973 - Fax 934 787 950
E-mail: comercial@elecsoft.com www.elecsoft.com
Marcas propias: VISUAL FACTORY
Electromediciones Kainos, S.A.
Energia, 56
08940 CORNELLÀ DE LLOBREGAT Barcelona
Tel. 934 742 333 - Fax 934 743 470
E-mail: kainos@kainos.es www.kainos.es
Marcas propias: KAINOS
Marcas representadas: CAMILLE BAUER, GOSSEN METRAWATT
Electrónica de Medida y Control, S.A.
Arturo Soria, 106,CH1 28027 MADRID
Tel. 913774459 - Fax 913 774 459
E-mail: emeco@ddnet.es www.emeco-sa.com
Gerencia: Ramón Martínez
Dir. Comercial: Ramón Martínez Ramos
Dir. de Administración: Concepcion Ramos
Elga Labwater
(Grupo Veolia Water Technologies)
Edificio Augusta Park. Avda. Vía Augusta, 3 - 11 08174 SANT CUGAT DEL VALLÈS Barcelona
Tel. 935 110 100 - Fax 935 110 109
E-mail: info.spain@veolia.com www.elgalabwater.com
Marcas propias: ELGA - VEOLIA WATER SOLUTIONS & TECHNOLOGIES
Emison
Art, 71 (Local Emison)
08041 BARCELONA
Tel. 934 552 314 - Fax 934 368 072
E-mail: marc@emison.com www.emison.com
Marcas propias: EMISON
Entesis Technology, S.L. Galileu, 313 08028 BARCELONA
Tel. 934 105 454 - Fax 934 199 733
E-mail: info@entesis.net www.entesis.net
Marcas propias: ENTESIS
Marcas representadas: PYRO-CONTROLE CHAUVIN ARNOUX, HITECH INSTRUMENTS, SUPER SYSTEMS, ADITEC, ARTHUR GRILLO, Tokai, Winner
Entorn, S.A. - Enginyeria i Serveis Guitard, 45, 5è 08014 BARCELONA
Tel. 934 914 826 - Fax 933 303 073
E-mail: entorn@entorn.com www.entorn.com
Eppendorf AG Barkhausenweg 1
DE-22339 HAMBURG
Tel. + 49 40 53 8010 - Fax + 49 40 53 801 556
E-mail: doerler.b@eppendorf.de, peplow.j@eppendorf.de www.eppendorf.de
Eppendorf Ibérica, S.L.U.
Avda. Tenerife, 2 Edificio 1 28703 SAN SEBASTIÁN DE LOS REYES Madrid
Tel. 916 517 694 - Fax 916 518 144
E-mail: eppendorf@eppendorf.es www.eppendorf.es
Marcas propias: EPPENDORF
Equipamiento Científico
Avda. Quitapesares, 8 Nave 8 28670 VILLAVICIOSA DE ODÓN Madrid
Tel. 916 165 814 - Fax 916 165 783
E-mail: datapaq-es@grupoeucon.com www.grupoeucon.com
Marcas propias: GASLAB
Equirepsa Colombia, 64 28016 MADRID Tel. 913 455 444 - Fax 913 505 168
E-mail: equirepsa@equirepsa.com www.equirepsa.com
Equitec
Blasco de Garay 57 28015 MADRID Tel. 915 449 262 - Fax 915449262
E-mail: info@equi-tec.eu www.equi-tec.eu
Gerencia: Alfonso Molina
Marcas propias: EQUITEC, FOCUS INSTRUMENTS
Equitrol, S.L. Cristobal Bordiu, 35 - 5º 28003 MADRID Tel. 915 351 461 - Fax 915 352 195
E-mail: equitrol@equitrol.com www.equitrol.com
Marcas representadas: DWYER, SIKA, KURZ, MICHELL INSTRUMENTS, MONITRAN, ROYCE, MONITOR, POLYSONICS, INTRA-AUTOMATION, PEECO, MERCOID, BW, BURKERT, SENSOR PRODUCTS
Erlab, S.L.
Pol. Ind. Sur Pasaje Newton, 3A 08754 EL PAPIOL Barcelona Tel. 936 732 474 - Fax 936 732 476
E-mail: ventas@erlab.net www.captair.com
Gerencia: Antoine Hauville
Dir. Comercial: Clotilde Cadot (España y Portugal) Dir. de Exportación: Vincent Vervoux (Europa) Dir. de Administración: Gloria Lahoz (España y Portugal) Dir. de Marketing: Giovanni Cuffaro
Marcas propias: CAPTAIR SMART, CAPTAIR BIO, CAPTAIR FLOW, HALO, HALO SENSE, FLEX, GREENFUMEHOOD, BIOCAP, FLOWCAP, PYRAMID, ASURA
ERP Selenne Synerplus
Paseo San Isidro N.10 Bajo A 13700 TOMELLOSO Ciudad Real
Tel. +34 926 093 015 - Fax +34 926 093 014
E-mail: esna@synerplus.es www.erp-selenne.es
Gerencia: Eduardo Sánchez
Dir. Técnico: Javier Lara
Marcas propias: ERP SELENNE
Esindus, S.A.
Avda. Manoteras, s/n Calle 3 28050 MADRID Tel. 917 670 966 - Fax 917 671 240
E-mail: esindus@esindus.es www.esindus.com
Expert System Solutions S.R.L.
Viale Virgilio 58/L IT-41123 MODENA
Tel. +39 0598860020 - Fax +39 0598860024
E-mail: info@expertsystemsolutions.com www.expertsystemsolutions.com
Marcas propias: MISURA®, TILE MASTER®, GLAZE MASTER®, BUDGET MASTER®
FAL Calzados de Seguridad, S.A.
Avda. de Logroño, 21 bis 26580 ARNEDO La Rioja
Tel. 941 380 800 - Fax 941 382 609
E-mail: info@falseguridad.es falseguridad.es
Fedelco, S.L.
Lago Constanza, 46
28017 MADRID
Tel. 914 081 625 - Fax 914 081 690
E-mail: informacion@fedelco.com www.fedelco.com
Marcas representadas: SPEX, REAGECON, ICL
Filtra Vibración, S.L.
Pol. Ind. Les Guixeres. Bronce, 1-3 08915 BADALONA Barcelona
Tel. 902 190 069 - Fax 902 190 070
E-mail: filtra@filtra.com www.filtra.com
Marcas propias: FILTRA
Filtros Anoia, S.A.
Camí de Baix, s/n
08776 SANT PERE DE RIUDEBITLLES Barcelona
Tel. 938 995 036 - Fax 938 997 172
E-mail: fanoia@fanoia.com www.fanoia.com
Marcas propias: FILTER-LAB
Marcas representadas: SARTORIUS
Filtros Ceta, S.L.U.
Orion, 16 - Parque Empresarial Las Cubiertas 28971 GRIÑÓN Madrid
Tel. 918 141 722 - Fax 918 141 721
E-mail: info@filtrosceta.com www.filtrosceta.com
Marcas propias: FILTROS CETA
Marcas representadas: FREUDENBERG ITALIA, O.R.V., HOLLINEE, ANDREAE
Fine Science Tools GmbH (FST) Vangerowstraße 14 DE-69115 HEIDELBERG
Tel. +49 62 21 90 50 50 - Fax +49 62 21 90 50 590
E-mail: europe@finescience.de www.finescience.com
Marcas propias: FST
Fisher Scientific C/ Anabel Segura, 16. Edif.2, Planta 3 Centro Empresarial Vega Norte 28108 ALCOBENDAS Madrid
Tel. 913 806 710
E-mail: es.fisher@thermofisher.com www.fishersci.es
Site Leader: Sr. Angel Barroso
Flores Valles, S.A. Isla Jamaica, 10 28034 MADRID
Tel. 913 581 818 - Fax 913 580 567
E-mail: madrid@floresvalles.com www.floresvalles.com
Marcas propias: FLORES VALLES
Fluidex
Gran Via, 13 5º 48001 BILBAO Vizcaya
Tel. 944 706 506 - Fax 944 220 061
E-mail: fluidex@fluidex.es www.fluidex.es
Fonderia Especial, S.A.
Pol. Ind. El Molí de la Bastida. C/ Collita, 13 08191 RUBÍ Barcelona
Tel. 935 861 233 - Fax 936 996 463
E-mail: fonderiaespecial@fondesal.com www.fondesal.com
Formimetal, S.L.
Ctra. Zaragoza - Huesca, km 9.6
50830 ZARAGOZA
Tel. 976 185 268 - Fax 976 180 150
E-mail: ventas@formimetal.com www.formimetal.com
Marcas propias: FORMIMETAL
Forns Hobersal, S.L.
Pol. Ind. El Pinatar. Pasaje Les Serres, s/n 08140 CALDES DE MONTBUI Barcelona
Tel. 938 626 104 - Fax 938 626 297
E-mail: hobersal@hobersal.com www.fornshobersal.com
Foss Electric España, S. Unipersonal Josep Tarradellas, 8-10 bajos 08029 BARCELONA
Tel. 934 949 940
E-mail: general@foss.es
Frances Micron España, S.A. Argenters, 7. Edificio II. Módulo CP. Parque Tecnológico del Vallés 08290 CERDANYOLA DEL VALLÈS Barcelona
Tel. 935 441 330 - Fax 936 754 868
E-mail: anna.manzanares@francesmicron.es
Marcas representadas: ALPINE, MICRON, STOTT, RIETZ, BEPEX, VRIECO NAUTA, SCHUGI, GÜNTER
Freeze-Cast Europa, S.L. Pol. Ind. Nicomedes García, D-2 40140 VALVERDE DEL MAJANO Segovia
Tel. 921 490 096 - Fax 921 490 174
E-mail: fysa@freeze-cast.com www.freeze-cast.com
Fritsch GmbH
Industriestrasse 8
D-55743 IDAR-OBERSTEIN Alemania Tel. +49 6784 70-0
E-mail info@fritsch.de www.fritsch.de/en
Gerente: Sebastian Fritsch
Dtor. Exportación: Maik Paluga
Marcas propias: PULVERISETTE, ANALYSETTE, LABORETTE
Fundigex
Gran Via, 13 5º
48001 BILBAO Vizcaya
Tel. 944 706 512 - Fax 944 220 061
E-mail: fundigex@fundigex.es www.fundigex.es

Fungilab, S.A. Constitució, 64 08980 SANT FELIU DE LLOBREGAT Barcelona
Tel. 936 853 500 - Fax 936 853 750
E-mail: sales@fungilab.com www.fungilab.com
Gaztelu Laboratorios Modulares
Ald. de Urquijo, 87 48013 BILBAO Vizcaya
Tel. 944 276 498 - Fax 944 416 873
E-mail: info@proquinorte.com www.proquinorte.com
Marcas propias: LAB MOBEL
Marcas representadas: AGILENT TECHNOLOGIES
GE Sensing & Inspection Technologies 35 Whitefield Rd. Stockton Heath. GB-WA4 6NA WARRINGTON. CHESHIRE Tel. +44 1925 604095
E-mail: david.jervis@ge.com www.ge.com
Gema Medical, S.L. Pol. Ind. Cadesbank. Segre, 6-7 08291 RIPOLLET Barcelona Tel. 935 808 477 - Fax 935 809 477
E-mail: info@gemamedical.com www.gemamedical.com
Gesfilter, S.L. Avenida Cerdanyola 92-94 Local B4 08173 SANT CUGAT DEL VALLÈS Barcelona Tel. 935 921 554 - Fax 936 914 518
E-mail: a.hernandez@gesfilter.com www.gesfilter.com
Gerencia: Andrés Hernández Montoya
Dir. Comercial: Andrés Hernández Montoya
Dir. de Administración: Teresa Arcos Escamez
Dir. Técnico: Andrés Hernández Montoya
Dir. RR.HH.: Marta Hernández Arcos
Dir. de Marketing: Javier Hernández Arcos
Marcas propias: GESFILTER
Marcas representadas: ROKI TECHNO, MICROFILTREX, AMAZON FILTERS, FUJIFILTER,
Gestión y Especificaciones Técnicas, S.L. Gran Via, 680 Àtic 08010 BARCELONA
Tel. 934 880 318 - Fax 934 873 236
E-mail: mireiacolomer@getsl.com www.getsl.com
Marcas representadas: TRESPA TOPLAB PLUS, TRESPA ATHLON
Gilson International BV (sucursal España) Avda. Castilla, 1. (Edificio Best Point ) Planta 1, Oficina 9.12 28830 SAN FERNANDO DE HENARES Madrid Tel. 916 781 772 - Fax 916 569 968
E-mail: sales-es@gilson.com www.gilson.com
Marcas propias: GILSON, ASPEC, PIPETMAN, MICROMAN, DISTRIMAN, DIAMOND TIPS
Marcas representadas: DIAMOND, DISTRIMAN, CONCEPT
Global Werbeagentur GmbH Nürnberg
Gleissbuehlstrasse 10 90402 Nürnberg
Tel. +49 (0) 911 / 20 185 - 0
Fax +49 (0) 911 / 20 185 - 185
E-mail: redaktion@global-werbeagentur.de www.global-werbeagentur.de
Gomensoro, S.A. Aguacate, 15 28044 MADRID
Tel. 915 086 586 - Fax 915 086 511
E-mail: marketing@gomensoro.net www.gomensoro.net
Marcas representadas: METROHM, ERWEKA, SPECTRO, MILESTONE, PP SYSTEMS, AUTOLAB, ATAGO, AMS ALLIANCE, SYLAB, ANKOM, NOVASINA, SYSTEA, BIOCHROM
Gram Precisión, S.L. Pallars, 65
08018 BARCELONA
Tel. 933 003 332 - Fax 933 006 698 E-mail: comercial@gram.es www.gram.es
Marcas propias: GRAM PRECISION, BLAUSCAL
Grupo Taper
Arbea Campus Empresarial Ed. 5 PB Ctra Fuencarral km 3’800 28108 ALCOBENDAS Madrid
Tel. 916 596 520 - Fax 916 610 084
E-mail: informacion@grupotaper.com www.grupotaper.com
Gerencia: José Manuel Varela
Dir. Técnica: Isabel Duque
Dir. Financiero: Miguel Ángel Maestro
Marcas representadas: THERMOSCIENTIFIC, KUBOTA, ZEISS, ADVANCED, ALEXIS, MPBIO, HITACHI, OMNI, KUNZ, ENZO, DNR, HITACHI, GILSON, MILLIPORE
Guemisa
Sta. Virgilia, 29 Local 28033 MADRID
Tel. 917 642 100 - Fax 917 642 132
E-mail: ventas@guemisa.com www.guemisa.com
Marcas propias: DPF SENSORS, PESACAM
Marcas representadas: DPF SENSORS, ZAHM
Hach Lange Spain, S.L.U. Larrauri, 1C- 2ª Pl. 48160 DERIO Vizcaya Tel. 902 131 441
E-mail: info-es@hach.com www.es.hach.com
Gerencia: Iñaki Zurutua
Marcas propias: HACH, LANGE, CRISON, BIOTECTOR, APPLITEK
Marcas representadas: RADIOMETER ANALYTICAL, SIGMA, BÜHLER, POLYMETRON, ASTRO
Hanna Instruments
Pol. Ind. Azitain. Parc. 3D 20600 EIBAR Guipúzcoa Tel. 943 820 100
E-mail: info@hanna.es www.hanna.es
Marcas propias: HANNA INSTRUMENTS
Hanseata, S.A. Almirante, 8 28004 MADRID
Tel. 915 318 218 - Fax 915 324 508
E-mail: info@hanseata.es www.hanseata.es
Marcas representadas: DEFENSOR, CONDAIR, DRAABE, CONTRONIC, CALOREX, DST, PURLINE, BRUNE, MICROCOOL
Haver & Boecker Telas Metálicas Avda. Les Bòbiles, 7 Casa 2 08850 GAVÀ Barcelona
Tel. 936 626 355 - Fax 936 629 059
E-mail: haverboecker@telefonica.net www.telas-metalicas.es
Marcas representadas: HAVER & BOECKER
Hellma Hispania, S.L. Gregal, 20 08917 BADALONA Barcelona
Tel. 934 656 818 - Fax 934 657 283
E-mail: hellma@infonegocio.com www.hellmahispania.com
Herter Instruments, S.L.
Caracas, 15 08030 BARCELONA
Tel. 933 468 203 - Fax 933 460 618
E-mail: herter@herter.es www.herter.es
Gerencia: Enrique Hernández
Dir. Comercial: David Hernández
Marcas propias: HERTER, VENTIX
Marcas representadas: ESCORT, DELTA OHM, LAMBRECHT, AIRFLOW, TSI, MOTIC, MILWAUKEE, ANRITSU, JRI, DOSTMANN ELECTRONIC, TFA, SCHWEIZER, DELTATRAK, DATATRACE, MADGETECH, SCHOTT
Hidracar, S.A.
Pol. Ind. Les Vives, s/n
08295 SANT VICENÇ DE CASTELLET Barcelona
Tel. 938 330 252 - Fax 938 331 950
E-mail: hidracar@hidracar.com www.hidracar.com
Gerencia: Manel Carcaré Gimeno
Dir. Comercial: Xavier Bosch
Dir. de Exportación: Xavier Bosch
Dir. de Administración: Antònia Pladevall
Dir. Técnico: Enric Ponsa
Dir. Financiera: Àngels Bernadich
Dir. de Producción: Mauricio Cobos
Dir. RR.HH.: Antonia Pladevall
Dir. de Marketing: Manel Carcaré
Marcas propias: HIDRACAR
Hidrolab, S.L.
Pg. Campollano, C - 10
02007 ALBACETE Albacete
Tel. 967 224 133 - Fax 967 222 061
E-mail: hidrolab@hidrolab.es
Hirschmann Laborgeräte GmbH & Co. KG
Postfach 11 53. Hauptstraße 7-15
DE-74246 EBERSTADT
Tel. +49 (0) 71 34 / 5 11-0 - Fax +49 (0) 71 34 / 5 11-990
E-mail: info@hirschmannlab.de www.hirschmannlab.de Marcas propias: SOLARUS®, PIPETUS®, OPUS®, CERAMUS®, ROTARUS®, MINICAPS®, RINGCAPS®, LABOPETTE®, ASPIRETTE®
HMC Europe GmbH
E-mail: info@hmc-europe.com
HRS-Spiratube, S.L.
Avda. Ciclista Mariano Rojas, 52 3ª Planta 30009 MURCIA
Tel. 968 201 488 - Fax 968 200 461
E-mail: info@hrs-spiratube.com www.hrs-spiratube.com
Huber
Werner-von-Siemens-Strasse 1 DE-77656 OFFENBURG
Tel. +49 781 9603-0 - Fax +49 781 57211
E-mail: info@huber-online.com www.huber-online.com
Humysec - 2000, S.L. Andrade, 84
08020 BARCELONA
Tel. 933 085 262 - Fax 933 085 262
E-mail: humysec@telefonica.net
Dir. de Administración: Ricardo Cardiel
Marcas representadas: DEFENSOR, CONDAIR, DRAABE, CALOREX, COTES, CONTRONICS, BRUNE, MICROCOOL
Iberfluid Instruments, S.A.
Cardenal Reig, 12
08028 BARCELONA
Tel. 933 333 600 - Fax 933 340 524
E-mail: vft@iberfluid.com www.iberfluid.com
Iberlab, S.L.
Pol. Ind. Cabeza Beazo. C/ Bucarest, Parcela 105 30204 CARTAGENA Murcia
Tel. 968 516 547 - Fax 968 314 011
E-mail: iberlab@iberlab.es www.iberlab.es
Marcas representadas: AUXILAB, AFORA, PYREX, PANREAC, GUINAMA, POBEL, EPPENDORF, ERLAB, MOBICLINIC, MEDICAL EXPRESS, SHARLAB, HENRY SHEIN, FILTROS ANOIA, FILALBET, LINEALAB, SCHOTT IBERICA, SPINREAC, CROMAKIT, KEMIA, BAYER, SELECTA, SARTORIUS, MERCK, CULTIMED, BIOSER, HANNA, SBS, OVAN, RAYPA, CRISON, REAGECON, BUNSEN, ALBET, WITEG, CRUMA, TELSTAR, MOTIC, HAMILTON, LABPROCESS, EUTECH, MN, ROCHE, OLIMPUS, LEYCA, TAPVAL, SYSMEX, ORTOALRESA, NIRCO, GILSON, THERMO, ZEISS.
Iberlaser, S.A. Avda. Pirineos, 7 2-8b 28700 SAN SEBASTIÁN DE LOS REYES Madrid
Tel. 916 586 760 - Fax 916 541 700
E-mail: info@iberlaser.com www.iberlaser.com
Ielab Calidad, S.L. Dracma, 16-18. Pol. Ind. Las Atalayas 03114 ALICANTE Alicante
Tel. 965 105 501 - Fax 965 105 503
E-mail: ielab@ielab.es www.ielab.com
Gerencia: Guillermo Pascual Gisbert Dir. Comercial: Joaquín Gil Escoda
Marcas propias: BACUALI, BACUANTI, IELABKITS
IKA-Werke GmbH & Co.Kg
Janke & Kunkel - Straße 10 DE-79219 STAUFEN
Tel. +49 7633 831 0 - Fax +49 7633 831 98
E-mail: sales@ika.de, fm@ika.de, ame@ika.de, sf@ika.de, mka@ika.de www.ika.net
Marcas propias: IKA
Ilmvac GmbH
Am Vogelherd 20 DE-98693 ILMENAU
Tel. +49 3877 604 0 - Fax +49 3677 604 11
E-mail: k.graefe@ilmvac.de www.ilmvac.com
Inbeat Equipos
Pol. Ind. Can Parellada. Júpiter, 53 08228 TERRASSA Barcelona
Tel. 937 852 516 - Fax 937 837 878
E-mail: inbeat@inbeat.es www.inbeat.es
INELTEC - Ingeniería, Automatismos e Instrumentación de Control, S.L. Pol. Ind. Les Goules. Metal·lúrgia, 9 08551 TONA Barcelona
Tel. 938 605 100 - Fax 938 717 463
E-mail: lorenzomarti@ineltec.es www.ineltec.es
Gerencia: Lorenzo Martí Constantí Dir. Nacional y de Marketing: Alfredo Volpini Dir. Comercial: Antolín Moro Dir. de Exportación: Romain Boyer Dir. Técnico y de Producción: Carlos Martí Dir. Financiero, de Administración y RR.HH.: Jordi Trilla Marcas propias y representadas: INELTEC
Infors AG
Rittergasse, 27 CH-410 BOTIMINGEN
Tel. +4161 425 7700 - Fax +416 1425 7701
E-mail: headquarter@infors-ht.com www.infors-ht.com
Infrico Medcare
CR CO · 762 Los Piedros
Las Navas, s/n 14900 LUCENA Córdoba
Tel. 34 957 59 51 14 - Fax 34 957 59 11 83
e-mail: info@infricomedcare.com www.infricomedcare.com
Ingeniería de Climas para Procesos, S.L. Caracas, 33-35
08030 BARCELONA
Tel. 933 878 989 - Fax 933 974 559 E-mail: sales@ingclimas.com www.ingclimas.com
Marcas propias: ING. CLIMAS-FOCUS-TECNOMED
Inoxtop, S.A.
Apdo. Correos 501 08240 MANRESA Barcelona
Tel. 938 773 307 - Fax 938 773 276 E-mail: inoxtop@inoxtop.com www.inoxtop.com
Gerencia: Antoni Macià Dir. Comercial: Marta Vila Dir. de Administración: Alba Serra Dir. Técnico: Ignasi Rafart Dir. de Producción: Jaume Padró Dir. RR.HH.: Sònia Roca
Instron a Divison of ITW Limited
Parc Tec. del Vallès. C/ Argenters, 2 edif 1 08290 CERDANYOLA DEL VALLÈS Barcelona Tel. 935 947 561 - Fax 935 920 760
E-mail: ventas@instron.com www.instron.com.es
Marcas propias: INSTRON, SATEC
Instrumatic Española, S.A. Avda. Toreros, 5 1ºB 28231 LAS ROZAS Madrid Tel. 915 558 112 - Fax 915 971 077 E-mail: instrumatic@instrumatic.es www.instrumatic.es
Marcas representadas: varias
Instrumentación Analítica, S.A. Penedés, 46 08820 EL PRAT DE LLOBREGAT Barcelona Tel. 934 787 161 - Fax 934 787 984 E-mail: barcelona@instru.es www.instru.es
Gerencia: Hugo Newby Dir. Comercial: Javier Portero Dir. Financiera: Susana Hernández
Marcas propias: INSTRAN
Marcas representadas: A.KRUSS, BROOKFILED, BIOSYSTEMS, CANNON INST. CENTEC, DEXSIL, ECOPHYSICS, ERALYTICS, GR SCIENTIFIC, ISL, ISCO, JULABO, KRUSS, MODERN WATER, ORION, SERVOMEX, SIEVERS, SONTEK, STANHOPE-SETA, TANAKA, WILKS, WTW, XOS, YSI
Instrumentos Físicos Ibérica, S.L. San Quintín, 47 Entlo. 3ª 08041 BARCELONA
Tel. 934 463 659 - Fax 934 463 660
E-mail: ifisicos@teleline.es www.ifi.es
Marcas representadas: THERMO, HAAKE, VACUUBRAND, ISMATEC, DATAPHYSICS, THASS, CAHN
Instrumentos Testo, S.A.
Zona Industrial C/ B nº 2
08348 CABRILS Barcelona
Tel. 937 539 520 - Fax 937 539 526
E-mail: info@testo.es www.testo.com
Gerencia: Roberto Javier Mestre Arenzana
Dir. Nacional: Roberto Javier Mestre Arenzana
Dir. Técnico: Jordi Mañé
Dir. RR. HH.: Susana Lucas
Dir. de Marketing: Meritxell Juncá
Marcas propias: TESTO
Marcas representadas: TESTO SE & Co. KGaA
Instrumentos Wika, S.A.
Josep Carner, 11-17
08205 SABADELL Barcelona
Tel. 902 902 577 - Fax 933 938 666
E-mail: info@wika.es www.wika.es
Marcas propias: WIKA
Instruserv Ltda.
Cl 51 NO 9 - 29 of 504
CO-00057 BOGOTÁ
Tel. 2558195 - Fax 2558195
E-mail: ventas@instruservltda.com www.instruservltda.com
Marcas representadas: SHIMADZU, PHOTOVAC, OPTIKA, KACIL, THERMO, NITON, SKYRAY, MARIENFELD
INTEGRA Biosciences AG
Tardisstrasse 201
CH-7205 ZIZERS Switzerland
E-mail: info@integra-biosciences.com
T. +41 81 286 95 30
Soporte técnico
E-mail: support@integra-biosciences.com
T. +41 81 286 95 11 www.integra-biosciences.com
Interket Ibérica Spain SLU Alameda Recalde, 27 5º 48009 BILBAO Vizcaya
Tel. 902 377 388 / 944 354 460 - Fax 944 354 466
E-mail: info.spain@intertek.com www.intertek.es
Gerencia: Byron Peasland
Dir. Comercial: Iñaki Gutierrez
Dir. de Exportación: Nerea de Miguel
Dir. de Administración: Mercedes Sanz
Dir. Financiera: Fátima Gortazar
Dir. RR.HH.: Jose Antonio Izaguirre Dir. de Marketing: Iker Albestain
Interstuhl
E-mail: H.Boehlefeld@interstuhl.de
IUCT
Álvarez de Castro, 63
08100 MOLLET DEL VALLÈS Barcelona
Tel. 935 793 432 - Fax 935 705 745
E-mail: iuct.sales@iuct.com www.iuct.com
Gerencia: Josep Castells
Dir. Nacional: Josep Castells Dir. Comercial: Ángeles Molina
IUL, S.A.
Torrent de l’Estadella, 22 08030 BARCELONA
Tel. 932 740 232 - Fax 932 740 144
E-mail: iul@iul-inst.com www.iul-inst.com
Izasa Scientific Aragoneses, 13 28100 ALCOBENDAS Madrid
Tel. 902 203 080 - Fax 902 203 081
E-mail: dac2@izasa.es www.izasa.es
J. Bonals, S.A. Oliverar, 6
08940 CORNELLÀ DE LLOBREGAT Barcelona
Tel. 934 714 580 - Fax 933 769 712
E-mail: jbonals@jbonals.es www.jbonals.com
Marcas propias: BONALS
Marcas representadas: RIVA
J. Jimeno S.A.
Pol. de Argales. C/ Vázquez de Menchaca, 1 Nave 12
47008 VALLADOLID
Tel. 983 202 342 - Fax 983 307 570
E-mail: jjimeno@jjimeno.com www.jjimeno.com
Marcas propias: JIMENO
Marcas representadas: KÖTTERMANN, THERMO, SELECTA, ORTO, LEICA, MILLIPORE, HACH-LANGE, PANREAC, MERCK, DELTALAB, CRISON, LABPROCESS, HANNA, ANTON PAAR, TECATOR, BÜCHI
J. P. Selecta, S.A.
Autovía A- II, km 585,1
08630 ABRERA Barcelona
Tel. 937 700 877 - Fax 937 702 362
E-mail: selecta@jpselecta.es www.jpselecta.es
Marcas propias: J.P. SELECTA
J.J. BCN Internacional, S.A. Orfeó Català, 7. Pol. Ind. Sud 08440 CARDEDEU Barcelona
Tel. 938 713 304 - Fax 938 713 272
E-mail: info@jjbcn.com www.jjbcn.com
JC Fábrica de Válvulas, S.A. Pol. Ind. Les Salines. Cantabria, 2 08830 SANT BOI DE LLOBREGAT Barcelona Tel. 936 548 686 - Fax 936 548 687
E-mail: sales@jc-valves.com www.jc-valves.com
JHRoerden y Cía, S.A. Avda. Alberto Alcocer, 38 7º izq 28016 MADRID Tel. 914 579 128 - Fax 914 586 046
E-mail: contacto@jhroerden.com www.jhroerden.com
Marcas representadas: KYOCERA, SOLARWORLD, REC SOLAR, SOLFOCUS, UNISOLAR, WURTH, AVANCIS, LORENTZ, FRONIUS, STECA, REFU, SOLARMAX
Julabo The Temperature Control Company Gerhard-Juchheim-Strasse, 1 77960 SEELBACH Alemania
T. +49 7823 510 - F. +49 7823 2491
E-mail info.de@julabo.com www.julabo.com
Ventas Tel. +49 7823 51-190 - Fax +49 7823 2491
e-mail info.de@julabo.com
Servicio técnico
Tel. +49 7823 51-66 - Fax +49 7823 51-99
E-mail service.de@julabo.com
Kern & Sohn GmbH
Ziegelei 1 DE-72336 BALINGEN
Tel. +49 74433 9933 0 - Fax +49 74433 9933 149
E-mail: katharina.faradacco@kern-sohn.com www.kern-sohn.com
Marcas propias: KERN
Kern Frío, S.L. Avda. Pau Casals, 61 08907 L’HOSPITALET DE LLOBREGAT Barcelona Tel. 933 661 025 - Fax 933 661 028
E-mail: info@kernfrio.com www.kernfrio.com
Marcas propias: Termovial, LIP
KGW-Isotherm Gablonzerstraße 6 DE-76185 KARLSRUHE
Tel. +49 721 95897 0 - Fax +49 721 95897 77
E-mail: info@kgw-isotherm.com www.kgw-isotherm.com/haendler.html
Kinematica AG Luzernerstrasse 147a
CH-6014 LITTAU-LUZERN
Tel. +41 41 259 65 65 - Fax +41 41 259 65 75
E-mail: cornelia.zurkirchen@kinematica.ch, Wolfgang. Niens@kinematica.ch, Christian.Niens@kinematica.ch www.kinematica.ch
Knauer Wissenschaftliche Geräte GmbH
Hegauer Weg 38 14163 BERLIN
Tel. +49 30 8097270 - Fax +49 30 8015010
E-mail: info@knauer.net www.knauer.net
Gerencia: Alexandra Knauer, Carsten Losch
Marcas propias: AZURA (UHPLC, HPLC, FPLC, SMBC), BLUESHADOW (OEM), PURITYCHROM, CLARITYCHROM, SEPAPURE (COLUMNAS FPLC)
Marcas representadas: Eurospher, ProntoSIL, SEDEX
KNF Neuberger GmbH
Alter Weg 3
DE-79112 FREIBURG
Tel. +49 (0) 7664 5909 9 - Fax +49 (0) 7664 5909 99
E-mail: info@knf.de, jim.findlay@knf.de, marketing@knf.de www.knf.com
Konik-Tech
Avda. Cerdanyola, 73
08172 SANT CUGAT DEL VALLÈS Barcelona
Tel. 935 902 840 - Fax 935 902 844
E-mail: sales@konik-group.com www.konik-group.com
Marcas propias: KONIK
Marcas representadas: ADIXEN, OPT, ASTORIA, KJL, UHV, KEDRON
Köttermann Systemlabor, S.A. Consuegra 7, 3ºC 28036 MADRID
Tel. 917 320 110 - Fax 917 320 111 E-mail: exploris.es@koettermann.com www.koettermann.de
Marcas propias: KÖTTERMANN
Krüss GmbH Equipos científicos de laboratorio Borsteler Chaussee 85 22453 HAMBURG Alemania
T. +49 (40) 514401-0
E-mail: info@kruss.de www.kruss-scientific.com
Labbox Labware, S.L. Migjorn, 1
08338 PREMIA DE DALT Barcelona
Tel. 937 552 084 - Fax 937 909 532
E-mail: clientes@labbox.com
Atención al cliente: clientes@labbox.com
T. +34 937 552 084 e-Commerce: www.labbox.es www.labbox.com
Marcas propias: LBX INSTRUMENTS, LABKEM, LBG, HDN CERAMICS, EPIBOX, EASY, BRANCHIA, CLINK, BB, ASTIK’S, LYNX, GRYNIA, GQUENCE Y METRIA
Labexchange Bruckstrasse 58
DE-72393 BURLADINGEN
Tel. +49 7475 9514 0 - Fax +49 7475 9514 44
E-mail: Diana.Maucher@labexchange.com, Wolfgang. Kuster@labexchange.com
Labolan, S.L.
Pol. Ind. Comerca 2 C/ A nº 47 31191 ESPARZA DE GALAR Navarra
Tel. 948 325 392 - Fax 948 325 186
E-mail: info@labolan.es www.labolan.es
Marcas propias: INDELAB, LAN-OPTICS, LAN-TECHNIC, LABOLAN, URA-TECHNIC
Marcas representadas: BANDELIN, BIOOPTICA,CONSORT, EDMUND BUHLER. GFL, SCIEPLAST,TKA, VELP SCIENTIFICA,VILBERT LOURMAT
Laborat, S.L.
C/ Fragua, 15 / Pol. Ind. Santa Ana 28522 RIVAS-VACIAMADRID
Tel. 915 021 655 - Fax 914 339 417
E-mail: laborat@laborat.com www.laborat.com
Laboratorios Aquilab
Mare de Déu de Gràcia, 31-bajo 12540 VILA-REAL Castellón
Tel. 964 500 365
E-mail: info@laboratoriosaquilab.com www.laboratoriosaquilab.com
Laboratorios Microkit, S.L.
C/ Puerto de Navacerrada, 30 28210 VALDEMORILLO Madrid
Tel. 918 974 616 - Fax 918 974 641
E-mail: microkit@microkit.es www.laboratoriosmicrokit.com
Gerente: Jorge Sanchís Solera
Marcas propias: MICROKIT, CRIOTECA, M-IDENT, PLAQUIS, SEILAGUA, DESINFECTEST, MUGPLUS, CHROMOSALM, CHROMOCYTOGENES, COLICULT, CRIOSTRAINS, KIT PRO-5S
Labortech Waldner, S.L.
Miguel Faraday 20 - Edificio B - 1ª pta. Of. B101
28906 MADRID
Tel. 913 758 468 - Fax 913 758 347
E-mail: info@waldner.com.es www.waldner.de
Gerencia: Mª Nieves Sainz-Maza
Dir. de Administración: Ana Viedma Dir. Técnico: Sergio Guerrero
Marcas propias: WALDNER
Labotrade Spain, S.L.
Avda. Cornellà, 140 2-A
08950 ESPLUGUES DE LLOBREGAT Barcelona
Tel. 934 700 832 - Fax 933 720 812
E-mail: jruizdealda@labotrade.com www.labotrade.com
Labprocess
Doctor Faus, 17-19
08328 ALELLA Barcelona
Tel. 935 406 033 - Fax 935 406 034
E-mail: info@labprocess.es www.labprocess.es
Marcas propias: XS
Marcas representadas: KNICK, HAMILTON, EUTECH, REAGECON
Lagi, S.L.
Pia du Cos, 5 08270 NAVARCLES Barcelona
Tel. 938 276 741 - Fax 938 276 741
E-mail: lagu@plasticslagi.com
Lana Sarrate, S.A.
Paseo Manuel Girona, 2 08034 BARCELONA
Tel. 932 800 101 - Fax 932 806 416 E-mail: lanasarrate@lanasarrate.es www.lanasarrate.es
Landes Poli Ibérica, S.L.
Bac de Roda, 171 08018 BARCELONA
Tel. 932 664 614 - Fax 933 030 707
E-mail: landespoli@landespoli.com www.landespoli.com
Dir. Comercial: Albert Vilaltella Prados Marcas representadas: MECMESIN BATY FLLI.ROTONDI ARI CLIMATS SAPRATIN AFFRI MATSUZAWA HIGHWOOD HOYTOM STIL ABERLINK
Lasing, S.A.
Julian Camarillo 26 28037 MADRID
Tel. 913 775 006 - Fax 914 073 624
E-mail: info@lasing.com www.lasing.com
Marcas propias: LASING
Marcas representadas: NEWPORT, SPECTRA-PHYSICS, ANDOR, ORIEL, BIOLIN SCIENTIFIC, NEW FOCUS, SEMROCK, GIGAHERTZ-OPTIK, BENTHAM, OPHIR, LOTIS, BIONAVIS, JPK, FIANIUM, EDINBURGH INSTRUMENTS
LAUDA DR. R. WOBSER GMBH & CO. KG
Laudaplatz 1 97922 LAUDA-KÖNIGSHOFEN Alemania
T. +49 (0) 9343 503-0
E-mail info@lauda.es jordi.nogues@lauda-iberica.es www.lauda.de
Leco Instrumentos, S.L.
Avda. de la Industria, 43 28760 TRES CANTOS Madrid
Tel. 918 031 250 - Fax 918 040 577
E-mail: leco@leco.es www.leco.com
Lee Company Rue Jean Bart, 24 FR-78960 VOISINS LE BRETONNEUX
Tel. +33 306642712 - Fax +33 130649126
E-mail: info@leecompany.fr www.leecompany.fr
Leica Microsistemas, S.A. Nicaragua, 46 5º 2ª 08029 BARCELONA
Tel. 934 949 530 - Fax 934 949 532
E-mail: lme.mail@leica-microsystems.com www.leica-microsistemas.es
Marcas propias: LEICA
Marcas representadas: NOVOCASTRA
Lenz-Laborglas GmbH & Co KG Am Ried 8 DE-97877 WERTHEIM
Tel. +49 9342 9609 0 - Fax +49 (0)9342 9609 30
E-mail: info@lenz-laborglas.de, eberhard@lenz-laborglas.de www.lenz-laborglas.de
Levantina de Laboratorios, S.L.
Manuel Simó, 43 Bajo 46018 VALENCIA
Tel. 963 786 922 - Fax 963 787 805
E-mail: levantina@levantinalab.com www.levantinalab.com
LGC Standards Salvador Espriu, 59 2º 08005 BARCELONA
Tel. 933 084 181 - Fax 933 073 612
E-mail es@lgcgroup.com www.lgcstandards.com
Marcas propias: LABOR LGC STANDARDS GMBH, BREITLANDER, LGC POLAND CHE, LGC GERMANY CRO, LGC GERMANY DE, DR. EHRENSTORFER, INDUSTRIAL ANALYTICAL, IARM PRODUCTS, LGC POLAND IBP, LGC POLAND IC, LGC MM STANDARDS, LGC (UK) (INCLUDING UK PRODUCED ER), LGC AMP LOGICAL PRODUCTS, LGC ETHANOL STANDARDS, LGC FOR PRODUCTS, LGCMIC PRODUCTS, LGC QUANT PRODUCTS, LGC AXIO PTS, MBH, TRC, VHG PRODUCTS.
Marcas representadas:ALCAN, ALCOA, ATCC, BAM, BCR, BIO PURE, BP, BRAMMER STANDARDS INC, CHROMADEX, CERILLIANT, CHEMPLEX INDUSTRIES, INC., LABORATORIO CIFGA S.A, CIL, CONOSTAN (SCP SCIENCE), CPA PRODUCTS, CYANO BIOTECH, FLUKA, FPC FRENCH PHARMAC, GUM, ICRM, IPO, IRMM, LARODAN, MEDICHEM, MUVA, NCS (BEIING NCS ANALYTICAL), NEOCHEMA, NIES, NIM PRODUCTS, NIST, NMIA, NATIONAL RESEARCH CANADA, ENVIRONMENT CANADA (NW), PARAGON DX, PRG, PSL, REAGECON, RTC, SERO, SPEX CERTIPREP, SPL PRODUCTS, STANHOPE SETA, STARNA SCIENTIFIC, SUS ULRICH NELL, DE-TOX PRODUCTS, WEPAL, WHO, WHITEHOUSE SCIENTIFIC.
Lidering, S.A.U.
Pg. Ferrocarrils Catalans, 106-108 08940 CORNELLÀ DE LLOBREGAT Barcelona Tel. 93 480 44 11 - Fax 934 804 404
E-mail: info@lidering.com www.lidering.com
Dir. Técnica: Montse Grandal
Marcas propias: LIDERING, GLOSTER, GLOSTER-FLON, GLOSTER-PACK, LIDERING EXPRESS
Marcas representadas: EAGLEBURGMANN, TAMAR SEALS, HALLITE, ST.GOBAIN, GAPI, WEICON
L.Q.C., S.L.
Av. Girona 72 bx 17130 L’ESCALA Girona Tel. 902 889 342 - Móvil 607 071 196
E-mail: info@lqc.es www.lqc.es
Luis Frechilla, S.L.
Ricardo Montes, 42 Bajo 33012 OVIEDO Asturias
Tel. 985 291 582 - Fax 985 112 447
E-mail: frechilla.sl@telecable.es www.frechillasl.es
Gerencia: Iván Frechilla García
Dir. Técnico: Iván Frechilla García
Marcas representadas: ORTOALRESA, RAYPA, ALAMO, HANNA INSTRUMENTS, ETC.
Lumaquin, S.A.
Avda. del Riu Mogent, 18. Concentración Industrial Vallesana 08170 MONTORNÈS DEL VALLÈS Barcelona
Tel. 902 106 527 - Fax 935 722 674
E-mail: lumaquin@lumaquin.com www.lumaquin.com
Gerencia: Manuel Villarroya
Marcas propias: LUMAQUIN, LUMARE, LUMACLEAN
Marcas representadas: ELEKTRO PHYSIK, RK PRINT, VMA GETZMANN, ZEHNTNER, TQC, SDL ATLAS, LENETA, COLORLITE, AQUA TOOLS, PLASTI LAB, TROY, SELECTA, COBOS, HACH LANGE, COMECTA
Luwa Española, S.A.
Gran Via, 184 5º 3ª 08038 BARCELONA
Tel. 932 988 980 - Fax 934 319 999 E-mail: info@luwa.es www.luwa.es
M.A.D. Apparecchiature Scientifiche, Srl. M.A.D. IBÉRICA
Puig i Pidemunt, 28 1º 2ª (Pol. Ind. Plà) 08302 MATARÓ Barcelona
Tel. 937 586 245 - Fax 937 414 529 E-mail: iberica@optikamicroscopes.com www.optikamicroscopes.com
Marcas propias: OPTIKA MICROSCOPES
Mab Industrial, S.L.U. Córcega, 117 08029 BARCELONA
Tel. 934 308 301 - Fax 934 195 879 E-mail: mabindustrial@mab.es www.mabindustrial.es
Marcas representadas: BROOKFIELD, CAFRAMO, LEICA y otras.
Macoga, S.A. Leira, s/n 15680 ORDENES A Coruña
Tel. 981 680 000 - Fax 981 680 238 E-mail: macoga@macoga.com www.macoga.com
Manema, S.A.
Camino Artana. Pol. Ind. Pinella, nave 28 12540 VILA-REAL Castellón
Tel. 964 360 478 - Fax 964 361 065 E-mail: manema@manema.com www.manema.com
Maquinsa (Materiales Técnicos Maquinsa, S.L.)
Joaquín Sorolla, 74 28529 RIVAS VACIAMADRID
Tel. 914 990 210 - Fax 914 992 409 E-mail: mqrivas@maquinsa.info www.maquinsa@maquinsa.info
Marcas propias: SANITECH, TECNYFOOD, SILIPRESS
Marcas representadas: SAINT GOBAIN, BACOU, ANSELL
Marelli, S.A. Bombas Ercole
Ctra. Madrid-Toledo, km 30,8 45200 ILLESCAS Toledo
Tel. 925 511 200 - Fax 925 511 600
E-mail: marellipumps@marellipumps.com marellipumps-com
Maselli Ibérica
C/ Colom, 451-453 Nave C40 08223 TERRASSA Barcelona
Tel. 902 425 000 - Fax 935 507 383
E-mail: info@maselliberica.com www.maselliberica.com
Gerencia: Albert Barneda
Marcas propias: MASELLI MISURE
Matelco, S.A.
C/ Molinot nº 57. Polígono CAMI RAL
08860 CASTELLDEFELS Barcelona
Tel. 625 550 716
E-mail: comercial@matelco.es www.matelco.es
Gerencia: Xavier Oliveras
Dir. Comercial: Francisco Serrano
Dir. Técnico: Javier Minelli
Marcas propias: MATELCO
Marcas representadas: SWAN, NEO MONITORS, ADOS, SIERRA, CONTROL INSTRUMENTS
Mathias, S.L.
Roger de Flor, 293 1ª
08025 BARCELONA
Tel. 934 588 100 - Fax 932 076 315
E-mail: comercial@mathiasbcn.com www.mathiasbcn.com
Marcas representadas: NOVASINA, INTERSCIENCE
Mdmil Sciences Group, S.L.
Mestre Falla, 34
08440 CARDEDEU Barcelona
Tel. 938 455 344 - Fax 938 455 344
E-mail: marketing@smartechbiosciences.com http://www.smartechbiosciences.com
Gerencia: Miquel Calvo
Dir. Nacional: Miquel Calvo
Dir. Comercial: Miquel Calvo
Dir. de Exportación: Miquel Calvo
Dir. de Administración: Joana
Dir. Financiera: Joana
Dir. RR.HH.: Joana
Dir. de Marketing: Joana
Marcas representadas: LIOFILCHEM, OVAN, DELTALAB
Memmert GmbH + Co. KG
Auessere Rittersbacher Strasse 38
91126 SCHWABACH Alemania
Tel. +49 (0) 9122/925-0 - Fax +49 (0) 9122/14585
E-mail sales@memmert.com
Metalúrgica Zaes, S.L.
Dolores Almeda, 12
08940 CORNELLÀ DE LLOBREGAT Barcelona
Tel. 933 774 671 - Fax 933 778 608
E-mail: zaes@zaes.es www.zaes.es
Metrofísica, S.L.
Menéndez y Pelayo, 140 bis 08223 TERRASSA Barcelona
Tel. 937 315 858
E-mail: metrofisica@metrofisica.com www.metrofisica.com
Marcas propias: SAMIS-win, MS
Metrohm AG
Oberdorfstrasse 68
CH-9101 HERISAU
Tel. +41 71 353 8585 - Fax +41 71 353 8901
E-mail: info@metrohm.com www.metrohm.com
Metrotec, S.A.
Pº Ubarburu 113. Pol. 27 Martutene 20014 SAN SEBASTIÁN Guipúzcoa Tel. 943 470 007 - Fax 943 470 273
E-mail: comercial@metrotec.es www.metrotecgroup.com
Gerencia: Ernesto Jiménez
Dir. Comercial: Ernesto Jiménez
Dir. de Exportación: Javier Jiménez
Dir. Técnico: Joxe Mari Azkune
Dir. Financiero: José Ángel Jiménez
Dir. de Producción: David Pérez
Dir. RR.HH.: Juan José Eizaguirre
Marcas propias: METROTEC, GESLAB, METROTEST, LYNX
Marcas representadas: TINIUS OLSEN, SATRAHAMPDEN, LABTHINK, GURLEY, SHIMPO, IGT, SARTORIUS, AT2E, DOSER,
Mettler Toledo, S.A.E.
C/ Segrià 7-9
08940 CORNELLÀ DE LLOBREGAT Barcelona
Tel. +34 900 922 550 E-mail mtemkt@mt.com www.mt.com
Microciencia, S.A. Montnegre, 2-6
08029 BARCELONA
Tel. 934 105 856 - Fax 933 210 507
E-mail: microciencia@microciencia.com www.microciencia.com
Marcas representadas: KYOWA, UNION, LABOMED, BMS, SHIBUYA, LINKAM, SYNCROSCOPY, SYNBIOSIS, X-LOUPE
Micronic Europe BV Platinastraat 51 8211 AR. P.O. Box 604 8200 AP LELYSTAD Tel. +31 320 277070
E-mail: sales@micronic.com www.micronic.com
Miele - Centre Calvet Calvet, 32 08021 BARCELONA Tel. 932 008 710 - Fax 934 142 563
Marcas propias: MIELE
Miele, S.A. Ctra. de Fuencarral, 20 28108 ALCOBENDAS Madrid Tel. 916 232 000 - Fax 916 620 266
E-mail: miele@miele.es www.miele.es
MIL, S.L. Camarena, 304 local posterior 28047 MADRID Tel. 916 461 966 - Fax 917 198 805
E-mail: mant.labora11@mi.madritel.es www.milsl.com
Millipore Ibérica, S.A. Avda. Burgos, 114 28050 MADRID Tel. 901 516 645 - Fax 902 011 644
E-mail: iberica@millipore.com www.millipore.com
Marcas propias: MILLEX, MILLI-Q, DURAPORE, OPTICAP, VANTAGE, PROSEP, STERITEST
Modelos y Maquinaria de Fundición Pol. Ind. Lekunberri, 8A 31870 LEKUNBERRI Navarra Tel. 948 604 663 - Fax 948 604 672
E-mail: mym@mymcasting.com www.mymcasting.com
Modulabo, S.L. Doctor Velázquez, 3 28224 POZUELO Madrid Tel. 916 110 001 - Fax 916 190 613
E-mail: modulabo@modulabo.com www.modulabo.com
Gerencia: Pedro Olmos
Marcas propias: TECLAB, MULTIPLO
Montero - Fibras y Elastómeros, S.A. Barrio el Juncal, s/n. Edif. Fuentes 2º. Local 11 48510 VALLE DE TRÁPAGA Vizcaya Tel. 944 180 011 - Fax 944 189 183
E-mail: access@monterofye.com www.monterofye.com
Munters Spain, S.A. Europa Empresarial. Ed. Londres. C/ Playa de Liencres, 2 28290 LAS MATAS Madrid Tel. 916 400 902 - Fax 916 401 132
E-mail: marketing@munters.es www.munters.es
Dir. Comercial: Jesús Fernandez Dir. Técnico: Jose Guzmán
Dir. Financiero: Pablo Ruiz
Dir. de Marketing: Ana Pérez-Bustamante Marcas propias: MUNTERS AB
Nabertherm GmbH
Bahnhofstr. 20 DE-28865 LILIENTHAL
Tel. +49 (04298) 922 0 - Fax +49 (04298) 922 129
E-mail: contact@nabertherm.es www.nabertherm.es
National Instruments Spain
Rozabella, 2 Edif. Berlín 1ª Planta 28230 LAS ROZAS Madrid Tel. 916 400 085 - Fax 916 400 533
E-mail: ni.spain@ni.com www.ni.com/spain
Marcas propias: labVIEW, NI -DAQ, CVI
Net Interlab, S.A.L. San Marcelo, 14 posterior 28017 MADRID Tel. 914 047 514 - Fax 914 041 563
E-mail: central@net-interlab.com www.net-interlab.com
Marcas representadas: BIOTAGE SWEDEN AB: CROMATOGRAFÍA - PURFICACIÓN - MICROONDAS PARA SÍNTESIS - CHEMSPEED AG: REACTORES AUTOMATIZADOS PARA SÍNTESIS. GENEVAC TECNOLOGIES: EVAPORADORES CENTRÍFUGOS EN VACÍO - EXTRACCIÓN, PURIFICACIÓN. AND INSTRUMENTS LTD: BALANZAS DE PRECISIÓN E INDUSTRIALES. BIONISIS OPLC: CROMATOGRAFÍA LAMINAR - EMTEC: INVESTIGACIÓN PAPEL. MUTEK (DISTRIBUIDOR) ANALIZADORES PAR INVESTIGACIÓN PAPEL. ANTON PAAR AG (DISTRIBUIDOR AUTORIZADO): DENSÍMETROS LAB Y ON-LINE - VISCOSÍMETROS. FOSS TECATOR (DISTRIB. AUTORIZADO): ANÁLISIS EN ALIMENTACIÓN, DETERMINACIÓN PROTEINAS, GRASA, FIBRAS. BUCHI (DISTRIB. AUTORIZADO): ROTAVAPORES,SISTEMAS DE VACÍO, ATOMIZADORES, PUNTO FUSIÓN. CRISON INSTRUMENTS: TITRADORES, PH-METROS, CONDUCTIVIDAD, TERMÓMETROS, ETC. ILMVAC GMBH: BOMBAS DE VACÍO, ROTATIVAS, DIFUSORAS, TURBOMOLECULARES, ETC. THYRACONT AG: MEDIDORES DE VACÍO, CONTROLADORES, TRANSDUCTORES. CULATTI AG: MICROMOLINOS
netSteril S.L.
C/ Masia, 40-42 08110 MONTCADA I REIXAC Barcelona Tel. +34 935 554 063 - Fax +34 935 183 757 e-mail: info@netsteril.com www.netsteril.com
Director de Negocio: Jordi Net
Director Técnico: José Fernández
Marcas representadas: LYTZEN, PROTAK SCIENTIFIC, SALAMANDER U, SOLIDFOG, STERIXENE, SYNTEGON
Nippon Gases España, S.L.U. C/ Orense, 11 28020 MADRID Tel. 914 533 000
e-mail: info.spain@nippongases.com http://nippongases.com/es
Nirco, S.L.
Pol. Ind. Can Salvatella. Avda. Salvatella, 4 8210 BARBERÀ DEL VALLÈS Barcelona Tel. 937 180 808 - Fax 937 182 338
E-mail: nirco@nirco.com www.nirco.com
Marcas propias: DASLAB
Marcas representadas: NUAIRE, HERMLE, NICHIRYO, GLW, BIOSAFE, GRANT, BOEKEL, PBI, DRUMMOND, JULES RICHARD INSTRUMENTS, SORENSON, TOMY, TERMAKS, DON WHITLEY SCIENTIFIC, SCIENTIFIC INDUSTRIES
Normalab, S.L. Fundición, 4 bis Nave 22 28531 RIVAS-VACIAMADRID Madrid
Tel. 914 992 379 - Fax 914 992 379
Ögussa - Österreichische Gold- und SilberScheideanstalt Ges.m.b.H. AT-1235 WIEN
Tel. +43 1 866 46 0
E-mail: Frederic.Marguet@oegussa.at
Olympus Iberia, S.A.U. Plaza Europa, 29 - 31 08908 L’HOSPITALET DE LLOBREGAT Barcelona
Tel. 902 444 204 - Fax 93 241 46 95
E-mail: informacion.micro@olympus-europa.com www.olympus.es
Marcas propias: OLYMPUS
Omadisa Industrias del Laboratorio, S.A. Milanos, 6 Naves 9 y 12
28320 MADRID Madrid
Tel. 913 316 810 - Fax
E-mail: central@omadisa.net www.omadisa.net
Marcas propias: OMADISA, DISELABOR
Orbinox, S.A. Pol. Ind. Anoeta, s/n 20270 ANOETA Guipúzcoa
Tel. 943 698 030 - Fax 943 653 066
E-mail: orbinox@orbinox.com www.orbinox.com
Ortoalresa C/ Los Frailes 121
28814 DAGANZO DE ARRIBA Madrid
Tel. 918 844 016 - Fax 918 844 423
E-mail: marketing@ortoalresa.com www.ortoalresa.com
Gerencia: Penelope Álvarez
Marcas propias: ORTOALRESA
Ovan Equipos Laboratorio (Suministros Grupo Esper S.L.)
Pol. Ind. Bonavista. Pintor Roig i Soler, 14 8916 BADALONA Barcelona Tel. 934 657 002
E-mail: info@ovan.es www.ovan.es
Gerencia y dir. Comercial: J.C.Serra
Dir. Nacional: Silvia Borrás Dir. de Exportación: Silvia Borras Dir. Técnico: Antonio Cuesta
Marcas propias: OVAN, AXTOR
PANalytical B.V. Sucursal en España
José Silva, 3 - 4º B
28043 MADRID
Tel. 918 261 450 - Fax 915 100 415
E-mail: jose.m.alegre@panalytical.com www.panalytical.es
Marcas propias: PANALYTICAL
Panreac Química, S.L.U.
Pol. Pla de la Bruguera. C/ Garraf, 2 08211 CASTELLAR DEL VALLÈS Barcelona
Tel. 937 489 400 - Fax 937 489 401
E-mail: info.es@itwreagents.com www.itwreagents.com
Gerencia: Joan Roget Alemany
Marcas propias: PANREAC APPLICHEM, DERQUIM, VINIKIT, AQUAMETRIC
Marcas representadas: MACHEREY-NAGEL
Pedro Gil, S.L.
Pol. Ind. Vallmorera. Salvador Albert i Riera, 9 08339 VILASSAR DE DALT Barcelona
Tel. 937 537 171 - Fax 937 537 300
E-mail: ventas@pedrogil.com www.pedrogil.com
Pekos Valves, S.A.
Rec del Molinar, 9 08160 MONTMELÓ Barcelona
Tel. 935 799 370 - Fax 935 579 244 E-mail: valvulas@pekos.es www.pekos.es
Penox Engineering
Carrer L, 20 08040 BARCELONA Tel. 933 350 149 - Fax 933 357 071
E-mail: engineering@penox.de, coplosa@coplosa.es www.penoxgroup.com
PerkinElmer España, S.L.
Ronda de Poniente, 19 Edif. Fiteni VI 28760 TRES CANTOS Madrid
Tel. 918 061 200 - Fax 918 040 414
E-mail: atencionalcliente@perkinelmer.com www.perkinelmer.es
Marcas propias: PERKINELMER
Pesos M.B.M., S.L.
Puigcerdà, 225 08020 BARCELONA
Tel. 933 467 355 - Fax 933 467 355
E-mail: info@pesosmbm.com www.pesosmbm.com
Peter Huber Kältemaschinenbau AG
Werner-von-Siemens-Strasse 1
77656 OFFENBURG Alemania
Tel. +49 781 9603-0 - Fax +49 781 57211
E-mail info@huber-online.com www.huber-online.com
Gerencia: Daniel Huber, Benedikt Huber, Joachim Huber, Beatrice Geiler, Bärbel Huber
Pfeiffer Vacuum GmbH
Berliner Straße 43 DE-35614 ASSLAR
Tel. +49 (0) 6441 802 0 - Fax +49 (0) 6441 802 202
E-mail: a.fiore@filusch-fiore.de, sabine.trylat@presse. pfeiffer-vacuum.de www.pfeiffer-vacuum.de
Polyco Iberial, S.L. Gaskoinen, 2-2 20280 HONDARRIBIA Guipúzcoa Tel. 943 645 341 - Fax 943 646 140
E-mail: ventas@polyco.es www.polyco.co.uk Marcas representadas: SUPERGLOVE
Polymer Standards Service-USA, Inc. 43 Jefferson Blvd. Suite 3 US-02888 WARWICK Rhode Island Tel. 401-780-8884 - Fax 401-780-8824
E-mail: info@pssgpcshop.com pssgpcshop.com
Gerencia: Michael Gray
Dir. Comercial: Craig Silverman Dir. de Marketing: Clara Trimmer Marcas propias: PSS
Prisma Mecánica, S.L. Pol. Ind. Sota el Molí. C/ del Telègraf, 1-7 08160 MONTMELÓ Barcelona Tel. 934 621 154 - Fax 934 621 274 E-mail: sales@prisma.es www.prisma.es
Promolab - Mobiliario Técnico de Laboratorio, S.L.
Ronda de Poniente, 2 1º Puerta L 28760 TRES CANTOS Madrid Tel. 918 062 240 - Fax 918 031 536
E-mail: promolab@promolab.es www.promolab.es
Protón Pallars, 85 6º 5ª 08018 BARCELONA Tel. 933 092 369 - Fax 933 003 669
E-mail: proton@sefes.es
Qiagen
E-mail: Veronique.Voss@qiagen.com www.qiagen.com
Quilinox, S.L. C/ Louis Pasteur, 4 46980 PATERNA Valencia Tel. 902 304 316 - Fax 902 364 960 E-mail: quilinox@quilinox.com www.quilinox.com
Gerencia y Nacional: Francisco Quiles Dir. Comercial: Alberto Tellechea Dir. de Exportación: Francisco Quiles Dir. Técnico: Fernando Marí Dir. Financiera: Vanesa Carmona Dir. de Marketing: Javier Olucha
Marcas propias: QLX
Marcas representadas: GECI, ABSCISSE, CSF INOX, OMAC, AZZINI, DOCKWEILER, PBM, MBS, BARDIANI, GRACO, RAMEX, BRECONCHERRY, METAGLAS, RATTIINOX, INOX FER, G-FLOW, BOYER, ADVANCED COUPLING LIMITED, LANTHALUX, SERVINOX, ECOMETEO, entre otras.
Quimipol J. Blanch Ferrer, S.L. Pol. Ind. Monsolis. Balmes, 139-145 08930 SANT ADRIÀ DE BESÒS Barcelona Tel. 934 620 565 - Fax 934 622 375
E-mail: quimipol@quimipol.com www.quimipol.com
Marcas propias: QUIMIPOL
Quimivita, S.A. División Laboratorio
C/ Balmes, 245 08006 BARCELONA Tel. 938 484 610 - Fax 938 484 625
E-mail: iampuero@quimivita.com www.quimivita.es
Marcas propias: QUIMIVITA MICROBIOLOGÍA
Marcas representadas: CARLO ERBA, CARL ROTH, BÜRKLE, BOCHEM, DISTELL,SILVERSON, ULTAG, KOEHLER, SAMPLING SYSTEMS, CHM LAB, BIOLAB VISC, COPLEY, KYOWA, GBX AW, ABDOS LIFE SCIENCE
R-Biopharm España, S.A.U
Manzanos, 4
28700 SAN SEBASTIÁN DE LOS REYES Madrid
Tel. 902 903 355 - Fax 916 548 992
E-mail: info@r-biopharm.es
Marcas representadas: R-BIOPHRAM RHONE LTD.
R. Espinar S.L.
Pol. Ind. Els Bellots. Avda. del Vallès, 322 08227 TERRASSA Barcelona
Tel. 937 830 720
E-mail: raypa@raypa.com www.raypa.com
Marcas propias: RAYPA,TERRA FOOD-TECH
Rectus Tema, S.L.
Avda. Real de Pinto, 87. Módulo 2 Nave E 28021 VILLAVERDE ALTO Madrid
Tel. 913 835 022 - Fax 915 053 474
E-mail: info@rectustema.es www.rectus.de
Marcas propias: RECTUS-TEMA, NYCOIL
Reichelt Chemietechnik GmbH + Co. Englerstr. 18
DE-69126 HEIDELBERG
E-mail: eholzhofer@rct-online.de www.rct-online.de
Representaciones Eduardo Muñiz, S.L. Puerto Pajares 4, bajo 33420 LUGONES Asturias
Tel. 985 732 128 - Fax 985 732 129
E-mail: logistica@rem-sl.com www.rem-sl.com
Representaciones Jürgen Appenrodt Laurel, 15. Urb.
46900 TORRENTE Valencia
Tel. 961 571 746 - Fax 961 560 623
E-mail: appenrodt@xpress.es www.acp-micron.com
Marcas representadas: ACP (Alemania)
Retsch GmbH
Retsch-Allee 1-5
42781 HAAN Alemania
Tel. +49 2104 2333-100 - Fax +49 2104 2333-199
E-mail info@retsch.es www.retsch.es
Riera Nadeu, S.A. Pol. Ind. Coll de la Manya. C/ Cal Ros dels Ocells, parc. 8 naves 1-2 08400 GRANOLLERS Barcelona
Tel. 938 407 072 - Fax 938 407 085
E-mail: comercial@rieranadeu.com www.rieranadeu.com
Gerencia: Marc Riera Domènech
Dir. Comercial: Ricard Fenollosa Domènech
Dir. Técnico: Daniel Terol Pinos
Dir. Financiero: Josep Mª Guil Domènech
Marcas propias: RINA, RINA-JET, RINA-BIOTECH
Marcas representadas: EUROPEAN SPRAYDRY TECHNOL. CELSIUS
Romero Muebles de Laboratorio, S.A. Verano, 17. Pol. Las Monjas
28850 TORREJÓN DE ARDOZ Madrid
Tel. 902 209 219 - Fax 902 102 992
E-mail: romero@romero.es www.romero.es
Gerencia: Felipe Romero
Marcas propias: ROMEROTECH, MOVITECH
Marcas representadas: DYNAMICFLOW
Rubilabor, S.L.
Murcia, 36-38
08191 RUBÍ Barcelona
Tel. 935 882 515 - Fax 935 881 948
E-mail: joana@rubilabor.com www.rubilabor.com
S.A. de Hornos Automáticos
Bordeus, 35 entlo. 1ª
08029 BARCELONA
Tel. 933 100 161 - Fax 933 100 246
E-mail: info@hornosautomaticos.com www.hornosautomaticos.com
Dir. Técnico: César Álvaro
Marcas propias: SAHA
Sarstedt, S.A.U
Pol. Ind. Valldoriolf. Camí de Can Grau, 24 08430 LA ROCA DEL VALLÈS Barcelona
Tel. 938 464 103 - Fax 938 463 978
E-mail: info.es@sarstedt.com www.sarstedt.com
Sartorius AG
Weender Landstrasse 94-108
DE-37075 GOETTINGEN
Tel. +49 551 308 0 - Fax +49 551 308 3289
E-mail: dominic.grone@sartorius.com www.sartorius.com
Sartorius Stedim Spain, S.A.U. Isabel Colbrand, 10 -12 Oficina 70. Pol. Ind. de Fuencarral
28050 MADRID
Tel. 913 586 092 - Fax 913 589 623
E-mail: montse.garcia@sartorius-stedim.com www.sartorius-stedim.com
Marcas propias: SARTORIUS STEDIM, SARTORIUS STEDIM BIOTECH
SCAT Europe GmbH
Opelstraße 3
DE-64546 MÖRFELDEN-WALLDORF
Tel. +49 06105 320 200 - Fax +49 06105 320 201
E-mail: mecke@scat-europe.com, johann.rittgasser@scat-europe.com www.scat-europe.com
Marcas propias: SCAT EUROPE GMBH, SAFETYCAPS, SAFETYWASTECAPS
Scharlab, S.L. C/. Gato Pérez, 33. Pol. Ind. Mas d’en Cisa
08181 SENTMENAT Barcelona
Tel. 93 745 64 00 - Fax 93 715 27 65
e-mail: consultas@scharlab.com www.scharlab.com
Chairman: Werner Scharlau Director gerente: Pedro Gallego
Science Basic Solutions, S.L. - SBS, S.L. Xaloc, 2
08203 SABADELL Barcelona
Tel. 937 484 599 - Fax 937 273 739
E-mail: sales@websbs.com www.websbs.com
Marcas propias: SBS
Sensotran, S.L.
Avda. Remolar, 31
08820 EL PRAT DE LLOBREGAT Barcelona
Tel. 934 785 842 - Fax 934 785 592
E-mail: sensotran@sensotran.com www.sensotran.com
Gerencia: Marc Delgado
Marcas propias: SENSOTRAN
Marcas representadas: RAE, BIONICS
Servibombas, S.L. Avda. Pompeu Fabra, 75-77
08820 EL PRAT DE LLOBREGAT Barcelona
Tel. 934 786 343 - Fax 934 786 339
E-mail: servibombas@servibombas.com www.servibombas.com
Serviquimia, S.L.U.
Dinamarca, s/n Pol. Ind. de Constantí 43120 CONSTANTÍ Tarragona Tel. +34 977 524 477
E-mail serviquimia@serviquimia.com www.serviquimia.com
Directora General: Núria Batet
Marcas representadas: AIT FRANCE, AQUALYTIC/LOVIBOND, ASEM, AVANTOR (JT BAKER), BETTER BASICS, BIOKAR, BRAND, BÜRKLE, CHEM-LAB, CYTIVA EUROPE GMBH, DELTALAB, DWK LIFE SCIENCE GMBH (DURAN), EXACTA, GVS, HAIER, HANNA, HELLMA, HENKE-SASS, HUBER, IKA WERKE GMBH & CO.KG, ISOLAB, LABORGERÄTE GMBH, KAKUHUNTER, KERN & SOHN GMBH, KOÜMER, LAB LOGISTICS GROUP (LLG), LABMIX 24, LIEBHERR, MACHEREYNAGEL, MEMMERT, MERCK – MILLIPORE – SIGMA – MILLIQ - SUPELCO, MIELE, NABERTHERM, NEDERMAN, OHAUS, REAGECON, RAYPA, SCAT, SMEG, SPEX CERTIPREP, SPEX SAMPLE PRERP, WASSERLAB, WHATMAN, XYLEM ANALYTICS GERMANY (WTW)
Shodex, Showa Denko Europe GmbH Konrad-Zuse-Platz 3 (Baviera)
DE-81829 MUNICH
Tel. +49 89 9399 6237 - Fax +49 89 9399 6277 34
E-mail: Solsona@sde.de www.shodex.es
Gerencia: Atsuo Takai
Sistemas Electrónicos de Detección y Análisis, S.L. - SEDA Pº Ferrocarriles Catalanes, 27 Bajos 08940 CORNELLÀ DE LLOBREGAT Barcelona Tel. 933 774 601
E-mail: info@sedasl.es www.sedasl.es
Gerencia: Nuria Florenza
Dir. de Administración: Marian López
Dir. Técnico: David Edo
Marcas representadas: SYSTRONIK, GMI, CROWCON, YUKON, SENSEAIR, BACHARACH (MSA)
Sistemas y Tecnología Ribas, S.L. - SISTEC Prat de la Riba, 16 08150 PARETS DEL VALLÈS Barcelona Tel. 935 730 950 - Fax 935 730 995
E-mail: sistec@sis-tec.com www.sis-tec.com
Marcas representadas: GEMS SENSORS, WEKA, BETA, MAGNETROL, MPL, RCM, DYNASONICS, KEP, PMA,

Socorex Isba, S.A.
Chemin de Champ-Colomb, 7a 1024 ECUBLENS/LAUSANNE (Suiza)
Tel. +41 21 651 6000
E-mail socorex@socorex.com www.socorex.com
Spectro Hispania, S.L.
P. A. E. Asuarán, Edificio Enekuri, nave 9 48950 ERANDIO (Asua) Vizcaya Tel. 944 710 401 - Fax 944 711 741 E-mail: comercial@spectro.es www.spectro.com
Gerencia: Guillermo Lecumberri Marcas representadas: SPECTRO
Spetec GmbH
Am Kletthamer Feld 15 85435 ERDING Baviera
Tel. +49 8122 95909-0 - Fax +49 8122/95909-55
E-mail: spetec@spetec.de https://www.spetec.de/es/ Marcas propias: CLEANBOY®, SUSI®
Starna Scientific Ltd. 52/54 Fowler Road Hainault, Essex IG6 3UT Tel. 4,42085E+11 - Fax 4,42085E+11 E-mail: sales@starna.com www.starna.com
Gerencia: Nathan Hulme
Steris Iberia, S.A. Caléndula, 95 Miniparc II
28109 EL SOTO DE LA MORALEJA Madrid
Tel. 916 585 920 - Fax 916 250 115
E-mail: gregorio_kaklis@steris.com www.steris.com
Sugelabor, S.A. Sicilia, 36 28038 MADRID
Tel. 915 013 936 - Fax 915 013 938
E-mail: info@sugelabor.com www.sugelabor.com
Surcis, S.L.
Encarnación 125, bajos 08024 BARCELONA
Tel. 932 194 595 - Fax 932 104 307 E-mail: eserrano@surcis.com www.surcis.com / www.environmental-expert.com
Marcas propias: RESPIROMETROS BM: BM-EVO, BM.EVO2, BM-ADVANCE, BM-ADVANCE2, BM-ADVANCE PRO, BM-ADVANCE PRO2INE
Marcas representadas: SURCIS, INSITE, DINKO
Swag, S.L. Software para el Laboratorio Mayor, 63 Izq. 08170 MONTORNÉS DEL VALLÈS Barcelona Tel. 935 721 746 - Fax 935 722 076 E-mail: swag@swaglab.com www.swaglab.com
Symta, S.L.L.
San Máximo, 31 28041 MADRID Tel. 915 002 060 - Fax 915 000 045
E-mail: info@symta.com www.symta.com
Dir. Comercial: Arturo Allende
Dir. Financiero: Roberto Fernández
Marcas propias: SYMTA
Marcas representadas: BIOTAGE, HICHROM, ACE, LABSCAN, QUADREX, DR.EHRENSTORFER, VICI VALCO, J.G. FINNERAN, HPC, SHODEX, LABKINGS, SILICYCLE, KINESIS, COLE PALMER, AVANTOR, HILICON, ZODIAC, COSMICSIL
T.T.V., S.A.
Severo Ochoa, 11
28914 LEGANÉS Madrid
Tel. 916 857 365
E-mail: valvulas@ttv.es www.ttv.es
Tecan Group Ltd.
Seestrasse 103 CH-8708 MÄNNEDORF
Tel. +41 44 922 81 11 - Fax +41 44 922 81 11
E-mail: Tobias.Haessner@tecan.com schuch@henkes-schuch.de www.tecan.com
Tecan Ibérica Instrumentación, S.L. Sabino de Arana, 32
08028 BARCELONA
Tel. 934 900 174 - Fax 934 112 407
E-mail: helpdesk.spain@tecan.com www.tecan.com
Tecfluid, S.A.
Narcís Monturiol, 33 08960 SANT JUST DESVERN Barcelona
Tel. 933 724 511 - Fax 934 734 449
E-mail: tecfluid@tecfluid.com www.tecfluid.com
Gerencia: Jordi Picazo Dir. Nacional: Raúl Hernández
Dir. de Exportación: Miguel Ángel Reina
Marcas propias: TECFLUID
Tecil
Lope de Vega, 99-101
08005 BARCELONA
Tel. 933 086 333 - Fax 933 084 871
E-mail: info@tecil.com www.tecil.com
Marcas propias: TECIL
Marcas representadas: ADVANCED, SPIRAL BIOTECH, MEDICA, MAXMAT, DIATRON, DIAGON, BAKER, RNA
Tecnium - Casals Cardona Industrial, S.A. F. Casablancas, 24 08243 MANRESA Barcelona
Tel. 938 748 480 - Fax 938 757 668
E-mail: tecnium@tecnium.es www.tecnium.es
Gerencia: Pere Casals
Dir. Nacional: Vicente Soriano
Dir. Comercial: Vicente Soriano
Dir. de Exportación: Vicente Soriano
Dir. de Administración: María Casals
Dir. Técnico: Carlos Ortega
Dir. Financiera: María Casals
Dir. de Producción: David Llussà
Dir. de Marketing: Jordi Pedrola
Marcas propias: TECNIUM
Tecnokroma
Camí de Can Calders, 14 08173 SANT CUGAT DEL VALLÉS Barcelona
Tel. +34 93 674 88 00
E-mail: comercial@teknokroma.es www.tecnokroma.es
Tecno Química Veyca, S.L.
Pol.Ind.Villalonquejar C/ López Bravo nº5, Naves CAM 48-49
09001 BURGOS
Tel. 947 225 553 - Fax 947 236 034
E-mail: veyca@veyca.net
Marcas representadas: PANREAC, LINEALAB, COBOS, MEDOP, PYREX, SELECTA, SCHOTT, BRAND, CRISON
Tecnología para Diagnóstico e Investigación (TDI, S.A.)
José Echegaray, 8 P.A.E. Casablanca I 28100 ALCOBENDAS Madrid
Tel. 916 624 473 - Fax 916 624 469
E-mail: juanfer@tdi.es www.tdi.es / www.euroaire.com
Marcas propias: EUROAIRE
Tecnoquim, S.L.
Pol. Ind. Oeste. Avda. Principal, Parcela 29/28
30169 MURCIA
Tel. 968 880 298 - Fax 968 880 417
E-mail: calidad@tecnoquim.es www.tecnoquim.es
Gerencia: T. Bernal
Dir. Comercial: Gonzalo Madrid
Dir. de Administración: F. Balsalobre
Dir. de Producción: Víctor Madrid
Dir. de Marketing: R. Madrid
Marcas propias: TQTECH, TQCHEM
Marcas representadas: ATAGO, HANNA, INFRICO, KERN, MEMMERT, ORTO, SELECTA, SMEG, TELSTAR, TESTO WASSERLAB
Tecny Fluor (Materiales Tecny Fluor, S.L.)
Paseo Joan Miró, 10 Local 1 08222 TERRASSA Barcelona
Tel. 937 361 030 - Fax 937 361 031
E-mail: tecnyfluor@tecnyfluor.com www.tecnyfluor.com
Tecop, S.A. Oro, 52. Pol. Ind. Sur 28770 COLMENAR VIEJO Madrid Tel. 918 457 402 - Fax 918 464 898
E-mail: sales@tecopsa.com www.tecopsa.com
Tecval, S.L. Pol. Ind. Can Torrella. Berlín, 1 Nave 4 08223 VACARISSES Barcelona Tel. 938 280 055 - Fax 938 280 174
E-mail: export@tecval.es www.tecval.es
Telstar Technologies, S.L. Avda. Font i Sagué, 55. Parc Científic i Tecnològic Orbital 40 08227 TERRASSA Barcelona Tel. 937 361 600 - Fax 937 859 342
E-mail: telstar@telstar.eu www.telstar.eu
Marcas propias: Telstar
Marcas representadas: UIC GMBH, FLEXICON, WEILER, GECIL,CBS, PLANNER, CHART, ACP, GASPROFI
Tema Maquinaria, S.A. Narváez, 39 28009 MADRID Tel. 915 733 904
E-mail: temamaquinaria@fontventa.com www.tema-trisa.es
Marcas representadas: SIEBTECHNIK, TEMA PROCESS, STEINHAUS
Testing Lab Equipments, S.L. Calle Emilio Alzamora, 27 28009 LEGANÉS Madrid Tel. 918 273 484
E-mail: info@testinglab.es www.testinglab.es
Marcas propias: EQUITEC Y FOCUS INSTRUMENTS
Thermo Fisher Scientific SLU
Anabel Segura, 16 Edif 2 Planta 3 - Centro Vega Norte 28108 ALCOBENDAS Madrid Tel. 914 845 965 - Fax 914 843 598
E-mail: analyze.es@thermo.com www.thermofisher.com
Marcas propias: THERMO SCIENTIFIC
Tintometer GmbH
Schleefstr. 8-12 DE-44 287 DORTMUND Tel. +49 231 94510 0 - Fax +49 231 94510 20
E-mail: Matthias.Ostermann@Tintometer.de, helmut. reber@tintometer.de www.tintometer.de
Tiselab - Soluciones GMP para la industria biofarmacéutica y afines
Albareda, 6-8 Entlo. 08004 BARCELONA Tel. 933 220 636 - Fax 934 416 590
E-mail: info@tiselab.com www.tiselab.com
Gerencia: Santi Tintoré Dir. de Marketing: Mar Tintoré
Marcas representadas: GETINGE LIFE SCIENCES, LA CALHÈNE, LINAC, SGM BIOTECH, SHIELD MEDICARE, NITRITEX, G.S. ANDERSON, ANDERSON INSTRUMENT, STERIDOSE, POLIFLUX, STERIVALVES, LANCER, BIOVIGILANT
Titan Eko, S.L. Sucursal en España Lino, 8 1º C 28020 MADRID Tel. 915 715 690 - Fax 915 715 644
E-mail: titan@titan-ltd.es www.titan-ltd.es
Marcas representadas: TITAN
Tolquimex, S.L. Hernisa II, 16 45007 TOLEDO Toledo Tel. 925 230 020 - Fax 925 230 872
E-mail: tolquimex@retemail.es
Trallero & Schlee, S.L.
Mollet, 14
08120 LA LLAGOSTA Barcelona
Tel. 934 360 609 - Fax 934 504 109
E-mail: comercial@tralleroschlee.com www.tralleroschlee.com
Gerencia: Ángel Trallero Marcas propias: SCHLEE
Transmecánica J.A.I., S.L. Pol. Lapatza. C/ Araztoi, 5 48970 BASAURI Vizcaya
Tel. 944 014 312 - Fax 944 014 315
E-mail: transmecanica@transmecanica.com www.transmecanica.com
Trelleborg Izarra S.A.U. San Vicente, 25 1440 IZARRA Álava
Tel. 945 437 000 - Fax 945 437 007
E-mail: izarra@trelleborg.com www.trelleborg.com/expansionjoints
TROX España, S.A. Ctra. Castellón, km 7 50720 ZARAGOZA
Tel. 976 500 250 - Fax 976 500 904
E-mail: trox@trox.es www.trox.es
Gerencia: Jorge Aznar
Dir. Técnico: Javier Aramburu Dir. Financiero: José Antonio Carcas Dir. de Producción: Manuel Braña Marcas propias: TROX TECHNIK
USB Europe GmbH
Hauptstrasse 1 DE-79219 STAUFEN
Tel. +49 (0)76 33 - 933 40 0 - Fax +49 (0)76 33 - 933 40 20
E-mail: tmengel@usbweb.de www.usbweb.com
Utilcel - Técnicas de Electrónica y Automatismos, S.A. Espronceda, 176-180 08018 BARCELONA
Tel. 934 984 465 - Fax 933 06 993
E-mail: tce@utilcell.es www.utilcell.es
Vacuubrand GmbH + CO KG Alfred-Zippe-Str. 4 97877 WERTHEIM Alemania
Tel. +49 9342 808 5550 - Fax +49 9342 808 5555 e-mail: info@vacuubrand.com www.vacuubrand.com
Valves Entreprise S.L. / S.V.R. Las Mercedes, 23 6º Edif. El Abra 1 48930 LAS ARENAS (Getxo) Vizcaya Tel. 944 643 922 - Fax 944 316 758 www.valvesentreprise.es
Válvulas VS, S.L. Pol. Ind. Santelices, Nave B-2 48550 MUSKIZ Vizcaya Tel. 944 801 642 - Fax 944 802 385 www.valvulasvs.com
Vamein de España, S.A. Pol. Ind. Tres Cantos. Temple 1 28760 TRES CANTOS Madrid Tel. 918 034 517 - Fax 918 035 769 E-mail: comercial@vamein.es www.vamein.es
Gerencia: Valentín Almodovar Gracia
Marcas propias: VAMEIN
Varian Ibérica, S.L.
Avda. Pedro Díez, 25 28019 MADRID Tel. 914 727 612 - Fax 914 725 001
E-mail: marketing.es@varianinc.com www.varianinc.com
Marcas propias: VARIAN
Veolia Labwater España Electrodo, 52. Pol. Ind. Santa Ana 28522 RIVAS VACIAMADRID Madrid Tel. 916 604 000 - Fax 916 667 716
E-mail: hector.castro@veoliawater.com www.elgalabwater.com, www.purelabflex.com
Marcas propias: ELGA LABWATER
Verder Scientific Iberia, S.L. Polígono Industrial Azitain 3A 20600 EIBAR (Gipuzkoa) Tel. 843 93 02 93
E-mail: info.vsib@verder.com
Director general: Haritz Elexpuru
Director comercial: Aratz Akarregi
Marcas Propias: RETSCH, MICROTRAC, QATM, CARBOLITE, ELTRA
Vertex Technics, S.L. Comercio, 12-14 Bajos
08902 L’HOSPITALET DE LLOBREGAT Barcelona
Tel. 932 233 333 - Fax 932 232 220
E-mail: vertex@vertex.es www.vertex.es
Marcas representadas: DIONEX, CEM, ISCO_TELEDYNE, CALIPER, SHELLAB, HACH, PACIFIC, MET ONE, HIAC ROYCO, ANATEL, NIPPON INST., ZINSSER, DISTEK, ORANGE, SPECTRUM, SKC, GRIMM, GASTEC, INDUSTRIAL SCIENTIFIC-OLDHAM, METROSONICS-QUEST, BIOS, PPM, TSI, LARSON DAVIS, LOOK LINE, SPILLTECH
Vestilab, S.A. - Clean Room Control
Ctra. Rubí-Terrassa, BP 1503 km 19,4
08228 SANT QUIRZE DEL VALLÈS Barcelona
Tel. 937 363 510 - Fax 937 363 511
E-mail: info@vestilab.com www.vestilab.com
Vidra Foc, S.A.
C/ dels Almogàvers, 182-186 08018 BARCELONA
Tel. 933 093 566 / 933 093 750 - Fax 933 009 766
E-mail info@vidrafoc.com www.vidrafoc.com
Administradora: Mª Teresa Ferrer Ortuño Marcas propias: VIDRA FOC
Marcas representadas: ALFA AESAR, A&D INSTRUMENTS, ANTON PAAR, ANSELL HEALTH CARE, ASECOS, AXIGEN, BERMAN, BINDER, BIOMERIEUX, BIOSER, BOHLENDER, BRAND, BROOKFIELD, BÜCHI, BÜRKLE, CARLOS ARBOLES, CHROMACOL, CISA, COBOS, CONDALAB, CORNING, CRISON, CRUMA, DELTALAB, DELTA OHM, DRÄGER, DR. EHRENSTORFER, DURAN GROUP, ELMA, EPPENDORF, EDQM, EQUITEC, EUROMEX, FILTERLAB, FILTRA VIBRACIÓN, FLUKA, GENERAL ELECTRIC, GILSON, GOSSELIN, HAAKE, HACH-LANGE, HAHNEMÜHLE, HALDENWANGER, HAMILTON, HANNA INSTRUMENTS, HEIDOLPH, HELLMA, HETTICH, HOBERSAL, HONEYWELL, HUBERLAB, IKA, ISMATEC, JOSE COLLADO, JULABO, KARTELL, KERN, KINESIS, KNITTEL GLASS, LABPROCESS, LAUDA, LENZ,LGC, LIEBHERR, LIFE TECHNOLOGIES, LIOFILCHEM, LUDWIG SCHNEIDER, MACHEREY-NAGEL, MBY, MEMMERT, MENZEL-GLASER, MERCK, METTLER, METROHM, MIELE, MILLIPORE, MILLI-Q, MLE, MOBICAT, MOTIC, MOLECULAR BIOPRODUCTS, NABERTHERM, NAHITA, NALGENE, NEW BRUNSWICK, NICHIRYO, NUNC, OHAUS, ORTO-ALRESA, OVAN, PALL, PANREAC APPLICHEM, PERKIN ELMER, PLASTIBRAND, PYREX, RAININ, RAYPA, REAGECON, ROTH, SARTORIUS, SCAT, SCHOTT, SELECTA, SIGMA ALDRICH, SIMAX, SOCOREX, SUPELCO, TELSTAR, TESTO, THERMO SCIENTIFIC, USP, VACUUBRAND, VIDRA FOC, VITLAB, WATERS, WHATMANN,WTW, XS, ZUZI
Vidrio Industrial Pobel, S.A. Luis I, 60 Almacén 12. Pol. Ind. Vallecas IV 28031 MADRID
Tel. 913 803 318 - Fax 913 803 216
E-mail: pobel@pobel.com www.pobel.com
Marcas propias: POBEL
Viscotech Hispania, S.L. Vidriers, 21 43700 EL VENDRELL Tarragona Tel. 977 668 020 - Fax 977 668 030
E-mail: viscotech@myr.com.es www.myr.com.es
Marcas propias: MYR
Vrep, S.A.
Aribau, 259 Entlo. 08021 BARCELONA Tel. 932 002 347 - Fax 932 011 366
E-mail: vrepsa@vrepsa.com www.vrepsa.com
VWR International Eurolab, S.L. Tecnología, 5-17. A7 Llinars Parc 08450 LLINARS DEL VALLÈS Barcelona Tel. 902 222 897 - Fax 902 430 657 E-mail: info.es@vwr.com www.vwr.com
Marcas propias: VWR Collection, VWR BDH PROLABO Marcas representadas: MERCK, PALL LIFE SCIENCES, DUPONT, BACOU-DALLOZ, KIMBERLY CLARK, NALGENE, WHATMAN, 3M, UVEX, GOJO, CEDERROTH, ANSELL, MAPA, CLEANAIR, KOTTERMANN, ERLAB, ASECOS, BIENS, MIELE, KARTELL, BRAND, VIVA SCIENCE, VACUUBRAND, KNF, SCHOTT, HIRSCHMAN, NALGE, BINDER, THERMO HERAEUS,IKA, JULABO, EPPENDORF, GRANT, WTW, OHAUS, LAUDA, LIEBHERR, RETSCH, HITACHI, CHROMACOL, SGE, SARTORIUS, AXYGEN, MLBP, THERMO LABSYSTEMS, STUART, AMARELL, TESTO, MOTIC, ZEISS, METTLER, SCHOTT INSTRUMENTS, CALBIOCHEM, NOVAGEN, OMEGA BIOTEK, NUNC, AIR LIQUIDE, THERMO HYBAID
VYC Industrial, S.A.
Transversal, 179 08225 TERRASSA Barcelona
Tel. 937 357 690 - Fax 937 358 135
E-mail: info@vycindustrial.com www.vycindustrial.com
Waldner Holding GmbH & Co. KG
Anton-Waldner-Str. 10-16 DE-88239 WANGEN
Tel. +49 7522 986 0 - Fax +49 7522 986 280
E-mail: Birgit.Burger@Waldner.de, stefan.holler@waldner.de www.waldner.de
Wasserlab Sistemas de Purificación de Agua Pol.Ind Comarca 2- C/ A-Nº 26 31191 BARBATÁIN Navarra Tel. 699 325 528
E-mail: cirigoyen@wasserlab.com www.wasserlab.com
Gerencia: Carlos Irigoyen Dir. Comercial: Luis Aurreco Dir. de Exportación: Eduardo de Julian Dir. de Administración: Beatriz García Dir. Técnico: Sabin Urreta Marcas propias: WASSERLAB
Waters Cromatografía, S.A.
Ronda de Can Fatjó, 7 A. Parc Tecnològic del Vallès 08290 CERDANYOLA DEL VALLÈS Barcelona Tel. 936 009 300 - Fax 936 009 360
E-mail: spain@waters.com www.waters.com
Marcas propias: WATERS, ALLIANCE, SYMMETRY, SPHERISORB, ATLANTIS, XBRIDGE, ACQUITY UPLC, SUNFIRE, OASIS, EMPOWER, NUGENESIS, ACCQ.TAG, XTERRA, XEVO, SYNAPT
Marcas representadas: TA INSTRUMENTS, VICAM
Watlow Iberica SLU
Marte, 12. Posterior Local 9 28850 TORREJÓN DE ARDOZ Madrid Tel. 916 751 292 - Fax 916 487 380
E-mail: ccarrero@watlow.com www.watlow.es
Dir. Comercial: Carlos Carrero Marcas propias: WATLOW
Whatman Hispánica, S.L. Villanueva, 29 28001 MADRID Tel. 618 616 970
E-mail: information@whatman.com www.whatman.com
Marcas propias: WHATMAN®
WTW Wissenschaftlich-Technische Werkstätten GmbH Dr. Karl-Slevogt-Straße 1 DE-82362 WEILHEIM
Tel. +49 (0) 881 183 0 - Fax +49 (0) 881 183 420
E-mail: hoheller@WTW.de, sdonnelly@wtw.com www.wtw.com
Wyatt Technology France 45 rue Adolphe Coll FR-31300 TOULOUSE
Tel. +33 (0)5 34 55 99 28 - Fax +33 (0)5 67 20 64 74
E-mail: lionel-rouzic@wyatt.com www.wyatt.com
Marcas propias: WYATT TECHNOLOGY CORPORATION
X-Rite Iberica Vilamari, 86-88 Bajos 08015 BARCELONA Tel. +34 93 567 70 73 - Fax +34 93 567 70 78
E-mail: franceorders@xrite.com www.xrite.com
Dir. Comercial: Ignasi Benito Dir. Técnico: Marc Montcada
Dir. de Marketing: Jessica Hillaert
Marcas propias: X-RITE, PANTONE, MUNSELL
Zwick Ibérica Equipos de Ensayos, S.L. Pol. Les Guixeres, s/n. Edificio BCIN. C/ Marcus Porcius, 1 08915 BADALONA Barcelona Tel. 934 648 002 - Fax 934 648 048
E-mail: comercial@zwick.es www.zwick.es
Marcas propias: ZWICK, AMSLER, INDENTEC
Marcas representadas: TONI TECHNIK
Análisis térmico (AT)
Analizadores automáticos por flujo continuo 444
Analizadores de gases por IR 444
Cromatografía a gran escala 444
Cromatografía de fluidos supercríticos 444
Cromatografía de gases (GC) 444
Cromatografía de gases con espectrometría de masas (GC-MS) 444
Cromatografía de líquidos de baja presión (LPLC) 444
Cromatografía de líquidos de alta presión (HPLC) 445
Cromatografía en placa 445
Cromatografía iónica 445
Cromatografía líquida rápida de proteínas (FPLC) 445
Densitometría
Difracción por rayos X
Espectrofluorescencia (RF)
Espectrometría de dispersión de energías (EDS) 445
Espectrometría de masas (MS)
Espectrometría infrarroja (IR) 445
Espectrometría infrarroja por transformada de Fourier (IR/FT)
Espectrometría por reflectancia en el infrarrojo cercano (NIR)
Bombas peristálticas
Cabinas de flujo laminar
Cabinas de seguridad biológica
Cámaras climáticas
Centrifugación
Cestos y gradillas
Conexiones
Criocongeladores
Cubetas
Análisis térmico (AT)
Aimplas Álava Ingenieros, S.A. Arcamo Controls, S.A.
Bonsai Advanced Technologies, S.L. Bulcase, S.A.
Chemlabor, S.L.
Distrilab, S.L Equitrol, S.L. Esindus, S.A. Expert System Solutions S.R.L. Gomensoro, S.A.
Iberlab, S.L.
Instrumentos Físicos Ibérica, S.L.
Instrumentos Testo, S.A.
Izasa Scientific J. Jimeno S.A. Laborat, S.L. Metrotec, S.A.
Mettler-Toledo, S.A.E. PerkinElmer España, S.L. Serviquimia, S.L.
Sugelabor, S.A.
Tecny Fluor (Materiales Tecny Fluor, S.L.) Tolquimex, S.L.
Waters Cromatografía, S.A.
Analizadores automáticos por flujo continuo Álava Ingenieros, S.A.
Análisis y Filtración, S.L.
Anorsa (Aparatos Normalizados, S.A.)
Arcamo Controls, S.A.
Assainissement Technique International, S.L.
AxFlow, S.A.
Bentley Instruments Chemlabor, S.L.
Comexglobal S.R.L. Dinter-Dinko
Entesis Technology, S.L. Equitrol, S.L.
Esindus, S.A.
Fisher Scientific Foss Electric España, S. Unipersonal Gomensoro, S.A. Iberlab, S.L. Instrumentos Testo, S.A. Laborat, S.L. Matelco, S.A.
Mettler-Toledo, S.A.E.
National Instruments Spain
PerkinElmer España, S.L. Serviquimia, S.L. Tecop, S.A.
Analizadores de gases por IR Álava Ingenieros, S.A.
Anisol Equipos, S.L.
Anorsa (Aparatos Normalizados, S.A.)
Aplein Ingenieros, S.A. Arcamo Controls, S.A.
Aries Ingeniería y Sistemas, S.A. Assainissement Technique International, S.L. Bonsai Advanced Technologies, S.L. Bulcase, S.A.
Casella España, S.A. Chemlabor, S.L.
Distrilab, S.L Entesis Technology, S.L. Equitrol, S.L.
Esindus, S.A. Fedelco, S.L.
Gomensoro, S.A.
Hidrolab, S.L.
Iberlab, S.L.
Instrumentación Analítica, S.A. Instrumentos Testo, S.A. Laborat, S.L.
Lana Sarrate, S.A.
Leco Instrumentos, S.L. Matelco, S.A.
Mettler-Toledo, S.A.E.
PerkinElmer España, S.L. Sensotran, S.L. Serviquimia, S.L.
Sistemas Electrónicos de Detección y Análisis, S.L. - SEDA
Tecny Fluor (Materiales Tecny Fluor, S.L.) Tecop, S.A.
Thermo Fisher Scientific SLU Tolquimex, S.L. Vidra Foc, S.A.
Cromatografía a gran escala
Agilent Technologies Spain, S.L.
Álava Ingenieros, S.A.
Análisis Vínicos, S.L.
Anorsa (Aparatos Normalizados, S.A.)
Arcamo Controls, S.A. Chemlabor, S.L.
Distribuciones Científicas Sanitarias Distrilab, S.L
Gilson International BV (sucursal España)
Iberlab, S.L.
Knauer Wissenschaftliche Geräte GmbH
Mettler-Toledo, S.A.E.
Millipore Ibérica, S.A.
Serviquimia, S.L.
Symta, S.L.L.
Tecny Fluor (Materiales Tecny Fluor, S.L.)
Varian Ibérica, S.L.
Vertex Technics, S.L.
Cromatografía de fluidos supercríticos
Agilent Technologies Spain, S.L.
Álava Ingenieros, S.A.
Anorsa (Aparatos Normalizados, S.A.)
Arcamo Controls, S.A.
Elga Labwater (Grupo Veolia Water Technologies)
Gilson International BV (sucursal España)
Iberlab, S.L.
Izasa Scientific
Mettler-Toledo, S.A.E.
Serviquimia, S.L.
Symta, S.L.L.
Tecny Fluor (Materiales Tecny Fluor, S.L.)
Vidra Foc, S.A.
Cromatografía de gases (GC)
Agilent Technologies Spain, S.L.
Aimplas
Álava Ingenieros, S.A.
Análisis Vínicos, S.L.
Anisol Equipos, S.L.
Anorsa (Aparatos Normalizados, S.A.)
Aplein Ingenieros, S.A. Arcamo Controls, S.A.
Aries Ingeniería y Sistemas, S.A.
Assainissement Technique International, S.L. Bercu Instruments, S.L. Chemlabor, S.L.
Deltalab, S.L.U.
Distribuciones Científicas Sanitarias
Distrilab, S.L
Domnick Hunter Ibérica
Esindus, S.A. Fedelco, S.L. Gaztelu Laboratorios Modulares Gomensoro, S.A.
Iberlab, S.L.
Ielab Calidad, S.L.
IUCT
Izasa Scientific
J. Jimeno S.A. Konik-Tech LGC Standards, S.L.U. Mettler-Toledo, S.A.E. Panreac Química, S.L.U.
PerkinElmer España, S.L.
Serviquimia, S.L. Sugelabor, S.A. Symta, S.L.L. Tecny Fluor (Materiales Tecny Fluor, S.L.)
Thermo Fisher Scientific SLU Tolquimex, S.L. Varian Ibérica, S.L. Vertex Technics, S.L. Vidra Foc, S.A. VWR International Eurolab, S.L. Waters Cromatografía, S.A.
Cromatografía de gases con espectrometría de masas (GC-MS) Agilent Technologies Spain, S.L. Aimplas Álava Ingenieros, S.A. Análisis Vínicos, S.L. Anorsa (Aparatos Normalizados, S.A.) Arcamo Controls, S.A. Assainissement Technique International, S.L. Bercu Instruments, S.L. Chemlabor, S.L.
Distrilab, S.L
Domnick Hunter Ibérica
Elga Labwater (Grupo Veolia Water Technologies)
Fedelco, S.L.
Gaztelu Laboratorios Modulares
Iberlab, S.L.
Ielab Calidad, S.L.
IUCT
Izasa Scientific J. Jimeno S.A.
Konik-Tech
Laborat, S.L.
Leco Instrumentos, S.L.
LGC Standards, S.L.U. Mettler-Toledo, S.A.E. Nippon Gases
PerkinElmer España, S.L.
Serviquimia, S.L.
Symta, S.L.L.
Tecny Fluor (Materiales Tecny Fluor, S.L.) Tecop, S.A. Thermo Fisher Scientific SLU Tolquimex, S.L. Varian Ibérica, S.L. Waters Cromatografía, S.A.
Cromatografía de líquidos a baja presión (LPLC)
Acefe, S.A. Álava Ingenieros, S.A. Análisis Vínicos, S.L. Anorsa (Aparatos Normalizados, S.A.)
Arcamo Controls, S.A. Assainissement Technique International, S.L. Bercu Instruments, S.L. Distribuciones Científicas Sanitarias Distrilab, S.L Fisher Scientific Gilson International BV (sucursal España) Iberlab, S.L. IUCT
Izasa Scientific J. Jimeno S.A. Knauer Wissenschaftliche Geräte GmbH Laborat, S.L.
LGC Standards, S.L.U. Mettler-Toledo, S.A.E. Millipore Ibérica, S.A. Net Interlab, S.A.L. Serviquimia, S.L. Sugelabor, S.A. Symta, S.L.L. Tecny Fluor (Materiales Tecny Fluor, S.L.)
VWR International Eurolab, S.L.
Cromatografía de líquidos de alta presión (HPLC)
Acefe, S.A.
Agilent Technologies Spain, S.L. Aimplas
Álava Ingenieros, S.A.
Albet-Hahnemuehle, S.L.U
Análisis Vínicos, S.L.
Anorsa (Aparatos Normalizados, S.A.)
Arcamo Controls, S.A.
Assainissement Technique International, S.L. Bercu Instruments, S.L. Chemlabor, S.L.
CHMLAB Group
Distribuciones Científicas Sanitarias Distrilab, S.L
Domnick Hunter Ibérica
Elga Labwater (Grupo Veolia Water Technologies) Fedelco, S.L.
Fisher Scientific Gaztelu Laboratorios Modulares
Gilson International BV (sucursal España) Gomensoro, S.A.
Iberlab, S.L.
Ielab Calidad, S.L.
IUCT
Izasa Scientific J. Jimeno S.A.
Knauer Wissenschaftliche Geräte GmbH
Konik-Tech
LGC Standards, S.L.U.
Mettler-Toledo, S.A.E.
Panreac Química, S.L.U.
PerkinElmer España, S.L. R-Biopharm España, S.A.U
Serviquimia, S.L.
Shodex, Showa Denko Europe GmbH
Sugelabor, S.A.
Symta, S.L.L.
Tecny Fluor (Materiales Tecny Fluor, S.L.)
Thermo Fisher Scientific SLU Tolquimex, S.L.
Varian Ibérica, S.L.
Vertex Technics, S.L.
Vidra Foc, S.A.
VWR International Eurolab, S.L. Waters Cromatografía, S.A.
Cromatografía en placa Acefe, S.A.
Análisis Vínicos, S.L.
Anorsa (Aparatos Normalizados, S.A.) Camag (Switzerland)
CHMLAB Group
Deltalab, S.L.U. Distrilab, S.L
Fisher Scientific Iberlab, S.L. IUCT
Izasa Scientific
J. Jimeno S.A. Laborat, S.L. Luis Frechilla, S.L. Mettler-Toledo, S.A.E.
Panreac Química, S.L.U. Quimivita, S.A. División Laboratorio Serviquimia, S.L.
Symta, S.L.L.
Tecny Fluor (Materiales Tecny Fluor, S.L.)
Tolquimex, S.L.
Trallero & Schlee, S.L. Vidra Foc, S.A.
VWR International Eurolab, S.L.
Cromatografía iónica
Acefe, S.A.
Anorsa (Aparatos Normalizados, S.A.)
Assainissement Technique International, S.L. Bercu Instruments, S.L.
Chemlabor, S.L.
Distrilab, S.L
Elga Labwater (Grupo Veolia Water Technologies)
Fedelco, S.L.
Fisher Scientific Gilson International BV (sucursal España) Gomensoro, S.A.
Iberlab, S.L.
Ielab Calidad, S.L.
Izasa Scientific
Knauer Wissenschaftliche Geräte GmbH
LGC Standards, S.L.U.
Mettler-Toledo, S.A.E.
Net Interlab, S.A.L.
Panreac Química, S.L.U.
Serviquimia, S.L.
Shodex, Showa Denko Europe GmbH
Sugelabor, S.A.
Symta, S.L.L.
Tecny Fluor (Materiales Tecny Fluor, S.L.)
Tolquimex, S.L.
Vertex Technics, S.L.
Vidra Foc, S.A.
Waters Cromatografía, S.A.
Cromatografía líquida rápida de proteínas (FPLC)
Acefe, S.A.
Análisis Vínicos, S.L.
Anorsa (Aparatos Normalizados, S.A.)
Chemlabor, S.L.
Distribuciones Científicas Sanitarias
Fisher Scientific
Gilson International BV (sucursal España)
Iberlab, S.L.
Knauer Wissenschaftliche Geräte GmbH
Mettler-Toledo, S.A.E.
Serviquimia, S.L.
Shodex, Showa Denko Europe GmbH
Sugelabor, S.A.
Symta, S.L.L.
Tecny Fluor (Materiales Tecny Fluor, S.L.)
Densitometría
Acefe, S.A.
Anisol Equipos, S.L.
Anorsa (Aparatos Normalizados, S.A.)
Aplein Ingenieros, S.A. Arcamo Controls, S.A. Bercu Instruments, S.L. Chemlabor, S.L.
Dinter-Dinko
Distrilab, S.L
Esindus, S.A.
Fisher Scientific Gomensoro, S.A.
Iberlab, S.L.
Izasa Scientific J. Jimeno S.A. Laborat, S.L.
LGC Standards, S.L.U. Maselli Ibérica
Metrotec, S.A.
Mettler-Toledo, S.A.E. Net Interlab, S.A.L. Quimivita, S.A. División Laboratorio Serviquimia, S.L. Tecnología para Diagnóstico e Investigación (TDI, S.A.)
Tolquimex, S.L.
Difracción por rayos X Acefe, S.A.
Carl Zeiss Iberia, S.L.
Crysforma (Institut Català d’Investigació Química)
Distrilab, S.L
Fedelco, S.L.
Iberlab, S.L. Iberlaser, S.A.
Izasa Scientific Mettler-Toledo, S.A.E.
PANalytical B.V. Sucursal en España Serviquimia, S.L. Tecnología para Diagnóstico e Investigación (TDI, S.A.)
Vidra Foc, S.A.
Espectrofluorescencia (RF)
Álava Ingenieros, S.A. Análisis Vínicos, S.L. Anorsa (Aparatos Normalizados, S.A.) Aplein Ingenieros, S.A. Chemlabor, S.L. Comercial Rafer, S.L. Deltalab, S.L.U. Distribuciones Científicas Sanitarias Distrilab, S.L Esindus, S.A. Fisher Scientific Gomensoro, S.A. Grupo Taper Iberlab, S.L. Iberlaser, S.A. Instrumatic Española, S.A. Laborat, S.L. Lasing, S.A. Mettler-Toledo, S.A.E. PerkinElmer España, S.L. Serviquimia, S.L. Sugelabor, S.A. Thermo Fisher Scientific SLU Vidra Foc, S.A.
Espectrometría de dispersión de energías (EDS) Aimplas
Carl Zeiss Iberia, S.L. Iberlab, S.L.
Izasa Scientific Laborat, S.L. Mettler-Toledo, S.A.E.
Espectrometría de masas (MS) Agilent Technologies Spain, S.L. Álava Ingenieros, S.A.
Análisis Vínicos, S.L.
Anorsa (Aparatos Normalizados, S.A.) Assainissement Technique International, S.L. Bercu Instruments, S.L. Chemlabor, S.L. Distrilab, S.L
Elga Labwater (Grupo Veolia Water Technologies) Iberlab, S.L. Ielab Calidad, S.L.
IUCT
Izasa Scientific Knauer Wissenschaftliche Geräte GmbH Konik-Tech
Leco Instrumentos, S.L. Mettler-Toledo, S.A.E. Panreac Química, S.L.U. Serviquimia, S.L. Symta, S.L.L. Tecnología para Diagnóstico e Investigación (TDI, S.A.)
Tecny Fluor (Materiales Tecny Fluor, S.L.)
Thermo Fisher Scientific SLU
Varian Ibérica, S.L. Waters Cromatografía, S.A.
Espectrometría infrarrojo (IR)
Álava Ingenieros, S.A. Aimplas
Análisis Vínicos, S.L.
Anisol Equipos, S.L. Anorsa (Aparatos Normalizados, S.A.)
Aplein Ingenieros, S.A.
Aries Ingeniería y Sistemas, S.A.
Assainissement Technique International, S.L. Bentley Instruments
Bercu Instruments, S.L. Chemlabor, S.L.
Comercial Rafer, S.L.
Distrilab, S.L
Esindus, S.A.
Fedelco, S.L.
Foss Electric España, S. Unipersonal Gomensoro, S.A.
Iberlab, S.L.
Iberlaser, S.A.
Ielab Calidad, S.L.
Instrumatic Española, S.A. Instrumentos Testo, S.A.
IUCT
Izasa Scientific Konik-Tech
Lasing, S.A. Metrotec, S.A.+
Mettler-Toledo, S.A.E.
Omadisa Industrias del Laboratorio, S.A. Panreac Química, S.L.U.
PerkinElmer España, S.L. Serviquimia, S.L.
Symta, S.L.L.
Tecop, S.A.
Thermo Fisher Scientific SLU
Tolquimex, S.L.
Varian Ibérica, S.L.
Vidra Foc, S.A.
Espectrometría infrarrojo por transformada de Fourier (IR/FT)
Aimplas
Análisis Vínicos, S.L.
Aplein Ingenieros, S.A.
Bentley Instruments
Bercu Instruments, S.L.
Chemlabor, S.L.
Crysforma (Institut Català d’Investigació Química)
Distrilab, S.L
Esindus, S.A. Fedelco, S.L.
Foss Electric España, S. Unipersonal Gomensoro, S.A.
Iberlab, S.L.
Iberlaser, S.A.
IUCT
Izasa Scientific Mettler-Toledo, S.A.E. PerkinElmer España, S.L. Serviquimia, S.L. Symta, S.L.L. Tecnoquim, S.L.
Thermo Fisher Scientific SLU Tolquimex, S.L.
Varian Ibérica, S.L.
Vidra Foc, S.A.
Espectrometría por reflectancia en el infrarrojo cercano (NIR)
Aimplas
Álava Ingenieros, S.A.
Anisol Equipos, S.L. Aplein Ingenieros, S.A.
Aries Ingeniería y Sistemas, S.A. AxFlow, S.A. Bercu Instruments, S.L. Bonsai Advanced Technologies, S.L. Chemlabor, S.L. Distrilab, S.L
Esindus, S.A. Fedelco, S.L.
Foss Electric España, S. Unipersonal Gomensoro, S.A.
Iberlab, S.L.
Iberlaser, S.A.
Izasa Scientific
Lasing, S.A.
Leco Instrumentos, S.L.
Mettler-Toledo, S.A.E.
PerkinElmer España, S.L.
Serviquimia, S.L.
Symta, S.L.L.
Tecnoquim, S.L.
Thermo Fisher Scientific SLU Varian Ibérica, S.L.
Espectrometría UV-Vis
Acefe, S.A.
Agilent Technologies Spain, S.L.
Aimplas
Álava Ingenieros, S.A.
Análisis Vínicos, S.L.
Anisol Equipos, S.L.
Aplein Ingenieros, S.A.
Asociación de Investigación y Centro Tecnológico de Miranda de Ebro Assainissement Technique International, S.L.
Auxilab, S.L.
AxFlow, S.A.
Bercu Instruments, S.L. Chemlabor, S.L.
Comecta, S.A. - Grupo Selecta Comercial Labor, S.A. Deltalab, S.L.U.
Dinter-Dinko
Distrilab, S.L
Eppendorf Ibérica, S.L.U.
Esindus, S.A.
Fedelco, S.L.
Fisher Scientific Gomensoro, S.A.
Grupo Taper
Hach Lange Spain, S.L.U.
Iberlab, S.L.
Iberlaser, S.A.
Ielab Calidad, S.L.
Instrumatic Española, S.A.
IUCT
Izasa Scientific J. Jimeno S.A.
J. P. Selecta, S.A.
Knauer Wissenschaftliche Geräte GmbH
Konik-Tech
Labolan, S.L.
Lasing, S.A.
Levantina de Laboratorios, S.L.
LGC Standards, S.L.U.
Luis Frechilla, S.L.
Mettler-Toledo, S.A.E.
MIL, S.L.
Omadisa Industrias del Laboratorio, S.A.
Panreac Química, S.L.U.
PerkinElmer España, S.L. Quimivita, S.A. División Laboratorio
Rubilabor, S.L.
Serviquimia, S.L. Sugelabor, S.A. Symta, S.L.L.
Tecan Ibérica Instrumentación, S.L. Tecnología para Diagnóstico e Investigación (TDI, S.A.)
Tecnoquim, S.L.
Thermo Fisher Scientific SLU Tolquimex, S.L. Varian Ibérica, S.L. Vidra Foc, S.A.
VWR International Eurolab, S.L.
Resonancia magnética nuclear (RMN)
Análisis y Filtración, S.L.
Aries Ingeniería y Sistemas, S.A. Fedelco, S.L. Iberlab, S.L.
IUCT
Izasa Scientific Panreac Química, S.L.U. Serviquimia, S.L. Tecop, S.A. Varian Ibérica, S.L.
Otros
Agem, Auxiliar General de Electromedicina, S.A. Agilent Technologies Spain, S.L.
Aimplas
Anisol Equipos, S.L. Aqua-Consult Ingenieros, S.L. Arcamo Controls, S.A. AxFlow, S.A. Camag (Switzerland)
Casella España, S.A. Crysforma (Institut Català d’Investigació Química) Deltalab, S.L.U. Dinter-Dinko Distrilab, S.L Entorn, S.A. - Enginyeria i Serveis Esindus, S.A. Fisher Scientific Formimetal, S.L. Gomensoro, S.A. Grupo Taper Hidracar, S.A. Ielab Calidad, S.L. Izasa Scientific LGC Standards, S.L.U. Matelco, S.A. Metrotec, S.A. Net Interlab, S.A.L. Omadisa Industrias del Laboratorio, S.A. R-Biopharm España, S.A.U Rectus Tema, S.L. Serviquimia, S.L. Sistemas Electrónicos de Detección y Análisis, S.L. - SEDA
Tecop, S.A.
Vertex Technics, S.L. Vidra Foc, S.A.
Espectrometría de absorción atómica (AA) Análisis Vínicos, S.L. Anorsa (Aparatos Normalizados, S.A.) Aplein Ingenieros, S.A.
Asociación de Investigación y Centro Tecnológico de Miranda de Ebro Assainissement Technique International, S.L. Bercu Instruments, S.L. Chemlabor, S.L. Distrilab, S.L
Elga Labwater (Grupo Veolia Water Technologies) Fedelco, S.L. Iberlab, S.L. Iberlaser, S.A. Ielab Calidad, S.L. IUCT
Izasa Scientific J. Jimeno S.A. Konik-Tech
Leco Instrumentos, S.L. LGC Standards, S.L.U. Millipore Ibérica, S.A. Panreac Química, S.L.U. PerkinElmer España, S.L. Rubilabor, S.L. Serviquimia, S.L. Sugelabor, S.A. Symta, S.L.L. Tecnoquim, S.L. Thermo Fisher Scientific SLU Tolquimex, S.L. Varian Ibérica, S.L. Vertex Technics, S.L. Vidra Foc, S.A.
Espectrometría de arco
Anorsa (Aparatos Normalizados, S.A.) Bonsai Advanced Technologies, S.L. Iberlab, S.L. Iberlaser, S.A.
Rubilabor, S.L.
Serviquimia, S.L.
Spectro Hispania, S.L.
Espectrometría de emisión
Anorsa (Aparatos Normalizados, S.A.)
Asociación de Investigación y Centro Tecnológico de Miranda de Ebro
Bonsai Advanced Technologies, S.L. Chemlabor, S.L.
Distrilab, S.L Fedelco, S.L.
Fisher Scientific Gomensoro, S.A.
Iberlab, S.L.
Iberlaser, S.A.
Ielab Calidad, S.L.
IUCT
Izasa Scientific J. Jimeno S.A.
Leco Instrumentos, S.L.
National Instruments Spain
PerkinElmer España, S.L. Rubilabor, S.L.
Serviquimia, S.L.
Spectro Hispania, S.L.
Thermo Fisher Scientific SLU
Varian Ibérica, S.L.
Espectrometría de plasma
Agilent Technologies Spain, S.L. Anorsa (Aparatos Normalizados, S.A.)
Bercu Instruments, S.L.
Chemlabor, S.L.
Distrilab, S.L Fedelco, S.L.
Gomensoro, S.A.
Iberlab, S.L.
Iberlaser, S.A.
Ielab Calidad, S.L.
J. Jimeno S.A.
LGC Standards, S.L.U.
Panreac Química, S.L.U.
PerkinElmer España, S.L. Rubilabor, S.L.
Serviquimia, S.L. Symta, S.L.L.
Thermo Fisher Scientific SLU Varian Ibérica, S.L.
Espectrometría de rayos X Anorsa (Aparatos Normalizados, S.A.)
Bonsai Advanced Technologies, S.L. Distrilab, S.L
Gomensoro, S.A. Iberlab, S.L. Iberlaser, S.A.
Instrumatic Española, S.A. Izasa Scientific J. Jimeno S.A. Laborat, S.L.
PANalytical B.V. Sucursal en España Rubilabor, S.L. Serviquimia, S.L.
Spectro Hispania, S.L. Tecop, S.A.
Espectroscopia de masas de iones secindarios (SIMS)
Anorsa (Aparatos Normalizados, S.A.) Biometa, S.A. Gomensoro, S.A.
Iberlab, S.L.
IUCT
Laborat, S.L. Rubilabor, S.L. Serviquimia, S.L.
Espectroscopia electrónica para análisis químicos (ESCA)
Álava Ingenieros, S.A.
Anorsa (Aparatos Normalizados, S.A.)
Comercial Rafer, S.L. Distrilab, S.L
Elga Labwater (Grupo Veolia Water Technologies) Iberlab, S.L. Laborat, S.L. Rubilabor, S.L. Serviquimia, S.L.
Espectroscopia microscópica de masas (LAMMA)
Álava Ingenieros, S.A.
Anorsa (Aparatos Normalizados, S.A.) Iberlab, S.L. Rubilabor, S.L. Serviquimia, S.L.
Microscopia electrónica de barrido
Álava Ingenieros, S.A.
Aimplas
Anorsa (Aparatos Normalizados, S.A.)
Carl Zeiss Iberia, S.L. Comercial Rafer, S.L. Fedelco, S.L.
Iberlab, S.L.
Izasa Scientific Rubilabor, S.L. Serviquimia, S.L.
Microscopia electrónica de transmisión Álava Ingenieros, S.A.
Anorsa (Aparatos Normalizados, S.A.)
Carl Zeiss Iberia, S.L. Comercial Rafer, S.L. Fedelco, S.L. Iberlab, S.L.
Izasa Scientific Rubilabor, S.L. Serviquimia, S.L. Vidra Foc, S.A.
Otros
Agem, Auxiliar General de Electromedicina, S.A. Aqua-Consult Ingenieros, S.L. Biometa, S.A.
Carl Zeiss Iberia, S.L. Deltalab, S.L.U. Entorn, S.A. - Enginyeria i Serveis Fisher Scientific Formimetal, S.L. Gomensoro, S.A. Grupo Taper Hidracar, S.A. Ielab Calidad, S.L. Izasa Scientific LGC Standards, S.L.U. Metrotec, S.A. National Instruments Spain Olympus Iberia, S.A.U. PerkinElmer España, S.L. Quimivita, S.A. División Laboratorio Rectus Tema, S.L. Rubilabor, S.L. Serviquimia, S.L. Tecop, S.A. Vidra Foc, S.A.
Agitadores
Acefe, S.A.
AES Laboratorio, S.A.
Agem, Auxiliar General de Electromedicina, S.A.
Análisis Vínicos, S.L.
Anorsa (Aparatos Normalizados, S.A.)
Assainissement Technique International, S.L. Auxilab, S.L. Bentley Instruments Bercu Instruments, S.L. Bombas Grundfos España, S.A. Chemlabor, S.L. Cobos Precisión, S.L. Comecta, S.A. - Grupo Selecta Comercial Labor, S.A. Comercial Rafer, S.L. Comercial Tecno, S.L. Comexglobal S.R.L. Deltalab, S.L.U. Dinter-Dinko Distribuciones Científicas Sanitarias Distrilab, S.L E. Bachiller B., S.A. Ecogen, S.L. Eppendorf Ibérica, S.L.U. Fedelco, S.L. Fisher Scientific Frances Micron España, S.A. Fritsch GmbH - Molienda y Medición Gilson International BV (sucursal España) Gomensoro, S.A. Grupo Taper Hach Lange Spain, S.L.U. Iberfluid Instruments, S.A. Iberlab, S.L. IKA-Werke GmbH & Co.Kg Instrumentos Físicos Ibérica, S.L. IUCT
Izasa Scientific J. Jimeno S.A. J. P. Selecta, S.A. Labbox Labware, S.L. Labolan, S.L. Laborat, S.L. Levantina de Laboratorios, S.L. Lidering, S.A.U. Linealab,S.L. Luis Frechilla, S.L. Lumaquin, S.A. Mab Industrial, S.L.U. Manema, S.A. Mathias, S.L. Metrotec, S.A. Net Interlab, S.A.L. Nirco, S.L. Normalab, S.L. Omadisa Industrias del Laboratorio, S.A. Ortoalresa Ovan Equipos Laboratorio (Suministros Grupo Esper S.L) Quilinox, S.L. Quimivita, S.A. División Laboratorio R. Espinar S.L. Rubilabor, S.L. Sarstedt, S.A.U Sartorius Stedim Spain, S.A.U. Science Basic Solutions, S.L. - SBS, S.L. Servibombas, S.L. Serviquimia, S.L. Sugelabor, S.A. Tecno Química Veyca, S.L. Tecnoquim, S.L.
Thermo Fisher Scientific SLU Tiselab - Soluciones GMP para industrial Biofarmacéutica y afines Tolquimex, S.L. Trallero & Schlee, S.L. Vertex Technics, S.L.
Vidra Foc, S.A.
VWR International Eurolab, S.L. Aminoácidos
Agilent Technologies Spain, S.L. Anorsa (Aparatos Normalizados, S.A.)
Distribuciones Científicas Sanitarias
Distrilab, S.L
Gomensoro, S.A.
Iberlab, S.L.
J. Jimeno S.A. Laborat, S.L.
Normalab, S.L.
Panreac Química, S.L.U. Quimivita, S.A. División Laboratorio Rubilabor, S.L. Sugelabor, S.A. Tecno Química Veyca, S.L. Vidra Foc, S.A.
VWR International Eurolab, S.L.
Arcones climáticos AES Laboratorio, S.A. Agem, Auxiliar General de Electromedicina, S.A. Álava Ingenieros, S.A. Anorsa (Aparatos Normalizados, S.A.)
Arcox
Bercu Instruments, S.L. CCI Control de Calidad Chemlabor, S.L.
Comecta, S.A. - Grupo Selecta Comercial Rafer, S.L. Comercial Tecno, S.L.
Distribuciones Científicas Sanitarias Distrilab, S.L
Ecogen, S.L.
Fisher Scientific Grupo Taper Iberlab, S.L.
Ingeniería de Climas para Procesos, S.L.
IUCT
Izasa Scientific J. Jimeno S.A.
J. P. Selecta, S.A.
Kern Frío, S.L. Laborat, S.L.
Landes Poli Ibérica, S.L. Levantina de Laboratorios, S.L.
Luis Frechilla, S.L. Lumaquin, S.A.
Metrotec, S.A. Nirco, S.L. Normalab, S.L.
Omadisa Industrias del Laboratorio, S.A. Quimivita, S.A. División Laboratorio Rubilabor, S.L.
Sartorius Stedim Spain, S.A.U. Serviquimia, S.L. Tecnología para Diagnóstico e Investigación (TDI, S.A.) Tecnoquim, S.L.
Thermo Fisher Scientific SLU Titan Eko, S.L. Sucursal en España Tolquimex, S.L. Trallero & Schlee, S.L. Vertex Technics, S.L. Vidra Foc, S.A.
VWR International Eurolab, S.L.
Armarios de seguridad
Agem, Auxiliar General de Electromedicina, S.A.
Anorsa (Aparatos Normalizados, S.A.)
Arcamo Controls, S.A.
Asecos Seguridad y Protección del Medio Ambiente, S.L. Bentley Instruments Bioser, S.A.
Burdinola, S. Coop.
CCI Control de Calidad Chemlabor, S.L.
Comecta, S.A. - Grupo Selecta Comercial Rafer, S.L. Comercial Tecno, S.L. Dimanlab, S.L.
Distribuciones Científicas Sanitarias
Distrilab, S.L
Erlab, S.L. Formimetal, S.L.
Grupo Taper Iberlab, S.L. Ingeniería de Climas para Procesos, S.L. Izasa Scientific J. Jimeno S.A.
Köttermann Systemlabor, S.A. Labolan, S.L. Laborat, S.L. Levantina de Laboratorios, S.L. Luis Frechilla, S.L. Lumaquin, S.A.
Miele - Centre Calvet Modulabo, S.L. Nirco, S.L. Normalab, S.L.
Omadisa Industrias del Laboratorio, S.A. Quimivita, S.A. División Laboratorio
Romero Muebles de Laboratorio, S.A. Rubilabor, S.L.
Serviquimia, S.L.
Sistemas Electrónicos de Detección y Análisis, S.L. - SEDA
Sugelabor, S.A.
Tecnología para Diagnóstico e Investigación (TDI, S.A.)
Tecnoquim, S.L.
Tecny Fluor (Materiales Tecny Fluor, S.L.)
Tolquimex, S.L.
Trallero & Schlee, S.L.
Vidra Foc, S.A.
VWR International Eurolab, S.L.
Autoclaves
Acefe, S.A.
AES Laboratorio, S.A.
Agem, Auxiliar General de Electromedicina, S.A. Anorsa (Aparatos Normalizados, S.A.)
Antonio Matachana, S.A.
Antonio Matachana, S.A. Div. Laboratorios
Assainissement Technique International, S.L. Bercu Instruments, S.L. Biometa, S.A.
Bioser, S.A.
CCI Control de Calidad Chemlabor, S.L.
Comercial Rafer, S.L. Comercial Tecno, S.L. Comexglobal S.R.L. Distribuciones Científicas Sanitarias Distrilab, S.L
E. Bachiller B., S.A. Ecogen, S.L. Fedelco, S.L. Fisher Scientific Gomensoro, S.A. Grupo Taper Iberfluid Instruments, S.A. Iberlab, S.L.
IUCT
Izasa Scientific
J. Jimeno S.A.
J. P. Selecta, S.A. Labolan, S.L. Laborat, S.L. Levantina de Laboratorios, S.L. Lidering, S.A.U.
Luis Frechilla, S.L.
Lumaquin, S.A.
Mathias, S.L. Metrotec, S.A. Nippon Gases Nirco, S.L. Normalab, S.L.
Omadisa Industrias del Laboratorio, S.A. Quimivita, S.A. División Laboratorio R. Espinar S.L. Rectus Tema, S.L. Rubilabor, S.L. Sartorius Stedim Spain, S.A.U. Serviquimia, S.L. Steris Iberia, S.A. Tecnoquim, S.L. Tolquimex, S.L. Trallero & Schlee, S.L. Vidra Foc, S.A. VWR International Eurolab, S.L.
Balanzas analíticas y electrónicas Acefe, S.A. AES Laboratorio, S.A. Agem, Auxiliar General de Electromedicina, S.A. Análisis Vínicos, S.L. Anorsa (Aparatos Normalizados, S.A.)
Assainissement Technique International, S.L. Auxilab, S.L. Bacsa
Bercu Instruments, S.L. Bioser, S.A. Chemlabor, S.L.
Cobos Precisión, S.L. Comecta, S.A. - Grupo Selecta
Comercial Labor, S.A. Comercial Rafer, S.L. Comercial Tecno, S.L. Distribuciones Científicas Sanitarias Distrilab, S.L Ecogen, S.L. Electrónica de Medida y Control, S.A. Fedelco, S.L.
Fisher Scientific Gomensoro, S.A. Gram Precisión, S.L. Grupo Taper Guemisa
Herter Instruments, S.L. Iberlab, S.L. Instrumentación Analítica, S.A. IUCT
Izasa Scientific J. Jimeno S.A. Kern & Sohn GmbH Labbox Labware, S.L. Labolan, S.L. Laborat, S.L. Landes Poli Ibérica, S.L. Levantina de Laboratorios, S.L. Linealab,S.L. Luis Frechilla, S.L. Lumaquin, S.A. Mathias, S.L. Metrotec, S.A. Net Interlab, S.A.L. Nirco, S.L. Normalab, S.L. Omadisa Industrias del Laboratorio, S.A. Pesos M.B.M., S.L. Quimivita, S.A. División Laboratorio Rubilabor, S.L. Serviquimia, S.L. Sugelabor, S.A. Tecnoquim, S.L. Tolquimex, S.L. Trallero & Schlee, S.L. Vidra Foc, S.A.
VWR International Eurolab, S.L.
Baños termostáticos
Acefe, S.A. AES Laboratorio, S.A. Agem, Auxiliar General de Electromedicina, S.A.
Álava Ingenieros, S.A.
Analab, S.A.
Análisis Vínicos, S.L.
Anorsa (Aparatos Normalizados, S.A.) Assainissement Technique International, S.L. Auxilab, S.L.
Bercu Instruments, S.L. Biometa, S.A.
Bioser, S.A.
CCI Control de Calidad Chemlabor, S.L.
Comercial Labor, S.A.
Comercial Rafer, S.L.
Comercial Tecno, S.L.
Dinter-Dinko
Distribuciones Científicas Sanitarias Distrilab, S.L
Dycometal, Equipos de C.C., S.L. Ecogen, S.L. Fedelco, S.L.
Filtra Vibración, S.L.
Fisher Scientific Gomensoro, S.A.
Grupo Taper Huber
Iberlab, S.L.
IKA-Werke GmbH & Co.Kg
Ineltec, S.L.
Instrumentación Analítica, S.A. Instrumentos Físicos Ibérica, S.L.
IUCT
Izasa Scientific J. Jimeno S.A.
J. P. Selecta, S.A.
Julabo GmbH
Labbox Labware, S.L.
Labolan, S.L.
Laborat, S.L.
Landes Poli Ibérica, S.L.
LAUDA DR. R. WOBSER GMBH & CO. KG
Levantina de Laboratorios, S.L. Linealab,S.L.
Luis Frechilla, S.L.
Lumaquin, S.A.
Mathias, S.L. Metrotec, S.A.
Net Interlab, S.A.L. Nirco, S.L. Normalab, S.L.
Omadisa Industrias del Laboratorio, S.A.
Ovan Equipos Laboratorio (Suministros Grupo Esper S.L) Quimivita, S.A. División Laboratorio
R. Espinar S.L. Rubilabor, S.L.
Science Basic Solutions, S.L. - SBS, S.L. Serviquimia, S.L. Sugelabor, S.A. Surcis, S.L. Tecnoquim, S.L.
Thermo Fisher Scientific SLU Tolquimex, S.L.
Trallero & Schlee, S.L.
Vertex Technics, S.L.
Vidra Foc, S.A.
VWR International Eurolab, S.L.
Baños ultrasónicos
Acefe, S.A.
Analab, S.A.
Assainissement Technique International, S.L.
Cobos Precisión, S.L.
Distrilab, S.L
Haver & Boecker Telas Metálicas Labbox Labware, S.L.
Laborat, S.L.
Levantina de Laboratorios, S.L.
Luis Frechilla, S.L.
Lumaquin, S.A.
Ovan Equipos Laboratorio
(Suministros Grupo Esper S.L)
Quimivita, S.A. División Laboratorio Retsch GmbH
Serviquimia, S.L.
Tecnoquim, S.L.
Trallero & Schlee, S.L.
Vidra Foc, S.A.
Bombas de dosificación
Arcamo Controls, S.A.
Assainissement Technique International, S.L.
Bercu Instruments, S.L.
Comexglobal S.R.L.
Dinter-Dinko
Distrilab, S.L
Hirschmann Laborgeräte GmbH & Co. KG
Knauer Wissenschaftliche Geräte GmbH
Laborat, S.L.
Lidering, S.A.U.
Levantina de Laboratorios, S.L.
Luis Frechilla, S.L.
Quilinox, S.L.
Quimivita, S.A. División Laboratorio
Serviquimia, S.L.
Spetec GmbH
Tecnium - Casals Cardona Industrial, S.A.
Trallero & Schlee, S.L.
Bombas de vacío
Acefe, S.A.
Agem, Auxiliar General de Electromedicina, S.A.
Albet-Hahnemuehle, S.L.U
Análisis Vínicos, S.L.
Anorsa (Aparatos Normalizados, S.A.)
Arcamo Controls, S.A.
Assainissement Technique International, S.L.
Auquime, S.A.
Auxilab, S.L.
Bercu Instruments, S.L. Blowair, S.L.
Bonsai Advanced Technologies, S.L.
CCI Control de Calidad Chemlabor, S.L.
CHMLAB Group
Comecta, S.A. - Grupo Selecta Comercial Labor, S.A. Comercial Rafer, S.L. Comercial Tecno, S.L.
Comexglobal S.R.L. Dinter-Dinko
Distribuciones Científicas Sanitarias Distrilab, S.L Ecogen, S.L. Equirepsa Fedelco, S.L. Fisher Scientific Gomensoro, S.A. Grupo Taper Iberlab, S.L. Instrumentos Físicos Ibérica, S.L. IUCT
Izasa Scientific
J. Jimeno S.A.
J. P. Selecta, S.A. KGW-Isotherm Konik-Tech
Labbox Labware, S.L. Laborat, S.L. Levantina de Laboratorios, S.L. Lidering, S.A.U. Linealab,S.L. Luis Frechilla, S.L. Lumaquin, S.A. Manema, S.A. Millipore Ibérica, S.A.
Net Interlab, S.A.L. Nirco, S.L. Normalab, S.L. Omadisa Industrias del Laboratorio, S.A. Panreac Química, S.L.U. Quilinox, S.L. Quimivita, S.A. División Laboratorio Rectus Tema, S.L. Rubilabor, S.L. Science Basic Solutions, S.L. - SBS, S.L. Servibombas, S.L. Serviquimia, S.L. Tecno Química Veyca, S.L. Tecnología para Diagnóstico e Investigación (TDI, S.A.) Tecnoquim, S.L. Tecop, S.A. Telstar Technologies, S.L. Tolquimex, S.L. Trallero & Schlee, S.L. Varian Ibérica, S.L. Vidra Foc, S.A. VWR International Eurolab, S.L.
Bombas peristálticas
AES Laboratorio, S.A.
Agem, Auxiliar General de Electromedicina, S.A. Analab, S.A. Análisis Vínicos, S.L.
Anorsa (Aparatos Normalizados, S.A.)
Assainissement Technique International, S.L. Bercu Instruments, S.L. CCI Control de Calidad Chemlabor, S.L. Comecta, S.A. - Grupo Selecta Comercial Rafer, S.L. Comercial Tecno, S.L. Dinter-Dinko
Distribuciones Científicas Sanitarias Distrilab, S.L Fisher Scientific Gilson International BV (sucursal España) Grupo Taper Hirschmann Laborgeräte GmbH & Co. KG Iberlab, S.L. Instrumentos Físicos Ibérica, S.L. IUCT
J. Jimeno S.A. J. P. Selecta, S.A. Laborat, S.L. Levantina de Laboratorios, S.L. Lidering, S.A.U. Linealab,S.L. Luis Frechilla, S.L. Lumaquin, S.A. Manema, S.A. Millipore Ibérica, S.A. Nirco, S.L. Normalab, S.L. Omadisa Industrias del Laboratorio, S.A. Quilinox, S.L. Quimivita, S.A. División Laboratorio Rubilabor, S.L. Science Basic Solutions, S.L. - SBS, S.L. Servibombas, S.L. Serviquimia, S.L. Spetec GmbH Surcis, S.L. Tecnoquim, S.L. Tecny Fluor (Materiales Tecny Fluor, S.L.) Telstar Technologies, S.L. Tolquimex, S.L. Trallero & Schlee, S.L. Vidra Foc, S.A. Vrep, S.A. VWR International Eurolab, S.L.
Cabinas de flujo laminar
AES Laboratorio, S.A.
Agem, Auxiliar General de Electromedicina, S.A.
Análisis Vínicos, S.L.
Anorsa (Aparatos Normalizados, S.A.)
Bercu Instruments, S.L.
Bioser, S.A.
Burdinola, S. Coop.
CCI Control de Calidad Chemlabor, S.L.
Comecta, S.A. - Grupo Selecta Comercial Rafer, S.L. Comercial Tecno, S.L.
Comexglobal S.R.L.
Cruma Material de Laboratorio, S.A. Distribuciones Científicas Sanitarias Distrilab, S.L Ecogen, S.L. Erlab, S.L.
Fisher Scientific Formimetal, S.L.
Frances Micron España, S.A.
Grupo Taper
Iberlab, S.L.
IUCT
Izasa Scientific J. Jimeno S.A.
Labolan, S.L.
Laborat, S.L.
Labortech Waldner, S.L. Levantina de Laboratorios, S.L. Luis Frechilla, S.L.
Luwa Española, S.A.
Mathias, S.L.
Miele - Centre Calvet
Net Interlab, S.A.L.
Nirco, S.L.
Normalab, S.L.
Omadisa Industrias del Laboratorio, S.A. Quimivita, S.A. División Laboratorio Romero Muebles de Laboratorio, S.A. Rubilabor, S.L.
Serviquimia, S.L.
Spetec GmbH Tecnología para Diagnóstico e Investigación (TDI, S.A.) Tecnoquim, S.L.
Telstar Technologies, S.L.
Thermo Fisher Scientific SLU Tolquimex, S.L.
Trallero & Schlee, S.L. Vidra Foc, S.A. VWR International Eurolab, S.L.
Cabinas de seguridad biológica Acefe, S.A. AES Laboratorio, S.A.
Agem, Auxiliar General de Electromedicina, S.A. Análisis Vínicos, S.L. Anorsa (Aparatos Normalizados, S.A.)
Bercu Instruments, S.L. Bioser, S.A.
Burdinola, S. Coop.
CCI Control de Calidad Chemlabor, S.L.
Comercial Tecno, S.L.
Distribuciones Científicas Sanitarias Distrilab, S.L
Fisher Scientific Formimetal, S.L.
Grupo Taper
Iberlab, S.L.
IUCT
Izasa Scientific J. Jimeno S.A. Labolan, S.L. Laborat, S.L.
Labortech Waldner, S.L.
Levantina de Laboratorios, S.L.
Luis Frechilla, S.L.
Lumaquin, S.A.
Luwa Española, S.A. Nirco, S.L.
Normalab, S.L.
Omadisa Industrias del Laboratorio, S.A. Quimivita, S.A. División Laboratorio
Romero Muebles de Laboratorio, S.A. Rubilabor, S.L. Serviquimia, S.L. Tecnología para Diagnóstico e Investigación (TDI, S.A.)
Tecnoquim, S.L.
Telstar Technologies, S.L.
Thermo Fisher Scientific SLU Tiselab - Soluciones GMP para industrial Biofarmacéutica y afines Tolquimex, S.L.
Trallero & Schlee, S.L.
Vidra Foc, S.A.
VWR International Eurolab, S.L.
Calderas de vapor Aningas, S.A.
Aplein Ingenieros, S.A.
CCI Control de Calidad
Comexglobal S.R.L.
Distrilab, S.L
Fisher Scientific
Iberlab, S.L.
Lidering, S.A.U.
Luis Frechilla, S.L.
Omadisa Industrias del Laboratorio, S.A.
Quimivita, S.A. División Laboratorio
Rubilabor, S.L.
Serviquimia, S.L.
Tecno Química Veyca, S.L.
Vidra Foc, S.A.
Cámaras climáticas
Acefe, S.A.
Álava Ingenieros, S.A.
Arcox
Bercu Instruments, S.L.
CCI Control de Calidad Distrilab, S.L
Grupo Taper
Landes Poli Ibérica, S.L.
Levantina de Laboratorios, S.L.
Luis Frechilla, S.L.
Lumaquin, S.A.
Quimivita, S.A. División Laboratorio Sartorius Stedim Spain, S.A.U.
Serviquimia, S.L.
Thermo Fisher Scientific SLU
Tecnoquim, S.L.
Testing Lab Equipments, S.L. Trallero & Schlee, S.L. Vidra Foc, S.A.
Centrifugación
Acefe, S.A.
Agem, Auxiliar General de Electromedicina, S.A.
Análisis Vínicos, S.L.
Anorsa (Aparatos Normalizados, S.A.)
Arcox
Assainissement Technique International, S.L.
Auxilab, S.L.
Bercu Instruments, S.L.
Bioser, S.A.
Chemlabor, S.L.
Comecta, S.A. - Grupo Selecta Comercial Labor, S.A.
Comercial Rafer, S.L.
Comercial Tecno, S.L.
Comexglobal S.R.L. Deltalab, S.L.U.
Distribuciones Científicas Sanitarias
Distrilab, S.L
Ecogen, S.L. Eppendorf Ibérica, S.L.U. Fisher Scientific Grupo Taper Iberlab, S.L. IUCT
Izasa Scientific J. Jimeno S.A. J. P. Selecta, S.A. Labolan, S.L. Laborat, S.L. Levantina de Laboratorios, S.L. Luis Frechilla, S.L. Lumaquin, S.A. Net Interlab, S.A.L. Nirco, S.L. Normalab, S.L. Omadisa Industrias del Laboratorio, S.A. Ortoalresa Quimivita, S.A. División Laboratorio
Riera Nadeu, S.A. Rubilabor, S.L. Sarstedt, S.A.U
Sartorius Stedim Spain, S.A.U. Serviquimia, S.L. Tecno Química Veyca, S.L. Tecnoquim, S.L. Tema Maquinaria, S.A. Thermo Fisher Scientific SLU Tolquimex, S.L. Trallero & Schlee, S.L. Vidra Foc, S.A.
VWR International Eurolab, S.L.
Cestos y gradillas
Acefe, S.A.
Agem, Auxiliar General de Electromedicina, S.A. Anorsa (Aparatos Normalizados, S.A.) Assainissement Technique International, S.L. Auxilab, S.L. CCI Control de Calidad CISA - Cedacería Industrial, S.L. Comecta, S.A. - Grupo Selecta Comercial Labor, S.A. Comercial Rafer, S.L. Comercial Tecno, S.L. Deltalab, S.L.U. Distribuciones Científicas Sanitarias Distrilab, S.L Fisher Scientific Grupo Taper Iberlab, S.L. IUCT
J. Jimeno S.A. J. P. Selecta, S.A. Labbox Labware, S.L. Labolan, S.L. Laborat, S.L. Levantina de Laboratorios, S.L. Luis Frechilla, S.L. Lumaquin, S.A. Mettler-Toledo, S.A.E. Nirco, S.L. Normalab, S.L. Omadisa Industrias del Laboratorio, S.A. Quilinox, S.L. Quimivita, S.A. División Laboratorio Rubilabor, S.L. Science Basic Solutions, S.L. - SBS, S.L. Serviquimia, S.L. Sugelabor, S.A. Tecno Química Veyca, S.L. Thermo Fisher Scientific (Barcelona) Tolquimex, S.L.
Trallero & Schlee, S.L. Vidra Foc, S.A. Vidrio Industrial Pobel, S.A.
VWR International Eurolab, S.L.
Colorantes
Anorsa (Aparatos Normalizados, S.A.)
Bentley Instruments Chemlabor, S.L.
Comercial Tecno, S.L.
Deltalab, S.L.U.
Distribuciones Científicas Sanitarias
Distrilab, S.L
Fisher Scientific
Iberlab, S.L.
Iberlaser, S.A.
J. Jimeno S.A.
Labbox Labware, S.L.
Lasing, S.A.
Levantina de Laboratorios, S.L. Luis Frechilla, S.L.
Panreac Química, S.L.U.
Quimivita, S.A. División Laboratorio Rubilabor, S.L.
Serviquimia, S.L.
Tolquimex, S.L.
Trallero & Schlee, S.L.
Vidra Foc, S.A.
VWR International Eurolab, S.L.
Colorímetros
Acefe, S.A.
Agem, Auxiliar General de Electromedicina, S.A.
Análisis Vínicos, S.L.
Análisis y Filtración, S.L.
Anisol Equipos, S.L.
Anorsa (Aparatos Normalizados, S.A.)
Aplein Ingenieros, S.A.
Assainissement Technique International, S.L.
Auxilab, S.L.
AxFlow, S.A.
Bercu Instruments, S.L. Chemlabor, S.L.
Comecta, S.A. - Grupo Selecta Comercial Labor, S.A. Comercial Tecno, S.L.
Dinter-Dinko
Distribuciones Científicas Sanitarias
Distrilab, S.L Equitrol, S.L.
Esindus, S.A.
Fisher Scientific Gomensoro, S.A.
Grupo Taper
Hach Lange Spain, S.L.U.
Hanna Instruments
Iberlab, S.L.
Iberlaser, S.A. Instrumentación Analítica, S.A.
IUCT
Izasa Scientific J. Jimeno S.A.
J. P. Selecta, S.A.
Labolan, S.L. Labprocess
Landes Poli Ibérica, S.L. Levantina de Laboratorios, S.L. Luis Frechilla, S.L. Lumaquin, S.A.
Maselli Ibérica
Metrotec, S.A.
Omadisa Industrias del Laboratorio, S.A.
Panreac Química, S.L.U. Quimivita, S.A. División Laboratorio Rubilabor, S.L. Serviquimia, S.L. Sugelabor, S.A.
Surcis, S.L.
Tecno Química Veyca, S.L. Tecnoquim, S.L.
Tecop, S.A.
Thermo Fisher Scientific (Barcelona) Tolquimex, S.L.
Trallero & Schlee, S.L.
Vidra Foc, S.A.
VWR International Eurolab, S.L.
Conducciones
Acefe, S.A.
Arcamo Controls, S.A.
CCI Control de Calidad Lidering, S.A.U.
Tecnium - Casals Cardona Industrial, S.A.
Conexiones
Acefe, S.A.
Arcamo Controls, S.A.
CCI Control de Calidad Quilinox, S.L. Serviquimia, S.L. Symta, S.L.L.
Consumibles
Acefe, S.A.
AES Laboratorio, S.A.
Agem, Auxiliar General de Electromedicina, S.A. Agilent Technologies Spain, S.L. Analab, S.A.
Análisis Vínicos, S.L.
Anorsa (Aparatos Normalizados, S.A.)
Aplicaciones Analíticas Doménech, S.L.
Arcamo Controls, S.A.
Assainissement Technique International, S.L.
Auxilab, S.L.
AxFlow, S.A.
Bercu Instruments, S.L. Bioser, S.A.
CCI Control de Calidad Chemlabor, S.L.
CHMLAB Group
Comecta, S.A. - Grupo Selecta Comercial Labor, S.A. Comercial Rafer, S.L. Comercial Tecno, S.L.
Deltalab, S.L.U.
Distribuciones Científicas Sanitarias
Distrilab, S.L
Ecogen, S.L. Eppendorf Ibérica, S.L.U. Fedelco, S.L.
Fisher Scientific
Fine Science Tools GmbH (FST)
Grupo Taper
Hach Lange Spain, S.L.U.
Iberlab, S.L.
Instrumentación Analítica, S.A.
IUCT
Izasa Scientific J. Jimeno S.A.
J. P. Selecta, S.A.
Kern Frío, S.L.
Konik-Tech
Labbox Labware, S.L.
Laboratorios Microkit, S.L. Levantina de Laboratorios, S.L. Leica Microsistemas, S.A. Linealab,S.L.
Luis Frechilla, S.L.
Lumaquin, S.A.
Maquinsa (Materiales Técnicos Maquinsa, S.L.)
Mettler-Toledo, S.A.E. Normalab, S.L.
Omadisa Industrias del Laboratorio, S.A. Panreac Química, S.L.U.
Quimivita, S.A. División Laboratorio R-Biopharm España, S.A.U
Rectus Tema, S.L.
Rubilabor, S.L.
Sarstedt, S.A.U
Serviquimia, S.L.
Shodex, Showa Denko Europe GmbH
Socorex Isba, S.A.
Sugelabor, S.A.
Symta, S.L.L.
Tecnología para Diagnóstico e Investigación (TDI, S.A.)
Tecny Fluor (Materiales Tecny Fluor, S.L.)
Thermo Fisher Scientific SLU
Tiselab - Soluciones GMP para industrial Biofarmacéutica y afines Tolquimex, S.L.
Trallero & Schlee, S.L.
Varian Ibérica, S.L. Vertex Technics, S.L. Vidra Foc, S.A. VWR International Eurolab, S.L.
Contadores de centelleo
Anorsa (Aparatos Normalizados, S.A.)
Distrilab, S.L Iberlab, S.L. J. Jimeno S.A. Quilinox, S.L. Rubilabor, S.L. Serviquimia, S.L. Vidra Foc, S.A.
Contadores de colonias
Acefe, S.A. AES Laboratorio, S.A. Agem, Auxiliar General de Electromedicina, S.A. Anisol Equipos, S.L. Anorsa (Aparatos Normalizados, S.A.)
Aplein Ingenieros, S.A. Bentley Instruments
Bioser, S.A. Chemlabor, S.L. Comercial Tecno, S.L.
Distribuciones Científicas Sanitarias
Distrilab, S.L Equitrol, S.L.
Fisher Scientific Gomensoro, S.A. Iberlab, S.L. IUCT
Izasa Scientific J. Jimeno S.A. J. P. Selecta, S.A.
Labolan, S.L. Laborat, S.L. Levantina de Laboratorios, S.L. Luis Frechilla, S.L. Lumaquin, S.A. Mathias, S.L. Omadisa Industrias del Laboratorio, S.A. Quilinox, S.L. Quimivita, S.A. División Laboratorio Rubilabor, S.L. Science Basic Solutions, S.L. - SBS, S.L. Serviquimia, S.L.
Tecil
Tecnología para Diagnóstico e Investigación (TDI, S.A.) Tecnoquim, S.L. Tolquimex, S.L. Trallero & Schlee, S.L. Vidra Foc, S.A. Vidrio Industrial Pobel, S.A. VWR International Eurolab, S.L.
Contadores de partículas
Acefe, S.A. Agem, Auxiliar General de Electromedicina, S.A. Álava Ingenieros, S.A. Anorsa (Aparatos Normalizados, S.A.)
Beko Tecnológica, S.L. Bentley Instruments
Bercu Instruments, S.L. Chemlabor, S.L.
Distribuciones Científicas Sanitarias Distrilab, S.L Equitrol, S.L. Esindus, S.A.
Fisher Scientific
Hach Lange Spain, S.L.U. Haver & Boecker Telas Metálicas Iberlab, S.L. Instrumentos Testo, S.A.
Izasa Scientific J. Jimeno S.A.
Omadisa Industrias del Laboratorio, S.A. Representaciones Jürgen Appenrodt
Rubilabor, S.L.
Serviquimia, S.L.
Tecil
Tiselab - Soluciones GMP para industrial Biofarmacéutica y afines
Vertex Technics, S.L.
Vidra Foc, S.A.
Criocongeladores
Acefe, S.A.
AL Air Liquide España, S.A.
Anorsa (Aparatos Normalizados, S.A.)
Arcox
Carburos Metálicos, S.A. - Grupo Air Products
CCI Control de Calidad Chemlabor, S.L.
Comercial Tecno, S.L.
Distribuciones Científicas Sanitarias
Distrilab, S.L
Fisher Scientific Grupo Taper
Iberlab, S.L.
Ingeniería de Climas para Procesos, S.L. Instrumentación Analítica, S.A.
Izasa Scientific
J. Jimeno S.A.
Julabo GmbH
Kern Frío, S.L.
Levantina de Laboratorios, S.L.
Linealab,S.L.
Lumaquin, S.A.
Net Interlab, S.A.L.
Nippon Gases
Nirco, S.L.
Normalab, S.L.
Omadisa Industrias del Laboratorio, S.A. Quimivita, S.A. División Laboratorio Rubilabor, S.L.
Sartorius Stedim Spain, S.A.U.
Serviquimia, S.L.
Telstar Technologies, S.L.
Thermo Fisher Scientific SLU
Tolquimex, S.L.
Trallero & Schlee, S.L. Vidra Foc, S.A.
VWR International Eurolab, S.L.
Cubetas para espectrofotometría Acefe, S.A.
Agem, Auxiliar General de Electromedicina, S.A. Agilent Technologies Spain, S.L. Análisis Vínicos, S.L.
Anorsa (Aparatos Normalizados, S.A.) Auxilab, S.L.
Bentley Instruments
Bercu Instruments, S.L. Chemlabor, S.L. Comecta, S.A. - Grupo Selecta Comercial Tecno, S.L. Deltalab, S.L.U. Dinter-Dinko Distribuciones Científicas Sanitarias Distrilab, S.L Fedelco, S.L. Fisher Scientific Gomensoro, S.A. Grupo Taper Hach Lange Spain, S.L.U. Hanna Instruments Hellma Hispania, S.L. Iberlab, S.L.
IUCT
Izasa Scientific J. Jimeno S.A. Labbox Labware, S.L. Laborat, S.L. Levantina de Laboratorios, S.L.
Linealab,S.L.
Luis Frechilla, S.L.
Lumaquin, S.A. Mettler-Toledo, S.A.E. Nirco, S.L.
Omadisa Industrias del Laboratorio, S.A.
Panreac Química, S.L.U.
Quimivita, S.A. División Laboratorio Rubilabor, S.L. Serviquimia, S.L. Sugelabor, S.A. Tecnoquim, S.L.
Titan Eko, S.L. Sucursal en España Tolquimex, S.L.
Trallero & Schlee, S.L.
Varian Ibérica, S.L.
Vidra Foc, S.A.
VWR International Eurolab, S.L.
Cultivos anaerobios Acefe, S.A.
AES Laboratorio, S.A.
Anorsa (Aparatos Normalizados, S.A.)
Bioser, S.A.
Chemlabor, S.L.
Deltalab, S.L.U.
Distribuciones Científicas Sanitarias
Distrilab, S.L
Fisher Scientific Iberlab, S.L.
IUCT
J. Jimeno S.A.
Laborat, S.L.
Laboratorios Microkit, S.L.
LGC Standards, S.L.U.
Luis Frechilla, S.L.
Nirco, S.L.
Omadisa Industrias del Laboratorio, S.A.
Panreac Química, S.L.U.
Quimivita, S.A. División Laboratorio
Rubilabor, S.L.
Sartorius Stedim Spain, S.A.U.
Serviquimia, S.L.
Tecnología para Diagnóstico e Investigación (TDI, S.A.)
Thermo Fisher Scientific SLU Tolquimex, S.L.
Trallero & Schlee, S.L.
Vidra Foc, S.A.
VWR International Eurolab, S.L.
Desinfección por contacto
Anorsa (Aparatos Normalizados, S.A.)
Chemlabor, S.L.
Cosemar Ozono, S.L. Deltalab, S.L.U.
Distribuciones Científicas Sanitarias Distrilab, S.L
Fisher Scientific Iberlab, S.L.
IUCT
J. Jimeno S.A.
Laboratorios Microkit, S.L. Luis Frechilla, S.L.
Omadisa Industrias del Laboratorio, S.A. Quimivita, S.A. División Laboratorio Rubilabor, S.L.
Serviquimia, S.L.
Steris Iberia, S.A. Tecnoquim, S.L.
Tiselab - Soluciones GMP para industrial Biofarmacéutica y afines Tolquimex, S.L.
Vidra Foc, S.A.
VWR International Eurolab, S.L.
Dosificación y pipeteo
Acefe, S.A.
Agem, Auxiliar General de Electromedicina, S.A.
Anorsa (Aparatos Normalizados, S.A.)
Assainissement Technique International, S.L. Auquime, S.A. Auxilab, S.L. Bentley Instruments Bercu Instruments, S.L. Bioser, S.A. Bombas Grundfos España, S.A. Chemlabor, S.L. Comecta, S.A. - Grupo Selecta Comercial Labor, S.A. Comercial Rafer, S.L. Comercial Tecno, S.L. Deltalab, S.L.U. Distribuciones Científicas Sanitarias Distrilab, S.L Ecogen, S.L. Eppendorf Ibérica, S.L.U. Fisher Scientific Gomensoro, S.A. Grupo Taper Hirschmann Laborgeräte GmbH & Co. KG Iberlab, S.L. IUCT Izasa Scientific J. Jimeno S.A. Labbox Labware, S.L. Labolan, S.L. Laborat, S.L. Levantina de Laboratorios, S.L. Luis Frechilla, S.L. Lumaquin, S.A. Mettler-Toledo, S.A.E. Nirco, S.L. Normalab, S.L. Omadisa Industrias del Laboratorio, S.A. Panreac Química, S.L.U. Quimivita, S.A. División Laboratorio Rubilabor, S.L. Sarstedt, S.A.U Serviquimia, S.L. Socorex Isba, S.A. Tecan Ibérica Instrumentación, S.L. Tecnoquim, S.L. Thermo Fisher Scientific SLU Tolquimex, S.L. Trallero & Schlee, S.L. Vidra Foc, S.A. Vidrio Industrial Pobel, S.A. VWR International Eurolab, S.L.
Electrodos selectivos Agem, Auxiliar General de Electromedicina, S.A. Anorsa (Aparatos Normalizados, S.A.) Assainissement Technique International, S.L. Bulcase, S.A. Chemlabor, S.L. Comecta, S.A. - Grupo Selecta Comercial Rafer, S.L. Comercial Tecno, S.L. Crison Instruments, S.A. Dinter-Dinko Distribuciones Científicas Sanitarias Distrilab, S.L Esindus, S.A. Fedelco, S.L. Fisher Scientific Gomensoro, S.A. Grupo Taper Guemisa
Hach Lange Spain, S.L.U. Hanna Instruments Herter Instruments, S.L. Iberlab, S.L. Instrumentación Analítica, S.A. Izasa Scientific J. Jimeno S.A. Laborat, S.L. Labprocess
Levantina de Laboratorios, S.L. Linealab,S.L. Luis Frechilla, S.L. Lumaquin, S.A.
Matelco, S.A.
Mettler-Toledo, S.A.E.
Net Interlab, S.A.L. Normalab, S.L.
Omadisa Industrias del Laboratorio, S.A. Quimivita, S.A. División Laboratorio Rubilabor, S.L.
Serviquimia, S.L.
Surcis, S.L.
Tecil
Tecnoquim, S.L.
Thermo Fisher Scientific SLU Tolquimex, S.L.
Trallero & Schlee, S.L.
Vidra Foc, S.A.
VWR International Eurolab, S.L.
Electroválvulas
Arcamo Controls, S.A.
Knauer Wissenschaftliche Geräte GmbH Laborat, S.L.
Quilinox, S.L.
Trallero & Schlee, S.L.
Esterilizadores
Acefe, S.A.
Agem, Auxiliar General de Electromedicina, S.A.
Anorsa (Aparatos Normalizados, S.A.)
Antonio Matachana, S.A.
Antonio Matachana, S.A. Div. Laboratorios
Bercu Instruments, S.L.
CCI Control de Calidad Chemlabor, S.L.
Comercial Rafer, S.L.
Comercial Tecno, S.L.
Cosemar Ozono, S.L.
Deltalab, S.L.U.
Distribuciones Científicas Sanitarias
Distrilab, S.L
Fisher Scientific Gomensoro, S.A.
Grupo Taper Iberlab, S.L.
IUCT
Izasa Scientific J. Jimeno S.A. J. P. Selecta, S.A. Laborat, S.L. Levantina de Laboratorios, S.L. Luis Frechilla, S.L. Lumaquin, S.A. Normalab, S.L.
Omadisa Industrias del Laboratorio, S.A. Quimivita, S.A. División Laboratorio R. Espinar S.L. Rubilabor, S.L. Science Basic Solutions, S.L. - SBS, S.L. Serviquimia, S.L.
Steris Iberia, S.A. Tecno Química Veyca, S.L. Tiselab - Soluciones GMP para industrial Biofarmacéutica y afines Tolquimex, S.L.
Trallero & Schlee, S.L.
Vidra Foc, S.A.
VWR International Eurolab, S.L.
Estufas
Acefe, S.A.
AES Laboratorio, S.A.
Agem, Auxiliar General de Electromedicina, S.A.
Anorsa (Aparatos Normalizados, S.A.)
Antonio Matachana, S.A.
Antonio Matachana, S.A. Div. Laboratorios Arcox
Assainissement Technique International, S.L. Auxilab, S.L.
Bautermic, S.A.
Bercu Instruments, S.L. Biometa, S.A. Bioser, S.A.
CCI Control de Calidad Chemlabor, S.L. Comercial Labor, S.A. Comercial Rafer, S.L. Comercial Tecno, S.L. Comexglobal S.R.L. Dinter-Dinko
Distribuciones Científicas Sanitarias Distrilab, S.L Ecogen, S.L. Emison
Entesis Technology, S.L. Fisher Scientific Gomensoro, S.A. Grupo Taper Iberlab, S.L. Ineltec, S.L.
Ingeniería de Climas para Procesos, S.L.
IUCT
Izasa Scientific J. Bonals, S.A.
J. Jimeno S.A.
J. P. Selecta, S.A.
Labolan, S.L.
Laborat, S.L.
Landes Poli Ibérica, S.L. Levantina de Laboratorios, S.L. Linealab,S.L.
Luis Frechilla, S.L.
Lumaquin, S.A.
Mathias, S.L.
Metrotec, S.A.
Munters Spain, S.A.
Net Interlab, S.A.L.
Nirco, S.L.
Normalab, S.L.
Omadisa Industrias del Laboratorio, S.A.
Quimivita, S.A. División Laboratorio
R. Espinar S.L.
Rubilabor, S.L.
S.A. de Hornos Automáticos
Sartorius Stedim Spain, S.A.U.
Serviquimia, S.L.
Tecno Química Veyca, S.L.
Tecnoquim, S.L.
Thermo Fisher Scientific SLU
Tolquimex, S.L.
Trallero & Schlee, S.L.
Vertex Technics, S.L.
Vidra Foc, S.A.
VWR International Eurolab, S.L.
Gases para espectrometría, cromatografía y analizadores específicos
Abelló Linde, S.A.
AL Air Liquide España, S.A.
Anorsa (Aparatos Normalizados, S.A.)
Beko Tecnológica, S.L.
Carburos Metálicos, S.A. - Grupo Air Products Chemlabor, S.L.
Distribuciones Científicas Sanitarias
Distrilab, S.L
Domnick Hunter Ibérica Equipamiento Científico Fedelco, S.L.
Iberlab, S.L.
Instrumentación Analítica, S.A. Instrumentos Testo, S.A.
IUCT
Izasa Scientific J. Jimeno S.A. Nippon Gases
Rubilabor, S.L.
Sensotran, S.L.
Serviquimia, S.L. Sistemas Electrónicos de Detección y Análisis, S.L. - SEDA Sugelabor, S.A. Tecop, S.A. Tolquimex, S.L. Vidra Foc, S.A.
Generadores de vapor Aningas, S.A. Anorsa (Aparatos Normalizados, S.A.)
Antonio Matachana, S.A. CCI Control de Calidad Chemlabor, S.L. Comercial Labor, S.A. Comercial Tecno, S.L. Distrilab, S.L Fisher Scientific Hanseata, S.A. Humysec - 2000, S.L. Iberlab, S.L. Izasa Scientific J. Jimeno S.A. Normalab, S.L. Omadisa Industrias del Laboratorio, S.A. Quimivita, S.A. División Laboratorio Rubilabor, S.L. Serviquimia, S.L. Steris Iberia, S.A. Tiselab - Soluciones GMP para industrial Biofarmacéutica y afines Tolquimex, S.L. Trallero & Schlee, S.L. Vidra Foc, S.A. Grifería, duchas, lavaojos
Analab, S.A. Anorsa (Aparatos Normalizados, S.A.)
Asecos Seguridad y Protección del Medio Ambiente, S.L. Borda Laboratorios
Burdinola, S. Coop. Carlos Árboles, S.A. Chemlabor, S.L. Comercial Tecno, S.L. Deltalab, S.L.U. Dimanlab, S.L. Distribuciones Científicas Sanitarias Distrilab, S.L Fisher Scientific Flores Valles, S.A. Iberfluid Instruments, S.A. Iberlab, S.L.
IUCT
Izasa Scientific J. Jimeno S.A. Laborat, S.L. Labortech Waldner, S.L. Levantina de Laboratorios, S.L. Luis Frechilla, S.L. Maquinsa (Materiales Técnicos Maquinsa, S.L.)
Modulabo, S.L. Normalab, S.L. Omadisa Industrias del Laboratorio, S.A. Quilinox, S.L. Quimivita, S.A. División Laboratorio Romero Muebles de Laboratorio, S.A. Rubilabor, S.L. Serviquimia, S.L. Tecno Química Veyca, S.L. Tecnoquim, S.L. Tecop, S.A. Tolquimex, S.L. Trallero & Schlee, S.L. Vidra Foc, S.A.
VWR International Eurolab, S.L.
Higrómetros
Agem, Auxiliar General de Electromedicina, S.A. Álava Ingenieros, S.A.
Analab, S.A.
Anisol Equipos, S.L.
Anorsa (Aparatos Normalizados, S.A.)
Aries Ingeniería y Sistemas, S.A.
Auxilab, S.L.
Bioser, S.A.
Bulcase, S.A.
Casella España, S.A.
CCI Control de Calidad Chemlabor, S.L.
Comercial Tecno, S.L.
Distrilab, S.L
Electromediciones Kainos, S.A.
Electrónica de Medida y Control, S.A. Equitrol, S.L.
Esindus, S.A.
Fisher Scientific
Guemisa
Hanseata, S.A.
Herter Instruments, S.L. Humysec - 2000, S.L. Iberlab, S.L.
Instrumentos Testo, S.A.
Izasa Scientific
J. Jimeno S.A.
Laborat, S.L.
Labprocess
Levantina de Laboratorios, S.L.
Luis Frechilla, S.L.
Lumaquin, S.A.
Mathias, S.L.
Metrotec, S.A. Normalab, S.L.
Omadisa Industrias del Laboratorio, S.A. Quimivita, S.A. División Laboratorio Rubilabor, S.L.
Serviquimia, S.L.
Tecnoquim, S.L.
Tolquimex, S.L.
Trallero & Schlee, S.L.
Vidra Foc, S.A.
Vidrio Industrial Pobel, S.A. VWR International Eurolab, S.L.
Homogeneizadores
Acefe, S.A. AES Laboratorio, S.A.
Agem, Auxiliar General de Electromedicina, S.A. Anorsa (Aparatos Normalizados, S.A.) Auquime, S.A.
Bercu Instruments, S.L. Bioser, S.A. Chemlabor, S.L.
Comecta, S.A. - Grupo Selecta Comercial Rafer, S.L. Comercial Tecno, S.L. Dinter-Dinko Distribuciones Científicas Sanitarias Distrilab, S.L Fedelco, S.L.
Filtra Vibración, S.L. Fisher Scientific Frances Micron España, S.A. Fritsch GmbH - Molienda y Medición Gomensoro, S.A.
Grupo Taper
Iberlab, S.L.
IKA-Werke GmbH & Co.Kg Instrumentos Físicos Ibérica, S.L. IUCT
Izasa Scientific J. Jimeno S.A.
Labolan, S.L.
Laborat, S.L.
Levantina de Laboratorios, S.L. Linealab,S.L.
Luis Frechilla, S.L.
Lumaquin, S.A.
Mathias, S.L.
Omadisa Industrias del Laboratorio, S.A.
Quimivita, S.A. División Laboratorio
Retsch GmbH
Rubilabor, S.L.
Sartorius Stedim Spain, S.A.U. Serviquimia, S.L.
Tecil
Tecnoquim, S.L.
Tolquimex, S.L.
Trallero & Schlee, S.L.
Vidra Foc, S.A.
Vidrio Industrial Pobel, S.A.
VWR International Eurolab, S.L.
Hornos y estufas
Acefe, S.A.
AES Laboratorio, S.A.
Agem, Auxiliar General de Electromedicina, S.A. Álava Ingenieros, S.A.
Aningas, S.A.
Anorsa (Aparatos Normalizados, S.A.)
Antonio Matachana, S.A.
Antonio Matachana, S.A. Div. Laboratorios
Arcox
Assainissement Technique International, S.L.
Auxilab, S.L.
Bautermic, S.A.
Bercu Instruments, S.L.
Biometa, S.A.
Bioser, S.A.
CCI Control de Calidad Chemlabor, S.L.
Comecta, S.A. - Grupo Selecta Comercial Labor, S.A.
Comercial Rafer, S.L.
Comercial Tecno, S.L.
Comexglobal S.R.L.
Dinter-Dinko
Distribuciones Científicas Sanitarias Distrilab, S.L Emison
Entesis Technology, S.L.
Fisher Scientific
Forns Hobersal, S.L.
Gomensoro, S.A. Grupo Taper Iberlab, S.L. Ineltec, S.L.
Ingeniería de Climas para Procesos, S.L.
IUCT
Izasa Scientific
J. Bonals, S.A.
J. Jimeno S.A. J. P. Selecta, S.A. Knauer Wissenschaftliche Geräte GmbH Labolan, S.L. Laborat, S.L. Landes Poli Ibérica, S.L. Levantina de Laboratorios, S.L. Linealab,S.L. Luis Frechilla, S.L. Lumaquin, S.A. Mathias, S.L. Metrotec, S.A. Mettler-Toledo, S.A.E. Net Interlab, S.A.L. Nirco, S.L. Normalab, S.L.
Omadisa Industrias del Laboratorio, S.A. Quimivita, S.A. División Laboratorio
R. Espinar S.L. Rubilabor, S.L.
S.A. de Hornos Automáticos Serviquimia, S.L. Ovan Equipos Laboratorio (Suministros Grupo Esper S.L) Surcis, S.L. Tecno Química Veyca, S.L. Tecnoquim, S.L.
Testing Lab Equipments, S.L. Thermo Fisher Scientific SLU Tolquimex, S.L. Trallero & Schlee, S.L. Vertex Technics, S.L. Vidra Foc, S.A. VWR International Eurolab, S.L. Watlow Iberica SLU
Humidificadores / deshumidificadores Agem, Auxiliar General de Electromedicina, S.A. Anorsa (Aparatos Normalizados, S.A.) Assainissement Technique International, S.L. CCI Control de Calidad Comercial Rafer, S.L. Distrilab, S.L Fisher Scientific Hanseata, S.A. Humysec - 2000, S.L. Iberlab, S.L. Ineltec, S.L. IUCT Izasa Scientific J. Jimeno S.A. Laborat, S.L. Manema, S.A. Mettler-Toledo, S.A.E. Munters Spain, S.A. Omadisa Industrias del Laboratorio, S.A. Quimivita, S.A. División Laboratorio Rubilabor, S.L. Serviquimia, S.L. Tecno Química Veyca, S.L. Tecnología para Diagnóstico e Investigación (TDI, S.A.) Tecnoquim, S.L. Tolquimex, S.L. Vidra Foc, S.A.
Incubadores por CO2 Acefe, S.A. AES Laboratorio, S.A. Agem, Auxiliar General de Electromedicina, S.A. Anorsa (Aparatos Normalizados, S.A.) Assainissement Technique International, S.L. Bercu Instruments, S.L. Carl Zeiss Iberia, S.L. CCI Control de Calidad Chemlabor, S.L. Comercial Rafer, S.L. Comercial Tecno, S.L. Distribuciones Científicas Sanitarias Distrilab, S.L Ecogen, S.L. Eppendorf Ibérica, S.L.U. Fisher Scientific Grupo Taper Iberlab, S.L. Iberlaser, S.A. Izasa Scientific J. Jimeno S.A. J. P. Selecta, S.A. Laborat, S.L. Levantina de Laboratorios, S.L. Linealab,S.L. Luis Frechilla, S.L. Lumaquin, S.A. Nirco, S.L. Omadisa Industrias del Laboratorio, S.A. Quimivita, S.A. División Laboratorio Rubilabor, S.L. Sartorius Stedim Spain, S.A.U. Serviquimia, S.L. Tecnoquim, S.L. Thermo Fisher Scientific SLU Tolquimex, S.L. Trallero & Schlee, S.L. Vertex Technics, S.L.
Vidra Foc, S.A.
VWR International Eurolab, S.L.
Instrumentación para conducta animal / animales
Anorsa (Aparatos Normalizados, S.A.)
Bacsa
CCI Control de Calidad Distribuciones Científicas Sanitarias
Fisher Scientific Fine Science Tools GmbH (FST) Iberlab, S.L.
J. Jimeno S.A. Nirco, S.L. Rubilabor, S.L. Serviquimia, S.L. Sugelabor, S.A.
Tecnología para Diagnóstico e Investigación (TDI, S.A.)
Vidra Foc, S.A.
Láseres
Álava Ingenieros, S.A.
Anisol Equipos, S.L.
Carl Zeiss Iberia, S.L.
Fisher Scientific Fritsch GmbH - Molienda y Medición Iberlab, S.L.
Iberlaser, S.A.
Instrumatic Española, S.A. Izasa Scientific
Lasing, S.A. Rubilabor, S.L.
Tecno Química Veyca, S.L. Tecnología para Diagnóstico e Investigación (TDI, S.A.)
Lavado de vidrio
Agem, Auxiliar General de Electromedicina, S.A. Anorsa (Aparatos Normalizados, S.A.)
Antonio Matachana, S.A. Chemlabor, S.L. Comecta, S.A. - Grupo Selecta Comercial Rafer, S.L. Comercial Tecno, S.L.
Cosemar Ozono, S.L.
Deltalab, S.L.U. Distribuciones Científicas Sanitarias Distrilab, S.L
Elga Labwater (Grupo Veolia Water Technologies) Fisher Scientific Grupo Taper
Iberlab, S.L.
IUCT
Izasa Scientific J. Jimeno S.A. Laborat, S.L. Levantina de Laboratorios, S.L. Linealab,S.L. Luis Frechilla, S.L.
Miele - Centre Calvet Miele, S.A. Normalab, S.L.
Omadisa Industrias del Laboratorio, S.A. Panreac Química, S.L.U. Quimivita, S.A. División Laboratorio Rubilabor, S.L.
Serviquimia, S.L.
Tecno Química Veyca, S.L. Tecnoquim, S.L.
Tiselab - Soluciones GMP para industrial Biofarmacéutica y afines Tolquimex, S.L.
Trallero & Schlee, S.L.
Vidra Foc, S.A.
Vidrio Industrial Pobel, S.A.
VWR International Eurolab, S.L.
Material de cristal
Acefe, S.A.
Agem, Auxiliar General de Electromedicina, S.A.
Anorsa (Aparatos Normalizados, S.A.)
Assainissement Technique International, S.L.
Auxilab, S.L.
CCI Control de Calidad Chemlabor, S.L.
Comercial Labor, S.A. Comercial Tecno, S.L. Deltalab, S.L.U.
Distribuciones Científicas Sanitarias Distrilab, S.L Fedelco, S.L.
Fisher Scientific Iberlab, S.L.
IUCT
J. Jimeno S.A.
Labbox Labware, S.L. Laborat, S.L. Levantina de Laboratorios, S.L. Linealab,S.L.
Luis Frechilla, S.L. Lumaquin, S.A. Normalab, S.L.
Omadisa Industrias del Laboratorio, S.A. Quilinox, S.L.
Quimivita, S.A. División Laboratorio Rubilabor, S.L.
Serviquimia, S.L.
Tecno Química Veyca, S.L.
Tecnoquim, S.L.
Tolquimex, S.L.
Trallero & Schlee, S.L.
Vidra Foc, S.A.
Vidrio Industrial Pobel, S.A.
VWR International Eurolab, S.L.
Material de plástico desechable
AES Laboratorio, S.A.
Agem, Auxiliar General de Electromedicina, S.A. Anorsa (Aparatos Normalizados, S.A.)
Assainissement Technique International, S.L. Auxilab, S.L.
Bioser, S.A.
Chemlabor, S.L.
Comercial Rafer, S.L.
Comercial Tecno, S.L.
Deltalab, S.L.U.
Distribuciones Científicas Sanitarias Distrilab, S.L Ecogen, S.L.
Eppendorf Ibérica, S.L.U. Fedelco, S.L.
Fisher Scientific
Gilson International BV (sucursal España) Grupo Taper Iberlab, S.L. IUCT
J. Jimeno S.A.
J. P. Selecta, S.A. Labbox Labware, S.L. Labolan, S.L. Laborat, S.L. Levantina de Laboratorios, S.L. Luis Frechilla, S.L. Lumaquin, S.A. Nirco, S.L. Normalab, S.L.
Omadisa Industrias del Laboratorio, S.A. Panreac Química, S.L.U. Quimivita, S.A. División Laboratorio Rubilabor, S.L. Sarstedt, S.A.U
Serviquimia, S.L. Tecno Química Veyca, S.L. Tecnoquim, S.L.
Tecny Fluor (Materiales Tecny Fluor, S.L.)
Thermo Fisher Scientific SLU Tolquimex, S.L.
Trallero & Schlee, S.L.
Vertex Technics, S.L. Vidra Foc, S.A. Vidrio Industrial Pobel, S.A. VWR International Eurolab, S.L.
Medidores de partículas
Agilent Technologies Spain, S.L. Álava Ingenieros, S.A. Anorsa (Aparatos Normalizados, S.A.)
Beko Tecnológica, S.L. Biometa, S.A. Casella España, S.A. Chemlabor, S.L. Comercial Labor, S.A. Distrilab, S.L Equitrol, S.L. Esindus, S.A. Fisher Scientific Frances Micron España, S.A. Fritsch GmbH - Molienda y Medición Haver & Boecker Telas Metálicas Iberlab, S.L.
Instrumentos Físicos Ibérica, S.L. IUCT
Izasa Scientific J. Jimeno S.A.
Laborat, S.L.
Omadisa Industrias del Laboratorio, S.A. Quimivita, S.A. División Laboratorio
Representaciones Jürgen Appenrodt Retsch GmbH Rubilabor, S.L. Serviquimia, S.L.
Sistemas Electrónicos de Detección y Análisis, S.L. - SEDA Tecil
Tecno Química Veyca, S.L. Tiselab - Soluciones GMP para industrial Biofarmacéutica y afines Vertex Technics, S.L.
Vidra Foc, S.A.
VWR International Eurolab, S.L.
Mesas antivibratorias
Acefe, S.A. Anorsa (Aparatos Normalizados, S.A.) Asecos Seguridad y Protección del Medio Ambiente, S.L. Borda Laboratorios
Burdinola, S. Coop. Chemlabor, S.L. Comecta, S.A. - Grupo Selecta Dimanlab, S.L. Distrilab, S.L Fisher Scientific Flores Valles, S.A. Formimetal, S.L. Gram Precisión, S.L. Grupo Taper Iberlab, S.L. Iberlaser, S.A. IUCT
J. Jimeno S.A. Labolan, S.L. Lasing, S.A. Levantina de Laboratorios, S.L. Luis Frechilla, S.L. Metrotec, S.A. Miele - Centre Calvet Modulabo, S.L. Normalab, S.L. Olympus Iberia, S.A.U. Omadisa Industrias del Laboratorio, S.A. Quimivita, S.A. División Laboratorio Romero Muebles de Laboratorio, S.A. Rubilabor, S.L. Serviquimia, S.L. Tecnoquim, S.L.
Tolquimex, S.L.
Trallero & Schlee, S.L.
Vidra Foc, S.A.
VWR International Eurolab, S.L.
Micro-ultramicrotomía
Anorsa (Aparatos Normalizados, S.A.)
Carl Zeiss Iberia, S.L.
Distrilab, S.L
Fedelco, S.L. Fisher Scientific Iberlab, S.L.
Izasa Scientific J. Jimeno S.A. Leica Microsistemas, S.A. Microciencia, S.A.
Omadisa Industrias del Laboratorio, S.A. Quimivita, S.A. División Laboratorio Rubilabor, S.L. Vidra Foc, S.A.
Micropipetas automáticas
Acefe, S.A.
Agem, Auxiliar General de Electromedicina, S.A.
Análisis Vínicos, S.L.
Anorsa (Aparatos Normalizados, S.A.)
Assainissement Technique International, S.L. Auxilab, S.L.
Bercu Instruments, S.L. Bioser, S.A.
Chemlabor, S.L.
Comecta, S.A. - Grupo Selecta Comercial Labor, S.A. Comercial Rafer, S.L. Comercial Tecno, S.L.
Deltalab, S.L.U.
Distribuciones Científicas Sanitarias Distrilab, S.L
Ecogen, S.L. Eppendorf Ibérica, S.L.U. Fisher Scientific Grupo Taper
Hirschmann Laborgeräte GmbH & Co. KG
Iberlab, S.L.
IUCT
Izasa Scientific J. Jimeno S.A.
Labbox Labware, S.L. Laborat, S.L. Levantina de Laboratorios, S.L. Linealab,S.L.
Luis Frechilla, S.L. Lumaquin, S.A. Mettler-Toledo, S.A.E. Nirco, S.L. Normalab, S.L.
Omadisa Industrias del Laboratorio, S.A. Panreac Química, S.L.U. Quimivita, S.A. División Laboratorio Rubilabor, S.L. Socorex Isba, S.A. Serviquimia, S.L. Tecnoquim, S.L.
Thermo Fisher Scientific SLU Tolquimex, S.L. Trallero & Schlee, S.L.
Vertex Technics, S.L.
Vidra Foc, S.A.
VWR International Eurolab, S.L.
Microscopia óptica
Acefe, S.A.
Agilent Technologies Spain, S.L. Álava Ingenieros, S.A.
Anorsa (Aparatos Normalizados, S.A.)
Arcox
Auxilab, S.L.
Bercu Instruments, S.L. Biometa, S.A.
Carl Zeiss Iberia, S.L.
Chemlabor, S.L.
Comecta, S.A. - Grupo Selecta Comercial Labor, S.A. Comercial Tecno, S.L. Crysforma (Institut Català d’Investigació Química) Deltalab, S.L.U.
Distribuciones Científicas Sanitarias Distrilab, S.L Fedelco, S.L.
Fisher Scientific Grupo Taper Herter Instruments, S.L. Iberlab, S.L. Iberlaser, S.A.
IUCT
Izasa Scientific
J. Jimeno S.A. Labbox Labware, S.L. Labolan, S.L. Landes Poli Ibérica, S.L. Lasing, S.A. Leica Microsistemas, S.A. Levantina de Laboratorios, S.L.
Luis Frechilla, S.L.
M.A.D. Apparecchiature Scientifiche, Srl.M.A.D. IBERICA
Mab Industrial, S.L.U. Metrotec, S.A.
Microciencia, S.A.
Olympus Iberia, S.A.U.
Omadisa Industrias del Laboratorio, S.A.
Quimivita, S.A. División Laboratorio
Rubilabor, S.L.
Serviquimia, S.L.
Surcis, S.L.
Tecnoquim, S.L.
Tolquimex, S.L.
Vidra Foc, S.A.
VWR International Eurolab, S.L.
Mobiliario e instalaciones de laboratorio
Agem, Auxiliar General de Electromedicina, S.A.
AL Air Liquide España, S.A.
Anorsa (Aparatos Normalizados, S.A.)
Antonio Matachana, S.A.
Antonio Matachana, S.A. Div. Laboratorios
Arcamo Controls, S.A.
Asecos Seguridad y Protección del Medio Ambiente, S.L.
Bioser, S.A.
Borda Laboratorios
Burdinola, S. Coop.
CCI Control de Calidad Chemlabor, S.L.
Cruma Material de Laboratorio, S.A.
Deltalab, S.L.U.
Dimanlab, S.L.
Distrilab, S.L
Fisher Scientific Flores Valles, S.A. Formimetal, S.L.
Gaztelu Laboratorios Modulares
Gestión y Especificaciones Técnicas, S.L.
Hach Lange Spain, S.L.U.
Iberlab, S.L.
IUCT
Izasa Scientific J. Jimeno S.A.
Köttermann Systemlabor, S.A.
Labolan, S.L.
Laborat, S.L.
Labortech Waldner, S.L.
Levantina de Laboratorios, S.L.
Luis Frechilla, S.L.
Metrotec, S.A.
Miele - Centre Calvet
Modulabo, S.L.
Nippon Gases
Normalab, S.L.
Omadisa Industrias del Laboratorio, S.A.
Promolab - Mobiliario Técnico de Laboratorio, S.L.
Quilinox, S.L.
Quimipol J. Blanch Ferrer, S.L.
Quimivita, S.A. División Laboratorio
Rectus Tema, S.L.
Romero Muebles de Laboratorio, S.A.
Rubilabor, S.L.
Serviquimia, S.L.
Tecno Química Veyca, S.L.
Tecnología para Diagnóstico e Investigación (TDI, S.A.)
Tecnoquim, S.L.
Tecny Fluor (Materiales Tecny Fluor, S.L.)
Tolquimex, S.L.
Trallero & Schlee, S.L.
Vidra Foc, S.A.
VWR International Eurolab, S.L.
Molinos de laboratorio
Analab, S.A.
Biometa, S.A.
Comexglobal S.R.L.
Dinter-Dinko
Distrilab, S.L
Fritsch GmbH - Molienda y Medición
Levantina de Laboratorios, S.L.
Luis Frechilla, S.L.
Lumaquin, S.A.
Omadisa Industrias del Laboratorio, S.A.
Ortoalresa
Quimivita, S.A. División Laboratorio Retsch GmbH
Riera Nadeu, S.A.
Serviquimia, S.L.
Tema Maquinaria, S.A.
Trallero & Schlee, S.L.
Molturación
Acefe, S.A.
Anorsa (Aparatos Normalizados, S.A.)
Biometa, S.A.
Bioser, S.A.
Chemlabor, S.L.
CISA - Cedacería Industrial, S.L. Dinter-Dinko Distrilab, S.L
E. Bachiller B., S.A. Fedelco, S.L.
Fisher Scientific
Foss Electric España, S. Unipersonal Frances Micron España, S.A. Fritsch GmbH - Molienda y Medición Iberlab, S.L. Izasa Scientific J. Bonals, S.A. Lumaquin, S.A. Manema, S.A. Normalab, S.L. Quimivita, S.A. División Laboratorio Rubilabor, S.L. Serviquimia, S.L. Tema Maquinaria, S.A. Tolquimex, S.L.
Trallero & Schlee, S.L.
Vidra Foc, S.A.
pH-metros y conductivímetros Acefe, S.A. Agem, Auxiliar General de Electromedicina, S.A. Analab, S.A.
Análisis Vínicos, S.L.
Anisol Equipos, S.L.
Anorsa (Aparatos Normalizados, S.A.)
Arcamo Controls, S.A.
Assainissement Technique International, S.L.
Auxilab, S.L.
AxFlow, S.A.
Bentley Instruments
Bercu Instruments, S.L.
Bioser, S.A.
Bulcase, S.A.
Bürkert Contromatic, S.A.
Chemlabor, S.L.
Comercial Labor, S.A.
Comercial Rafer, S.L.
Comercial Tecno, S.L.
Crison Instruments, S.A. Dinter-Dinko
Distribuciones Científicas Sanitarias Distrilab, S.L
Electromediciones Kainos, S.A. Electrónica de Medida y Control, S.A.
Equitrol, S.L. Esindus, S.A. Fedelco, S.L.
Fisher Scientific Gomensoro, S.A. Grupo Taper Guemisa
Hach Lange Spain, S.L.U.
Hanna Instruments
Herter Instruments, S.L. Iberlab, S.L.
Instrumentación Analítica, S.A.
Instrumentos Testo, S.A. IUCT
Izasa Scientific J. Jimeno S.A.
J. P. Selecta, S.A.
Labbox Labware, S.L. Laborat, S.L. Labprocess Levantina de Laboratorios, S.L. Linealab,S.L.
Luis Frechilla, S.L. Lumaquin, S.A.
Maselli Ibérica Matelco, S.A.
Mathias, S.L. Metrotec, S.A.
Mettler-Toledo, S.A.E. Net Interlab, S.A.L. Normalab, S.L.
Omadisa Industrias del Laboratorio, S.A. Panreac Química, S.L.U. Quimivita, S.A. División Laboratorio Rubilabor, S.L. Serviquimia, S.L. Sugelabor, S.A. Surcis, S.L.
Tecno Química Veyca, S.L. Tecnoquim, S.L.
Thermo Fisher Scientific (Barcelona) Tiselab - Soluciones GMP para industrial Biofarmacéutica y afines Tolquimex, S.L.
Trallero & Schlee, S.L.
Vidra Foc, S.A.
Vidrio Industrial Pobel, S.A.
VWR International Eurolab, S.L.
Pipetas
Acefe, S.A.
Agem, Auxiliar General de Electromedicina, S.A. Anorsa (Aparatos Normalizados, S.A.) Aplicaciones Analíticas Doménech, S.L. Assainissement Technique International, S.L. Auxilab, S.L.
Bercu Instruments, S.L.
Bioser, S.A.
Chemlabor, S.L.
Comecta, S.A. - Grupo Selecta Comercial Labor, S.A.
Comercial Rafer, S.L.
Comercial Tecno, S.L.
Deltalab, S.L.U.
Distribuciones Científicas Sanitarias Distrilab, S.L Eppendorf Ibérica, S.L.U. Fedelco, S.L.
Fisher Scientific
Gilson International BV (sucursal España) Grupo Taper
Hach Lange Spain, S.L.U. Hirschmann Laborgeräte GmbH & Co. KG Iberlab, S.L. IUCT
Izasa Scientific J. Jimeno S.A. KGW-Isotherm
Labbox Labware, S.L. Laborat, S.L. Levantina de Laboratorios, S.L. Linealab,S.L.
Luis Frechilla, S.L. Lumaquin, S.A. Mathias, S.L.
Mettler-Toledo, S.A.E. Nirco, S.L. Normalab, S.L.
Omadisa Industrias del Laboratorio, S.A. Quimivita, S.A. División Laboratorio Rubilabor, S.L.
Sarstedt, S.A.U
Serviquimia, S.L.
Socorex Isba, S.A.
Tecno Química Veyca, S.L.
Tecnoquim, S.L.
Thermo Fisher Scientific SLU
Tolquimex, S.L.
Trallero & Schlee, S.L.
Vertex Technics, S.L.
Vidra Foc, S.A.
Vidrio Industrial Pobel, S.A.
VWR International Eurolab, S.L.
Porcelana de laboratorio
Acefe, S.A.
Agem, Auxiliar General de Electromedicina, S.A.
Anorsa (Aparatos Normalizados, S.A.)
Assainissement Technique International, S.L.
Auxilab, S.L.
Chemlabor, S.L.
Comecta, S.A. - Grupo Selecta Comercial Labor, S.A. Comercial Tecno, S.L.
Distribuciones Científicas Sanitarias Distrilab, S.L
Fisher Scientific Iberlab, S.L. J. Jimeno S.A.
Labbox Labware, S.L. Laborat, S.L. Levantina de Laboratorios, S.L. Linealab,S.L.
Luis Frechilla, S.L. Lumaquin, S.A. Normalab, S.L.
Omadisa Industrias del Laboratorio, S.A. Quimivita, S.A. División Laboratorio Rubilabor, S.L. Serviquimia, S.L. Tecnoquim, S.L. Tolquimex, S.L. Trallero & Schlee, S.L.
Vidra Foc, S.A.
VWR International Eurolab, S.L.
Porosímetros
Agem, Auxiliar General de Electromedicina, S.A. Anorsa (Aparatos Normalizados, S.A.)
Bonsai Advanced Technologies, S.L. Distrilab, S.L
Fisher Scientific
Iberlab, S.L. J. Jimeno S.A. Lumaquin, S.A. Metrotec, S.A. Quimivita, S.A. División Laboratorio Rubilabor, S.L. Serviquimia, S.L. Tecno Química Veyca, S.L. Tolquimex, S.L. Trallero & Schlee, S.L. Vidra Foc, S.A.
Productos para microbiología Acefe, S.A. AES Laboratorio, S.A. Agem, Auxiliar General de Electromedicina, S.A. Albet-Hahnemuehle, S.L.U Anorsa (Aparatos Normalizados, S.A.) Assainissement Technique International, S.L. Auxilab, S.L. BC Aplicaciones Analíticas, S.L. Bioser, S.A. Chemlabor, S.L. Comercial Labor, S.A. Comercial Tecno, S.L. Cosemar Ozono, S.L. Deltalab, S.L.U. Distribuciones Científicas Sanitarias Distrilab, S.L Fedelco, S.L.
Fine Science Tools GmbH (FST)
Fisher Scientific Productos para microbiología Foss Electric España, S. Unipersonal Gomensoro, S.A.
Hach Lange Spain, S.L.U. Iberlab, S.L. Iberlaser, S.A.
IUCT
Izasa Scientific J. Jimeno S.A. Labbox Labware, S.L. Laboratorios Microkit, S.L. Levantina de Laboratorios, S.L. Linealab,S.L. Luis Frechilla, S.L. Mathias, S.L. Millipore Ibérica, S.A. Nirco, S.L. Normalab, S.L. Omadisa Industrias del Laboratorio, S.A. Panreac Química, S.L.U. Quimivita, S.A. División Laboratorio Rubilabor, S.L. Sarstedt, S.A.U Serviquimia, S.L. Tecno Química Veyca, S.L. Tecnología para Diagnóstico e Investigación (TDI, S.A.)
Tecnoquim, S.L.
Tecny Fluor (Materiales Tecny Fluor, S.L.)
Tiselab - Soluciones GMP para industrial Biofarmacéutica y afines
Tolquimex, S.L.
Trallero & Schlee, S.L.
Vidra Foc, S.A.
VWR International Eurolab, S.L.
Psicrómetros
Analab, S.A. Anisol Equipos, S.L. Anorsa (Aparatos Normalizados, S.A.)
Auxilab, S.L.
Bercu Instruments, S.L. Bulcase, S.A.
CCI Control de Calidad
Comercial Tecno, S.L. Distrilab, S.L
Fisher Scientific Guemisa
Herter Instruments, S.L.
Hidrolab, S.L.
Iberlab, S.L.
J. Jimeno S.A.
Levantina de Laboratorios, S.L.
Luis Frechilla, S.L.
Metrotec, S.A.
Omadisa Industrias del Laboratorio, S.A. Quimivita, S.A. División Laboratorio Rubilabor, S.L.
Sistemas Electrónicos de Detección y Análisis, S.L. - SEDA Tecnoquim, S.L. Tolquimex, S.L.
Vidra Foc, S.A.
Punto de fusión
Acefe, S.A.
Análisis Vínicos, S.L.
Anorsa (Aparatos Normalizados, S.A.)
Bercu Instruments, S.L. Chemlabor, S.L.
Comecta, S.A. - Grupo Selecta Comercial Tecno, S.L. Distrilab, S.L
Fisher Scientific Iberlab, S.L.
IUCT
J. Jimeno S.A.
Lasing, S.A.
Levantina de Laboratorios, S.L.
Luis Frechilla, S.L.
Lumaquin, S.A.
Mettler-Toledo, S.A.E.
Metrotec, S.A.
Net Interlab, S.A.L.
Omadisa Industrias del Laboratorio, S.A. Quimivita, S.A. División Laboratorio Rubilabor, S.L.
Serviquimia, S.L. Tecnoquim, S.L. Tolquimex, S.L. Trallero & Schlee, S.L.
Vidra Foc, S.A.
VWR International Eurolab, S.L. Waters Cromatografía, S.A.
Racores
Arcamo Controls, S.A. Distrilab, S.L
Quilinox, S.L.
Trallero & Schlee, S.L.
Reactivos AES Laboratorio, S.A.
Agem, Auxiliar General de Electromedicina, S.A. Agilent Technologies Spain, S.L. Análisis Vínicos, S.L. Anorsa (Aparatos Normalizados, S.A.) Aplicaciones Analíticas Doménech, S.L. Assainissement Technique International, S.L. Chemlabor, S.L. Comercial Rafer, S.L. Deltalab, S.L.U. Dinter-Dinko Distribuciones Científicas Sanitarias Distrilab, S.L Ecogen, S.L. Fedelco, S.L. Fisher Scientific Grupo Taper Hach Lange Spain, S.L.U. Hanna Instruments Iberlab, S.L. IUCT
Izasa Scientific J. Jimeno S.A. Labbox Labware, S.L. Laborat, S.L. Laboratorios Microkit, S.L. Levantina de Laboratorios, S.L
Luis Frechilla, S.L.
Nirco, S.L. Normalab, S.L.
Omadisa Industrias del Laboratorio, S.A. Panreac Química, S.L.U. Quimivita, S.A. División Laboratorio Rubilabor, S.L. Serviquimia, S.L.
Symta, S.L.L.
Tecno Química Veyca, S.L. Tecnoquim, S.L. Tolquimex, S.L.
Trallero & Schlee, S.L. Vidra Foc, S.A.
VWR International Eurolab, S.L.
Registradores oscilográficos y potenciométricos
Anorsa (Aparatos Normalizados, S.A.)
Aplein Ingenieros, S.A.
Bulcase, S.A.
Distrilab, S.L
Electromediciones Kainos, S.A.
Electrónica de Medida y Control, S.A.
Equitrol, S.L.
Esindus, S.A.
Fisher Scientific Guemisa
Iberlab, S.L.
Instrumatic Española, S.A.
J. Jimeno S.A.
Lumaquin, S.A.
Metrofísica, S.L.
Quimivita, S.A. División Laboratorio Rubilabor, S.L.
Serviquimia, S.L.
Tiselab - Soluciones GMP
para industrial Biofarmacéutica y afines
Vidra Foc, S.A.
Reguladores de humedad
Analab, S.A.
Anisol Equipos, S.L.
Anorsa (Aparatos Normalizados, S.A.)
Arcamo Controls, S.A.
Arcox
Bulcase, S.A.
CCI Control de Calidad Chemlabor, S.L.
Distrilab, S.L
Electrónica de Medida y Control, S.A.
Entesis Technology, S.L.
Equitrol, S.L.
Fisher Scientific Guemisa
Hanseata, S.A.
Herter Instruments, S.L. Humysec - 2000, S.L. Iberlab, S.L.
Ineltec, S.L.
Ingeniería de Climas para Procesos, S.L. Instrumentos Testo, S.A.
J. Jimeno S.A. Kern & Sohn GmbH Labprocess Levantina de Laboratorios, S.L.
Luis Frechilla, S.L.
Lumaquin, S.A.
Luwa Española, S.A. Mathias, S.L. Metrofísica, S.L.
Omadisa Industrias del Laboratorio, S.A.
Quimivita, S.A. División Laboratorio
Rubilabor, S.L.
Serviquimia, S.L.
Tecno Química Veyca, S.L. Tolquimex, S.L.
Trallero & Schlee, S.L.
Vidra Foc, S.A.
VWR International Eurolab, S.L.
Sensores de gases
Álava Ingenieros, S.A. Analab, S.A. Anisol Equipos, S.L. Anorsa (Aparatos Normalizados, S.A.) Bulcase, S.A. Bürkert Contromatic, S.A. Casella España, S.A. CCI Control de Calidad Chemlabor, S.L. Cosemar Ozono, S.L. Distribuciones Científicas Sanitarias Distrilab, S.L Entesis Technology, S.L. Equipamiento Científico Equitrol, S.L. Esindus, S.A. Fisher Scientific Guemisa Hidrolab, S.L. Iberfluid Instruments, S.A. Iberlab, S.L. Instrumentación Analítica, S.A. Instrumentos Testo, S.A. J. Jimeno S.A. Lana Sarrate, S.A. Luis Frechilla, S.L. Matelco, S.A. Mettler-Toledo, S.A.E. Omadisa Industrias del Laboratorio, S.A. Rubilabor, S.L. Sensotran, S.L. Serviquimia, S.L. Sistemas Electrónicos de Detección y Análisis, S.L. - SEDA Tecno Química Veyca, S.L. Tecnoquim, S.L. Tecop, S.A. Thermo Fisher Scientific (Barcelona) Tolquimex, S.L. Trallero & Schlee, S.L. Trox España, S.A. Vertex Technics, S.L. Vidra Foc, S.A. VWR International Eurolab, S.L.
Sintetizadores de DNA y proteínas Agilent Technologies Spain, S.L. Anorsa (Aparatos Normalizados, S.A.) Bentley Instruments Chemlabor, S.L. Distribuciones Científicas Sanitarias Distrilab, S.L Fisher Scientific Iberlab, S.L. Izasa Scientific Trallero & Schlee, S.L. Vidra Foc, S.A. VWR International Eurolab, S.L.
Sistemas de captación y tratamiento de muestras ambientales Acefe, S.A. Álava Ingenieros, S.A. Analab, S.A. Análisis Vínicos, S.L. Anisol Equipos, S.L. Anorsa (Aparatos Normalizados, S.A.) Assainissement Technique International, S.L. Bulcase, S.A. Casella España, S.A. Chemlabor, S.L. Cosemar Ozono, S.L. Dinter-Dinko Distrilab, S.L Esindus, S.A. Fisher Scientific Gomensoro, S.A. Iberlab, S.L. J. Jimeno S.A.
Luis Frechilla, S.L.
Omadisa Industrias del Laboratorio, S.A.
Quimivita, S.A. División Laboratorio Rubilabor, S.L. Serviquimia, S.L.
Sistemas Electrónicos de Detección y Análisis, S.L. - SEDA Surcis, S.L.
Tecnium - Casals Cardona Industrial, S.A. Tecop, S.A. Tolquimex, S.L. Vidra Foc, S.A.
Tamizado
Acefe, S.A.
Agem, Auxiliar General de Electromedicina, S.A. Analab, S.A.
Anorsa (Aparatos Normalizados, S.A.) Auquime, S.A. Biometa, S.A.
CCI Control de Calidad Chemlabor, S.L.
CISA - Cedacería Industrial, S.L. Comercial Tecno, S.L. Distrilab, S.L Fedelco, S.L.
Filtra Vibración, S.L.
Fisher Scientific Frances Micron España, S.A. Fritsch GmbH - Molienda y Medición Gomensoro, S.A.
Haver & Boecker Telas Metálicas Iberlab, S.L.
IUCT
Izasa Scientific J. Jimeno S.A.
Laborat, S.L. Levantina de Laboratorios, S.L. Luis Frechilla, S.L. Lumaquin, S.A. Metrotec, S.A. Mettler-Toledo, S.A.E. Normalab, S.L.
Omadisa Industrias del Laboratorio, S.A. Ortoalresa Quimivita, S.A. División Laboratorio Retsch GmbH Rubilabor, S.L. Serviquimia, S.L. Tecno Química Veyca, S.L. Tecnoquim, S.L. Tema Maquinaria, S.A. Tolquimex, S.L. Trallero & Schlee, S.L. Vidra Foc, S.A.
VWR International Eurolab, S.L.
Tanques criogénicos
Abelló Linde, S.A.
Agem, Auxiliar General de Electromedicina, S.A. AL Air Liquide España, S.A. Anorsa (Aparatos Normalizados, S.A.) Carburos Metálicos, S.A. - Grupo Air Products CCI Control de Calidad Chemlabor, S.L.
Distrilab, S.L Fisher Scientific
Grupo Taper
Iberlab, S.L.
Izasa Scientific
J. Jimeno S.A.
Nippon Gases
Nirco, S.L.
Quilinox, S.L.
Quimivita, S.A. División Laboratorio Rubilabor, S.L.
Serviquimia, S.L.
Telstar Technologies, S.L.
Trallero & Schlee, S.L.
Vidra Foc, S.A.
VWR International Eurolab, S.L.
Termómetros
Acefe, S.A.
AES Laboratorio, S.A.
Agem, Auxiliar General de Electromedicina, S.A. Álava Ingenieros, S.A.
Analab, S.A.
Análisis Vínicos, S.L.
Anorsa (Aparatos Normalizados, S.A.)
Arcamo Controls, S.A.
Assainissement Technique International, S.L. Auxilab, S.L.
Bercu Instruments, S.L. Bulcase, S.A.
Casella España, S.A.
CCI Control de Calidad Chemlabor, S.L.
Comecta, S.A. - Grupo Selecta Comercial Labor, S.A. Comercial Tecno, S.L.
Crison Instruments, S.A. Dinter-Dinko
Distribuciones Científicas Sanitarias
Distrilab, S.L
Electromediciones Kainos, S.A.
Electrónica de Medida y Control, S.A.
Equitrol, S.L. Fedelco, S.L.
Fisher Scientific Guemisa
Hanna Instruments
Herter Instruments, S.L. Iberlab, S.L.
Instrumentos Testo, S.A. Instrumentos Wika, S.A.
IUCT
Izasa Scientific
J. Jimeno S.A.
J. P. Selecta, S.A.
Kern Frío, S.L.
Labbox Labware, S.L. Laborat, S.L.
Labprocess
Lana Sarrate, S.A.
Levantina de Laboratorios, S.L.
Linealab,S.L.
Luis Frechilla, S.L.
Lumaquin, S.A.
Mathias, S.L. Metrofísica, S.L. Metrotec, S.A.
Net Interlab, S.A.L.
Nirco, S.L. Normalab, S.L.
Omadisa Industrias del Laboratorio, S.A. Protón
Quilinox, S.L. Quimivita, S.A. División Laboratorio Rubilabor, S.L.
Servibombas, S.L.
Serviquimia, S.L.
Sistemas Electrónicos de Detección y Análisis, S.L. - SEDA
Tecno Química Veyca, S.L.
Tecnoquim, S.L.
Tiselab - Soluciones GMP para industrial Biofarmacéutica y afines
Tolquimex, S.L.
Trallero & Schlee, S.L.
Vidra Foc, S.A.
Vidrio Industrial Pobel, S.A.
VWR International Eurolab, S.L.
Termostatos
Acefe, S.A.
Arcamo Controls, S.A.
Assainissement Technique International, S.L.
Bercu Instruments, S.L.
CCI Control de Calidad
Dinter-Dinko
Distrilab, S.L
Entesis Technology, S.L.
Huber
Julabo GmbH
LAUDA DR. R. WOBSER GMBH & CO. KG
Levantina de Laboratorios, S.L.
Luis Frechilla, S.L.
Omadisa Industrias del Laboratorio, S.A.
Quilinox, S.L.
Science Basic Solutions, S.L. - SBS, S.L. Serviquimia, S.L. Tecnoquim, S.L.
Trallero & Schlee, S.L.
Transductores
Álava Ingenieros, S.A.
Anorsa (Aparatos Normalizados, S.A.)
Aplein Ingenieros, S.A.
Bacsa
Bulcase, S.A.
Bürkert Contromatic, S.A.
Distrilab, S.L
Electromediciones Kainos, S.A.
Electrónica de Medida y Control, S.A. Entesis Technology, S.L. Equitrol, S.L. Esindus, S.A.
Fisher Scientific Gram Precisión, S.L.
Guemisa
Hidrolab, S.L. Iberfluid Instruments, S.A. Iberlab, S.L. Instrumentos Testo, S.A. Instrumentos Wika, S.A.
J. Jimeno S.A.
Lana Sarrate, S.A.
Linealab,S.L. Luis Frechilla, S.L. Mathias, S.L. Metrofísica, S.L.
Omadisa Industrias del Laboratorio, S.A. Rubilabor, S.L.
Sistemas y Tecnología Ribas, S.L. - SISTEC Tecno Química Veyca, S.L. Tiselab - Soluciones GMP para industrial Biofarmacéutica y afines Trox España, S.A. Vidra Foc, S.A. VWR International Eurolab, S.L.
Tratamientos acústicos
Casella España, S.A. CCI Control de Calidad Distrilab, S.L Iberlab, S.L. J. Jimeno S.A. Rubilabor, S.L. Serviquimia, S.L. Trox España, S.A. Vertex Technics, S.L. Vidra Foc, S.A.
Trituración
Acefe, S.A. Analab, S.A. Anorsa (Aparatos Normalizados, S.A.) Biometa, S.A. Chemlabor, S.L. CMBE-Cial. Maquinaria y Bienes de Equipo, S.L. Comecta, S.A. - Grupo Selecta Comercial Rafer, S.L. Comercial Tecno, S.L. Dinter-Dinko Distribuciones Científicas Sanitarias Distrilab, S.L E. Bachiller B., S.A. Fedelco, S.L. Filtra Vibración, S.L.
Fisher Scientific Foss Electric España, S. Unipersonal
Frances Micron España, S.A. Fritsch GmbH - Molienda y Medición Gomensoro, S.A.
Iberlab, S.L.
Izasa Scientific J. Bonals, S.A.
J. Jimeno S.A. Laborat, S.L. Levantina de Laboratorios, S.L. Linealab,S.L. Luis Frechilla, S.L. Lumaquin, S.A. Manema, S.A.
Normalab, S.L.
Omadisa Industrias del Laboratorio, S.A. Quimivita, S.A. División Laboratorio Retsch GmbH
Serviquimia, S.L. Tecnoquim, S.L.
Tema Maquinaria, S.A. Tolquimex, S.L.
Trallero & Schlee, S.L.
Vidra Foc, S.A.
VWR International Eurolab, S.L.
Válvulas
Arcamo Controls, S.A. Knauer Wissenschaftliche Geräte GmbH Quilinox, S.L.
Symta, S.L.L.
Tiselab - Soluciones GMP para industrial Biofarmacéutica y afines Trallero & Schlee, S.L.
Vamein de España, S.A.
Vidrio para laboratorio
Acefe, S.A.
Agem, Auxiliar General de Electromedicina, S.A. Álava Ingenieros, S.A.
Anorsa (Aparatos Normalizados, S.A.) Assainissement Technique International, S.L. Auxilab, S.L. CCI Control de Calidad Chemlabor, S.L. Comercial Labor, S.A. Comercial Rafer, S.L. Comercial Tecno, S.L. Deltalab, S.L.U.
Distribuciones Científicas Sanitarias Distrilab, S.L Fisher Scientific Flores Valles, S.A.
Hirschmann Laborgeräte GmbH & Co. KG
Iberlab, S.L.
IUCT
J. Jimeno S.A.
Labbox Labware, S.L. Laborat, S.L. Levantina de Laboratorios, S.L. Linealab,S.L. Luis Frechilla, S.L. Lumaquin, S.A. Normalab, S.L.
Omadisa Industrias del Laboratorio, S.A. Protón Quimivita, S.A. División Laboratorio Rubilabor, S.L. Serviquimia, S.L.
Tecno Química Veyca, S.L. Tecnoquim, S.L.
Tolquimex, S.L.
Trallero & Schlee, S.L.
Vidra Foc, S.A.
Vidrio Industrial Pobel, S.A.
VWR International Eurolab, S.L.
Vitrinas de gases
Agem, Auxiliar General de Electromedicina, S.A.
Anorsa (Aparatos Normalizados, S.A.)
Asecos Seguridad y Protección del Medio Ambiente, S.L.
Bercu Instruments, S.L.
Borda Laboratorios
Burdinola, S. Coop.
CCI Control de Calidad Chemlabor, S.L.
Comercial Rafer, S.L. Comercial Tecno, S.L.
Cruma Material de Laboratorio, S.A. Dimanlab, S.L.
Distribuciones Científicas Sanitarias
Distrilab, S.L
Erlab, S.L.
Fisher Scientific Flores Valles, S.A. Formimetal, S.L.
Gaztelu Laboratorios Modulares
Gestión y Especificaciones Técnicas, S.L.
Iberlab, S.L.
IUCT
Izasa Scientific J. Jimeno S.A.
Köttermann Systemlabor, S.A.
Labolan, S.L.
Laborat, S.L.
Labortech Waldner, S.L.
Levantina de Laboratorios, S.L.
Luis Frechilla, S.L.
Miele - Centre Calvet
Modulabo, S.L.
Nirco, S.L.
Normalab, S.L.
Omadisa Industrias del Laboratorio, S.A.
Promolab - Mobiliario Técnico de Laboratorio, S.L.
Quimipol J. Blanch Ferrer, S.L.
Quimivita, S.A. División Laboratorio
Romero Muebles de Laboratorio, S.A.
Rubilabor, S.L.
Serviquimia, S.L.
Tecnología para Diagnóstico e Investigación (TDI, S.A.)
Tecnoquim, S.L.
Tolquimex, S.L.
Trallero & Schlee, S.L.
Vidra Foc, S.A.
VWR International Eurolab, S.L.
Otros
A&B Laboratorios de Biotecnología, S.A. AES Laboratorio, S.A.
Agem, Auxiliar General de Electromedicina, S.A.
Agilent Technologies Spain, S.L.
Albet-Hahnemuehle, S.L.U
Analab, S.A.
Aningas, S.A.
Anorsa (Aparatos Normalizados, S.A.)
Aqua-Consult Ingenieros, S.L.
Arcamo Controls, S.A.
Arcox
Auxilab, S.L.
Bacsa
Beko Tecnológica, S.L.
Bioser, S.A.
Bombas Grundfos España, S.A.
Borda Laboratorios
Bulcase, S.A.
Bürkert Contromatic, S.A.
Camag (Switzerland)
Carl Zeiss Iberia, S.L. Casella España, S.A.
CCI Control de Calidad
Comercial Labor, S.A.
Comercial Tecno, S.L.
Cosemar Ozono, S.L.
Crison Instruments, S.A. Deltalab, S.L.U. Dimanlab, S.L. Dinter-Dinko
Distribuciones Científicas Sanitarias
Distrilab, S.L
Dycometal, Equipos de C.C., S.L. Elga Labwater (Grupo Veolia Water Technologies) Entorn, S.A. - Enginyeria i Serveis Eppendorf Ibérica, S.L.U. Equirepsa
Erlab, S.L. Esindus, S.A. Filtros Ceta, S.L.U. Fisher Scientific Fine Science Tools GmbH (FST) Formimetal, S.L. Frances Micron España, S.A. Gaztelu Laboratorios Modulares Hach Lange Spain, S.L.U. Hanna Instruments
Hanseata, S.A. Hellma Hispania, S.L. Iberfluid Instruments, S.A. Iberlab, S.L.
Ielab Calidad, S.L.
IKA-Werke GmbH & Co.Kg
Ineltec, S.L.
Ingeniería de Climas para Procesos, S.L. Instron a Divison of ITW Limited Instrumentos Físicos Ibérica, S.L. Instrumentos Wika, S.A.
Izasa Scientific J. Bonals, S.A. JHRoerden y Cía, S.A. Knauer Wissenschaftliche Geräte GmbH Labbox Labware, S.L. Laborat, S.L. Laboratorios Microkit, S.L. Landes Poli Ibérica, S.L. LGC Standards, S.L.U. Lidering, S.A.U. Lumaquin, S.A. Luwa Española, S.A. Manema, S.A. Maquinsa (Materiales Técnicos Maquinsa, S.L.) Matelco, S.A. Mathias, S.L. Metrofísica, S.L. Metrotec, S.A. Mettler-Toledo, S.A.E. Modulabo, S.L. Nippon Gases Normalab, S.L. Omadisa Industrias del Laboratorio, S.A. Ovan Equipos Laboratorio (Suministros Grupo Esper S.L) Pesos M.B.M., S.L. Polyco Iberial, S.L. Quimivita, S.A. División Laboratorio R-Biopharm España, S.A.U R. Espinar S.L. Rectus Tema, S.L. Rubilabor, S.L. Sartorius Stedim Spain, S.A.U. Servibombas, S.L. Serviquimia, S.L. Sistemas Electrónicos de Detección y Análisis, S.L. - SEDA Surcis, S.L. Tecil
Tecno Química Veyca, S.L. Tecop, S.A. Tiselab - Soluciones GMP para industrial Biofarmacéutica y afines Titan Eko, S.L. Sucursal en España Trallero & Schlee, S.L.
Trox España, S.A.
Vertex Technics, S.L.
Vidra Foc, S.A.
VWR International Eurolab, S.L. Watlow Iberica SLU
Análisis de imagen Acefe, S.A.
Álava Ingenieros, S.A. Analab, S.A. Biometa, S.A. Bulcase, S.A.
Carl Zeiss Iberia, S.L. Chemlabor, S.L. Distrilab, S.L Ecogen, S.L. Esindus, S.A.
Expert System Solutions S.R.L. Fisher Scientific Fritsch GmbH - Molienda y Medición Grupo Taper Iberlaser, S.A.
Instrumatic Española, S.A. Instrumentos Testo, S.A.
Izasa Scientific
J. Jimeno S.A.
Leco Instrumentos, S.L.Leica Microsistemas, S.A. Microciencia, S.A.
National Instruments Spain Olympus Iberia, S.A.U. PerkinElmer España, S.L.
Quimivita, S.A. División Laboratorio Rubilabor, S.L. Tecil
Vidra Foc, S.A.
VWR International Eurolab, S.L.
Análisis de proteína (nitrógeno)
Anisol Equipos, S.L.
Anorsa (Aparatos Normalizados, S.A.) Chemlabor, S.L.
Dinter-Dinko
Distrilab, S.L
Fisher Scientific Foss Electric España, S. Unipersonal Gomensoro, S.A. Iberlab, S.L. Instrumentación Analítica, S.A. J. Jimeno S.A. J. P. Selecta, S.A. Knauer Wissenschaftliche Geräte GmbH Labolan, S.L. Laborat, S.L. Leco Instrumentos, S.L. PerkinElmer España, S.L. Quimivita, S.A. División Laboratorio R. Espinar S.L. Rubilabor, S.L. Tecnoquim, S.L. Tolquimex, S.L.
Vidra Foc, S.A.
VWR International Eurolab, S.L.
Automatización del laboratorio
AES Laboratorio, S.A. Agilent Technologies Spain, S.L. Álava Ingenieros, S.A. Anorsa (Aparatos Normalizados, S.A.)
Aplicaciones Analíticas Doménech, S.L. Arcamo Controls, S.A. AxFlow, S.A.
BC Aplicaciones Analíticas, S.L. Bentley Instruments Bulcase, S.A.
Bürkert Contromatic, S.A.
Carl Zeiss Iberia, S.L.
CCI Control de Calidad
Comercial Rafer, S.L.
David Spuch Calvar Distribuciones Científicas Sanitarias Distrilab, S.L
Elga Labwater (Grupo Veolia Water Technologies) Eppendorf Ibérica, S.L.U.
Fisher Scientific
Foss Electric España, S. Unipersonal Gilson International BV (sucursal España) Gomensoro, S.A.
Guemisa
Hach Lange Spain, S.L.U.
Iberfluid Instruments, S.A. Iberlab, S.L.
Instrumentación Analítica, S.A.
Izasa Scientific
J. Jimeno S.A.
Knauer Wissenschaftliche Geräte GmbH
Labolan, S.L.
Matelco, S.A.
National Instruments Spain
Quimivita, S.A. División Laboratorio
Rubilabor, S.L.
Sarstedt, S.A.U
Serviquimia, S.L.
Spectro Hispania, S.L.
Swag, S.L. Software para el Laboratorio
Tecan Ibérica Instrumentación, S.L.
Tecil
Tecnoquim, S.L.
Tecny Fluor (Materiales Tecny Fluor, S.L.)
Thermo Fisher Scientific SLU
Vertex Technics, S.L.
Vidra Foc, S.A.
Watlow Iberica SLU
Zwick Ibérica Equipos de Ensayos, S.L.
Biología nuclear y celular
Acefe, S.A.
Anisol Equipos, S.L.
Anorsa (Aparatos Normalizados, S.A.)
Carl Zeiss Iberia, S.L.
Chemlabor, S.L.
Comercial Rafer, S.L.
Distribuciones Científicas Sanitarias Distrilab, S.L
Ecogen, S.L.
Elga Labwater (Grupo Veolia Water Technologies)
Fedelco, S.L.
Fisher Scientific Fine Science Tools GmbH (FST)
Iberlab, S.L.
Iberlaser, S.A.
Ielab Calidad, S.L.
Izasa Scientific
J. Jimeno S.A.
Labolan, S.L.
Nirco, S.L.
Quimivita, S.A. División Laboratorio
Rubilabor, S.L.
Tecny Fluor (Materiales Tecny Fluor, S.L.)
Thermo Fisher Scientific SLU
Vertex Technics, S.L.
Vidra Foc, S.A.
VWR International Eurolab, S.L.
Bioluminiscencia
Acefe, S.A.
Anisol Equipos, S.L.
BC Aplicaciones Analíticas, S.L.
Bioser, S.A.
Camag (Switzerland)
Carl Zeiss Iberia, S.L. Distrilab, S.L
Gomensoro, S.A.
Iberlab, S.L.
Iberlaser, S.A.
Izasa Scientific J. Jimeno S.A.
Lasing, S.A. Millipore Ibérica, S.A. Quimivita, S.A. División Laboratorio
Thermo Fisher Scientific (Barcelona)
VWR International Eurolab, S.L.
Calorimetría
Anorsa (Aparatos Normalizados, S.A.)
Biometa, S.A.
Bonsai Advanced Technologies, S.L. Chemlabor, S.L.
Crysforma (Institut Català d’Investigació Química) Distrilab, S.L Fisher Scientific Gomensoro, S.A. Iberlab, S.L. IKA-Werke GmbH & Co.Kg Instrumentos Físicos Ibérica, S.L. Izasa Scientific J. Jimeno S.A. Leco Instrumentos, S.L. LGC Standards, S.L.U. Linealab,S.L. Lumaquin, S.A. PerkinElmer España, S.L. Quimivita, S.A. División Laboratorio Rubilabor, S.L. Serviquimia, S.L. Sugelabor, S.A. Tecnoquim, S.L. Tecny Fluor (Materiales Tecny Fluor, S.L.) Tolquimex, S.L. Vidra Foc, S.A. VWR International Eurolab, S.L. Waters Cromatografía, S.A.
Centrifugación
Acefe, S.A. Agem, Auxiliar General de Electromedicina, S.A. Anisol Equipos, S.L. Anorsa (Aparatos Normalizados, S.A.) Auxilab, S.L. Bercu Instruments, S.L. Chemlabor, S.L. Comecta, S.A. - Grupo Selecta Comercial Labor, S.A. Comercial Rafer, S.L. Distribuciones Científicas Sanitarias
Distrilab, S.L Eppendorf Ibérica, S.L.U. Fisher Scientific Grupo Taper Iberlab, S.L. Ingeniería de Climas para Procesos, S.L. Instrumentación Analítica, S.A.
IUCT
Izasa Scientific J. Jimeno S.A. J. P. Selecta, S.A. Labolan, S.L. Levantina de Laboratorios, S.L. Luis Frechilla, S.L. Lumaquin, S.A. MIL, S.L. Nirco, S.L. Ortoalresa Quimivita, S.A. División Laboratorio Riera Nadeu, S.A. Rubilabor, S.L. Sarstedt, S.A.U Sartorius Stedim Spain, S.A.U. Serviquimia, S.L. Tecnoquim, S.L. Tecny Fluor (Materiales Tecny Fluor, S.L.)
Tema Maquinaria, S.A.
Thermo Fisher Scientific SLU Tolquimex, S.L. Trallero & Schlee, S.L. Vidra Foc, S.A. VWR International Eurolab, S.L.
Corrosión
Acefe, S.A.
Álava Ingenieros, S.A.
Anorsa (Aparatos Normalizados, S.A.)
Bonsai Advanced Technologies, S.L. CCI Control de Calidad Fisher Scientific Gomensoro, S.A.
Hanseata, S.A.
Iberlab, S.L.
Ineltec, S.L.
Instrumatic Española, S.A. Instrumentación Analítica, S.A. Lumaquin, S.A.
Metrotec, S.A.
Quimivita, S.A. División Laboratorio Tecny Fluor (Materiales Tecny Fluor, S.L.)
Trallero & Schlee, S.L.
Vidra Foc, S.A.
Waters Cromatografía, S.A.
Criogenia
Acefe, S.A.
AL Air Liquide España, S.A.
Anorsa (Aparatos Normalizados, S.A.) Arcamo Controls, S.A.
Carburos Metálicos, S.A. - Grupo Air Products CCI Control de Calidad
Chemlabor, S.L.
Distribuciones Científicas Sanitarias Distrilab, S.L
Fisher Scientific Grupo Taper Iberlab, S.L.
Instrumatic Española, S.A.
Izasa Scientific J. Jimeno S.A.
Laborat, S.L.
Laboratorios Microkit, S.L. Leica Microsistemas, S.A. Linealab,S.L.
Lumaquin, S.A.
Nippon Gases
Nirco, S.L.
Quimivita, S.A. División Laboratorio Rubilabor, S.L. Sarstedt, S.A.U
Serviquimia, S.L.
Tecny Fluor (Materiales Tecny Fluor, S.L.)
Telstar Technologies, S.L.
Trallero & Schlee, S.L. Vidra Foc, S.A.
VWR International Eurolab, S.L.
Desmineralización
Agem, Auxiliar General de Electromedicina, S.A. Anorsa (Aparatos Normalizados, S.A.)
Aplicaciones Analíticas Doménech, S.L. CCI Control de Calidad Chemlabor, S.L.
CMBE-Cial. Maquinaria y Bienes de Equipo, S.L. Comecta, S.A. - Grupo Selecta Distrilab, S.L
Elga Labwater (Grupo Veolia Water Technologies)
Fisher Scientific Gomensoro, S.A.
Iberlab, S.L.
J. Jimeno S.A. Labolan, S.L.
Levantina de Laboratorios, S.L.
Luis Frechilla, S.L.
Quimivita, S.A. División Laboratorio Rubilabor, S.L.
Tecny Fluor (Materiales Tecny Fluor, S.L.)
Thermo Fisher Scientific SLU Tolquimex, S.L.
Veolia Labwater España Vidra Foc, S.A.
Vrep, S.A.
VWR International Eurolab, S.L.
Destilación camino corto
Anorsa (Aparatos Normalizados, S.A.)
Auxilab, S.L.
Chemlabor, S.L.
CMBE-Cial. Maquinaria y Bienes de Equipo, S.L. Distrilab, S.L
Fisher Scientific Iberlab, S.L.
J. Jimeno S.A.
Luis Frechilla, S.L.
Quimivita, S.A. División Laboratorio
Riera Nadeu, S.A.
Rubilabor, S.L.
Trallero & Schlee, S.L.
Vidra Foc, S.A.
Destilación fraccionada
Anorsa (Aparatos Normalizados, S.A.)
Auxilab, S.L.
Chemlabor, S.L.
CMBE-Cial. Maquinaria y Bienes de Equipo, S.L.
Distrilab, S.L
Esindus, S.A.
Fisher Scientific Iberlab, S.L. IUCT
Izasa Scientific J. Jimeno S.A.
Luis Frechilla, S.L.
Quimivita, S.A. División Laboratorio
Rubilabor, S.L.
Science Basic Solutions, S.L. - SBS, S.L.
Telstar Technologies, S.L.
Trallero & Schlee, S.L.
Vidra Foc, S.A.
Electroforesis
Acefe, S.A.
Agilent Technologies Spain, S.L.
Análisis Vínicos, S.L.
Anorsa (Aparatos Normalizados, S.A.)
Aplicaciones Analíticas Doménech, S.L.
Auxilab, S.L.
Bercu Instruments, S.L. Biometa, S.A.
Chemlabor, S.L.
Comercial Rafer, S.L.
Distribuciones Científicas Sanitarias
Distrilab, S.L
Ecogen, S.L.
Fisher Scientific Grupo Taper Iberlab, S.L. IUCT
Izasa Scientific J. Jimeno S.A.
Labolan, S.L. Levantina de Laboratorios, S.L.
Luis Frechilla, S.L.
Net Interlab, S.A.L. Nirco, S.L.
Panreac Química, S.L.U.
Quimivita, S.A. División Laboratorio
Rubilabor, S.L.
Science Basic Solutions, S.L. - SBS, S.L. Sugelabor, S.A.
Thermo Fisher Scientific SLU
Tolquimex, S.L.
Trallero & Schlee, S.L.
Vidra Foc, S.A.
VWR International Eurolab, S.L.
Espectrómetro campo visual
Análisis Vínicos, S.L.
Anorsa (Aparatos Normalizados, S.A.)
Chemlabor, S.L.
Comercial Labor, S.A.
Comercial Rafer, S.L. Dinter-Dinko Distribuciones Científicas Sanitarias
Distrilab, S.L Fisher Scientific Gomensoro, S.A.
Hach Lange Spain, S.L.U.
Hanna Instruments Iberlab, S.L. Iberlaser, S.A. Instrumentación Analítica, S.A. IUCT
Izasa Scientific Laborat, S.L. Levantina de Laboratorios, S.L. Mettler-Toledo, S.A.E. Rubilabor, S.L. Serviquimia, S.L. Tecan Ibérica Instrumentación, S.L.
Vidra Foc, S.A.
VWR International Eurolab, S.L.
Fermentación
Análisis y Filtración, S.L.
Anisol Equipos, S.L. Anorsa (Aparatos Normalizados, S.A.) Chemlabor, S.L. Distribuciones Científicas Sanitarias
Distrilab, S.L E. Bachiller B., S.A. Ecogen, S.L.
Fisher Scientific Gomensoro, S.A.
Grupo Taper Iberfluid Instruments, S.A. Iberlab, S.L.
IUCT
Izasa Scientific J. Jimeno S.A.
Labprocess
Rubilabor, S.L. Sartorius Stedim Spain, S.A.U. Science Basic Solutions, S.L. - SBS, S.L. Tecny Fluor (Materiales Tecny Fluor, S.L.)
Trallero & Schlee, S.L.
Vidra Foc, S.A.
Filtración
Acefe, S.A.
Agem, Auxiliar General de Electromedicina, S.A. Agilent Technologies Spain, S.L. Albet-Hahnemuehle, S.L.U
Análisis Vínicos, S.L. Análisis y Filtración, S.L.
Anisol Equipos, S.L.
Anorsa (Aparatos Normalizados, S.A.)
Assainissement Technique International, S.L. Auxilab, S.L.
Beko Tecnológica, S.L. Bioser, S.A. Chemlabor, S.L.
CHMLAB Group
CISA - Cedacería Industrial, S.L. CMBE-Cial. Maquinaria y Bienes de Equipo, S.L. Comercial Labor, S.A. Comercial Rafer, S.L. Comercial Tecno, S.L. Comexglobal S.R.L. Distribuciones Científicas Sanitarias Distrilab, S.L Domnick Hunter Ibérica E. Bachiller B., S.A. Elga Labwater (Grupo Veolia Water Technologies) Equitrol, S.L.
Filtra Vibración, S.L.
Filtros Anoia, S.A.
Filtros Ceta, S.L.U.
Fisher Scientific Gesfilter, S.L.
Haver & Boecker Telas Metálicas Iberfluid Instruments, S.A. Iberlab, S.L.
IUCT
Izasa Scientific J. Jimeno S.A.
KGW-Isotherm
Labbox Labware, S.L. Laborat, S.L. Levantina de Laboratorios, S.L. Linealab,S.L.
Luis Frechilla, S.L. Manema, S.A.
Millipore Ibérica, S.A. Nirco, S.L. Panreac Química, S.L.U. Quilinox, S.L. Quimivita, S.A. División Laboratorio Riera Nadeu, S.A. Rubilabor, S.L.
Sartorius Stedim Spain, S.A.U. Serviquimia, S.L. Spetec GmbH Symta, S.L.L.
Tecan Ibérica Instrumentación, S.L. Tecnoquim, S.L.
Tecny Fluor (Materiales Tecny Fluor, S.L.)
Thermo Fisher Scientific SLU Tolquimex, S.L.
Trallero & Schlee, S.L. Trox España, S.A.
Veolia Labwater España Vertex Technics, S.L. Vidra Foc, S.A.
Vidrio Industrial Pobel, S.A. Vrep, S.A.
VWR International Eurolab, S.L.
Hibridación sobre membrana Acefe, S.A.
Análisis Vínicos, S.L. Chemlabor, S.L. Distrilab, S.L Ecogen, S.L. Fisher Scientific Grupo Taper Iberlab, S.L. J. Jimeno S.A. Nirco, S.L. Rubilabor, S.L.
Tecan Ibérica Instrumentación, S.L. Vidra Foc, S.A.
VWR International Eurolab, S.L.
Indicadores biológicos AES Laboratorio, S.A. Antonio Matachana, S.A. Antonio Matachana, S.A. Div. Laboratorios Chemlabor, S.L. Distribuciones Científicas Sanitarias Distrilab, S.L Ecogen, S.L. Fisher Scientific Iberlab, S.L. Instrumentación Analítica, S.A. Izasa Scientific J. Jimeno S.A. Laboratorios Microkit, S.L. Levantina de Laboratorios, S.L. Quimivita, S.A. División Laboratorio Rubilabor, S.L. Steris Iberia, S.A. Surcis, S.L.
Tecny Fluor (Materiales Tecny Fluor, S.L.) Tiselab - Soluciones GMP para industrial Biofarmacéutica y afines
Vidra Foc, S.A.
VWR International Eurolab, S.L.
LIMS
Agilent Technologies Spain, S.L.
Carl Zeiss Iberia, S.L. Chemlabor, S.L.
David Spuch Calvar Distrilab, S.L
Izasa Scientific
J. Jimeno S.A.
PerkinElmer España, S.L. Swag, S.L. Software para el Laboratorio
Tecnoquim, S.L.
Thermo Fisher Scientific SLU
Vidra Foc, S.A.
Zwick Ibérica Equipos de Ensayos, S.L.
Liofilización
Anorsa (Aparatos Normalizados, S.A.)
Bercu Instruments, S.L.
Chemlabor, S.L.
Distrilab, S.L
Fedelco, S.L.
Fisher Scientific Frances Micron España, S.A. Grupo Taper Iberlab, S.L.
IUCT
Izasa Scientific
J. Jimeno S.A. Metrofísica, S.L.
Quimivita, S.A. División Laboratorio Rubilabor, S.L.
Sartorius Stedim Spain, S.A.U.
Serviquimia, S.L.
Tecnoquim, S.L.
Tecny Fluor (Materiales Tecny Fluor, S.L.)
Telstar Technologies, S.L. Tolquimex, S.L.
Trallero & Schlee, S.L.
Vidra Foc, S.A.
VWR International Eurolab, S.L.
Mediciones electromagnéticas
Álava Ingenieros, S.A.
Distrilab, S.L
Electrónica de Medida y Control, S.A.
Iberlab, S.L.
Vidra Foc, S.A.
Ósmosis inversa
Acefe, S.A.
Agem, Auxiliar General de Electromedicina, S.A.
Anisol Equipos, S.L.
Antonio Matachana, S.A.
Aplicaciones Analíticas Doménech, S.L.
Assainissement Technique International, S.L.
Bombas Grundfos España, S.A.
CCI Control de Calidad Chemlabor, S.L.
CMBE-Cial. Maquinaria y Bienes de Equipo, S.L.
Distrilab, S.L
Fisher Scientific
Gomensoro, S.A.
Hanna Instruments Iberlab, S.L.
Izasa Scientific
J. Jimeno S.A.
Labolan, S.L. Levantina de Laboratorios, S.L.
Luis Frechilla, S.L.
Millipore Ibérica, S.A.
Quimivita, S.A. División Laboratorio
Rectus Tema, S.L.
Sartorius Stedim Spain, S.A.U.
Sugelabor, S.A.
Tecnoquim, S.L.
Tecny Fluor (Materiales Tecny Fluor, S.L.)
Thermo Fisher Scientific SLU
Tiselab - Soluciones GMP para industrial Biofarmacéutica y afines
Tolquimex, S.L.
Trallero & Schlee, S.L.
Veolia Labwater España
Vidra Foc, S.A.
Vrep, S.A.
VWR International Eurolab, S.L.
Polarimetría
Acefe, S.A.
Agem, Auxiliar General de Electromedicina, S.A.
Analab, S.A.
Análisis y Filtración, S.L.
Anisol Equipos, S.L.
Anorsa (Aparatos Normalizados, S.A.)
Auxilab, S.L.
Bercu Instruments, S.L.
Chemlabor, S.L.
Comecta, S.A. - Grupo Selecta Comercial Labor, S.A. Comercial Rafer, S.L. Distribuciones Científicas Sanitarias Distrilab, S.L
Fisher Scientific Gomensoro, S.A. Grupo Taper Iberlab, S.L. Instrumentación Analítica, S.A. IUCT Izasa Scientific J. Jimeno S.A. Levantina de Laboratorios, S.L. Luis Frechilla, S.L. Microciencia, S.A. PerkinElmer España, S.L. Quimivita, S.A. División Laboratorio Serviquimia, S.L. Sugelabor, S.A. Tecnoquim, S.L. Tolquimex, S.L. Trallero & Schlee, S.L. Vidra Foc, S.A. VWR International Eurolab, S.L. Refractometría
Acefe, S.A. Agem, Auxiliar General de Electromedicina, S.A. Analab, S.A. Análisis Vínicos, S.L. Análisis y Filtración, S.L.
Anisol Equipos, S.L. Anorsa (Aparatos Normalizados, S.A.)
Aries Ingeniería y Sistemas, S.A. Auxilab, S.L. Bercu Instruments, S.L. Chemlabor, S.L. Comecta, S.A. - Grupo Selecta Comercial Labor, S.A. Comercial Rafer, S.L. Distribuciones Científicas Sanitarias Distrilab, S.L Esindus, S.A. Fedelco, S.L. Fisher Scientific Gomensoro, S.A. Grupo Taper Herter Instruments, S.L. Hanna Instruments Iberlab, S.L. Iberlaser, S.A. J. Jimeno S.A. Knauer Wissenschaftliche Geräte GmbH Laborat, S.L. Leica Microsistemas, S.A. Levantina de Laboratorios, S.L. Luis Frechilla, S.L. Maselli Ibérica Microciencia, S.A. Panreac Química, S.L.U. Quimivita, S.A. División Laboratorio Rubilabor, S.L. Serviquimia, S.L. Tecnoquim, S.L. Tolquimex, S.L. Trallero & Schlee, S.L. Vidra Foc, S.A. VWR International Eurolab, S.L.
Screening automático
Bentley Instruments Carl Zeiss Iberia, S.L. Chemlabor, S.L. Distribuciones Científicas Sanitarias Distrilab, S.L Fisher Scientific Fine Science Tools GmbH (FST) Iberlab, S.L. Izasa Scientific Tecan Ibérica Instrumentación, S.L. Thermo Fisher Scientific SLU Vertex Technics, S.L. Vidra Foc, S.A.
Software para laboratorio
Acefe, S.A.
AES Laboratorio, S.A.
Agilent Technologies Spain, S.L. Aicos Technologies, S.A. Álava Ingenieros, S.A.
Anorsa (Aparatos Normalizados, S.A.)
Aplicaciones Analíticas Doménech, S.L. Bentley Instruments
Carl Zeiss Iberia, S.L. Chemlabor, S.L.
David Spuch Calvar Elecsoft, S.L.
Expert System Solutions S.R.L. Fisher Scientific Gomensoro, S.A.
Haver & Boecker Telas Metálicas
Huber Iberlab, S.L. Iberlaser, S.A.
Instrumentos Físicos Ibérica, S.L.
Izasa Scientific Julabo GmbH
Konik-Tech
LAUDA DR. R. WOBSER GMBH & CO. KG
Leica Microsistemas, S.A. Maselli Ibérica Metrofísica, S.L.
Mettler-Toledo, S.A.E.
Metrotec, S.A. Microciencia, S.A.
National Instruments Spain
Quimivita, S.A. División Laboratorio Swag, S.L. Software para el Laboratorio Thermo Fisher Scientific SLU Vertex Technics, S.L. Vidra Foc, S.A.
Titración
Acefe, S.A.
Anorsa (Aparatos Normalizados, S.A.)
AxFlow, S.A.
Bercu Instruments, S.L. Chemlabor, S.L.
Comercial Rafer, S.L.
Crison Instruments, S.A. Distribuciones Científicas Sanitarias Distrilab, S.L Esindus, S.A. Fedelco, S.L. Fisher Scientific Gomensoro, S.A. Hach Lange Spain, S.L.U. Hanna Instruments Hirschmann Laborgeräte GmbH & Co. KG Iberlab, S.L. Instrumentación Analítica, S.A. IUCT
Izasa Scientific J. Jimeno S.A. Laborat, S.L. Labprocess Linealab,S.L. Luis Frechilla, S.L. Lumaquin, S.A. Mettler-Toledo, S.A.E. Net Interlab, S.A.L. Panreac Química, S.L.U. Quimivita, S.A. División Laboratorio R. Espinar S.L. Serviquimia, S.L. Tecnoquim, S.L. Tolquimex, S.L. Trallero & Schlee, S.L.
Vidra Foc, S.A.
VWR International Eurolab, S.L.
Ultracentrifugación
Acefe, S.A.
Agem, Auxiliar General de Electromedicina, S.A.
Anisol Equipos, S.L.
Anorsa (Aparatos Normalizados, S.A.)
Chemlabor, S.L.
Comecta, S.A. - Grupo Selecta
Distribuciones Científicas Sanitarias
Distrilab, S.L
Fisher Scientific Iberlab, S.L.
Izasa Scientific J. Jimeno S.A.
Millipore Ibérica, S.A.
Quimivita, S.A. División Laboratorio
Rubilabor, S.L.
Serviquimia, S.L.
Thermo Fisher Scientific SLU
Tolquimex, S.L.
Vidra Foc, S.A.
VWR International Eurolab, S.L.
Ultrafiltración
Acefe, S.A.
Agem, Auxiliar General de Electromedicina, S.A.
Anisol Equipos, S.L.
Anorsa (Aparatos Normalizados, S.A.)
Assainissement Technique International, S.L. Chemlabor, S.L.
CMBE-Cial. Maquinaria y Bienes de Equipo, S.L.
Distribuciones Científicas Sanitarias
Distrilab, S.L
Elga Labwater (Grupo Veolia Water Technologies)
Filtros Ceta, S.L.U.
Fisher Scientific Iberlab, S.L.
Izasa Scientific J. Jimeno S.A.
Laborat, S.L.
Millipore Ibérica, S.A.
Quimivita, S.A. División Laboratorio
Sartorius Stedim Spain, S.A.U.
Spetec GmbH
Thermo Fisher Scientific (Barcelona) Tolquimex, S.L.
Veolia Labwater España
Vidra Foc, S.A.
Vrep, S.A.
VWR International Eurolab, S.L.
Viscosimetría
Agem, Auxiliar General de Electromedicina, S.A.
Anisol Equipos, S.L.
Anorsa (Aparatos Normalizados, S.A.)
Aplein Ingenieros, S.A.
Aries Ingeniería y Sistemas, S.A.
Auxilab, S.L.
Bercu Instruments, S.L. Chemlabor, S.L.
Comecta, S.A. - Grupo Selecta Comercial Labor, S.A.
Distribuciones Científicas Sanitarias Distrilab, S.L Esindus, S.A. Fedelco, S.L.
Fisher Scientific Gomensoro, S.A.
Iberlab, S.L.
Instrumentación Analítica, S.A. Instrumentos Físicos Ibérica, S.L.
IUCT
Izasa Scientific J. Jimeno S.A. J. P. Selecta, S.A.
Julabo GmbH Labolan, S.L.
Laborat, S.L.
LAUDA DR. R. WOBSER GMBH & CO. KG Levantina de Laboratorios, S.L. LGC Standards, S.L.U. Linealab,S.L.
Luis Frechilla, S.L. Lumaquin, S.A.
Mab Industrial, S.L.U. Metrotec, S.A.
Maselli Ibérica
Net Interlab, S.A.L. PerkinElmer España, S.L. Protón
Quimivita, S.A. División Laboratorio
Rubilabor, S.L.
Serviquimia, S.L. Spectro Hispania, S.L. Tecnoquim, S.L. Tecny Fluor (Materiales Tecny Fluor, S.L.) Tolquimex, S.L. Trallero & Schlee, S.L. Vidra Foc, S.A. Vidrio Industrial Pobel, S.A. Viscotech Hispania, S.L. VWR International Eurolab, S.L. Waters Cromatografía, S.A.
Voltametría
Anorsa (Aparatos Normalizados, S.A.) Chemlabor, S.L. Distrilab, S.L Fisher Scientific Gomensoro, S.A. Iberlab, S.L. Instrumatic Española, S.A. J. Jimeno S.A. Net Interlab, S.A.L. Sugelabor, S.A. Tecnoquim, S.L. Trallero & Schlee, S.L. Vidra Foc, S.A.
Otros
AES Laboratorio, S.A. Agem, Auxiliar General de Electromedicina, S.A. Aicos Technologies, S.A. Albet-Hahnemuehle, S.L.U Anorsa (Aparatos Normalizados, S.A.) Aqua-Consult Ingenieros, S.L. Arcamo Controls, S.A. Beko Tecnológica, S.L. Bioser, S.A. CCI Control de Calidad Comercial Rafer, S.L. Dinter-Dinko Distrilab, S.L Elecsoft, S.L. Entorn, S.A. - Enginyeria i Serveis Esindus, S.A. Filtros Ceta, S.L.U. Fisher Scientific Formimetal, S.L. Frances Micron España, S.A. Gomensoro, S.A. Hanseata, S.A. Hidracar, S.A. Iberfluid Instruments, S.A. Iberlab, S.L. IKA-Werke GmbH & Co.Kg Ineltec, S.L. Izasa Scientific J. Bonals, S.A. Knauer Wissenschaftliche Geräte GmbH Laborat, S.L. Laboratorios Microkit, S.L. LGC Standards, S.L.U. Matelco, S.A. Metrofísica, S.L. Metrotec, S.A. Pesos M.B.M., S.L. Quimivita, S.A. División Laboratorio R. Espinar S.L. Rectus Tema, S.L. Sartorius Stedim Spain, S.A.U. Sistemas Electrónicos de Detección y Análisis, S.L. - SEDA Surcis, S.L.
Tecil
Tiselab - Soluciones GMP para industrial Biofarmacéutica y afines
Trallero & Schlee, S.L.
Vidra Foc, S.A.
VWR International Eurolab, S.L.
Watlow Iberica SLU
Zwick Ibérica Equipos de Ensayos, S.L.























































































